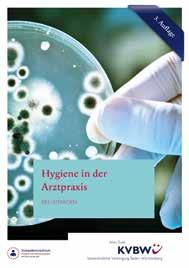

Amts- und Mitteilungsblatt der ärztlichen Körperschaften | ISSN 0720-3489 | E 1041 | 78. Jahrgang | Gentner Verlag
zteblatt Baden-Württemberg 07 | 2023 www.ärzteblatt-bw.de Foto: Wellcome Collection / Science Museum, London
Är
Außergewöhnliche,großonnen-undlichtdurchflutete weisonnigeDachbalkone,modernehelleDesigner-Ausiefgaragenplätze,sofortfrei,Energieverbrauchsausweis, a),EnergieeffizienzklasseD,Energieträgerder Heizung:Erdgas.Bj.2008.EinPlatzanderSonnemittraumhaftemSonnenuntergangund
Stuttgart-Gänsheide: Einzigartige,herrschaftlicheJahrhundertwende-Villa, Top-Originalzustand. BestlageimGrünenmitStadtblick.Viele,wunderschöneOriginalelmenteverleihendemVillenobjekt seinenbesonderenCharmeundFlair.Bj.1906,ca.350m² Wohnfläche,ca.3.100m² traumhafter,uneinsehbarer Park, 5Garagen,Raumhöheca.3,3m.Energieausweisliegtnichtvor,daDenkmalobjekt. Traumhaftes,seltenesVillenanwesenderabsolutenSpitzenklasse!
Stuttgart-Sonnenberg:(Toplagemiteinzigartigem Weitblick) Außergewöhnliche,großzügige5-Zimmer-Penthouse-WohnungmitLoftcharakter,sonnen-undlichtdurchflutete 5Zimmer,Wohnflächeca.182m²,zweisonnigeDachbalkone,modernehelleDesigner-Ausstattung,offenerKamin,Aufzug, 2Tiefgaragenplätze,sofortfrei,Energieverbrauchsausweis, Endenergieverbrauchswert125.2kWh/(m²a),EnergieeffizienzklasseD,Energieträgerder Heizung:Erdgas.Bj.2008.EinPlatzanderSonnemittraumhaftemSonnenuntergangund Weitblick,kennzeichnendiesen Wohnklassiker!
Großzügige,familiengerechte ldnähe,herrliTopzuroßzügigeAuffahrtmit a),EnergieträgerderHeizung:Heizöl,EnergieeffizienzklasseD,Bj.1959(1987hochwertigstkernsaniertund aumhausfüreineGroßfamiliein
Stuttgart-West – Eine seltene Gelegenheit in Toplage Am Kräherwald: Ein Großzügiges, vielseitiges und familiengerechtes Wohnhaus (Doppelhaushälfte), derzeit als 2Famillienhaus genutzt, nach Umbau/Ausbau vielseitig nutzbar, Wohnfläche ca. 234 m², ca. 483 m² herrliches, ebenes und sonniges Grundstück (echtes Kinderspielparadies!), 3 große Garagen mit direktem Zugang ins Haus, guter Zustand, sofort frei! Energiebedarfsausweis, Endenergiebedarfswert 220.1 kWh/(m²a), Energieträger der Heizung: Erdgas, Energieeffizienzklasse G, Bj. 1936. Ein perfektes Wohlfühlhaus für eine Großfamilie/Mehrgenerationenhaus/Wohnen/Arbeiten! Kaufpreis Euro 1.295.000.--
Stuttgart-Gänsheide: Einzigartige,herrschaftlicheJahrhundertwende-Villa, Top-Originalzustand. BestlageimGrünenmitStadtblick.Viele,wunderschöneOriginalelmenteverleihendemVillenobjekt seinenbesonderenCharmeundFlair.Bj.1906,ca.350m² Wohnfläche,ca.3.100m² traumhafter,uneinsehbarer Park, 5Garagen,Raumhöheca.3,3m.Energieausweisliegtnichtvor,daDenkmalobjekt. Traumhaftes,seltenesVillenanwesenderabsolutenSpitzenklasse!
KaufpreisundDetailsaufAnfrage
,
Stuttgart-Degerloch(BestlagemitbestechendemStadtpanoramaweitblick), liche, großzügigeundrepräsentativeEtagenwohnungfürhöchsteWohnsprüchesowieechtem Wohlfühlcharakter,absolutruhige,sonnigeBestlageinWald Stadtpanoramaweitblick,Wohnflächeca.239m², ment,helle,exklusiveAusstattung,offenerKamin, garagenplätze, (m²a),EnergieträgerderHeizung:Erdgas,EnergieeffizienzklasseE,Bj.1992.EineabsoluteRarität undperfekteTraumwohnungmitschönstemStadtpanoramaweitblicküberStuttgart! KaufpreisundDetailsaufAnfrage.


Stuttgart-Nord, (Villenlage Nähe Doggenburg): Ein Wohlfühlhaus! Wunderschöne, herrschaftliche 1-Familien-Stadtvilla mit vielseitiger Nutzung, Toplage – Nähe Kräherwald, schöne Stadtsicht, ca. 929 m² großes, herrliches und ebenes Grundstück, Wohnfläche ca. 248 m², ca. 2.8 m stilvolle Raumhöhe, 9 Räume und ideal für eine Großfamilie. Weitere Bebauungsmöglichkeiten auf dem Grundstück vorhanden.

Energiebe- darfsausweis, Endenergiebedarfswert 196.02 kWh/(m²a), Energieeffizienzklasse F, Energieträger der Heizung Heizöl, Bj. 1925. Ein großzügiger Villenklassiker mit viel Charme und Flair! Kaufpreis und Details auf Anfrage
Stuttgart-Beste Villenlage(NäheDegerloch/Waldschule): Großzügige,familiengerechte aumvillamitechtem Wohlfühlcharakter,absolutruhige,sonnigeBestlagein Waldnähe,herrlicher Weitblick, Wohnflächeca.384m stand,helleSchwimmhalle,traumhaftes Doppelgarage,Energiebedarfsausweis,Endenergiebedarfswert111.9kWh/(m gerderHeizung:Heizöl,EnergieeffizienzklasseD,Bj.1959(1987hochwertigstkernsaniertund kompletterUmbaumitvielLiebeinsDetail).Einperfektes schönsterVillenlage!

oßzügigeundfamiglichkeiten, 290 m² , Ausstattung, rkgrundstück,Doppelgarage,Energieverng: Erdaumgrundstückund
Stuttgart–Einmaliger
KaufpreisundDetailsaufAnfrage
Außergewöhnliche,moderneEinfamilien-VillaimBungalowstil,sehrbequemes Ebene,ca.280m läufiger,ebener Saunahaus,Energiebedarfsausweis,Endenergiebedarfswert371.9kWh/(m H,EnergieträgerderHeizung: einzigartiges einerderschönstenprivatenGartenparkanlageninStuttgart!
illen,Eigentumswohnungen, BauplätzeaufAnfrage in StuttgartundUmgebung. rnhaldenstraße87 ■ D70184Stuttgart ■ Telefon0711 -235370 ■ Fax0711 -235319 .steffenboeckimmobilien.de ■ info@steffenboeckimmobilien.de
Stuttgart-Höhenlage (Naturnahes Wohnen, Nähe Geroksruhe/Merzschule) : Stilvolle, wunderschöne 1-Familien-Stadtvilla mit viel Charme und Flair, einzigartige, naturnahe Alleinlage in den Weinbergen mit herrlichem Weitblick, Wohnfläche ca. 201 m², Topzustand mit viel Liebe ins Detail fortlaufend saniert, exklu- sive Ausstattung, ca. 3.748 m² wunderschönes, großzügiges Grundstück mit herrlichen Terrassen, 6 Außen- stellplätze und 1 große Garage, Energiebedarfsausweis, Endenergiebedarfswert 102.3 kWh/(m²a), Energieträger der Heizung: Heizöl, Energieeffizienzklasse D, Bj. 1910. Eine absolute Kaufgelegenheit für echte Naturliebhaber! Kaufpreis und Details auf Anfrage.
Stuttgart-Süd (Naturnahe Traumlageim Villengebiet Bopser): Elegante, großzügigeundfamiliengerechte 1-Familien-Villamit schöner Einliegerwohnung,vielseitigeNutzungsmöglichkeiten, beste, ruhige undsonnige Villenlage, phantastischer Panoramastadtblick, Wohnfläche ca 290 m² , licht- und sonnendurchflutete Zimmer, sehr gepflegterZustand, hochwertige Ausstattung, ca. 1.228 m² großes,wunderschönes und ebenes Parkgrundstück,Doppelgarage,Energieverbrauchsausweis,Endenergieverbrauchswert 221.80kWh/(m²a), Energieträger derHeizung: Erdgas, EnergieeffizienzklasseG,Bj.1979.EinzigartigesLiebhaberobjekt mit Traumgrundstückund Panoramastadtblick in sonniger Traumlage!
KaufpreisundDetailsaufAnfrage.
KaufpreisundDetailsaufAnfrage
Stuttgart-Degerloch (Bestlage mit bestechendem Stadtpanoramaweitblick): Außergewöhnliche, groß- zügige und repräsentative Etagenwohnung für höchste Wohnansprüche sowie echtem Wohlfühlcharakter, absolut ruhige, sonnige Bestlage in Waldnähe, unverbaubarer, bestechender Stadtpanoramaweitblick, Wohn- fläche ca. 239 m², 4 ½ Zimmer inklusive separates Gäste-Appartement, helle, exklusive Ausstattung, offener Kamin, 6 schöne Balkone, Aufzug, Topzustand, 4 Tiefgaragenplätze, 2 Abstellräume, Energieverbrauchsaus- weis, Endenergieverbrauchswert 128 kWh/(m²a), Energie-träger der Heizung: Erdgas, Energieeffizienzklasse E, Bj. 1992. Eine absolute Rarität und perfekte Traumwohnung mit schönstem Stadtpanoramaweitblick über Stuttgart! Kaufpreis und Details auf Anfrage.
Stuttgart-Degerloch(BestlagemitbestechendemStadtpanoramaweitblick), Außergewöhn liche, großzügigeundrepräsentativeEtagenwohnungfürhöchsteWohnsprüchesowieechtem Wohlfühlcharakter,absolutruhige,sonnigeBestlageinWaldnähe,unverbaubarer,bestechender Stadtpanoramaweitblick,Wohnflächeca.239m², 4½ Zimmer inklusiveseparatesGäste-Apparte ment,helle,exklusiveAusstattung,offenerKamin, 6 schöneBalkone,Aufzug,Topzustand, 4 Tief garagenplätze, 2 Abstellräume,Energieverbrauchsausweis,Endenergieverbrauchswert128kWh/ (m²a),EnergieträgerderHeizung:Erdgas,EnergieeffizienzklasseE,Bj.1992.EineabsoluteRarität undperfekteTraumwohnungmitschönstemStadtpanoramaweitblicküberStuttgart! KaufpreisundDetailsaufAnfrage.
Stuttgart-Gänsheide: Einzigartige, herrschaftliche Jahrhundertwende-Villa, Top Originalzustand. Bestlage im Grünen mit Stadtblick. Viele, wunderschöne Originalelmente verleihen dem Villenobjekt seinen besonderen Charme und Flair. Bj. 1906, ca. 350 mÇ Wohnfläche, ca. 3.100 mÇ traumhafter, uneinsehbarer Park, 5 Garagen, Raumhöhe ca. 3,3 m. Energieausweis liegt nicht vor, da Denkmalobjekt. Traumhaftes, seltenes Villenanwesen der absoluten Spitzenklasse! Kaufpreis und Details auf Anfrage.
Stuttgart Degerloch (Villengebiet Auf dem Haigst): einzigartiges, exklusives Baugrundstück, Bestlage mit einmaligen Panoramastadtblick, Baugenehmigung für moderne Villa mit ca. 450 m² Wohnfläche, Schwimmbad, Aufzug, 3 Garagen, liegt vor, ca. 1.341 m², mit traumhafter weitläufiger Park. Einzigartige Kaufgelegenheit mit einmaligem Panoramastadtblick über Stuttgart! Kaufpreis und Details auf Anfrage.

Stuttgart–Einmaliger Wohnklassikerinnaturnaher,sonnigerAlleinlage: Außergewöhnliche,moderneEinfamilien-VillaimBungalowstil,sehrbequemes Wohnenaufeiner Ebene,ca.280m² Wohnfläche,7Zimmer,exklusiveAusstattung, ca. 4.913 m² einzigartiger, weitläufiger,ebener ParkmitvielLiebeinsDetail,Doppelgarage,herrlicherSchwimmbadteich, großes Saunahaus,Energiebedarfsausweis,Endenergiebedarfswert371.9kWh/(m²a),Energieeffizienzklasse H,EnergieträgerderHeizung: Heizöl,Bj.1966,fortlaufendhochwertigsaniert.DieVillavermitteltein einzigartiges WohngefühlundLebensqualitätfürhöchsteAnsprüche.EinmaligerVillenklassikermit einerderschönstenprivatenGartenparkanlageninStuttgart!
KaufpreisundDetailsaufAnfrage.

Weitere interessante Häuser / Villen, Eigentumswohnungen, Bauplätze auf Anfrage in Stuttgart und Umgebung. Steffen Böck Immobilien . Wernhaldenstraße 87 . D 70184 Stuttgart . Telefon 0711 - 23 53 70 . Fax 0711 - 23 53 19 www.steffenboeckimmobilien.de . info@steffenboeckimmobilien.de
18.03.22 08:44 We itereinteressante Häuser /Villen,Eigentumswohnungen, StuttgartundUmgebung. SteffenBöck Immobilien ■ We rnhaldenstraße87 ■ D7 0184Stuttgart -23531 9 www.steffenboeckimmobilien.de ■ info@steffenboeckimmobilien.de
KaufpreisundDetailsaufAnfrage.
TOP_0122_Boeck.indd 1 Boeck_Immobilien_Anz_top0422.indd 27 21.11.22 15:46
Menschliches Ohr

Das Modell des menschlichen Ohres kann zerlegt werden, wodurch die Strukturen des Mittel- und Innenohres erkennbar werden. Das aus Elfenbein vermutlich in Europa zwischen 1700 und 1800 gefertigte Modell eines unbekannten Herstellers diente offenbar dazu, Medizinstudierenden nicht nur die Anatomie des Ohres zu illustrieren, sondern ihnen auch vermitteln, wie akustische Signale auf ihrem Weg vom Außenohr über das Mittelohr hin zu den Nervenzellen des Innenohrs jeweils umgeformt und verarbeitet werden. In vielen Bereichen der Medizin wurden und werden Modelle eingesetzt. Einige Beispiele aus aller Welt zeigt das Ärzteblatt BadenWürttemberg in diesem Jahr. Ermöglicht wird die Serie durch die Baden-Württembergische Bank (BW-Bank). Die Bank verdeutlicht damit ihre enge Beziehung zur Medizin und zur Ärzteschaft im Südwesten. So bieten die Beratungsspezialisten der BW-Bank seit über einem Vierteljahrhundert in ihren FinanzZentren Medizin kompetente Unterstützung und Beratung in allen wirtschaftlichen Fragen von Heilberuflern.

Mehr Informationen zum umfangreichen Leistungsangebot für Heilberufler sowie zu den Kontaktdaten der Finanz-Zentren Medizin in Ihrer Nähe erhalten Sie unter: www.bw-bank.de/heilberufe


E-Mail: heilberufe@bw-bank.de

ÄBW 07 | 2023 435 @AerzteblattBW Inhalt Editorial Verrat an der Patienten-Versorgung 436 Kammern und KV Digitalisierungs-Showroom erweitert 437 Bundesweiter Hitzeaktionstag 438 Blackout 440 Clinician Scientists Programm ICON 442 „Sehen die Auswirkungen mit Sorge“ 442 Hygiene in der Arztpraxis 443 MVZ-Regulierung 443 Solidarität mit Ärzteprotest 444 Vermischtes Namen und Nachrichten 446 CO₂-Rechner für Gesundheitseinrichtungen 449 Stärkung der Allgemeinmedizin im Studium 449 Alarmstufe Rot in Krankenhäusern 450 Online zum Job in der Arztpraxis 450 Interview: „Wehrmedizinisches Wissen verbreitern“ 451 Vernetzung 451 Förderung für Kliniken mit Geburtshilfe 452 Gewaltopfer 452 Rettet die ambulante medizinische Versorgung 453 Schutz vor Cybercrime 453 Gute Weiterbildungs- und Arbeitsbedingungen 454 Posttraumatische Stresssymptome im Arztberuf 454 Interview: „Nur mein Hausarzt wusste davon“ 456 Veranstaltungsübersicht 457 Bekanntmachungen 461 Impressum 490 Bundesweiter Hitzeaktionstag 438 Blackout Solidarität mit Ärzteprotest 444 Interview:
Wissen verbreitern“ 451 440 Anzeige
„Wehrmedizinisches
07 11 / 1 24 - 4 50 19
Telefon:
Anzeige
A. Gräfin Vitzthum
Gesundheitspolitisch Verantwortliche negieren ärztlichen Sachverstand Verrat an der Patienten-Versorgung
Warum lassen wir seit Jahrzehnten zu, dass die gesundheitspolitisch Verantwortlichen den Wert ärztlicher Arbeit und unseren hohen Einsatz für die Patienten nicht wertschätzen? Sie missachten unser Tun und negieren unseren Sachverstand in allen entscheidenden Gremien. Seit 45 Jahren arbeite ich als Ärztin, davon 33 Jahre in eigener Praxis und mehr als 25 Jahre in der Standespolitik. Bekannt für klare Worte und Mut, muss ich konstatieren: Das reicht nicht!
Zur Erinnerung: Beim 114. Deutschen Ärztetag 2011 in Kiel bestritten Prof. Jörg-Dietrich Hoppe, Präsident der Bundesärztekammer, und Gesundheitsminister Daniel Bahr die feierliche Eröffnungsveranstaltung. Der Minister versprach Maßnahmen gegen den Ärztemangel, eine neue GOÄ, mehr Freiheit bei der Berufsausübung und weniger Bürokratie. –Nichts davon wurde seither realisiert. Stattdessen steht nun die Staatsmedizin ante portas.
Ein Editorial aus meiner Feder im Ärzteblatt Baden-Württemberg vom Februar 2018 trug als Überschrift „Die Lunte brennt“. Nicht erst seit dieser Zeit ertragen wir alle täglich das Ergebnis des Verrats an den Prinzipien der Rahmenbedingungen für eine gute Versorgung. Gibt es außerhalb des ärztlichen Standes eine Berufsgruppe mit einer „Fallzahlzuwachsbegrenzung“? – Gibt es Fallpauschalen für Handwerker? – Letztere haben Bundesgesundheitsministerin Ulla
PRAXISRECHT .de
Ihr Spezialist in allen Rechtsfragen für Ärzte, Zahnärzte, Apotheken, Krankenhausträger, Berufsverbände und alle anderen Unternehmen des Gesundheitswesens.
Wir sind bundesweit für Sie aktiv. Ihre nächstgelegene Kanzlei befindet sich in Heidelberg, Hamburg oder Berlin.
Schmid und ihr international wissenschaftlich versierter Staatssekretär Karl Lauterbach seinerzeit gegen unsere wohlüberlegten Argumente durchgesetzt. Seither entlässt das Krankenhaus frühestmöglich unsere Patienten, vor allem auch die betagten Kranken. Die Kinder leben weit weg, Wartelisten werden in den Pflegeeinrichtungen, der Kurzzeitpflege und im Hospiz geführt. Die alten Menschen sind unversorgt und allein gelassen. Operationen werden wegen Personalmangels verschoben. Und wir Hausärztinnen und -ärzte stemmen mehr Hausbesuche bei geringerer Vergütung, als ein Handwerker für den Hilfsarbeiter berechnet.
Die niedergelassenen Kollegen halfen in entscheidendem Maße bei COVID-Impfungen und somit aus der Pandemie. – Immer wieder höre ich: „Ihr habt doch gut verdient beim Impfen!“ – Doch das verdreht die Tatsachen, denn wir haben noch länger gearbeitet. Unsere Medizinischen Fachangestellten haben unzählige Überstunden geleistet. Dennoch gab es bis heute keinen Bonus für diese exzellente Performance. Im Gegenteil: In den letzten zehn Jahren erhielten wir lediglich zwei Mal ein Plus von 0,2 bis 0,5. Das macht mich schier sprachlos.
Was bitte hält Minister Lauterbach ab von der Akzeptanz der notwendigen Patientensteuerung im Notdienst? Er nannte es jüngst beim Deutschen Ärztetag in Essen „Abkassieren“. – Hat er jemals Notdienst abgeleistet? Dann könnte er erkennen, dass Fehlinanspruchnahme wegen Bagatellen die Versorgung Schwerkranker verhindert. Ich kann und mag meine Erlebnisse der letzten Wochen nicht schildern. Alle Kollegen im Notdienst stehen unter Zeitdruck. Manchem „Welpen“ fehlt die hilfreiche Erfahrung der Oberärztinnen und -ärzte. Die aber sind beschäftigt mit Patienten aus dem Rettungswagen (bei gleichermaßen hohen Fehleinsätzen).
bar! Der Apotheker zerstampft beispielsweise Amoxicillin-Tabletten, um altersgerechte Säfte für Scharlachkinder herzustellen. Absurdistan! Etwa jeder dritte Patient kommt mit der Bitte um ein neues beziehungsweise geändertes Rezept zurück. Und die Gesetzlichen Krankenkassen verweigern – noch – die klare Aussage einer Regressfreiheit, wenn Niedergelassene auf eine teurere Alternative ausweichen müssen!
Bei meinem letzten „J’accuse“ geht es um ein Papier aus dem Hause von Arbeitsminister Hubertus Heil: Im Bereitschaftsdienst tätige Kolleginnen und Kollegen sollen Sozialversicherungsbeiträge zahlen (Notärzte waren hiervon immer ausgeschlossen). Sollte sein Haus darauf bestehen, ist ein Ende der baden-württembergischen Bereitschaftsdienst-Reform absehbar sicher! Rund ein Drittel unserer bislang hilfreichen Rentnerinnen und Rentner werden wohl diesen Dienst quittieren.

Wir benötigen dann künftig pro Bereitschaftsdienst 600 statt bisher 200 Kolleginnen und Kollegen, wie es das Arbeitszeitgesetz fordert. Die Kassenärztliche Vereinigung beschäftigt rund 1.000 Medizinische Fachangestellte in den Notfallpraxen. 1.700 Ärzte wird sie nicht anstellen können, um dieser Gesetzesvorlage Genüge zu tun. Utopia mit heftigsten Folgen, da alle Niedergelassenen zum Bereitschaftsdienst verpflichtet sind. Die Zentralisierung diente der Entlastung der Dienstfrequenz auf dem Land und war gerade für junge Kolleginnen und Kollegen ein Segen.
Ich könnte Seiten füllen mit Beispielen von Fehlentscheidungen aus dem Elfenbeinturm basisferner Würdenträger. Ritualisierte Debatten mit Floskelsprache der zuständigen Minister, beratungsresistent und ohne Anerkennung von Realitäten. Wenn etwas unsagbar bleibt, kommen die Unsäglichen. Diese Immunschwäche werden wir therapieren müssen, um versorgen zu können.
Rechtsanwälte & Fachanwälte für Medizinrecht | Steuerrecht
Kanzlei Heidelberg | Römerstraße 9 | 69115 Heidelberg
Telefon +49 (0)6221 659 790 | E-Mail heidelberg@praxisrecht.de
Täglich fehlen Medikamente: Analgetika, Antiallergika, Antibiotika, Dosieraerosole, auch Chemotherapie. Unfass-
436 ÄBW 07 | 2023 Editorial
Dr.
Dr. Anne Gräfin Vitzthum Stellvertretende Vorsitzende der Vertreterversammlung der Kassenärztlichen Vereinigung Baden-Württemberg
Kooperation zwischen Landesärzte- und Landesapothekerkammer Baden-Württemberg Digitalisierungs-Showroom
erweitert
Die Landesärztekammer BadenWürttemberg und die Landesapothekerkammer Baden-Württemberg sind Mitte Juni eine neue und langfristige Zusammenarbeit eingegangen. Gemeinsam wollen die beiden Körperschaften der Ärzte- und Apothekerschaft im Südwesten die flächendeckende Digitalisierung im Gesundheitswesen weiter voranbringen. Zu diesem Zweck wurde dem Digitalisierungs-Showroom der Landesärztekammer ein weiterer typischer Arbeitsplatz in Form einer Apotheke – und damit eine weitere Schnittstelle im digitalen Gesundheitsraum – hinzugefügt.
Digitale Kommunikation und Datenaustausch im Showroom















Ziel der sogenannten Telematikinfrastruktur im Gesundheitswesen ist es, eine zeitgemäße technische Infrastruktur für das Gesundheitswesen bereitzustellen. In diesem gemeinsamen Kommunikationsraum sollen sämtliche Leistungserbringer wie Arztpraxen, Kliniken, Apotheken, aber auch Patientinnen und Patienten, sicher miteinander kommunizieren und wichtige Gesundheitsdaten standardisiert und strukturiert untereinander austauschen können.
Bereits seit über einem halben Jahr betreibt die Landesärztekammer Baden-Württemberg ihren Showroom, in dem sich die digitale Kommunikation und der Datenaustausch zwischen Arztpraxen erleben lassen (das ÄBW berichtete mehrfach). Ärztinnen und Ärzte können hier die neuen digitalen Anwendungen – beispielsweise Tele -
matikinfrastruktur, Telemedizin oder Apps auf Rezept – im geschützten Raum spielerisch ausprobieren. Auf diesem Wege lassen sich Berührungsängste abbauen und mehr Akzeptanz für die Digitalisierung der gesundheitlichen Versorgung erzielen.
Kooperation zwischen Ärzteund Apothekerkammer
In Zusammenarbeit mit der Landesapothekerkammer Baden-Württemberg wurde dem Showroom jetzt der Arbeitsplatz Apotheke – und damit eine weitere Schnittstelle im digitalen Gesundheitsraum – hinzugefügt. „Durch die Kooperation mit der Landesapothekerkammer können wir jetzt die Verbindung zwischen Praxen und Apotheke innerhalb der Telematikinfrastruktur simulieren“, erläuterte Dr. Wolfgang Miller, Präsident der Landesärztekammer Baden-Württemberg. Hierfür hat die Landesapothekerkammer einen vollumfänglich ausgestatteten Arbeitsplatz mit einem Apothekenverwaltungssystem (AVS) im Showroom eingerichtet. „So kann der komplette Prozess des elektronischen Rezeptes, von Ausstellung in der Arztpraxis bis hin zur Einlösung und Ausgabe eines Medikamentes in der Apotheke, realitätsnah abgewickelt und dargestellt werden“, ergänzte Dr. Martin Braun, Präsident der Landesapothekerkammer Baden-Württemberg.
Einlösewege für das E-Rezept
Derzeit sind drei Einlösewege des E-Rezeptes möglich: via Papierausdruck durch die Arztpraxis, via E-Re -
zept-App per Smartphone oder nach Vorlage der elektronischen Gesundheitskarte (eGK). Im Showroom können jetzt all diese Szenarien durchgespielt und nachvollzogen werden. „Die Einbindung von weiteren digitalen Prozessen stärkt die Kommunikation zwischen den Praxen und den Apotheken. Mit dieser Simulation machen wir digitale Gesundheitsversorgung erlebbar“, betonte Dr. Miller. Und Dr. Braun ergänzte: „Mit dem Einsatz von neuesten Entwicklungen und Technologien unterstreichen unsere beiden Kammern einmal mehr, dass wir auch in Zukunft unseren gesetzlichen Auftrag voll und ganz erfüllen werden: fachliche Befähigung, Optimierung und Qualität der Versorgung im Gesundheitswesen zu unterstützen und voranzutreiben.“
Bundesweit verfügbare OnlineFortbildung zum E-Rezept
Die beiden Körperschaften arbeiten künftig auch bei der Vermittlung von Digital-Kompetenzen im medizinischen Bereich zusammen. So fand Ende Juni die erste gemeinsame Online-Fortbildung zum E-Rezept statt. Neben den bisher möglichen Einlösewegen über die E-Rezept-App und den Papierausdruck wurde hier erstmalig und bundesweit die Prozessabwicklung über die elektronische Gesundheitskarte (eGK) live demonstriert. Da die eGK weit verbreitet ist, wird bei der verpflichteten Einführung des E-Rezepts große Hoffnung in diesen Prozess gesetzt.
Weitere Informationen: www.aerztekammer-bw.de/ehealth
Ultraschall-System trifft Praxissoftware





Clevere Systemanbindung per DICOM oder sonoGDT.




Moderne Ultraschallgeräte verfügen über praktische Schnittstellen zur digitalen Anbindung an Ihre Praxissoftware – z.B. per DICOM oder sonoGDT. Patientendaten und Bilder werden so automatisch zwischen Ultraschall-System und Patientenakte transferiert – das spart Zeit und erleichtert Ihre Arbeit.
Entdecken Sie die digitale Zukunft des Ultraschalls –in unserer Sonothek in Leinfelden-Echterdingen oder online unter www.dormed-stuttgart.de
ÄBW 07 | 2023 Kammern und KV
DORMED Stuttgart • Meisenweg 37 •
Leinfelden-Echterdingen • Tel. 0711 75859700 • Fax 0711 75859701
70771
Wir beraten Sie gerne! Tel. 071175859700 Anzeige
Informationen und Videos zum bundesweiten

Hitzeaktionstag

Aktionsbündnis zum Schutz vor gesundheitlichen Auswirkungen von Hitze im Südwesten
Bundesweiter Hitzeaktionstag
Immer deutlicher macht sich der Klimawandel auch in gemäßigten Breiten durch lang andauernde Hitzewellen bemerkbar. Diese bergen gesundheitliche Gefahren vor allem für ältere, pflegebedürftige und vorerkrankte Menschen, Schwangere, Säuglinge und Kinder sowie für Menschen mit Behinderungen.
Gesundheitsminister Manne Lucha kündigte am 14. Juni (dem bundesweiten Hitzeaktionstag der Bundesärztekammer) an, unter anderem gemeinsam mit der Landesärztekammer und dem Deutschen Wetterdienst ein Aktionsbündnis zu gründen. Damit soll gezeigt werden, dass mawandel und Gesundheit, insbesondere der gesundheitliche Hitzeschutz, in Baden-Württemberg einen hohen Stellenwert
einnimmt und die Bevölkerung entsprechend sensibilisiert werden soll. Die Akteure wollen die bestehende Zusammenarbeit ausbauen und verstetigen sowie das Thema Hitzeschutz stärker in den gesellschaftlichen Fokus rücken und konkrete Maßnahmen vor allem für vulnerable Gruppen entwickeln.
„Gefahren, die von Hitzewellen ausgehen, müssen wir sehr ernst nehmen. Unsere Botschaft ist klar: Hitze betrifft uns alle, und wir müssen sie als gesamtgesellschaftliche Aufgabe wahrnehmen und angehen. Ich begrüße es deshalb sehr, dass wir zusammen mit der Landesärztekammer und dem Deutschen Wetterdienst an einem Strang ziehen und in dem Aktionsbündnis noch stärker zusammenarbeiten werden. Wir müssen uns auf die zunehmenden Hitzewellen vorbereiten und an besonders heißen Tagen Schutzmaßnahmen ergreifen“, sagte Minister Lucha.
Hitzeschutz bundesweit gesetzlich verankern
Beim Hitzeaktionstag am 14. Juni hat die Bundesärztekammer gemeinsam mit dem Deutschen Pflegerat und der Deutschen Allianz Klimawandel und Gesundheit darauf hingewiesen, dass bisher nur wenige Kommunen Hitzeaktionspläne eingeführt haben, und nur selten wurden Gesundheitsberufe beteiligt.
Bundesärztekammer-Präsident Dr. Klaus Reinhardt sagte: „Die Ärzteschaft sieht sich mit in der Verantwortung, die Gesundheit der Bevölkerung zu schützen. Hitzeschutz gelingt aber nur gemeinsam. Daher muss der gesundheitliche Hitzeschutz als Pflichtaufgabe gesetzlich verankert werden, mit klaren Zuständigkeiten und Kompetenzen. Darüber hinaus sollten Kommunen, Gesundheits- und Sozialeinrichtungen, Kitas, Schulen und Unternehmen noch in diesem Sommer erste pragmatische Schutzkonzepte umsetzen, um Hitzerisiken zu reduzieren. Wir stehen mit unserem Fachwissen bereit, um bei der Planung und Umsetzung der Maßnahmen zu helfen.“
Der Präsident der Landesärztekammer, Dr. Wolfgang Miller, betonte: „Als Ärztinnen und Ärzte bringen wir unsere Fachkenntnis beim gesundheitsbezogenen Hitzeschutz ein. Zudem intensivieren wir im Kreis unserer Kolleginnen und Kollegen das Wissen um die Folgen des Klimawandels und um die gesundheitliche Gefährdung durch Hitze. Bereits in den letzten Jahren haben wir die Kenntnis der Folgen des Klimawandels und ihre Bedeutung für die Gesundheit der Menschen verpflichtend in die Ausund Weiterbildung von Ärztinnen und Ärzten aufgenommen.“
Der Klimaschutzbeauftragte der Landesärztekammer, Dr. Robin Maitra, ergänzte: „Als Ärzteschaft nehmen wir unsere Verantwortung wahr, die Kenntnisse um die gesundheitlichen Folgen von Hitze auch in die Bevölkerung zu tragen. Hier werden wir in unserer Eigenschaft als Experten für die Gesundheit der Menschen vertrauensvoll und als Multiplikatoren tätig und können das Bewusstsein unserer Patientinnen und Patienten schärfen.“
Prof. Dr. Andreas Matzarakis, der Leiter des Zentrums für Medizin-Meteorologische Forschung des Deutschen Wetterdienstes, erklärte: „Laut Weltklimarat und wissenschaftlichen Untersuchungen werden die Hitzewellen an Intensität gewinnen, ihre Dauer wird ansteigen und die Häufigkeit zunehmen. Dies bedeutet nicht, dass wir in Deutschland heute keine Hitzewellen und keine Auswirkungen hätten. Wir haben in den letzten 20 Jahren intensive Hitzewellen. In
438 ÄBW 07 | 2023 Kammern und KV
Foto: OE
LGA-Chef Dr. G. Roller, LÄK-Klimaschutzbeauftragter Dr. R. Maitra, Kammerpräsident Dr. W. Miller, Gesundheitsminister M. Lucha
Wenn Hitze zum Risiko wird
Über einen sonnigen Sommertag freuen sich viele Menschen. Doch in den letzten Jahren wurden die Sommer immer heißer: Sie waren gekennzeichnet durch häufiger werdende Hitzewellen. Grund dafür ist der Klimawandel. Er wirkt sich nicht nur auf die Umwelt aus, sondern kann auch die Gesundheit schwer beeinträchtigen. Neben Beschwerden durch Hitze kann das veränderte Klima zu anderen Erkrankungen führen, wie vermehrten Allergien oder seelischen Belastungen. Auch Infektionskrankheiten können auftreten, die bisher in Deutschland nicht vorgekommen sind. Informationen zum richtigen Verhalten während einer Hitzewelle hält das Ärztliche Zentrum für Qualität in der Medizin vor.
Weitere Informationen: https://www.patienten-information.de/kurzinformationen/hitze

Deutschland ist das Hitzewarnsystem für die menschliche Gesundheit seit 2005 im Einsatz und liefert alle wichtigen und notwendigen Informationen über die Situation im Freien, in Innenräumen, in der Nacht, für die speziellen Bedingungen in Städten und für ältere Menschen. Auf der Webseite www. hitzewarnungen.de kann ein entsprechender E-Mail-Newsletter abonniert werden. Dort sind auch flächendeckende Informationen über Warnungen für den aktuellen und nächsten Tag auf Landkreisebene sowie einen Hitzetrend für die darauffolgenden Tage drei bis sechs zu finden.“
Dr. Gottfried Roller, der Leiter des Landesgesundheitsamts, unterstrich: „Insbesondere gefährdete Personen und deren Angehörige sollten sich unbedingt über Schutzmaßnahmen vor Hitze informieren und diese an heißen Tagen entsprechend umsetzen. Hitze stellt eine große gesundheitliche Belastung dar und kann im schlimmsten Fall zum Tod führen.“ Nach Schätzungen des Statistischen Landesamts würden in Baden-Württemberg pro Jahr im Schnitt etwa 1.500 Todesfälle durch Hitze mitverursacht.
Erste Städte wie Mannheim und Heidelberg hätten sich bereits auf den Weg gemacht und Hitzeaktionspläne erstellt, berichtete der LGA-Leiter weiter. „Wir begleiten diesen Weg und beraten die Gesundheitsämter durch das im Mai 2022 neu gegründete Kompetenzzentrum Klimawandel und Gesundheit“, sagte LGA-Leiter Dr. Roller. „Beispielsweise enthält der Hitzeaktionsplan von Mannheim eine Info-Broschüre mit Notrufnummern, Hitzeschutztipps, kühlen Orten, zielgruppenspezifischen Tipps für Multiplikatoren wie Pflegepersonal und Erzieherinnen und Erzieher und einen Hitze-Check zur eigenen Empfindlichkeit – das ist vorbildlich.“
Politische Forderungen zum Hitzeschutz
Obwohl Hitzeschutz öffentlich und politisch mehr und mehr Gehör findet, stockt die Umsetzung. Die 93. Gesundheitsministerkonferenz rief schon im Jahr 2020 zu einer flächendeckenden Erstellung und Umsetzung von Hitzeaktionsplänen in deutschen Kommunen bis 2025 auf. Dennoch haben bisher nur wenige Kommunen Hitzeaktionspläne erstellt, meist ohne maßgebliche Einbeziehung des Gesundheitssektors. Dies, obwohl Gesundheitsberufen eine zentrale Funktion in der präventiven Stärkung von Hitzekompetenz sowie bei der Behandlung von Hitzeerkrankungen zukommt.
Für mehr Hitzeschutz in Deutschland hat daher die Bundesärztekammer gemeinsam mit dem Deutschen Pflegerat und der Deutschen Allianz Klimawandel und Gesundheit gefordert:
1. Einen klaren gesetzlichen Rahmen für gesundheitlichen Hitzeschutz auf Bundes-, Landes- und kommunaler Ebene, in dem Hitzeschutz als Pflichtaufgabe verankert wird; Zuständigkeiten und Kompetenzen müssen geklärt werden. Dies gilt auch für Gesundheits- und Pflegeeinrichtungen sowie für Be -
triebe, Kitas und Bildungseinrichtungen. Einen solchen Rahmen kann das sich in Arbeit befindliche Klimaanpassungsgesetz schaffen.
2. Neben der Verankerung von gesundheitlichem Hitzeschutz in Gesetzen des Gesundheitsrechts ist Hitzeschutz auch in relevanten Gesetzen und Rechtsverordnungen anderer Sektoren zu berücksichtigen. Hierzu gehören insbesondere das Baurecht und das Arbeitsrecht.
3. Flächendeckende Hitzewellen können sich zu Großschadensereignissen und Katastrophen entwickeln. Dafür braucht es Strukturen und klare Zuständigkeiten in den Gesundheitsministerien von Bund und Ländern, um den gesundheitlichen Hitzenotstand gemeinsam mit den verantwortlichen Stellen im Katastrophen- und Bevölkerungsschutz festzustellen, damit der Katastrophenfall ausgelöst werden kann. Dies beinhaltet klare Zuständigkeiten für Warnungen und Verhaltensmaßnahmen, multidisziplinäre Kompetenzzentren vergleichbar mit denen für die biologische Gefahrenabwehr, Konzepte und Ressourcen für Schutzmaßnahmen und eine Integration in Planungen des gesundheitlichen Bevölkerungsschutzes. Dazu gehören auch vorbereitende Planspiele und Übungen auf allen Verwaltungsebenen und mit den Akteuren des Katastrophenschutzes.
4. Ein staatlich finanziertes und unabhängig agierendes Kompetenzzentrum für gesundheitlichen Hitzeschutz auf Bundesebene, das Wissen aus Wissenschaft und Praxis sammelt, auf kommunaler, Länderund Bundesebene in der Umsetzung berät und Austausch zwischen den Akteurinnen und Akteuren fördert.
Bundesgesundheitsminister will Hitzeschutzplan Bundesgesundheitsminister Prof. Dr. Karl Lauterbach will gemeinsam mit der Ärzteschaft, der Pflege und weiteren Berufen des Gesundheitswesens einen bundesweiten Hitzeschutzplan erarbeiten. Er wolle sich dabei an Frankreich orientieren, wo je nach Schwere einer Hitzewelle im ganzen Land Schutzmaßnahmen ausgelöst werden. Diese reichen von Kälteräumen über Hitzeaktionspläne für Pflegeeinrichtungen und Kliniken bis zu Anrufen bei alten Menschen, damit sie regelmäßig trinken. Für die Umsetzung wären in Deutschland die Länder und Kommunen verantwortlich.
Der Bundesgesundheitsminister reagierte damit auf Forderungen aus der Ärzteschaft und der Pflege sowie der Deutschen Allianz Klimawandel und Gesundheit, die am bundesweiten Hitzeaktionstag auf die mangelnden Vorkehrungen in Deutschland aufmerksam gemacht hatten.
ÄBW 07 | 2023 439 Kammern und KV
Weitere Informationen: www.aerztekammer-bw.de/hitze @AerztekammerBW Rounded square AerztekammerBW Die Social-MediaKanäle der Landesärztekammer:
Blackout
Es ist ein Szenario, über das sich bisher wohl niemand in der Bevölkerung ernsthaft Gedanken gemacht hat: Stromausfall. Durch den Krieg in der Ukraine ist diese Thematik stärker in den Vordergrund gerückt. Daher hat die Landesregierung die Stadt Stuttgart beauftragt, sich die Frage zu stellen, wie die Gesundheitsversorgung in einem solchen Fall aufrechterhalten werden kann.
Vorab: Der Praxisbetrieb in unterschiedlicher Ausprägung ist stark davon abhängig, dass Strom zur Verfügung steht. Ohne Strom gibt es kein Licht, kein Wasser, kein Telefon, keine Heizung, keine Software, keine Drucker. Auch Mobiltelefone funktionieren nicht. Nur die wenigsten Praxen sind mit einem Notstromaggregat ausgestattet. Daher kann von keiner Praxis erwartet werden, dass sie versucht, auch bei einem Stromausfall
Veranstaltungshinweis
Die Management Akademie der Kassenärztlichen Vereinigung Baden-Württemberg (MAK) lädt zu einer Fortbildungsveranstaltung für Ärzte und Psychotherapeuten ein.
Veranstaltungstitel:
MVZ in Theorie und Praxis
Ziele:
Interessieren Sie sich für die Arbeit in einem MVZ oder wollen Sie eine neue Einrichtung gründen? In unserem Seminar erfahren Sie, in welchen Varianten ein MVZ möglich ist und worin die Unterschiede zur Berufsausübungsgemeinschaft bestehen. Wir vermitteln Ihnen die gesellschafts- und zulassungsrechtlichen Rahmenbedingungen zur Gründung eines MVZ und gehen dabei auch auf die Rolle von Investoren und die Möglichkeiten zur Beschäftigung von Angestellten ein. Darüber hinaus profitieren Sie von wertvollen Tipps zum Zulassungsverfahren.
Weitere Informationen zur Veranstaltung finden Sie im Internet unter www.mak-bw.de.
Referent:
• Jan-Ulrich Schuster, Rechtsassessor, KVBW
Termin und Veranstaltungsort:
13. September 2023 (15.00 bis ca. 18.00 Uhr), Live-Online
Information und Anmeldung:
• Management Akademie der KV Baden-Württemberg, Telefon (07 11) 78 75-35 35, Fax (07 11) 78 75-48 38 88, E-Mail: info@mak-bw.de
• oder Online-Anmeldung unter www.mak-bw.de
Teilnahmegebühr: 69,– Euro (inklusive Unterlagen)
Fortbildungspunkte: 4
den Praxisbetrieb aufrechtzuerhalten. Auf alle Fälle würden die Krankenhäuser – zumindest die größeren –offengehalten werden, hier sind auch Notstromaggregate vorhanden.
Geplanter Stromausfall

Der am wenigsten kritische Fall wäre eine geplante Stromabschaltung, die vorher angekündigt ist. Die Patiententermine könnten abgesagt, möglicherweise die Zeit für Hausbesuche genutzt werden. Ein Aushang an der Praxis und eine Bandansage im Vorfeld wären sicherlich hilfreich. Weiter wäre es wichtig, vorher die Systeme runterzufahren, damit keine Daten verloren gehen und vielleicht Kühlakkus für den Kühlschrank zu besorgen, damit für einzelne Arzneimittel die Kühlketten nicht unterbrochen werden. Gegebenenfalls sollten Aufzüge gesperrt werden, damit keine Patienten stecken bleiben. Die Kassenärztliche Vereinigung Baden-Württemberg (KVBW) empfiehlt, sich mit einem batteriebetriebenen Radio auszustatten, um die Durchsagen der Behörden empfangen zu können.
Plötzlicher Blackout
Schwieriger würde es, wenn der Stromausfall plötzlich, aber nur für kurze Zeit kommt, also vielleicht wenige Stunden dauert, was der Stromanbieter beispielsweise über das Radio ankündigt. Hier wäre es wichtig, vorab ein entsprechendes Vorgehen im Team festzulegen. Dazu gehört beispielsweise, dass die Praxis ein batteriebetriebenes oder Kurbelradio besitzt, mit dem die Praxis weitere Informationen erhalten kann. An Taschenlampen sollte ebenfalls gedacht werden. Die Patientinnen und Patienten müssten dann ihren Praxisbesuch um ein paar Stunden oder auf den nächsten Tag verschieben. Für Not-
fälle stehen die regional zuständigen Krankenhäuser zur Verfügung.
Schutz vor Datenverlust
Überaus wichtig, um dem Horror eines Datenverlusts zu entgehen, ist eine unterbrechungsfreie Stromversorgung (USV). Diese basiert auf Akkus, die so gesteuert werden, dass sie eine Stromunterbrechung abpuffern und bei einem Ausfall der Stromversorgung das ordnungsgemäße Herunterfahren des Computers sicherstellen. Auf diese Art werden nicht nur die Computer geschützt, die auf ein ungeregeltes Ausschalten sensibel reagieren oder gar Schaden nehmen können, das Abpuffern der IT kann auch vor Datenverlusten bewahren. Solche Geräte sind im Handel erhältlich und einfach zu installieren. Falls es einen Blackout geben sollte, also einen plötzlichen, flächendeckenden Stromausfall von unbestimmter Dauer, würden die Behörden den Katastrophenfall ausrufen. Zuständig wären die jeweiligen Katastrophenschutzbehörden; dies könnten die Landratsämter und Bürgermeisterämter der Stadtkreise beziehungsweise das Regierungspräsidium und das Innenministerium sein. Sie würden die zentrale Gesundheitsversorgung steuern. An den Krankenhäusern und anderen zentralen Orten würde eine Gesundheitsversorgung eingerichtet werden. Einen Blackout beurteilen Experten als sehr unwahrscheinlich. Vor allem, wenn jetzt die Temperaturen wieder steigen, sinkt das Risiko noch einmal, da dann auch weniger Strom verbraucht wird. Falls es wirklich zu einer Überlastung der Strominfrastruktur kommen sollte, würden eher rollierende Abschaltungen greifen. Dann würde die Stromversorgung einzelner Gebiete abwechselnd runtergefahren werden.
440 ÄBW 07 | 2023 Kammern und KV
management akademie der Kassenärztlichen Vereinigung Baden-Württemberg Anzeige
Julia Alber
Szenario eines Stromausfalls im Praxisalltag
Foto: gguy –stock.adobe.com
Krisenvorsorge für Stromausfälle
Ein Unternehmen der LBBW-Gruppe
Lücke in der Altersvorsorge? Nutzen Sie die Steuervorteile der BasisRente.
Beitragszahlungen für die BasisRente sind bereits ab diesem Jahr (und nicht erst 2025) im Rahmen der gesetzlichen Höchstgrenzen zu 100 % steuerlich absetzbar. Das ist eine gute Nachricht für alle, die eine Lücke in ihrer Altersvorsorge schließen möchten.
Optimale Altersvorsorge besteht aus vielen Bausteinen.
Nach einem erfüllten Arbeitsleben den gewohnten Lebensstandard aufrechterhalten – wer möchte das nicht? Aber: Stimmen bei Ihnen die finanziellen Voraussetzungen dafür? Aktuell gibt es einen guten Grund mehr, die eigene Altersvorsorge auf den Prüfstand zu stellen: Die volle steuerliche Absetzbarkeit von Beiträgen zur BasisRente im Rahmen der vorgegebenen Höchstgrenzen für Aufwendungen für die Altersvorsorge wurde von 2025 auf 2023 vorgezogen. Das ist besonders interessant für Ärzte und Zahnärzte, von denen wohl viele mit einer »Lebensstandardlücke« rechnen müssen. Aufgrund der demografischen und volkswirtschaftlichen Entwicklung (Inflation) wird für sie als Ruheständler die Summe aus Leistungen des Versorgungswerks plus sonstige Einnahmen (zum Beispiel aus einer privaten Altersversorgung oder Mieteinkünften) nicht ausreichen, um den aus der aktiven Berufsphase gewohnten Lebensstandard weiterzuführen. Eine BasisRente mit lebenslang garantierten monatlichen Zahlungen kann diese künftige Lücke schließen.

BasisRente bietet viele Gestaltungsmöglichkeiten.
Die private Rentenversicherung nach dem Rürup-Modell bietet zahlreiche Gestaltungsmöglichkeiten, um sie auf Ihre individuellen Bedürfnisse und Vorstellungen auszurichten. So können die Beiträge in Raten oder auf einmal entrichtet werden und Zuzahlungen in bestehende Verträge sind jederzeit möglich. Auch ist der Beginn der Rentenphase frei wählbar vom vollendeten 62. bis zum 85. Lebensjahr.
In welcher Form die BasisRente am besten zu Ihnen passt, ermitteln unsere Finanzberater Medizin in einem Beratungsgespräch. Mithilfe eines speziellen Beratungstools für Mediziner wird Ihre persönliche Situation analysiert und gemeinsam mit Ihnen eine ganzheitliche Vorsorgelösung aus verschiedenen Bausteinen entwickelt. Dabei wird die steuerliche Optimierung ebenso berücksichtigt wie ein Berufsunfähigkeits- und Hinterbliebenenschutz. Zum Schluss noch ein Tipp: Für Eheleute gilt eine Höchstgrenze von 53.056,00 EUR für den Sonderausgabenabzug. Schöpfen Sie die Freibeträge voll aus – auch damit Ihr Partner angemessen abgesichert ist. Mehr Informationen unter www.bw-bank.de/altersvorsorge

Altersvorsorge
Private Zusatzvorsorge (z. B. Riester-Rente, bAV)
Geförderte Zusatzvorsorge
Basisvorsorge (BasisRente)
Von Grund auf gut absichern: das 3-Schichten-Modell der Altersvorsorge
Basisvorsorge, geförderte Zusatzvorsorge und private Zusatzvorsorge: Mit unseren maßgeschneiderten Angeboten nutzen Sie alle Möglichkeiten für eine sichere Rentenzukunft.
Sie möchten mehr wissen über die BasisRente und die vielen Möglichkeiten einer Altersvorsorge?
Kontaktieren Sie uns unter:
Telefon 0711 124-45019
heilberufe@bw-bank.de
www.bw-bank.de/heilberufe
Werbung
Meike Alber Fokusberaterin Medizin, Tübingen
Gleichzeitige
Clinician Scientists Programm ICON
Die Medizinische Fakultät Mannheim der Universität Heidelberg fördert mit ihrem Programm für klinische und translationale Forschung
„ICON“ (Interfaces and Interventions in Complex Chronic Conditions) die Ausbildung von Clinician Scientists, die beinahe ohne Zeitverlust parallel zur Facharztweiterbildung absolviert
werden kann. Möglich macht dies eine besondere Vereinbarung mit der Bezirksärztekammer Nordbaden im Rahmen eines gemeinsamen Pilotprojektes, durch die – wenn bestimmte Kriterien erfüllt sind – bis zu zwölf Monate Forschungszeit auf die Facharztweiterbildung angerechnet werden können.
Jetzt hat der erste Absolvent des ICON-Programms seine Facharztweiterbildung abgeschlossen: Der klinisch tätige Arzt und Wissenschaftler Dr. Manuel Winkler, M. Sc. erhielt Mitte Juni sein Facharztzeugnis aus den Händen des Präsidenten der Bezirksärztekammer Nordbaden, Professor Dr. Dr. Christof Hofele.
Die Weiterbildung zum Facharzt dauert je nach Fachgebiet mindestens vier bis sechs Jahre. Wird der Arztberuf nicht in Vollzeit ausgeübt, so verlängert sich die Weiterbildung entsprechend. Die lange Weiterbildung stellt ein Dilemma für die Ausbildung von Clinician Scientists – klinisch tätigen Ärzten, die auch ernsthaft wissenschaftlich forschen – dar.
Die Absolventen des dreijährigen Programms ICON werden für rund die Hälfte der Zeit von klinischen Aufgaben
KVBW-Vorstand gratuliert Marburger Bund zum Honorarergebnis

freigestellt, um sich ihrer Forschung widmen zu können. Nach aktuellen Regularien würden den Absolventen des Programms von den insgesamt 18 Monaten Forschungszeit nur sechs Monate auf die Facharztweiterbildung angerechnet. „Mit unserem Pilotprogramm haben wir diese Zeit verdoppelt – für die Absolventen des ICON-Programms bedeutet dies faktisch einen Gewinn von einem halben Jahr Weiterbildung“, sagte Professor Hofele. „Es geht uns darum, mehr junge Ärzte dafür zu gewinnen, die Arbeit am Patienten mit der Forschung im Labor zu verbinden“, erläuterte er die Motivation der Bezirksärztekammer Nordbaden. Aufgrund des demografischen Wandels sei ein Anstieg von komplexen chronischen Erkrankungen zu erwarten, betonte Professor Dr. Matthias Ebert, Direktor der II. Medizinischen Klinik der Universitätsmedizin Mannheim und Sprecher des ICONProgramms. Die verkürzte Weiterbildung im Rahmen des Pilotprogramms der Bezirksärztekammer Nordbaden sorge letztlich dafür, die Versorgung dieser stetig wachsenden Patientengruppe durch forschende Fachärztinnen und -ärzte zu verbessern.
Der Vorstand der Kassenärztlichen Vereinigung Baden-Württemberg (KVBW) hat dem Marburger Bund zum Ergebnis bei den Tarifverhandlungen gratuliert. Vorstandschef Dr. Karsten Braun sagte dazu Ende Mai: „Der Marburger Bund hat für seine Mitglieder gegenüber den Kommunalen Kliniken ein Plus von 8,8 Prozent verhandelt. Das ist angesichts der Leistung der Ärztinnen und Ärzte in den Kliniken ein angemessenes Verhandlungsergebnis.“ Er freue sich für die Klinikärztinnen und -ärzte, aber es erhöhe den Druck auf die ambulante Versorgung.
Seine Vorstandskollegin Dr. Doris Reinhart erläuterte: „Klar ist, dass es
damit weniger attraktiv wird, in die ambulante Versorgung zu gehen. Wenn Ärzte im Krankenhaus mehr verdienen, werden sie es sich überlegen, in eine Praxis zu wechseln. Und weiter wird es den Druck auf die Praxen erhöhen, die selbst Ärzte oder Psychotherapeuten als Angestellte beschäftigen. Denn auch da wird die Frage nach einer Gehaltserhöhung im Raume stehen.“
Weiter werde es schwieriger, junge Ärztinnen und Ärzte zu finden, die während ihrer Facharztweiterbildung auch in eine Praxis gehen wollen. „Hier ist es vorgesehen, dass die Ärztinnen und Ärzte in der Praxis vergleichbar viel wie im Kranken-
haus verdienen. Wir sehen die Auswirkungen des Ergebnisses auf den ambulanten Sektor, der das Rückgrat für die Versorgung ist, daher mit Sorge.“
Beide Vorstände forderten denn auch, dass sich das Ergebnis für die Klinikärzte auch in den Honorarrunden für die ambulante Versorgung in diesem Jahr wiederfinden müsse. „Da muss sich deutlich etwas tun, sonst fallen wir hinten runter.“ Die Vorstände verwiesen auch darauf, dass die Kosten für angestellte medizinische oder nicht-medizinische Beschäftigte bisher in der Vergütungssystematik nicht berücksichtigt sind. Auch hier müsse nachgebessert werden.
442 ÄBW 07 | 2023 Kammern und KV
„Sehen die Auswirkungen mit Sorge“
Ausbildung zum Clinician Scientist und Facharztweiterbildung
Dr. M. Winkler und Prof. Dr. Dr. C. Hofele
Foto: Universitätsmedizin Mannheim
Kompaktes Unterstützungs- und Nachschlagewerk
Hygiene in der Arztpraxis
Während der Corona-Pandemie mussten viele Schutzmaßnahmen etabliert und mehrfach angepasst werden, um die Verbreitung des Virus so gut wie möglich einzudämmen. Nach über drei Jahren ist die Pandemie nun – auch „offiziell“ – vorbei. Alle verbindlichen flächendeckenden Maßnahmen wurden aufgehoben und die Hygiene in medizinischen Einrichtungen kann wieder auf das „normale Niveau runtergefahren“ werden. Dies ist ein guter Zeitpunkt, die Hygienemaßnahmen in der eigenen Praxis zu überdenken und gegebenenfalls anzupassen.
Auch wenn die Pandemie eindeutig im Vordergrund stand, gab es in den letzten Jahren rund um die Hygiene und den Umgang mit Medizinprodukten verschiedene rechtliche Änderungen, die auch für Arztpraxen relevant sind: Hierunter fallen beispielsweise die Impfpflicht gegen Masern, das neue EU-weite Medizinprodukterecht und neue beziehungsweise überarbeitete
Empfehlungen der Kommission für Krankenhaushygiene und Infektionsprävention beim Robert Koch-Institut. Diese Änderungen waren für das Kompetenzzentrum Hygiene und Medizinprodukte der Kassenärztlichen Vereinigungen und der Kassenärztli-
chen Bundesvereinigung Anlass, die erstmals im Jahr 2014 veröffentlichte und im Jahr 2019 überarbeitete Broschüre „Hygiene in der Arztpraxis. Ein Leitfaden“ neu aufzulegen. Der Hygieneleitfaden, welcher bereits als kompaktes Unterstützungsund Nachschlagewerk bundesweit in Arztpraxen etabliert und weit über diesen Kreis hinaus auf breites Interesse gestoßen ist, liegt nun als dritte Auflage in der bewährten Kapitelstruktur vor. Die erwähnten Neuerungen zu rechtlichen Grundlagen, dem Arbeitsschutz sowie zum Hygieneund Medizinproduktemanagement wurden eingearbeitet. Dabei wurden auch Themen wie beispielsweise Hygiene bei immunsupprimierten Patienten neu aufgenommen. Weiter informiert der Hygieneleitfaden über das digitale Prozedere zu meldepflichtigen Krankheitserregern oder zu Vorkommnissen mit Medizinprodukten bei der Übermittlung an die zuständigen Behörden.

Kassenärztliche Vereinigung möchte Radius auf KV-Bereich ausdehnen
MVZ-Regulierung
Die Kassenärztliche Vereinigung Baden-Württemberg (KVBW) hat den Vorstoß der drei Bundesländer Bayern, Rheinland-Pfalz und Schleswig-Holstein begrüßt, die Bundesregierung dazu zu bringen, endlich ein MVZ-Regulierungsgesetz vorzulegen. Die im Antrag der Bundesländer vorgesehene räumliche Beschränkung sei jedoch zu kleinräumig gedacht.
„Es ist richtig und gut, dass die Bundesregierung mit dem geplanten MVZ-Regulierungsgesetz den systemfremden und systemschädlichen Interessen von Kapitalinvestoren entgegentreten will. Einige Punkte sollten aber, wie im Eckpunktepapier der drei Bundesländer vorgesehen, nachgebessert werden“, sagte der KVBW-Vorstandsvorsitzende Dr. Karsten Braun. Für zentral hielt er die Kennzeichnungspflicht und das MVZ-Register mit Offenlegung nachgelagerter Inhaber-
strukturen, mit dem die notwendige Transparenz erreicht wird.
Auch weitere Kriterien wie die im Antrag vorgesehene Begrenzung der Versorgungsanteile von MVZ-Gruppen auf 25 Prozent bei Hausärzten und 50 Prozent bei Facharztgruppen sowie die Möglichkeit für Kassenärztliche Vereinigungen, Disziplinarmaßnahmen gegen MVZ-Betreiber zu verhängen, seien begrüßenswert. Das gelte auch für die Stärkung der ärztlichen Leitung und die Möglichkeit zur Übertragung von Zulassungen aus Eigeneinrichtungen der Kassenärztlichen Vereinigungen an die dort angestellten Ärzte, um die Niederlassung zu fördern.
Grundsätzlich befürwortete Dr. Braun auch die Einschränkung bundesweit agierender MVZ-Ketten. Die dafür vorgesehene räumliche Begrenzung auf einen Radius von 50 Kilometer hielt er jedoch für zu kleinräu-
mig gedacht. „Ich befürworte es, dass beispielsweise ein Besitzer einer Acht-Betten-Klinik auf einer kleinen Nordseeinsel nicht in ganz Deutschland eine MVZ-Kette betreiben kann. Aber den Radius auf nur 50 Kilometer festzulegen, ist unrealistisch. Er sollte auf das jeweilige Bundesland beziehungsweise den jeweiligen KV-Bereich ausgedehnt werden.“ In Einzelfällen beziehungsweise je nach Versorgungsbedarf müsste auch eine Ausweitung auf angrenzende Regionen möglich sein, sagte Dr. Braun.
Eine gelegentlich von anderer Seite geforderte Einschränkung auf nur fachübergreifende MVZ hielt er ebenfalls nicht für zielführend: „Sie bildet in Zeiten des Ärztemangels unter Umständen regional erforderliche Versorgungskonzepte nicht ab und erfüllt keinen Schutzzweck gegenüber Kapitalinvestoren.“
ÄBW 07 | 2023 443 Kammern und KV
Download des Leitfadens bei der Kassenärztlichen Vereinigung Baden-Württemberg
Spitzen ärztlicher Körperschaften schlossen sich Forderungen von Berufsverbänden an
Solidarität mit Ärzteprotest

Ende Juni fand auf dem Stuttgarter Schlossplatz eine Protestaktion der niedergelassenen Ärzteschaft und Psychotherapeutinnen und -therapeuten mit ihren Praxisteams sowie Patientinnen und Patienten statt. Veranstalter waren mehrere ärztliche und psychotherapeutische Verbände. Die rund 3.000 Teilnehmenden skandierten immer wieder das Motto der Zusammenkunft: „Ärzteprotest: Jetzt reicht‘s!“





Bereits im Vorfeld hatte Dr. Wolfgang Miller, Präsident der Landesärztekammer Baden-Württemberg, erklärt: „Der Landesärztekammer BadenWürttemberg ist es als Körperschaft des öffentlichen Rechts formal nicht möglich, zu derartigen Protestveranstaltungen aufzurufen. Gleichwohl: Unser Auftrag als Ärzteschaft ist eine gute Versorgung der Menschen, die sich uns anvertrauen. Die Ärztinnen und Ärzte wollen mit ihrer Protestaktion auf politische Fehlentscheidungen aufmerksam machen, die unmittelbar unsere Arbeit eingreifen und sie immer schwieriger machen.“ Auf der

Veranstaltungsbühne sagte er dann zum Beifall der Besucher: „Die Landesärztekammer Baden-Württemberg hat großes Verständnis für den Protest und erklärt sich solidarisch mit den protestierenden Ärztinnen und Ärzten.“
Auch die Kassenärztliche Vereinigung Baden-Württemberg unterstützte das Event und schloss sich den Forderungen der Berufsverbände an. Beide KV-Vorstände überbrachten den Protestlern symbolisch ein „Solidaritäts“-Paket. Vorstandschef Dr. Karsten Braun sagte: „Die Politik sollte es ernst nehmen, wenn die Ärzteschaft quer durch die Berufsverbände zu einer zentralen Protestaktion aufruft. Die Praxen der niedergelassenen Ärztinnen und Ärzte stellen das Rückgrat der medizinischen Versorgung dar. Wenn hier die Versorgung als gefährdet angesehen wird, ist das mehr als ein Alarmzeichen.“ Seine Vorstandskollegin Dr. Doris Reinhardt forderte ein Umdenken in der Versorgung. „Es ist mehr als nachvollziehbar, dass die Kolleginnen und Kollegen frustriert
sind und das Gefühl haben, mit ihren Anliegen nicht ernst genommen zu werden.“
In zahlreichen kämpferischen Wortbeiträgen kritisierten die Verbände unter anderem, dass die Berliner Politik dafür sorge, dass Patientinnen und Patienten mehrere Monate auf einen Facharzttermin warten müssen, dass durch mehr Bürokratie in den Praxen immer weniger Zeit für sprechende Medizin bleibe und dass immer mehr Praxen schließen müssten.
Termin-Glücksrad als Realsatire Für die Demonstrierenden sowie die Bürgerinnen und Bürger stand am Rande der Protestveranstaltung auf dem Stuttgarter Schlossplatz ein Glücksrad bereit. Dort hatten alle die Chance, einen Arzttermin zu gewinnen. Termine im laufenden Jahr waren allerdings mehr als rar. Wer sich einen Termin im nächsten Jahr erspielte, erhielt eine Packung Studentenfutter als Nervennahrung. Und wer Pech hatte, bekam nur ein Trostpflaster.
444 ÄBW 07 | 2023 Kammern und KV
Fotos: OE
Kammerpräsident Dr. W. Miller
KV-Vorstände Dr. D. Reinhardt und Dr. K. Braun
Initiator des Protesttags war Dr. Michael Eckstein, hausärztlicher Internist aus Reilingen. Er hatte die Anwesenden zu Beginn mit deutlichen Worten eingestimmt: „Wir haben bisher stillgehalten: Wir mussten die unsägliche Telematikinfrastruktur unter Strafandrohung einführen, wir haben den Großteil der Patienten in der Coronapandemie versorgt und die Krankenhäuser vor dem Zusammenbruch gerettet. Wir erdulden eine uralte GOÄ und den Diebstahl von Honoraren. Aber damit ist jetzt Schluss! Uns reicht‘s!“






Der MEDI-Vorsitzende Dr. Werner Baumgärtner stellte im Verlauf der Kundgebung eine ernüchternde Diagnose: „Das Gesundheitssystem ist krank! Die politisch verantwortete Budgetierung, die Zwangsdigitalisierung, die gesetzliche Reglementierung und die Überbürokratisierung zerstören die Praxen.“ Seine düstere Prognose: „Niedergelassene Praxen können schon
heute nicht mehr nachbesetzt werden – und das ist erst der Anfang…!“
Es folgten zahlreiche weitere Redebeiträge von Ärztinnen und Ärzten aus allen Teilen Baden-Württembergs. Alle Vortragenden nahmen kein Blatt vor den Mund und schilderten eindrückliche ihr persönliches Erleben von verfehlter Gesundheitspolitik und den dramatischen Folgen. So sprach unter anderem Dr. Cathérine Hetzer-Baumann von Young MEDI, der Vorsitzende des Spitzenverbandes der Fachärztlichen Berufsverbände Baden-Württemberg Dr. Bernd Salzer, Dr. Christiane von Holst vom Berufsverband der Frauenärzte, der Präsident des Berufsverbandes der Orthopäden und Unfallchirurgen Dr. Burkhard Lembeck, der Vorsitzende des Landesverbandes der Kinder- und Jugendärzte Dr. Roland Fressle oder auch der designierte MEDIVorsitzende Dr. Norbert Smetak. Ebenfalls auf der Bühne: die beiden Co-Vorsitzenden des Hausärzteverbandes Baden-Württemberg, Prof. Dr. Nicola Buhlinger-Göpfarth und Dr. Susanne
Die Veranstalter
MEDI Verbund, Hausärzteverband, Spitzenverband der Fachärztlichen Berufsverbände, Berufsverband der Kinder- und Jugendärzte, Berufsverband der Frauenärzte, Hessenmed, Berufsverband für Orthopädie und Unfallchirurgie, Berufsverband Deutscher Internistinnen und Internisten, Berufsverband der Deutschen Urologie, Dentimed
Bublitz. Sie kritisierten plastisch die „politische Tatenlosigkeit“, konstatierten das völlige Versagen der (Gesundheits-) Politik und forderten vehement ein bezahlbares Gesundheitswesen.
Lob für Medizinische Fachangestellte
Immer wieder lobten alle Ärztinnen und Ärzte ihr Personal, das in den Praxen stets mithilft, untersucht und tröstet, das aber viel zu häufig von Patienten auch beschimpft wird. Dies bestätigte mit einem eindrucksvollen Redebeitrag die Medizinische Fachangestellte Petra Schäfer aus Herrenberg: sie erinnerte die aufmerksam Zuhörenden daran, dass ihr Berufsstand während der Pandemie „Schwerstarbeit unter schwierigen Bedingungen“ geleistet hatte. Doch ein Corona-Bonus war ausgeblieben; die Politik in Berlin hatte den Berufsstand der MFA und deren Leistungen glatt vergessen. So blieb einmal mehr nur wertschätzender Applaus der Großveranstaltung.
Unterm Strich machte der Mittwochmittag in Stuttgart überdeutlich, dass die in der ambulanten Patientenversorgung Tätigen ihre Reihen geschlossen haben. Sie verdeutlichten, dass sich im Gesundheitswesen jetzt unbedingt etwas ändern muss. Ein erster Schritt wäre aus ihrer Sicht die Einführung des Streikrechts für niedergelassene Ärztinnen und Ärzte.

ÄBW 07 | 2023 445 Vermischtes
„Das Gesundheitssystem ist krank!“
Neue Ämter und wichtige Auszeichnungen Namen und Nachrichten
Nobelpreisträger Prof. zur Hausen †

Der Medizin-Nobelpreisträger Prof. Dr. Harald zur Hausen ist am 29. Mai 2023 im Alter von 87 Jahren verstorben. Mit seiner Forschung hatte er die Grundlagen für die Entwicklung einer Schutzimpfung gegen krebserregende humane Papillomviren geschaffen. Im Verlauf seines Forscherlebens war Prof. zur Hausen mit einer beeindruckenden Vielzahl akademischer Auszeichnungen geehrt worden. So war er Träger von fast 40 Ehrendoktorwürden und zahlreicher Ehrenprofessuren. Im Interview hatte der Wahl-Heidelberger dem Ärzteblatt Baden-Württemberg im Januar 2022 verraten, dass er auch in hohem Alter „kein Gefühl von Langeweile verspüre“, weil die Phase nach seiner Emeritierung in wissenschaftlicher Hinsicht die beste Zeit seines Lebens sei.
Hohe Ehre für Prof. Wenz
Die Deutsche Röntgengesellschaft hat Prof. Dr. Frederik Wenz vom Universitätsklinikum Freiburg zum Ehrenmitglied der Fachgesellschaft ernannt. Prof. Wenz ist Leitender Ärztlicher Direktor und Vorstandsvorsitzender des Universitätsklinikums Freiburg. Zuvor hatte er Professuren für Strahlentherapie an der Medizinischen Fakultät Mannheim der Universität Heidelberg inne. Daneben ist und war er in zahlreichen Gremien tätig, etwa als Vorstandsmitglied der Deutschen Krebsgesellschaft, und ist vielfach ausgezeichnet worden.
Wichtiges Amt für Prof. Seufferlein
Das Ministerium für Soziales, Gesundheit und Integration Baden-Württemberg hat Prof. Dr. Thomas Seufferlein, Ärztlicher Direktor der Klinik für Innere Medizin I am Universitätsklinikum Ulm, zum Vorsitzenden des Landesbeirats Onkologie ernannt. Der Beirat berät und unterstützt das Gesundheitsministerium bei der kontinuierlichen und bedarfsgerechten Weiterentwicklung von Versorgungsstrukturen für krebskranke Patienten. Außerdem trägt er wesentlich dazu bei, dass sich die an der Krebsbehandlung beteiligten Akteure landesweit vernetzen und ein interdisziplinärer Dialog stattfindet.
Dr. Maitra wiedergewählt
Der Internist Dr. Robin Maitra aus Hemmingen, Mitglied des Vorstandes der Landesärztekammer Baden-Württemberg, ist in seinem Amt als Vorstandsmitglied der Internationalen Ärztinnen und Ärzte für die Verhütung des Atomkriegs – Ärztinnen und Ärzte in sozialer Verantwortung (IPPNW) bestätigt worden. In der IPPNW engagieren sich Ärzte, Psychotherapeuten sowie Medizinstudierende für eine menschenwürdige Welt frei von atomarer Bedrohung. Frieden ist ihr zentrales Anliegen; dabei leiten sie das ärztliche Berufsethos und das Verständnis von Medizin als einer sozialen Wissenschaft.

Hohe Ämter für Prof. Fritsche und Szendrödi
Prof. Dr. Andreas Fritsche ist ab sofort für zwei Jahre Präsident der Deutschen Diabetes Gesellschaft. Der Diabetologe ist stellvertretender Leiter des Instituts für Diabetesforschung und Metabolische Erkrankungen des HelmholtzZentrums München, Leiter der Abteilung Prävention und Therapie des Diabetes mellitus sowie Leiter der Diabetestherapiestation und Diabetesambulanz an der Universität Tübingen. Vizepräsidentin ist Prof. Dr. Julia Szendrödi, Ärztliche Direktorin der Klinik für Endokrinologie, Diabetologie, Stoffwechselkrankheiten und Klinische Chemie am Universitätsklinikum Heidelberg.


Hohe Auszeichnung für Prof. Henkes
Die Deutsche Röntgengesellschaft hat Prof. Dr. Dr. h.c. mult. Hans Henkes, Ärztlicher Direktor der Neuroradiologischen Klinik im Klinikum Stuttgart, den Alfred Breit-Preis verliehen. Mit dem Preis werden exzellente Arbeiten und Entwicklungen ausgezeichnet, die aus dem Bereich der radiologischen Forschung kommen und erkennbar zu Fortschritten in der Behandlung von gut- und bösartigen Krankheiten beitragen können. Als Grundlage zur Entscheidung für die Preisvergabe können Publikationen oder Patente dienen, aber auch Verfahren, die sich in der Klinik etabliert haben, ohne dass sie publiziert worden sind.
Defizite aller Krankenhäuser in Baden-Württemberg
Für 2023 erwarten die Krankenhäuser im Land ein Defizit von mindestens 620 Millionen Euro. Eine zentrale Ursache ist, dass die überdurchschnittlichen Personal- und Sachkosten der Krankenhäuser in Baden-Württemberg in der Vergütungssystematik der Krankenhäuser schon seit vielen Jahren unberücksichtigt bleiben. Die baden-württembergische Krankenhausgesellschaft visualisiert die Unterfinanzierung im laufenden Jahr mit der Defizit-Uhr auf ihrer Website, die sekündlich aktualisiert wird. Demnach lag das Defizit Anfang Juni bei 70.776 Euro pro Stunde.
Weitere Informationen: www.pain2punkt0.de
Sportweltspiele der Medizin und Gesundheit
Die nächsten Sportweltspiele der Medizin und Gesundheit finden vom 4. bis 11. November 2023 im Norden Kolumbiens statt. Sie bieten den Teilnehmern auch die Möglichkeit, neue Sportarten unkompliziert auszuprobieren. In 20 verschiedenen Sportdisziplinen können die Teilnehmer und Begleiter an den Start zu gehen. Die Sportwettkämpfe werden außer im Mannschaftssport sowie bei Golf in sechs Alterskategorien gewertet. Teilnehmen können Medizinerinnen und Mediziner sowie Kollegen aus Praxis und Verwaltung. Neben den sportlichen Wettkämpfen bietet der internationale Kongress für Sportmedizin einen Erfahrungsaustausch unter Kollegen aus aller Welt.
Weitere Informationen: www.sportweltspiele.de
446 ÄBW 07 | 2023 Vermischtes
Prof. Dr. H. zur Hausen
Prof. Dr. F. Wenz
Prof. Dr. T. Seufferlein
Foto: © Uwe Anspach/DKFZ
Ulm
Dr. R. Maitra
Foto: DRG/Thomas Rafalzyk Foto: Universitätsklinikum
Probleme der elektronischen Krankmeldung
Es läuft noch nicht rund bei der elektronischen Arbeitsunfähigkeitsbescheinigung (eAU). Kürzlich berichtete der Südwestrundfunk über die Situation in Arztpraxen in Baden-Württemberg. Zu Wort kam dabei auch die Landesärztekammer und bemängelte unter anderem, dass Netzwerkstörungen und Softwareprobleme zu Verzögerungen und Systemabstürzen beim Übermittlungsprozess der eAU führten. Ob die Übermittlung erfolgreich war, sei für die Praxisteams oft nicht unmittelbar ersichtlich. Damit unterstrich die Standesvertretung eine zentrale Forderung der Ärzteschaft: Digitalisierung im Gesundheitswesen muss diejenigen, die im System arbeiten, entlasten. Sie darf unter keinen Umständen noch zusätzliche Arbeit machen und für noch mehr Bürokratie sorgen.
Interdisziplinär gegen den Schmerz
Ein neues bundesweites Projekt soll einen interdisziplinären Ansatz zur Behandlung chronischer Schmerzen erproben. „PAIN2.0” will die Versorgung von Erwachsenen mit wiederkehrenden Schmerzen und Risikofaktoren für eine Schmerzchronifizierung verbessern. Das Projekt richtet sich an Menschen mit wiederkehrenden Schmerzen von mehr als sechs Wochen oder häufig wiederkehrenden Schmerzen. In Baden-Württemberg sind die Universitätsklinika Freiburg und Heidelberg als Projektpartner beteiligt.
Weitere Informationen: www.pain2punkt0.de
Hohes Amt für Prof. Döhner

Prof. Konstanze Döhner, Oberärztin an der Klinik für Innere Medizin III am Universitätsklinikum Ulm, ist zur Präsidentin der Europäischen Fachgesellschaft für Hämatologie gewählt worden; das Amt wird sie im Juni 2025 antreten. Die Entschlüsselung der genetischen Grundlagen und deren Bedeutung für die Versorgung von Patienten mit Leukämien sowie die Entwicklung von personalisierten Behandlungsstrategien sind seit vielen Jahren Schwerpunkte ihre Forschungsarbeiten.

Dr. Köhler wiedergewählt
Dr. Dr. Carsten Köhler, Direktor des Kompetenzzentrums Tropenmedizin Baden-Württemberg am Institut für Tropenmedizin, Reisemedizin und Humanparasitologie der Universität und dem Universitätsklinikum Tübingen, ist bereits zum vierten Mal zum Ersten Vorsitzenden der Deutschen Gesellschaft für Tropenmedizin, Reisemedizin und Globale Gesundheit gewählt worden. Damit steht er der wissenschaftlich-medizinischen Fachgesellschaft bereits seit 2016 vor.
Stiftung viamedica preisgekrönt
Das Klimaschutzprojekt „Klimaretter – Lebensretter“ der Freiburger Stiftung viamedica hat den Deutschen Award für Nachhaltigkeitsprojekte erhalten und den ersten Platz in der Kategorie Aufklärung/Bildung erreicht. Der Preis würdigt herausragende Projekte, die Nachhaltigkeit vorbildlich umsetzen. Die Jury bewertete das Klimaschutzprojekt als „spannendes Tool mit großer Reichweite, welches im Gesundheitssektor neue Zielgruppen anspricht und ein breit gefächertes Angebot für Initiativen zur Emissionsreduzierung bietet.“
Ideal für mobiles Arbeiten
Patienteninfor-
Die Praxissoftware medatixx kann mehr als Desktop. Mit ihr betreuen Sie Patientinnen und Patienten bequem an einem beliebigen Ort in Ihrer Praxis, auf Hausbesuchen oder aus den eigenen vier Wänden. Hausarztpraxen dürfen sich über ein passendes Vorteilspaket freuen:
Neben den Grundfunktionen enthält das Angebot den mobilen Datenzugriff, sechs Zugriffslizenzen, eArztbrief, DMPs, Terminplaner und vieles mehr.
Sparen Sie jetzt monatlich 75,00 € und erhalten Sie das Vorteilspaket dauerhaft für 220,00 €*.
Jetzt zugreifen und Angebot sichern: mein.medatixx.de/hausaerzte
ÄBW 07 | 2023 447 Vermischtes
Prof. Dr. K. Döhner
Dr. Dr. C. Köhler
Anzeige
mationen überall griffbereit.
* Preis monatlich, zzgl. MwSt. Mindestvertragslaufzeit 12 Monate. Angebotsbedingungen siehe: mein.medatixx.de/hausaerzte
Vorteilspaket für Hausärztinnen und Hausärzte
„Wohnen in grüner Oase!“ Ruhige und sonnige Randlage!
• Modernes EFH, 152 m² Wfl.
• 6 Zimmer
• Südgarten in Randlage
• GEG 2023 / LWWP
• Garage möglich
Schlüsselfertig: € 894.660,–
„DHH in herrlicher Umgebung angrenzend zur Natur!“
• 145 m² Wfl.
• 273 m² Grdst.
• GEG 2023 / LWWP
• Kiga, Schule, Einkaufen in Fußnähe
Schlüsselfertig: € 673.282,–


„Sonnig und ruhig wohnen!“ Attraktives EFH mit großem Garten
• 135 m² Wfl., 6 Zimmer






• 276 m² Grundstück
• Südgarten
• Wohnen auf 2 Ebenen
• GEG 2023/LWWP
Schlüsselfertig: € 822.852,–
„Viel Platz für die Familie!“ Großzügiges EFH in beliebter Lage
• 198 m² Wfl., 7 Zimmer
• GEG 2023/LWWP
• Südterrasse und -garten
• Garage und Stellplatz möglich
Schlüsselfertig: € 929.780,–
„Familienfreundliches Wohnen mit herrlichem Südgarten!“ Großzügiges, sonniges EFH
• 6 Zimmer verteilt auf 178 m² Wohnfläche
• 334 m² Grundstück
• Doppelgarage möglich
• GEG 2023/LWWP
Schlüsselfertig: € 957.918,–
„Wohnen in herrlicher Aussichtslage!“ Moderne DHH
• 170 m² Wfl., 6 Zimmer


• 266 m² Grundstück
• GEG 2023/LWWP
• Wohnen auf 2 Ebenen mit Fernblick auf die Alb
Schlüsselfertig: € 793.662,–
„Wohnen in Randlage!“ Großzügiges EFH mit großem Garten
• ca. 190 m² Wfl., 429 m² Grdst.
• 6 Zimmer, 2 Bäder
• Sonnige Süd-/West-Lage!
• GEG 2023/LWWP
• Garage/Stellplatz möglich
Schlüsselfertig: € 991.750,–
• 160 qm Wfl., 6 Zimmer
• Nur 15 Minuten nach Böblingen & Sindelfingen
• GEG 2023 / LWWP
• Garage möglich
Schlüsselfertig: € 780.338,–
•
Immobilien Experten für Grundstücke und Häuser Sichern Sie sich jetzt:
den bestmöglichen Preis
•
eine sichere und schnelle Abwicklung
eine kostenlose Wertanalyse
Sie uns! 0711 - 72 20 90 30 www.gutimmo.de info@gutimmo.de „Sie wollen Ihren Bauplatz (auch Abbruch) verkaufen? gut Immobilien GmbH Große Falterstraße 101 70597 Stuttgart-Degerloch
Rosswälden LEONBERG AICHTAL -Grötzingen
WEIL im Schönbuch AFFALTERBACH HILDRIZHAUSEN
•
Kontaktieren
S-ZAZENHAUSEN EBERSBACH-
SCHÖNAICH
„Lassen Sie Ihre Träume von den eigenen vier Wänden wahr werden“
unverbindliche Illustration unverbindliche Illustration unverbindliche Illustration unverbindliche Illustration unverbindliche Illustration Grundstück Blick zum Bauplatz unverbindliche Illustration „Wohnen in traumhafter Lage!“ Moderne DHH angrenzend an die Natur
Vergleichbarkeit zwischen Kliniken möglich
CO₂-Rechner für Gesundheitseinrichtungen
Der Gesundheitssektor trägt laut Hochrechnungen mehr als fünf Prozent zum CO₂-Ausstoß in Deutschland bei. Krankenhäuser haben einen wesentlichen Anteil daran, allerdings sind die Emissionen bislang nur unzureichend erfasst. Nun hat das Universitätsklinikum Freiburg gemeinsam mit dem Öko-Institut unter Förderung der Deutschen Bundesstiftung Umwelt einen Open-AccessCO₂-Rechner veröffentlicht.
Mit dem Rechner können Krankenhäuser detailliert und nach internationalen Standards ihre CO₂-Bilanz erstellen. Damit wird eine bessere Vergleichbarkeit unterschiedlicher Gesundheitseinrichtungen möglich. Die Emissionen des Universitätsklinikums Freiburg, die dem laufenden Krankenhausbetrieb zugerechnet werden können, beliefen sich im Untersuchungsjahr 2019 auf 104.000 Tonnen CO₂-Äquivalente. Das ent-
sprach bei 1.616 Betten einem CO₂Ausstoß von 64,36 Tonnen CO₂ pro Krankenhausbett. Die CO₂-Bilanz enthält Emissionen im Bereich Energie, Mobilität, Ernährung, aber auch solche, die bei Herstellung und Transport von Medikamenten und medizinischen Verbrauchsmaterialien entstehen.
Mit rund 53.000 Tonnen CO₂Äquivalenten entsteht der größte Anteil bei Herstellung, Transport und Nutzung von Gütern und Dienstleistungen, die das Universitätsklinikum einkauft. Bei der Eigenproduktion von Wärme, Kälte und Strom, die im Klinikum genutzt werden, entstehen etwa 33.000 Tonnen CO₂-Äquivalente. Etwa 5.000 Tonnen der Emissionen entfallen auf Transporte von Patientinnen und Patienten. Zusätzlich entstehen bei der Produktion von Fernwärme für weitere Landeseinrichtungen wie die Universität Freiburg im Heizkraftwerk
des Klinikums rund 41.000 Tonnen Treibhausgase. Für diese Bilanz hat das Öko-Institut Verbrauchsdaten des Universitätsklinikums Freiburg aus dem Jahr 2019 ausgewertet. Das Universitätsklinikum Freiburg ist Unterzeichner der WIN-Charta und treibt den Umbau zum nachhaltigen Krankenhaus seit vielen Jahren voran. So werden durch die Nutzung von Motor- und Abgaswärme im Heizkraftwerk jährlich rund 5.000 Tonnen CO₂eingespart. Klimaschädliche Narkosegase wurden in der Anästhesie ersetzt, reduziert und, wo möglich, recycelt, was zu einer Reduktion um mehr als 450 Tonnen CO₂-Äquivalente jährlich beiträgt. Baumaßnahmen wie die passive Gebäudekühlung mit Schwarzwaldgrundwasser, der Einsatz von regionalem Holz als Baustoff und der Ausbau großer Photovoltaik-Anlagen tragen ebenfalls zur Ressourcenschonung bei.
Hausärzteverband Baden-Württemberg fordert zügige Umsetzung des Masterplans
Stärkung der Allgemeinmedizin im Studium
Wie aus einem Referentenentwurf des Bundesministeriums für Gesundheit hervorgeht, soll der Masterplan Medizinstudium 2020, der unter anderem eine Stärkung der Allgemeinmedizin im Studium durch eine Reform der Ärztlichen Approbationsordnung (ÄApprO) vorsieht, nun im Jahr 2027 umgesetzt werden. Bisher wurde die Reform durch die Länder aus Kostengründen verschleppt. Der Hausärzteverband Baden-Württemberg hat den neuen Anlauf begrüßt und eine zügige Umsetzung gefordert.
„Wir verlieren wertvolle Zeit, die wir nicht haben. Bereits jetzt fehlen über 800 Hausärztinnen und Hausärzte in Baden-Württemberg und fast 40 Prozent aller Kolleginnen und Kollegen sind über 60 Jahre alt“, sagte Prof. Dr. Nicola Buhlinger-Göpfarth, Vorstandsvorsitzende des Hausärzte -
verbands Baden-Württemberg. „Wir müssen jetzt dafür sorgen, dass auch in Zukunft ausreichend Hausärztinnen und Hausärzte die Bevölkerung versorgen können und hierfür ist ein wichtiger Schritt, dass die Allgemeinmedizin im Studium gestärkt wird, wie es der Masterplan vorsieht. Dass gerade diese wichtige Reform über Jahre verschleppt wird, ist unverantwortlich“, kritisierte sie. Dass Kostendiskussionen, die auf Basis überzogenerer Szenarien geführt wurden, über die Sicherung einer hochwertigen hausärztlichen Versorgung gestellt werden, sei skandalös.
Um die Kosten zu reduzieren, wurde der Masterplan nun deutlich abgespeckt. Die stationären Blockpraktika und das Blockpraktikum in der Allgemeinmedizin sollen von jeweils sechs auf fünf Wochen gekürzt werden und auch eine im letzten Staatsexamen
verpflichtende Prüfung in der Allgemeinmedizin ist nicht vorgesehen. Die Co-Vorstandsvorsitzende Dr. Susanne Bublitz kommentierte: „Die Kürzung von Praktika geht aus unserer Sicht komplett an dem eigentlichen Ziel vorbei, die Praxisnähe des Studiums zu erhöhen und die Allgemeinmedizin zu stärken. Auch dass die Reform nun erst 2027 greifen soll, ist eigentlich schon viel zu spät. Trotzdem ist auch dieser Entwurf eine Verbesserung zum aktuellen Zustand. Wichtig ist jetzt, dass die Neuregelung der ärztlichen Ausbildung zügig umgesetzt und nicht noch weiter aufgeweicht wird und so noch mehr Elemente, die die Allgemeinmedizin stärken sollen, verloren gehen. Es muss klar sein, dass eine Aufwertung der Allgemeinmedizin im Studium eine notwendige Investition in unsere Gesundheitsversorgung von morgen ist.“
ÄBW 07 | 2023 449 Vermischtes
Open-AccessCO₂-Rechner
Aktionstag warnte vor finanzielle Schieflagen und heftigen Insolvenzwellen
Alarmstufe Rot in Krankenhäusern

Die Lage in den Krankenhäusern im Land ist ernst: Die Personal- und Sachkosten steigen, die Einnahmen halten nicht mehr mit. In der Folge drohen finanzielle Schieflagen und – sofern sich nichts ändert –heftige Insolvenzwellen. Was dies für die Versorgung und die Gesundheit der Menschen bedeuten würde, ist nicht auszudenken.
Um auf diese „Alarmstufe Rot“ in den Krankenhäusern aufmerksam zu machen, veranstalteten die Kliniken Ende Juni einen bundesweiten Protesttag. Das Ziel: die Politik aktiv zum Handeln gegen das drohende Krankenhaussterben auffordern und die breite Öffentlichkeit für die Brisanz der Lage sensibilisieren. In Baden-Württemberg
Virchowbund erweitert Angebot um Stellenbörsen
Online zum Job in der Arztpraxis
R und 75 Prozent aller Arztpraxen haben Schwierigkeiten, offene Stellen zeitnah zu besetzen. Um es Praxisinhabern leichter zu machen, angestellte Ärztinnen und Ärzte sowie Medizinische Fachangestellte zu finden (und umgekehrt) wurden Mitte Juni entsprechende Online-Stellenbörsen auf der Website des Virchowbundes integriert. Je nach Bedarf lassen sich gezielt Positionen für Ärztinnen und Ärzte von der Anstellung bis zur Niederlassung, sowie für Medizinische Fachangestellte und jegliches Praxispersonal finden. Auch die Famulaturbörse des Virchowbundes listet nun Plätze in ganz Deutschland.
Weitere Infos: www.virchowbund.de
schlossen sich die Baden-Württembergische Krankenhausgesellschaft, der Marburger Bund Baden-Württemberg sowie der hiesige ver.diLandesbezirk zu einem Bündnis zusammen und informierten die Öffentlichkeit über die Situation.
Sylvia Ottmüller, Erste Landesvorsitzende des Marburger Bundes Baden-Württemberg, Vorstandsmitglied der Bezirksärztekammer Nordwürttemberg sowie Delegierte der Vertreterversammlung der Landesärztekammer, brachte es vor den versammelten Medienvertretern auf den Punkt: „Das Kliniksystem ist auf Kante genäht und unterfinanziert!“.
Die Fachärztin für Frauenheilkunde und Geburtshilfe gab Einblick in den ärztlichen Alltag und skizzierte die Arbeitsbedingungen der stationär tätigen Kolleginnen und Kollegen: Steigende Arbeitsbelastung, zu wenig Personal, kaum Zeit für Gespräche mit Patienten sowie überbordende Bürokratie seien feste Bestandteile der ärztlichen Arbeit, stellte die Expertin fest. Sie verwies auf eine Mitgliedsumfrage des Marburger Bundes im Südwesten, wonach fast 60 Prozent der Ärztinnen und Ärzte im Durchschnitt pro Arbeitstag bis zu 30 Prozent mit nicht-ärztlichen Verwaltungstätigkeiten beschäftigt seien.
In die vom Bundesgesundheitsminister Prof. Dr. Karl Lauterbach angekündigte Krankenhausreform, die maßgeblich die Strukturen der Krankenhauslandschaft verändern soll (das ÄBW berichtete), hätten viele Ärztinnen und Ärzte zunächst große Hoffnung gesetzt, so Frau Ottmüller. Vor allem habe man gehofft, wieder mehr Zeit für die Patienten zu haben. Bisher ließen konkrete Verbesserungen aber noch auf sich warten.
Heiner Scheffold, Vorstandsvorsitzender der Landes-Krankenhausgesellschaft und Landrat des Alb-Donau-Kreises, verwies auf Ergebnisse des „Krankenhaus Rating Reports“: Demnach seien 29 Prozent der badenwürttembergischen Krankenhäuser von einer Insolvenz bedroht. „Und wenn nichts passiert, werden den Krankenhäusern im Land im Jahr 2023 mindestens 620 Millionen Euro feh-
len“, führte er weiter aus. Auch er ging auf die geplante Krankenhaus-Strukturreform des Bundesgesundheitsministers ein: Diese umzusetzen, dauere Jahre – die Krankenhäuser bräuchten aber schon jetzt dringend Hilfe. Ohne eine baldige Stabilisierung der Finanzlage ergebe eine Strukturreform nur wenig Sinn. Es drohe ein kalter Strukturwandel mit einem massiven Abbau der Klinikleistungen.
Irene Gölz, Landesfachbereichsleiterin Gesundheit von ver.di, sagte: Die ordentliche Tarifbindung vieler Krankenhäuser im Land dürfe kein Nachteil sein und müsse zwingend refinanziert werden. Ebenfalls sei noch mehr Belastung für das Personal nicht akzeptabel. „Was die Beschäftigten brauchen, ist weniger Arbeitsverdichtung und mehr Kolleginnen und Kollegen.“
Die Bündnispartner forderten aktives Eingreifen der Politik: Die Bundesregierung solle durch ein sogenanntes, der Krankenhaus-Strukturreform vorangestelltes „Vorschaltgesetz“ die wirtschaftliche Lage der Kliniken fair und verlässlich sichern. Auch ein wirksamer Inflationsausgleich und die Refinanzierung von Tarifkostensteigerungen gehörten zur Lösung. Das Land Baden-Württemberg wurde in die Pflicht genommen, seinen notwendigen Investitionen in die Krankenhäuser umfangreicher nachzukommen. Die Stoßrichtung der Lösungsansätze war klar: Erst (finanziell) stabilisieren, danach Strukturen reformieren.
Auch an der Strukturreform an sich äußerte das Bündnis Kritik: Bundesgesundheitsminister Lauterbach solle die Kliniken als die von der Reform direkt Betroffenen mehr als bisher in Gespräche und Pläne einbeziehen, anstatt sie außen vor zu lassen. Landrat Scheffold betonte: Dass Minister Lauterbach seine Reform im engen Kreis ohne Folgenabschätzung, ohne Beteiligung der „praktisch Involvierten“ und ohne Berücksichtigung struktureller Unterschiede zwischen verschiedenen Ländern und Regionen einfach durchziehe, mache ihn „fassungslos“.
450 ÄBW 07 | 2023 Vermischtes
Interview · Behandlung von Gesichtsverletzten des Krieges in der Ukraine
„Wehrmedizinisches Wissen verbreitern“

Mehr als eine Million Flüchtlinge aus der Ukraine sind seit Kriegsbeginn bis Anfang März in Deutschland eingetroffen. Gerade bei Gesichtsverletzungen sind deutsche Mund-Kiefer-Gesichtschirurgen gefragt. Einer von ihnen ist Prof. Dr. Dr. Alexander Schramm, Klinischer Direktor der Klinik für Mund-, Kiefer- und plastische Gesichtschirurgie am Bundeswehrkrankenhaus Ulm und ärztlicher Direktor der Klinik für Mund-, Kiefer- und Gesichtschirurgie am Universitätsklinikum Ulm. Mit ihm sprach ÄBW-Chefredakteur Dr. Oliver Erens.
Welche Verletzungsmuster durch den Ukrainekrieg sehen Sie?
Die Mehrheit der Flüchtlinge sind Frauen und Kinder – wenn Männer kommen, sind sie häufig durch Kriegseinsätze verletzt und müssen hierzulande weiterbehandelt werden. Viele von ihnen haben Schuss- und Explosionsverletzungen – 20 bis 40 Prozent davon betreffen den Kopf-, Hals- und Gesichtsbereich. In solchen Fällen helfen wir mit modernen Behandlungsmethoden und in interdisziplinären Teams. Bei Schuss- und Explosionsverletzungen im Gesicht und im Kieferbereich sind häufig sowohl die Weichteile wie die Haut, die Muskeln und das Bindegewebe betroffen als auch die knöchernen Strukturen. Wir kümmern uns beispielsweise um die funktionelle Wiederherstellung der Schluck-, Kau- und Sprachfunktion inklusive der Wiederherstellung des Zahnverlustes durch Zahnimplantate. Und warum findet die Versorgung nicht in der Ukraine statt?
Auch in der Ukraine gibt es hervorragende Kliniken mit mund-, kieferund gesichtschirurgischen Abteilungen, allerdings stoßen diese seit dem Kriegsausbruch stark an ihre Kapazitätsgrenzen. Da deutsche und europäische Kliniken über modernste Standards verfügen und momentan noch ausreichend Kapazitäten haben, haben wir bereits zeitnah nach dem Kriegsausbruch unsere Unterstützung angeboten.
Die ukrainischen Soldaten werden in ihrem Heimatland erstversorgt – erhalten also zunächst stabilisierende, lebensrettende Maßnahmen. Häufig müssen beispielsweise Blutungen gestillt oder Luftwege gesichert werden. Wenn sie soweit stabilisiert sind, dass sie transportfähig sind, werden sie zunächst in der Ukraine weiter behandelt und nur bei Kapazitätsbedarf oder bei zivilen Verletzten auch auf Eigeninitiative zur weiteren Versorgung nach Deutschland oder in andere Länder gebracht.
Wie geht es anschließend weiter?
In der Weiterversorgung liegt der Fokus hierzulande dann vor allem auf der funktionellen Wiederherstellung. Aber auch ästhetische Belange werden dabei adressiert. Hierbei ist in der Regel eine multidisziplinäre Zusammenarbeit von MKG-Chirurgen, Oralchirurgen, Zahnärzten, HNO-Ärzten, Augenärzten, Anästhesisten, Neurochirurgen und Traumatologen gefragt. Wenn das Gesicht durch eine Schuss- und Expositionsverletzung zerstört ist, ist das für den Betroffenen nachhaltig entstellend. Dabei geht es dann oft sowohl darum, dass die Zähne mit Implantaten wieder funktionsfähig hergestellt werden, als auch, dass das verletzte Gewebe behandelt wird – und zwar so, dass möglichst viel davon erhalten bleibt.
Bei einigen Soldaten ist auch die Augenhöhle verletzt, was eine besondere Herausforderung darstellt: Mittels moderner intraoperativer Assistenzsysteme wie 3-D-Computer-Navigationen und einer intraoperativen Bildgebung im Zusammenspiel mit patientenspezifischen Implantaten und Operationsschablonen können wir selbst in dieser komplexen Körperregion Fremdkörper entfernen und knöcherne Symmetrien wiederstellen.
Als Kliniker und militärischer Oberstarzt haben Sie vermutlich einen anderen Blick auf das Kriegsgeschehen als andere Kolleginnen und Kollegen?
Unsere bisherigen Erfahrungen zeigen, dass wir in Deutschland auch auf die Behandlung komplexer Kriegsverletzungen gut vorbereitet sind. Dennoch muss das wehrmedizinische Wissen und die Versorgungen im Katastrophenfall nun mehr in die Breite gebracht werden – etwa durch entsprechende Aus-, Fort- und Weiterbildungen der Behandler. Hier benötigen wir letztlich auch die Unterstützung der Politik.
Austausch von Konnektoren und Zertifikaten
Vernetzung
In einigen Praxen, Krankenhäusern und Apotheken laufen in den kommenden Monaten Zertifikate ab. Was Einrichtungen dazu wissen müssen und wie sie überprüfen können, ob ihre Komponenten betroffen sind, wird auf einer neuen Themenseite der gematik erläutert. Außerdem wird ein Überblick gegeben, was Einrichtungen bei der TI-Anbindung beachten müssen und welche Optionen künftig zur Ver fügung stehen werden. Hierfür hat die gematik Informationen rund um die TI-Anbindung zusammengestellt.
Informationen zum Austausch von Konnektoren und Zertifikaten
ÄBW 07 | 2023 451 Vermischtes
Prof. Dr. A. Schramm
Übersicht der geförderten Standorte
15,65 Millionen Euro für geburtshilfliche Versorgung in Krankenhäusern
Förderung für Kliniken mit Geburtshilfe
Die geburtshilfliche Versorgung in den Krankenhäusern in Baden-Württemberg wird in den Jahren 2023 und 2024 mit jeweils rund 15,65 Millionen Euro gefördert. Diese zusätzlichen Bundesmittel sollen die Geburtshilfe unabhängig von der leistungsorientierten Fallkostenpauschale finanziell absichern und die Fachabteilungen für Geburtshilfe in den Krankenhäusern unterstützen.
Gesundheitsminister Manne Lucha sagte Anfang April: „Eine bedarfsgerechte Geburtshilfe ist essenziell für die Gebärenden und ihre Familien. Diese Strukturen stehen vielerorts unter
Druck. Umso wichtiger ist hier diese zusätzliche finanzielle Unterstützung, die wir durch eine Einigung zwischen Bund und Ländern erzielen konnten.“ Die Förderung richte sich an die Standorte, die eine Fachabteilung für Geburtshilfe oder eine Fachabteilung für Gynäkologie und Geburtshilfe vorhalten. In Baden-Württemberg könnten 71 Krankenhausstandorte von der Förderung profitieren. „Damit wird die für uns besonders wichtige geburtshilfliche Versorgung im Land flächendeckend gestärkt“, ergänzte der Minister.
Für die Versorgung der Geburtshilfe werden bundesweit aus der Li-
Traumatherapie für Opfer von Gewalttaten
Gewaltopfer
Opfer von Gewalttaten benötigen besondere Unterstützung, insbesondere bei der Bewältigung der oft schweren psychischen Folgen dieser Ereignisse. Mit der Neufassung des Sozialen Entschädigungsrechts im Sozialgesetzbuch XIV wurde
der Anspruch der Betroffenen auf schnelle psychotherapeutische Hilfe in spezialisierten Traumaambulanzen gesetzlich verankert. Das Ministerium für Soziales, Gesundheit und Integration und das Landesversorgungsamt im Regie -

quiditätsreserve des Gesundheitsfonds für 2023 und 2024 jeweils 120 Millionen Euro bereitgestellt und nach dem Königsteiner Schlüssel auf die Bundesländer verteilt. Für BadenWürttemberg stehen demnach jeweils rund 15,65 Millionen Euro zur Verfügung. Die standortindividuellen Förderbeträge wurden nun vom Gesundheitsministerium nach bestimmten Kriterien wie Geburtenzahl, das Vorhalten bestimmter Fachabteilungen sowie die Beteiligung an der praktischen Hebammenausbildung im Rahmen einer Allgemeinverfügung dem Grunde nach festgelegt.
Weitere Informationen zur Traumatherapie für Opfer von Gewalttaten
rungspräsidium Stuttgart sind in Baden-Württemberg gemeinsam dafür zuständig, dieses Angebot der Traumatherapie möglichst flächendeckend umzusetzen und für die Opfer von Gewalttaten verfügbar zu machen.
Das Sozialministerium möchte daher alle Kliniken, Ambulanzen und Praxen, welche die in der TAV aufgeführten Voraussetzungen erfüllen, für eine Zusammenarbeit mit der für das SGB XIV zuständigen Versorgungsverwaltung gewinnen. Es bietet eine vertraglich geregelte Zusammenarbeit zugunsten der Klienten an. Durch die Kliniken, Ambulanzen und Praxen mit psychotherapeutischen Angeboten in Baden-Württemberg erhalten Opfer von Gewalttaten einen schnellen und niederschwelligen Zugang zu psychotherapeutischer Hilfe.
Die Behandlung wird mit dem Versorgungsamt im Landratsamt vor Ort abgerechnet. Die Vergütung beinhaltet neben den gängigen EBMSätzen auch zusätzliche Pauschalen je Fall.
452 ÄBW 07 | 2023 Vermischtes
Vier Tübinger Ärztinnen und Ärzte starten Petition an den Deutschen Bundestag
Rettet die ambulante medizinische Versorgung
Vier Ärztinnen und Ärzte aus Tübingen und Umgebung haben sich zusammengetan, um gemeinsam mit ihren Patienten über ihre Petition „Rettet die ambulante medizinische Versorgung“ vom Deutschen Bundestag eine adäquate Finanzierung der niedergelassenen Haus- und Facharztpraxen zur Sicherung und Aufrechterhaltung der ambulanten Versorgung zu fordern.
„Die ambulante Versorgung stirbt, helfen Sie mit, sie zu retten!“, heißt es zu Beginn des Aufrufs, der bei der weltweit größten Petitionsplattform für gesellschaftliche Veränderung change.org zu finden ist. Und weiter: „Es betrifft auch Sie! – Praxen werden geschlossen, weil Ihre Ärztinnen und Ärzte in Rente gehen und es keine Nachfolger gibt. Die Folge sind lange Wartezeiten und weite Anfahrtswege. Leistungen werden vorenthalten, weil Ärztinnen und Ärzte diese von den Krankenkassen nicht oder nur teilwei-
se erstattet bekommen. Wir können uns kaum noch Zeit für Sie nehmen.“
Zu den Gründen für diese Entwicklung schreiben die Autoren: „Wir niedergelassene Haus- und Fachärzte unterliegen einem System der Unterfinanzierung und Mangelverwaltung, hervorgerufen durch Regelungen der Politik und der Krankenkassen. Budgetierung und Pauschalen sind hier die Schlagworte. Dadurch bleibt nicht zuletzt das Wohl der Patientinnen und Patienten außen vor!“
Die Vergütung und die Arbeitsbedingungen für niedergelassene Ärztinnen und Ärzte hätten sich durch Kostensteigerungen ohne Gegenfinanzierung, eine verfehlte Digitalisierung und eine stetig zunehmende Bürokratie in den letzten Jahren so verschlechtert, dass sich niemand mehr in die Niederlassung begeben wolle. „So geht es nicht mehr weiter. Die Grenze des Verantwortbaren ist längst überschritten. Unsere Aufgabe ist es, Ihnen zu helfen.


Datensicherheit und Schutz vor digitaler Erpressung im medizinischen Bereich
Schutz vor Cybercrime




















Ob Hackerangriffe oder Datenspionage: Digitale Bedrohungen nehmen zu. In den Fokus der Kriminellen rücken dabei immer öfter auch selbstständige Freiberufler. Sie haben es beispielsweise in ihren Praxen, aber auch in Apotheken, Kanzleien und Büros mit hochsensiblen Daten und sehr persönlichen Informationen ihrer Patienten beziehungsweise Klienten zu tun. Das macht sie zu potenziell sehr beliebten Zielen digitaler Erpressungen. In Kooperation mit dem Landeskriminalamt Baden-Württemberg (LKA) bietet der Landesverband der Freien Berufe Baden-Württemberg (LFB) eine Informations- und Präventionsveranstaltung zum Thema Cybersicherheit an. Ein Experte der Zentralen Ansprechstelle Cybercrime des LKA wird im Rahmen der Veranstaltung über typische Cybercrime-Phänomene und Taktiken der Angreifer aufklären und empfehlenswerte Gegenmaßnahmen vorstellen. Die kostenlose Veranstaltung startet am Mittwoch, 27. September 2023, um 18.30 Uhr bei der Bezirksärztekammer Nordwürttemberg (Jahnstraße 5, 70597 Stuttgart-Degerloch). Sie findet im hybriden Rahmen statt, Teilnahme ist in Präsenz und via Online-Livestream möglich (rechtzeitige Anmeldung erbeten).
Informationen zur Veranstaltung
Die Politik muss hier im Interesse der Patientinnen und Patienten handeln. Die ambulante Versorgung muss für alle dort Tätigen wieder attraktiv werden. Darum kämpfen wir für Sie und uns. Wir müssen ein Zeichen setzen und uns an den Bundestag wenden.“
Gefordert werden untere anderem die Abschaffung der Budgetierung und unrealistischer Pauschalen zugunsten einer Vergütung gemäß jeder erbrachten Leistung, eine ausreichende Honorierung zur Deckung sämtlicher Praxisausgaben inklusive einer adäquaten Vergütung ärztlicher Arbeit und die der Angestellten mit Inflationsausgleich, der Abbau unnötiger Bürokratie sowie eine arztfreundliche kostenneutrale Digitalisierung.
Ende Mai startete die Petition; Mitte Juni war bereits die Marke von 50.000 Unterstützern übersprungen. So viele Unterschriften sind nötig, um es mit dem Anliegen überhaupt in den Bundestag zu schaffen.
Keine Schulung mehr verpassen!
Veranstaltungskalender einmal im Quartal




Mehr erfahren
Wir vermitteln Wissen für den Praxisalltag – einfach & kompakt.
Lassen Sie sich einmal im Quartal unseren medatixx-akademie-Veranstaltungskalender per E-Mail zusenden. Kostenfrei abonnieren und 10 % Rabatt auf Ihre nächste Online-Buchung erhalten!


medatixx-akademie.de

ÄBW 07 | 2023 453 Vermischtes
Tübinger Petition
Anzeige
Online-Bewertungsplattform des Marburger Bundes hilft bei Stellensuche
Gute Weiterbildungs- und Arbeitsbedingungen
Der Marburger Bund (MB), Landesverband Baden-Württemberg, will Ärztinnen und Ärzten dabei behilflich sein, gute Weiterbildungsstätten und faire Arbeitsbedingungen zu finden. Denn Umfragen des Verbandes zeigen, dass die ärztliche Weiterbildung in Deutschland teilweise unbefriedigend läuft: Weiterbildungspläne werden nicht eingehalten und die geforderten Inhalte nicht ausreichend vermittelt. Darunter leiden die Qualität der Weiterbildung und die Attraktivität der klinischen Tätigkeit.
Helfen soll eine neue Online-Bewertungsplattform, die einen Mehrwert für Ärztinnen und Ärzte in Weiterbildung, aber auch für Krankenhäuser und Praxen schaffen möchte. Konkret soll die Plattform die Entscheidung, wo Ärztinnen und Ärzte ihre Weiterbildung absolvieren wollen und wo gute Arbeitsbedingungen herrschen, unterstützen. Dabei helfen die Bewertungen und persönlichen Erfahrungen anderer Medizinerin-
nen und Mediziner, die die Klinik oder Praxis kennen. Die Plattform sammelt die Bewertungen von Weiterbildungsmöglichkeiten und Arbeitsbedingungen in Kliniken und Praxen. Die Bewertungen der Kolleginnen und Kollegen thematisieren genau die Aspekte, die junge Ärztinnen und Ärzte wissen wollen. So will die Bewertungsplattform eine transparente, unabhängige Orientierungshilfe bei der Klinik- oder Praxissuche mit guten Weiterbildungsmöglichkeiten und Arbeitsbedingungen bieten.
Die Plattform deckt die zwei Bereiche Weiterbildung und Arbeitsbedingungen mit je vier Kategorien ab. Dabei geht es um die Beurteilung der Arbeitsbedingungen, die individuelle Arbeitsbelastung, das Arbeitsklima sowie die subjektive Gesamtbewertung. Zudem werden die Betreuung beziehungsweise die Einarbeitung bei Stellenantritt abgefragt, aber auch die Weiterbildungssituation und die subjektive Gesamtbewertung. Die Antwortmöglichkeiten zu den einzelnen Bewertungs-
kriterien sind gemäß Gewichtung mit Punkten unterlegt, welche mittels eines Algorithmus zur Bewertung der jeweiligen Arbeitsstätte führen. Da für jede Kategorie bei jeder Arbeitsstätte die gleichen Bewertungskriterien gelten, ist die Vergleichbarkeit gewährleistet.
Wer auf der Suche nach den Weiterbildungsmöglichkeiten und Arbeitsbedingungen in einer bestimmten Klinik ist, wählt zunächst die Wunschklinik oder -praxis aus. Es werden die Hauptkriterien wie zum Beispiel die Weiterbildungsbefugten, die Art der Weiterbildungsbefugnis und eine allgemeine Gesamtbewertung der Abteilung von 1 bis 5 Stethoskopen angezeigt. Mitglieder des Marburger Bundes bekommen zusätzlich die Anzahl der abgegebenen Bewertungen, detaillierte Fragebogen-Ergebnisse und subjektive Empfehlungen über eine Arbeitsstätte mitgeteilt.
Weitere Informationen: www.bewertung-mb.de
Hilfe für Ärztinnen und Ärzte zur Bewältigung von belastenden Ereignissen
Posttraumatische Stresssymptome im Arztberuf
Für Ärztinnen und Ärzte besteht ein erhöhtes Risiko, belastende Erfahrungen zu erleben, da sie täglich mit Schmerz, Leid, schweren Erkrankungen oder Tod konfrontiert sind. Zudem tragen sie eine große Verantwortung im Hinblick auf das Wohl von Patientinnen und Patienten. Kleine Fehlentscheidungen können schwerwiegende Konsequenzen nach sich ziehen.
Ein belastendes Ereignis, das die Bewältigungsmöglichkeiten der Betroffenen übersteigt, kann zu unterschiedlichen Folgeerscheinungen führen. Neben sozialem Rückzug und Schwierigkeiten in der Alltagsbewältigung kann es auch zur Entwicklung von posttraumatischen Stresssymptomen kommen: Das Ereignis kann sich als belastende Erinnerung aufdrängen, es werden bestimmte Orte,
Menschen oder Situationen vermieden, die Gedanken oder die Stimmung verändern sich negativ oder eine überhöhte Reizbarkeit entsteht.
Einige der betroffenen Ärztinnen und Ärzte wünschen sich therapeutische Unterstützung. Jedoch ist der Zugang zu Behandlungsmöglichkeiten oft erschwert, beispielsweise durch lange Wartezeiten oder eine Unvereinbarkeit der Behandlungstermine mit dem beruflichen Alltag.
Die Klinik und Poliklinik für Psychosomatische Medizin und Psychotherapie des Universitätsklinikums Leipzig bietet im Rahmen einer wissenschaftlichen Studie ein kostenfreies internetbasiertes Therapieprogramm für Ärztinnen und Ärzte an, die im Rahmen ihrer beruflichen Tätigkeit ein belastendes Ereignis erlebt haben. Das Behandlungsangebot
richtet sich an Ärztinnen und Ärzte oder Medizinstudierende im Praktischen Jahr, die nach einem traumatischen Ereignis in ihrem Beruf unter posttraumatischen Stresssymptomen leiden. Das Behandlungsprogramm umfasst einen Zeitraum von etwa fünf Wochen und ist für die Teilnehmenden zeitlich und räumlich flexibel gestaltbar. In insgesamt zehn Schreibaufgaben werden sie dabei angeleitet, das Erlebte zu verarbeiten, wobei über eine sichere Internetplattform regelmäßiger Kontakt zu einer Therapeutin oder einem Therapeuten besteht. Um die Wirksamkeit der Behandlung zu überprüfen, werden die Teilnehmenden gebeten, zu verschiedenen Zeitpunkten Fragebögen zu ihrem Befinden auszufüllen.
Weitere Informationen: www.belastung-im-arztberuf.de
454 ÄBW 07 | 2023 Vermischtes
STADT. LAND. GRÜN.
Repräsentativ wohnen. Im Herzen von Stuttgart-Degerloch.
So idyllisch wohnen wie in einem Dorf – und gleichzeitig alle Vorzüge genießen, die das Leben in einer Großstadt bietet. Wäre das Ihr Traum? In Stuttgart-Degerloch können Sie sich diesen erfüllen. Entdecken Sie ein neues Bauvorhaben von Wohnbau-Studio, das den Charme Alt-Degerlochs in moderne Architektur umsetzt. Praxisräume direkt an der Löwenstraße möglich.
Weitere Highlights: Nachhaltiges Energiekonzept ohne Gas und Öl, hochwertige Ausstattung, individuelle Grundrisse, bequemer Aufzug und Tiefgarage.
Architektur: blocher partners

Wir bauen für Sie. Mit Leidenschaft und Sachverstand. Seit über 45 Jahren.
Bei uns sind Sie immer an der richtigen Adresse. Lernen Sie uns kennen.
Wir freuen uns auf Ihren Anruf:
+49 711 45 999 6-30
www.wohnbaustudio.de
 Unverbindliche Visualisierung. Darstellung kann Sonderwünsche enthalten.
Unverbindliche Visualisierung. Darstellung kann Sonderwünsche enthalten.
Wir bauen aktuell für Sie in StuttgartDegerloch, am KillesbergStuttgarter und in Ostfildern-Ruit!
„Nur mein Hausarzt wusste davon“
Den Beipackzettel lesen, Anamnesebögen ausfüllen, Therapieanweisungen verstehen: 6,2 Millionen Erwachsene in Deutschland brauchen dabei Hilfe, weil sie nicht ausreichend lesen und schreiben können. Martin Sell ging das ebenso. Dann hat er sich für einen Kurs angemeldet. Was sein Arzt damit zu tun hatte und warum es ihm nun auch gesundheitlich viel besser geht, erklärt er hier.

Herr Sell, wie steht’s aktuell um Ihre Gesundheit?
Ich komme gerade vom Chirurgen. Vor ein paar Tagen habe ich mit der Flex die Hand erwischt. Das wurde im Krankenhaus genäht. Heute war ich zum Verbandswechsel.
Sie haben erst vor einigen Jahren Lesen und Schreiben gelernt. Was heißt das für Sie nach so einem Unfall?
Ich komme mittlerweile im Alltag gut zurecht. Aber der Patientenbogen ist für mich immer noch schwierig. Früher hätte ich das versteckt. Jetzt
In Ihrer Praxis gibt es Menschen mit geringer Lese- und Schreibkompetenz. Das können Sie tun.
1. Nutzen Sie das Vertrauensverhältnis. Es gibt viele Orte, an denen Erwachsene noch Lesen und Schreiben lernen können. Wenige finden den Weg dorthin allein. Womöglich sind Sie die einzige Person im Umfeld der Patientinnen und Patienten, die etwas mitbekommen hat. Zudem sind Sie professionell damit vertraut, sensible oder unangenehme Themen anzuschneiden. Kaum jemand anderes kann so gute Brücken bauen wie Sie.
2. Sprechen Sie die Schwierigkeiten sachlich und in Ruhe an. Schildern Sie konkrete Beobachtungen und fragen Sie freundlich nach. Anfängliche Abwehr ist möglich. Viele Menschen schämen sich zutiefst für ihre Schwierigkeiten. Dagegen hilft mitzuteilen, wie viele Menschen tatsächlich betroffen sind: jede und jeder achte Erwachsene, insgesamt 6,2 Millionen in Deutschland. Wenn diese Botschaft ankommt, haben Sie bereits viel erreicht.
3. Schaffen Sie Verbindlichkeit. Geben Sie möglichst konkretes Material zu Lern- und Beratungsangeboten weiter; Flyer zum Beispiel. Noch besser: Rufen Sie gemeinsam beim ALFA-Telefon an. Am ALFA-Telefon informieren Expertinnen und Experten anonym und kostenlos über passende Lernangebote und Selbsthilfegruppen in der Region und vermitteln passende Ansprechpersonen. Das ALFA-Telefon hilft unter: (08 00) 53 33 44 55.
sage ich offen bei der Anmeldung: Ich kann nicht so gut lesen und schreiben. Ich brauche Unterstützung. Das klappt oft gut. Auch heute war das Praxispersonal sehr freundlich und hat den Bogen mit mir zusammen ausgefüllt. Das ist ja auch für sie leichter, als sich über unleserliche Angaben oder fehlende Dokumente zu ärgern.
Seit wann weiß Ihr Hausarzt, dass Sie beim Lesen und Schreiben Schwierigkeiten haben?
Er wusste das von Anfang an. Zu ihm bin ich schon mit meinen Adoptiveltern gegangen. Sie haben viel versucht, als es in der Schule nicht funktioniert hat. Sie haben mich zurückstellen lassen und mich zum Psychologen und zur Logopädie geschickt. Einmal war ich in stationärer Behandlung. Meine Eltern haben das alles mit dem Hausarzt besprochen. Als meine Mutter gestorben war und der Kontakt zu meinem Vater abbrach, war mein Hausarzt der Einzige, der wusste, dass ich nur ganz wenig lesen und schreiben konnte, obwohl ich zehn Jahre in der Schule war.
Wie hat Ihr Hausarzt Sie dabei begleitet?
Seine Praxis war der einzige Ort, an dem ich mich nicht schämen musste. Er hat alles Schriftliche vorbereitet und mich krankgeschrieben,
wenn der Stress zu groß geworden ist. Ich musste mein Leben lang aufpassen, dass niemand etwas bemerkt. Ich habe jeden Job verloren, bei dem es doch herausgekommen ist. Viele können sich gar nicht vorstellen, wie anstrengend das ist. Ich hatte sogar Selbstmordgedanken.
Inzwischen haben Sie einen Kurs besucht. Was hat sich seither für Ihre Gesundheit verändert?
Der Stress ist weniger geworden. Ich muss nicht mehr so tun, als könnte ich etwas, das ich nicht gelernt habe. Ein Rezept kann ich heute allein lesen. Beim Beipackzettel hilft mir meine Lebensgefährtin. Das ist für sie kein Problem. Außerdem lese ich viel im Internet. Erst gestern habe ich etwas über Streptokokken gesucht, weil ich will, dass meine Wunde gut heilt. Ich wünsche mir, dass es im Internet zu solchen Themen noch viel mehr einfach geschriebene Texte gibt. Das Beste ist aber, dass ich jetzt richtig viel kann. Früher bin ich nie rausgekommen. Heute fahre ich mit dem Zug überall hin, weil ich weiß, dass ich auch wieder nach Hause finde. Ich bewege mich automatisch mehr. Mein Leben macht mir zum ersten Mal Spaß und ich will, dass dieses Leben noch lange dauert. Also esse ich auch weniger Fast Food als früher. Obwohl mir das wirklich schwerfällt.
Sie sind mittlerweile auch sozial sehr engagiert und beraten als Lernexperte andere Betroffene und ihr Umfeld. Was raten Sie Ärztinnen und Ärzten?
Es gibt keinen pauschalen Weg, aber Ansprechen finde ich wichtig. Es kann sein, dass die Person erst alles abstreitet. Aber mit dem Arzt besprechen viele doch auch andere Dinge, die unangenehm sind. Manche warten auch richtig darauf, dass es endlich jemand sagt, weil sie es selbst noch nicht schaffen. Bei vielen dauert es eine Weile, bis sie den Mut finden, etwas zu ändern. Aber was der Arzt gesagt hat, bleibt hängen.
456 ÄBW 07 | 2023 Vermischtes
Interview · Martin Sell kann nicht gut lesen und schreiben
Patient Martin Sell
Infomaterial für’s Wartezimmer und Tipps für‘s Patientengespräch
F ortbildung , S eminare & K ongre SS e
Deutschlands Ärzte (w/m/d) entdecken Akupunktur mit Dr. THAY JOE Tan

Einfach • Schnell • Sofort einsetzbar Ideal für Neu-/Wiedereinsteiger
TurboAkupunktur™-Akademie Dr. Tan Pain Elimination and Global Doctor Training Center of the Year 2019, 2020 & 2021 & 2022 Königstraße 70 • 70173 Stuttgart
A1.
Teil 1
Samstag, 22 07. 2023
oder
Samstag, 19. 08. 2023
jeweils 10.00 – 18.00 Uhr
A2.
Teil 2
Sonntag, 23. 07. 2023
oder
Sonntag, 20. 08. 2023
jeweils 10.00 – 18.00 Uhr
A1 oder A2:
Frühbucher 297 € bei Anmeldung bis 30. 06. 2023
bzw. 31. 07. 2023,
danach 497 €
A1 und A2:
Frühbucher 497 € bei Anmeldung
bis 30. 06. 2023
bzw. 31. 07. 2023,
danach 997 €
Begrenzte Teilnehmerzahl!
G. Sonntag, 23. 07. 2023 oder Sonntag, 20. 08. 2023
jeweils ca. 16.00 – 17.00 Uhr
497 € für Teilnehmer von Kurs A2., regulär 997 €
B. Samstag / Sonntag
29. / 30. 07. 2023
jeweils 10.00 – 18.00 Uhr vorheriges Auswahlgespräch erforderlich
A1.
Akupunktur KOMPAKT
Schnellstarter-Wochenende Teil 1
Basiswissen Chinesische Medizin
Theorie I
A2.
Akupunktur KOMPAKT
Schnellstarter-Wochenende Teil 2
Basiswissen Chinesische Medizin
Theorie II + Praxis + Abrechnung
inklusive
DIE 2 universellen Akupunkturpunkte zur Behandlung von: Schmerzen allgemein, An-/Verspannung (muskulär/emotional), Krämpfe und Koliken, Stress, innerer Unruhe, depressive Verstimmungen, Schlaf- und Verdauungsstörungen, Menstruationsbeschwerden.
A1–2. Online LIVE von zu Hause Begrenzte Präsenzmöglichkeit inkl. LIVE Demonstration je nach aktuellen Corona-Bestimmungen
Dr. Thay Joe Tan, Arzt und Zahnarzt
Ehem. Oberarzt TCM-Klinik Bad Kötzting
Erste Deutsche Klinik für Traditionelle Chinesische Medizin, Universitätskrankenhaus der Beijing Universität für Chinesische Medizin (BUCM)
International ausgezeichnet u. a. als: Most Influential Pain Elimination Expert 2020 & 2021 & 2022



Instant Pain Elimination Expert of the Year 2019 & 2020
Acupuncturist of the Year 2019
Acupuncture Expert of the Year 2019
Acupuncture Specialist of the Year 2018
ANMELDUNG UND INFO: 0176-47719647 (WhatsApp oder Telegram)
www.akupunktur-schnell-und-einfach-lernen.de office@turboakupunktur-akademie.de
G. Dr. Tan’s GRANDMASTER Point TurboAkupunktur™-Punkt mit max. breitem Indikationsspektrum
Einfach • Schnell • Sofort einsetzbar Nur für Fortgeschrittene (mind. Kurs A.)

B. Akupunktur schnell und einfach lernen mit dem T.A.N.-System™ für schnelle Schmerzfreiheit und mehr Privatumsatz
Exklusive Premium-Akupunkturausbildung zum Certified TurboAcupuncturist™

1 Wochenende + 12 Monate
Umsetzungsbegleitung zur Erfolgssicherung
Einfach · Schnell · Sofort einsetzbar
Zur Erlangung der therapeutischen Souveränität, Schmerzen mit EINER Nadel (sofort) eliminieren zu können
Ideal für
– Neu-/Wiedereinsteiger

– Praxisgründer
– Vor-/Ruheständler
G. Online LIVE von zu Hause
X. Samstag / Sonntag
29. / 30. 07. 2023
Uhrzeit n.V. kostenfrei
X. Endlich … schmerzfrei! Einfach. Schnell.™
Selbsterfahrungskurs für Ärzte (w/m/d) mit Schmerzen, die ihre Schmerzen sofort los werden wollen.
B. Online LIVE von zu Hause Begrenzte Präsenzmöglichkeit
X. Präsenzveranstaltung
TurboAkupunktur™Akademie Dr. Tan Königstraße 70 70173 Stuttgart
Anzeige TERMIN THEMA ORT VERANSTALTER
F ortbildung , S eminare & K ongre SS e
19. 07. 2023 –bis Frühjahr 2025
Zusatzweiterbildung
Psychotherapie 2023 – 2024
7 Blöcke à 4 Tage
Freiburg i. Brsg. 9.058,– € inkl. Fachliteratur und Tagungspauschale (zahlbar in Raten möglich)
AK PSM e. V., Universitätsklinikum Freiburg, http://www.psychosomatik-weiterbildung.de Tel.: 0761-48 89 95 53
25. – 30. 09. 2023
Intensivkurs Psychosomatische Grundversorgung 50 Std. (20 Std. Theorie, 30 Std. verb. Intervention) plus 10 Std. Balint
Freiburg i. Brsg. 1500,– € inkl. Fachliteratur und Tagungspauschale
AK PSM e. V., Universitätsklinikum Freiburg, http://www.psychosomatik-weiterbildung.de Tel.: 0761-48 89 95 53
23. – 28. 10. 2023 GYN
Intensivkurs Psychosomatische Grundversorgung in der Frauenheilkunde 50 Std. (20 Std. Theorie, 30 Std. verb. Intervention) plus 10 Std. Balint
Freiburg i. Brsg. 1500,– € inkl. Fachliteratur und Tagungspauschale
AK PSM e. V., Universitätsklinikum Freiburg, http://www.psychosomatik-weiterbildung.de Tel.: 0761-48 89 95 53
27. – 28.10. 2023
Medizinische Hypnose, Teil 1 – Grundkurs Dipl. Psych. Bettina Engemann
Freiburg i. Brsg. 370,– € inkl. Tagungspauschale
AK PSM e. V., Universitätsklinikum Freiburg, http://www.psychosomatik-weiterbildung.de Tel.: 0761-48 89 95 53
17. – 18. 11. 2023
Achtsamkeitskurs für Ärzte –Aufbaukurs
Dr. Marianne Schmidt
Freiburg i. Brsg. 370,– € inkl. Tagungspauschale
AK PSM e. V., Universitätsklinikum Freiburg, http://www.psychosomatik-weiterbildung.de Tel.: 0761-48 89 95 53
– 02. 12. 2023
Medizinische Hypnose, Teil 2 – Aufbaukurs
Dr. Charlotte Wirl
Freiburg i. Brsg. 370,– € inkl. Tagungspauschale
AK PSM e. V., Universitätsklinikum Freiburg, http://www.psychosomatik-weiterbildung.de Tel.: 0761-48 89 95 53
04. – 09. 12. 2023
Intensivkurs Psychosomatische Grundversorgung 50 Std. (20 Std. Theorie, 30 Std. verb. Intervention) plus 10 Std. Balint





Freiburg i. Brsg. 1500,– € inkl. Fachliteratur und Tagungspauschale
AK PSM e. V., Universitätsklinikum Freiburg, http://www.psychosomatik-weiterbildung.de Tel.: 0761-48 89 95 53
12. – 13. 01. 2024
Achtsamkeitskurs für Ärzte –Grundkurs
Dr. Marianne Schmidt
Freiburg i. Brsg. 370,– € inkl. Tagungspauschale
AK PSM e. V., Universitätsklinikum Freiburg, http://www.psychosomatik-weiterbildung.de Tel.: 0761-48 89 95 53
26. – 27. 04. 2024
Medizinische Hypnose, Teil 2 – Aufbaukurs Dipl. Psych. Bettina Engemann
Freiburg i. Brsg. 410,– € inkl. Tagungspauschale
AK PSM e. V., Universitätsklinikum Freiburg, http://www.psychosomatik-weiterbildung.de Tel.: 0761-48 89 95 53

20. 10. und 17. 11. 2023 16-h-Kurs Je 9.00 – 18.00 Uhr (230 €)
Klinische Transfusionsmedizin zur Qualifikation als Transfusionsbeauftragte/r- und verantwortliche/r Hämotherapie gemäß Curriculum der LÄK

DRK BSD
Baden-WürttembergHessen Institut Mannheim
Kontakt: Sabine Diehl Tel.: (06 21) 37 06-82 14 @: s.diehl@blutspende.de
DRK BSD Baden-Württemberg – Hessen gemeinnützige GmbH
Institut für Transfusionsmedizin und Immunologie Friedrich-Ebert-Straße 107
68167 Mannheim
Ärztl. Kursleiter: Prof. Dr. med. Harald Klüter
TERMIN
Anzeige
THEMA ORT VERANSTALTER
Spezial!
01.
F ortbildung , S eminare & K ongre SS e
13. / 14. 10. 2023
(I. Basis)
17. / 18. 11. 2023
(II. Aufbau)
09. / 10. 02. 2024
(III. Vertiefung)
(je 16 Std.; Kosten: 350 €, Fortbildungspunkte: 21)
01. / 02. 12. 2023
(je 16 Std.; Kosten: 350 €
Fortbildungspunkte: 21)
Medizinische Hypnose (I – III)
Moderne Hypnose-Interventionen zur Kontrolle akuter und chronischer Schmerzen, Symptom-Reduktion bei psychosomatischen Störungen, Angst- und Schlafstörungen. Als Zweitverfahren im Rahmen der Weiterbildung Psychotherapie (Entspannungsverfahren) anerkannt.
Hypno-systemische Selbststeuerung
Eine kompakte Auswahl praktischer Methoden der Selbststeuerung aus moderner Hypnose und Health-NLP der zweiten und dritten Generation zur Verwirklichung selbstkongruenter Ziele, Weiterentwicklung von Potenzialen, Gestaltung von Veränderung, Regulation von Emotionen, Entscheidungssicherheit und Verbesserung der Energiebilanz im Alltag.
„Psychosomatische Grundversorgung“ Komplettkurse incl. 30 h Balintgruppen (= sog. 80 Std. Kurs)






79098 Freiburg
Praxis PD Dr. Ross
Luisenstraße 6 Auskunft /
Praxis PD Dr. Ross
Luisenstraße 6
79098 Freiburg
E-Mail: Dr-Ross@web.de
Web: www.per-sono.de
79098 Freiburg
Praxis PD Dr. Ross
Luisenstraße 6
Auskunft / Anmeldung:
Praxis PD Dr. Ross
Luisenstraße 6
79098 Freiburg
E-Mail: Dr-Ross@web.de
Web: www.per-sono.de
/ 03. 02. 2024
19. / 20. 04. 2024
17. / 18. 05. 2024
Für Facharztprüfungen u. EBM-Ziff.: 35100 + 35110; Auch für Akupunktur – u. Schmerzstörung an insg. 4 Wochenenden Freitagnachmittag/Sa.
Die Kurse finden als Online-Veranstaltungen statt – befugt und zertifiziert von der LÄK Details/Anfragen und Anmeldungen über Homepage www.afpp.de > Anmeldungsanfrage
AfPP
Akademie für Psychotherapie
Kursleiter Dr. med. W. Polster – Gründer der Akademie –Schubertstraße 20, 75331 Engelsbrand / 75177 Pforzheim
Auskünfte:
F. Schleucher (Sekretariat) 0176-70330702, E-Mail: info@afpp.de; www.afpp.de
Fax: 07941-2070061
10. / 11. 11. 2023
23. / 24. 02. 2024
Workshop „Spirituelle Kompetenzen in der Psychiatrie, Psychotherapie, Psychosomatik“ entsprechend Empfehlung
SGB V § 2 Abs. 5 und OPD-orientiert im biopsychosozialen Modell –zertifiziert, neu überarbeitet und EBM-basiert
Der Workshop ist befugt und zertifiziert von der LÄK Details/Anfragen und Anmeldungen über Homepage www.afpp.de
> Anmeldungsanfrage
AfPP
Akademie für Psychotherapie Pforzheim
Kursleiter Dr. med. H. Scheiblich Altensteiger Straße 27, 72227 Egenhausen
Auskünfte: M. Prolingheuer (Sekretariat) 0151-72459745, E-Mail: info@afpp.de; www.afpp.de
Beginn
13. / 14. 10. 2023
Beginn Zusatztitel „Psychotherapie“
nach der neuen WBO 2020
Insg. über ca. 2 Jahre ca. alle 4 Wochen, Freitag/Samstag und Mittwochabend, incl. allen WBO-Modulen
Die Termine finden teils als Online-Veranstaltung, teils als Präsenzveranstaltung in Pforzheim statt –befugt und zertifiziert von der LÄK
Details/Anfragen und Anmeldungen über Homepage www.afpp.de
>Anmeldungsanfrage
AfPP
Akademie für Psychotherapie

Kursleiter Dr. med. H. Scheiblich
Altensteiger Straße 27, 72227 Egenhausen
Auskünfte: M. Prolingheuer (Sekretariat) 0151-72459745
E-Mail: info@afpp.de; www.afpp.de
Anzeige TERMIN THEMA ORT VERANSTALTER
Anmeldung: Tel. (07 61) 7 07 73 21 Fax (07 61) 7 07 73 22
Tel.
Fax
(07 61) 7 07 73 21
(07 61) 7 07 73 22
/ 23. 09.
/ 21. 10.
08. / 09. 12. 2023 02.
Curricula 22.
2023 20.
2023
F ortbildung , S eminare & K ongre SS e
Kurs 2: 22. – 24. 09. 2023
Kurs 3: 20. – 22. 10. 2023
Kurs 4: 10. – 12. 11. 2023
Psychosomatische Grundversorgung
4 WE-Seminare (inclusive Balint-Gruppe) mit KV- und ÄK-Anerkennung

69115 Heidelberg
Hybridveranstaltung (sowohl online als auch in Präsenz)
Dr. Olschewski-Hattenhauer und Dr. Valerie Elsässer Tel. (0 62 21) 16 35 24

E-Mail: info@ol-ha.de www.ol-ha.de/kurstermine.html
Beginn 13. 10. 2023 alle genauen Termine unter www.hit-heidelberg.de Veranstaltungszeiten:




mittwochs jeweils
18.15 – 20.30 Uhr (2 Std.)
20.45 – 22.15 Uhr (2 Std.)
samstags:
9.30 – 16.30 Uhr (8 U-Std.)
Theorie und Praxis der Psychosomatischen Grundversorgung (inkl. Balintgruppe) 2023 – 2024
Das Heidelberger Institut für Tiefenpsychologie veranstaltet in Zusammenarbeit mit der Akademie für Ärztliche Fortbildung der Bezirksärztekammer ein Curriculum nach den Richtlinien der KV für niedergelassene Ärztinnen und Ärzte sowie für Kolleginnen und Kollegen in der Facharztweiterbildung.

Die Weiterbildung für die ärztliche Zusatzbezeichnung „fachgebundene Psychotherapie“ sowie Bausteine für den Erwerb des Facharztes „Psychiatrie und Psychotherapie“ und „Psychosomatische Medizin“
Bergheimer Straße 20, 69115 Heidelberg Abteilung
Medizinische Psychologie
Organisation: Dr. med. Till Bugaj, TillJohannes.Bugaj@med.uni-heidelberg.de und Dr. med. Uta Sonneborn, uta.sonneborn@gmx.de
Teilnahmegebühr:
1200 € (Psychosomatische Grundversorgung, incl. Balintgruppe)
berechtigt zur Abrechnung der Ziffern 35100/35110. Die Teilnahme wird mit 80 Zertifizierungspunkten bewertet.
Auskunft: www.hit-heidelberg.de info@hit-heidelberg.de, Tel. 06221/8953030
HIT Alte Bergheimer Straße 5, 69115 Heidelberg Abteilung Medizinische Psychologie
Weitere Informationen zu unseren Bürosprechzeiten: Mo. 14.15 – 16.00 Uhr und Mi. 09.30 – 12.30 Uhr Tel. 06221-8953030 und auf unserer Homepage: www.hit-heidelberg.de
Infoabend: der Termin wird auf unserer Homepage in Kürze bekannt gegeben.
HIT, Alte Bergheimer-Straße 5, 69115 Heidelberg www.hit-heidelberg.de, info@hit-heidelberg.de Tel. 06221/8953030
Anzeigenschluss für Heft 8 / 2023 ist der 26. Juli 2023
Ihr Kontakt zur Anzeigenabteilung:
Herr Axel Hollenbach
Telefon 0711 / 63672-827, Fax 0711 / 63672-760
hollenbach@gentner.de
Herr Rudolf Beck
Telefon 0711 / 63672-861, Fax 0711 / 63672-760 beck@gentner.de
Anzeige
TERMIN THEMA ORT VERANSTALTER
HIT
Nächster Beginn WS 2023 / 2024 am 01. 10. 2023
Zum Gedenken
Landesausschuss Ärzte/Krankenkassen
Geschäftsstelle: Albstadtweg 11
70567 Stuttgart (Möhringen)
Telefon (07 11) 78 75-33 92 Fax (07 11) 78 75-32 74
Landesausschuss der Ärzte und Krankenkassen für Baden-Württemberg
Beschluss: Feststellung von Überversorgung
Der Landesausschuss der Ärzte und Krankenkassen für BadenWürttemberg stellt mit Beschluss vom 21. Juni 2023 gem. § 103 Abs. 1 Satz 1 SGB V i. V. mit § 16 b Abs. 1 Ärzte-ZV arztgruppenbezogen für nachstehende Planungsbereiche nach Maßgabe der Planungsblätter Überversorgung fest:
Hausärztliche Versorgung: Hausärzte: Breisach, Freiburg, Haslach/ Hausach/Wolfach, Konstanz, Mannheim, Müllheim, Offenburg, Rottenburg, Stockach, Waldkirch, Wiesloch/Walldorf.

Allgemeine fachärztliche Versorgung: Augenärzte: Alb-Donau-Kreis, Baden-Baden/ Rastatt, Biberach, Bodenseekreis, Breisgau-Hochschwarzwald, Calw, Emmendingen, Enzkreis, Esslingen, Freiburg, Heidelberg, Heidenheim, Landkreis Heilbronn, Stadt Heilbronn, Landkreis Karlsruhe, Stadt Karlsruhe, Konstanz, Lörrach, Ludwigsburg, MainTauber-Kreis, Mannheim, NeckarOdenwald-Kreis, Ortenaukreis, Pforzheim, Rems-Murr-Kreis, Reutlingen, Rottweil, Schwäbisch Hall, Schwarzwald-Baar-Kreis, Sigmaringen, Stuttgart, Tübingen, Tuttlingen, Ulm, Waldshut, Zollernalbkreis.
Chirurgen und Orthopäden: Alb-Donau-Kreis, Baden-Baden/ Rastatt, Biberach, Böblingen, Bodenseekreis, Breisgau-Hochschwarzwald, Calw, Emmendingen, Esslingen, Freiburg, Freudenstadt, Göppingen, Heidelberg, Heidenheim, Landkreis Heilbronn, Stadt Heilbronn, Hohenlohekreis, Landkreis Karlsruhe, Stadt Karlsruhe, Konstanz, Lörrach, Ludwigsburg, Main-Tauber-Kreis, Mannheim, Ortenaukreis, Ostalbkreis, Pforzheim, Ravensburg, Rems-MurrKreis, Reutlingen, Rhein-NeckarKreis, Rottweil, Schwäbisch Hall, Schwarzwald-Baar-Kreis, Sigmaringen, Stuttgart, Tübingen, Tuttlingen, Ulm, Waldshut, Zollernalbkreis.
Frauenärzte:
Alb-Donau-Kreis, Baden-Baden/ Rastatt, Biberach, Böblingen, Bodenseekreis, Breisgau-Hochschwarzwald, Calw, Emmendingen, Enzkreis, Esslingen, Freiburg, Freudenstadt, Göppingen, Heidelberg, Heidenheim, Landkreis Heilbronn, Stadt Heilbronn, Hohenlohekreis, Landkreis Karlsruhe, Stadt Karlsruhe, Konstanz, Lörrach, Ludwigsburg, Main-Tauber-Kreis, Mannheim, Neckar-Odenwald-Kreis, Ortenaukreis, Ostalbkreis, Pforzheim, Ravensburg, Rems-Murr-Kreis, Reutlingen, Rhein-Neckar-Kreis, Schwäbisch Hall, SchwarzwaldBaar-Kreis, Stuttgart, Tübingen, Tuttlingen, Ulm, Zollernalbkreis.
HNO-Ärzte:

Alb-Donau-Kreis, Baden-Baden/ Rastatt, Biberach, Böblingen, Bodenseekreis, Breisgau-Hochschwarzwald, Calw, Emmendingen, Enzkreis, Freiburg, Göppingen, Heidelberg, Stadt Heilbronn, Landkreis Karlsruhe, Stadt Karlsruhe, Konstanz, Ludwigsburg, Main-Tauber-Kreis, Mannheim, Ortenaukreis, Pforzheim, Ravensburg, Rems-Murr-Kreis, Reutlingen, Rhein-Neckar-Kreis, Rottweil, Schwarzwald-Baar-Kreis, Stuttgart, Tübingen, Tuttlingen, Ulm, Zollernalbkreis.
Hautärzte:
Alb-Donau-Kreis, Baden-Baden/ Rastatt, Biberach, Böblingen, Bodenseekreis, Breisgau-Hochschwarzwald, Calw, Emmendingen, Esslingen, Freiburg, Göppingen, Heidelberg, Heidenheim, Landkreis Heilbronn, Stadt Heilbronn,
ÄBW 07 | 2023 461 Bekanntmachungen
Dr. med. Christoph Worbes, Ulm * 04. 01. 1930 † 02. 07. 2022 Vesna Antunovic, Stuttgart * 22. 10. 1963 † 05. 04. 2023 Dr. med. Siegfried Danowski, Oberndorf * 20. 03. 1938 † 08. 04. 2023 Dr. med. Dieter Hauf, Schömberg * 15. 05. 1938 † 17. 04. 2023 Dr. med. Jan Kasprus, Ettlingen * 31. 12. 1928 † 19. 04. 2023 Esther Schmidt, Schönaich, Württ * 08. 02. 1976 † 22. 04. 2023 Dr. med. Ulrike Martin, Schönau * 13. 05. 1941 † 24. 04. 2023 Dr. med. Dieter Ritzmann, Reutlingen * 27. 02. 1936 † 26. 04. 2023 Dipl.-Med. Ursula Knapp, Ulm * 07. 08. 1952 † 27. 04. 2023 Dr. med. Clara Hahn, Stuttgart * 01. 09. 1925 † 29. 04. 2023 Peter Fischmann, Mössingen * 01. 09. 1942 † 30. 04. 2023 Dr. med. Ursula Hofele, Müllheim * 17. 10. 1925 † 02. 05. 2023 Prof. Dr. med. Dieter Waldmann, Müllheim * 16. 04. 1943 † 02. 05. 2023 Dr. med. Gustav Sakellari-Colmant, Gemmrigheim * 22. 06. 1940 † 03. 05. 2023 Dr. med. Peter Ehlers, Allensbach * 17. 03. 1936 † 06. 05. 2023 Dr. med. Rainer Weislogel, Neckargemünd * 25. 09. 1947 † 07. 05. 2023 Dr. med. Thomas Wüst, Mühlacker * 17. 02. 1957 † 09. 05. 2023 Dr. Medic/Hochschule f. Med. Temeschburg Klaus Hess, Konstanz * 25. 02. 1941 † 11. 05. 2023 Dr. med. Traudl Weinans, Donzdorf * 14. 03. 1948 † 13. 05. 2023 Dr. med. Ulrich Haaf, Rottenburg * 07. 02. 1954 † 16. 05. 2023 Dr. med. Conrad Müller, Mannheim * 02. 12. 1934 † 16. 05. 2023 Dr. med. Wolfgang Meer, Ladenburg * 25. 02. 1953 † 29. 05. 2023 Wir trauern um unsere Kolleginnen und Kollegen
Anzeige Eine Welt. Ein Klima. Eine Zukunft. 64.Aktion Brot für die Welt Foto: Mauricio Bustamante / Visum
Hohenlohekreis, Stadt Karlsruhe, Konstanz, Ludwigsburg, MainTauber-Kreis, Mannheim, NeckarOdenwald-Kreis, Ostalbkreis, Ravensburg, Reutlingen, Rottweil, Schwarzwald-Baar-Kreis, Stuttgart, Tübingen, Ulm, Zollernalbkreis.
Kinderärzte:
Alb-Donau-Kreis, Baden-Baden/ Rastatt, Bodenseekreis, BreisgauHochschwarzwald, Emmendingen, Esslingen, Freiburg, Freudenstadt, Heidelberg, Heidenheim, Landkreis Heilbronn, Landkreis Karlsruhe, Stadt Karlsruhe, Konstanz, Lörrach, Ludwigsburg, MainTauber-Kreis, Mannheim, Ortenaukreis, Ostalbkreis, Ravensburg, Rems-Murr-Kreis, Reutlingen, Rhein-Neckar-Kreis, SchwarzwaldBaar-Kreis, Stuttgart, Tübingen, Ulm, Waldshut.
Nervenärzte:
Baden-Baden/Rastatt, Böblingen, Bodenseekreis, Breisgau-Hochschwarzwald, Calw, Emmendingen, Esslingen, Freiburg, Freudenstadt, Göppingen, Heidelberg, Heidenheim, Stadt Heilbronn, Hohenlohekreis, Landkreis Karlsruhe, Stadt Karlsruhe, Konstanz, Lörrach, Ludwigsburg, Main-Tauber-Kreis, Mannheim, Ortenaukreis, RemsMurr-Kreis, Reutlingen, RheinNeckar-Kreis, Schwäbisch Hall, Schwarzwald-Baar-Kreis, Stuttgart, Tübingen, Tuttlingen, Ulm.
Psychotherapeuten:
Alb-Donau-Kreis, Bodenseekreis, Breisgau-Hochschwarzwald, Calw, Emmendingen, Enzkreis, Freiburg, Göppingen, Heidelberg, Stadt Karlsruhe, Konstanz, Mannheim, Ortenaukreis, Pforzheim, Ravensburg, Reutlingen, Rhein-NeckarKreis, Schwarzwald-Baar-Kreis, Sigmaringen, Stuttgart, Tübingen, Ulm, Waldshut, Zollernalbkreis.
Urologen:
Alb-Donau-Kreis, Baden-Baden/ Rastatt, Biberach, Böblingen, Bodenseekreis, Breisgau-Hochschwarzwald, Calw, Emmendingen, Enzkreis, Esslingen, Freiburg, Freudenstadt, Göppingen, Heidelberg, Heidenheim, Landkreis
Heilbronn, Stadt Heilbronn, Hohenlohekreis, Landkreis Karlsruhe, Stadt Karlsruhe, Konstanz, Lörrach, Ludwigsburg, MainTauber-Kreis, Mannheim, NeckarOdenwald-Kreis, Ortenaukreis, Ostalbkreis, Pforzheim, Ravensburg, Rems-Murr-Kreis, Reutlingen,
Rhein-Neckar-Kreis, Rottweil, Schwäbisch Hall, SchwarzwaldBaar-Kreis, Sigmaringen, Stuttgart, Tübingen, Tuttlingen, Ulm, Waldshut, Zollernalbkreis.
Spezialisierte fachärztliche Versorgung: Anästhesisten:
Region Bodensee-Oberschwaben, Region Donau-Iller, Region Heilbronn-Franken, Region Hochrhein-Bodensee, Region Mittlerer Oberrhein, Region Neckar-Alb, Region Nordschwarzwald, Region Ostwürttemberg, Region Rhein-Neckar, Region Schwarzwald-Baar-Heuberg, Region Stuttgart, Region Südlicher Oberrhein.
Fachärztlich tätige Internisten: Region Bodensee-Oberschwaben, Region Donau-Iller, Region Heilbronn-Franken, Region Hochrhein-Bodensee, Region Mittlerer Oberrhein, Region Neckar-Alb, Region Nordschwarzwald, Region Ostwürttemberg, Region Rhein-Neckar, Region Schwarzwald-Baar-Heuberg, Region Stuttgart, Region Südlicher Oberrhein.
Kinder- und Jugendpsychiater: Region Donau-Iller, Region Rhein-Neckar, Region Südlicher Oberrhein.
Radiologen: Region Bodensee-Oberschwaben, Region Donau-Iller, Region Heilbronn-Franken, Region Hochrhein-Bodensee, Region Mittlerer Oberrhein, Region Neckar-Alb, Region Nordschwarzwald, Region Ostwürttemberg, Region Rhein-Neckar, Region Schwarzwald-Baar-Heuberg, Region Stuttgart, Region Südlicher Oberrhein.
Gesonderte fachärztliche
Versorgung:
Humangenetiker:
Land Baden-Württemberg.
Laborärzte:
Land Baden-Württemberg.
Neurochirurgen:
Land Baden-Württemberg.
Strahlentherapeuten:
Land Baden-Württemberg.
Transfusionsmediziner:
Land Baden-Württemberg.
Feststellung, dass der allgemeine bedarfsgerechte Versorgungsgrad um 40 Prozent überschritten ist
Der Landesausschuss der Ärzte und Krankenkassen für BadenWürttemberg stellt mit Beschluss vom 21. Juni 2023 gem. § 103 Abs. 1 Satz 3 SGB V arztgruppenbezogen nach Maßgabe der Planungsblätter fest, dass in folgenden Planungsbereichen ein Versorgungsgrad von 140 Prozent erreicht oder überschritten ist:
Allgemeine fachärztliche
Versorgung:
Augenärzte:
Freiburg, Heidelberg, Stadt Heilbronn, Konstanz, Pforzheim, Ulm. Chirurgen und Orthopäden: Alb-Donau-Kreis, Baden-Baden/ Rastatt, Bodenseekreis, Freiburg, Göppingen, Heidelberg, Stadt Heilbronn, Stadt Karlsruhe, Konstanz, Main-Tauber-Kreis, Pforzheim, Ravensburg, Reutlingen, Rottweil, Schwarzwald-Baar-Kreis, Stuttgart, Tübingen, Ulm.
Frauenärzte: Bodenseekreis, Emmendingen, Ulm.
HNO-Ärzte: Ulm.
Hautärzte:
Alb-Donau-Kreis, Baden-Baden/ Rastatt, Bodenseekreis, BreisgauHochschwarzwald, Freiburg, Heidelberg, Heidenheim, Stadt Heilbronn, Konstanz, Main-TauberKreis, Tübingen.
Kinderärzte: Bodenseekreis, Heidelberg.
Nervenärzte:
Emmendingen, Freiburg, Heidelberg, Stadt Heilbronn, Konstanz, Stuttgart, Tübingen, Ulm.
Psychotherapeuten:
Breisgau-Hochschwarzwald, Freiburg, Heidelberg, Stadt Karlsruhe, Konstanz, Mannheim, Ravensburg, Tübingen, Zollernalbkreis.
Urologen:
Bodenseekreis, Freiburg, Heidelberg, Stadt Heilbronn, Ulm, Waldshut.
Spezialisierte fachärztliche Versorgung:
Anästhesisten: Region Donau-Iller, Region Neckar-Alb, Region Nordschwarzwald, Region Rhein-Neckar, Region Südlicher Oberrhein. Fachärztlich tätige Internisten: Region Donau-Iller, Region Mittlerer Oberrhein, Region Neckar-Alb, Region Rhein-Neckar, Region Südlicher Oberrhein. Kinder- und Jugendpsychiater: Region Südlicher Oberrhein.
Radiologen: Region Donau-Iller, Region Rhein-Neckar, Region Stuttgart.
Gesonderte fachärztliche Versorgung:
Humangenetiker: Land Baden-Württemberg.
Aufhebung von Zulassungsbeschränkungen Der Landesausschuss der Ärzte und Krankenkassen für BadenWürttemberg stellt mit Beschluss vom 21. Juni 2023 gemäß § 103 Abs. 3 SGB V i. V. mit § 16 b Abs. 3 Ärzte-ZV fest, dass für die nachstehenden Arztgruppen in den genannten Planungsbereichen in Baden-Württemberg die Voraussetzungen für eine Überversorgung entfallen sind. Er hebt daher insoweit die mit früheren Beschlüssen angeordneten Zulassungsbeschränkungen auf.
Hausärztliche Versorgung:
Hausärzte: Achern, Freudenstadt.
Allgemeine fachärztliche Versorgung:
Augenärzte: Göppingen.
HNO-Ärzte:
Schwäbisch Hall.
Kinderärzte:
Hohenlohekreis, Neckar-Odenwald-Kreis.
Nervenärzte: Landkreis Heilbronn, Ravensburg. Psychotherapeuten: Lörrach.
ÄBW 07 | 2023 Bekanntmachungen
Der Landesausschuss versieht mit verbindlicher Wirkung für die Zulassungsausschüsse seine Aufhebungsbeschlüsse mit der Auflage, dass Zulassungen – soweit sie bei der Ermittlung des Versorgungsgrades zu berücksichtigen sind – nur in einem solchen Umfang erfolgen dürfen, bis für die Arztgruppe Überversorgung eingetreten ist. Zulassungen nach § 101 Abs. 1 Satz 1 Nr. 4 SGB V und Anstellungen nach § 101 Abs. 1 Satz 1 Nr. 5 SGB V sind vorrangig umzuwandeln und bei der Arztzahl der jeweiligen Arztgruppe mitzurechnen, wobei die Zulassungen nach Nr. 4 den Anstellungen voran gehen. Maßgeblich für die Beendigung der Zulassungs- und Leistungsbegrenzung ist die Reihenfolge der jeweils längsten Dauer der gemeinsamen Berufsausübung oder der Anstellung. Ist danach noch keine Überversorgung eingetreten, ist über entsprechende Anträge auf (Neu-)Zulassung zu entscheiden, die mit den nach § 18 Ärzte-ZV erforderlichen vollständigen Unterlagen innerhalb einer Bewerbungsfrist bis einschließlich 16. August 2023 beim jeweils zuständigen Zulassungsausschuss eingegangen sind. Die Entscheidung erfolgt nach pflichtgemäßem Ermessen unter Berücksichtigung der beruflichen Eignung, der Dauer der bisherigen ärztlichen Tätigkeit, des Approbationsalters und der Dauer der Eintragung in die Warteliste für den jeweiligen Planungsbereich. Bei hiernach gleicher Eignung von Bewerbern soll die räumliche Wahl des Vertragsarztsitzes im Hinblick auf die bestmögliche Patientenversorgung, Entscheidung nach Versorgungsgesichtspunkten sowie die Belange von Menschen mit Behinderung beim Zugang zur Versorgung berücksichtigt werden.
Anordnung von Zulassungsbeschränkungen
Der Landesausschuss der Ärzte und Krankenkassen für BadenWürttemberg stellt mit Beschluss vom 21. Juni 2023 fest, dass für bestimmte Arztgruppen eine Überversorgung vorliegt. Er ordnet daher gemäß § 103 Abs. 1 Satz 2 SGB V i. V. mit § 16 b Abs. 2 Ärzte-ZV mit verbindlicher Wirkung Zulassungsbeschränkungen an, und zwar für die nachstehenden Planungsbereiche:
Hausärztliche Versorgung:
Hausärzte: Mannheim, Offenburg, Rottenburg, Wiesloch/Walldorf.
Allgemeine fachärztliche
Versorgung:
Augenärzte:
Landkreis Heilbronn, Rems-Murr-Kreis.
Frauenärzte: Böblingen, Stadt Heilbronn. HNO-Ärzte: Göppingen.
Kinderärzte: Freudenstadt, Ortenaukreis, Stuttgart.
Nervenärzte: Göppingen, Rems-Murr-Kreis.
Psychotherapeuten: Alb-Donau-Kreis.
Spezialisierte fachärztliche Versorgung: Kinder- und Jugendpsychiater: Region Donau-Iller.
Feststellung der Mindestversorgungsanteile für die Gruppe der Psychotherapeuten
Der Landesausschuss der Ärzte und Krankenkassen für BadenWürttemberg stellt mit Beschluss vom 21. Juni 2023 fest, dass in den nachstehenden Planungsbereichen für ärztliche Psychotherapeuten ein Mindestversorgungsanteil in Höhe von 25 Prozent und für Ärzte sowie Psychotherapeuten, die ausschließlich Kinder und Jugendliche psychotherapeutisch behandeln, ein Mindestversorgungsanteil in Höhe von 20 Prozent noch nicht ausgeschöpft ist:
Ärztliche Psychotherapeuten: Alb-Donau-Kreis, Enzkreis, Göppingen, Ortenaukreis, Reutlingen, Rhein-Neckar-Kreis, Sigmaringen, Waldshut, Zollernalbkreis.
Der Landesausschuss der Ärzte und Krankenkassen für BadenWürttemberg stellt mit Beschluss vom 21. Juni 2023 gemäß § 101 Abs. 4 Satz 5 SGB V i. V. mit § 25 Abs. 2 Bedarfsplanungs-Richtlinie fest, dass in den nachstehenden Planungsbereichen für Fachärzte für Psychosomatische Medizin und Psychotherapie der Anteil in Höhe von 50 Prozent innerhalb des Mindestversorgungsanteils der ärztlichen Psychotherapeuten noch nicht ausgeschöpft ist:
Psychosomatiker: Bodenseekreis, Calw, Konstanz, Schwarzwald-Baar-Kreis. Der Zulassungsausschuss darf bis zur Höhe der in den Planungsblättern ausgewiesenen Anzahl Zulassungen erteilen. Zulassungen nach § 101 Abs. 1 Satz 1 Nr. 4 SGB V und Anstellungen nach § 101 Abs. 1 Satz 1 Nr. 5 SGB V sind dabei jeweils vorrangig umzuwandeln, wobei die Zulassungen nach Nr. 4 den Anstellungen voran gehen. Maßgeblich für die Beendigung der Zulassungsund Leistungsbegrenzung ist die Reihenfolge der jeweils längsten Dauer der gemeinsamen Berufsausübung oder der Anstellung. Ist danach der vorgesehene Mindestversorgungsanteil noch nicht ausgeschöpft, ist über entsprechende Anträge auf (Neu-)Zulassung zu entscheiden, die mit den nach § 18 Ärzte-ZV erforderlichen vollständigen Unterlagen innerhalb einer Bewerbungsfrist bis einschließlich 16. August 2023 beim jeweils zuständigen Zulassungsausschuss eingegangen sind. Die Entscheidung erfolgt nach pflichtgemäßem Ermessen unter Berücksichtigung der beruflichen Eignung, der Dauer der bisherigen ärztlichen/psychotherapeutischen Tätigkeit, des Approbationsalters und der Dauer
der Eintragung in die Warteliste für den jeweiligen Planungsbereich. Bei hiernach gleicher Eignung von Bewerbern soll die räumliche Wahl des Vertragsarztes/-psychotherapeuten im Hinblick auf die bestmögliche Patientenversorgung, die Entscheidung nach Versorgungsgesichtspunkten sowie die Belange von Menschen mit Behinderung beim Zugang zur Versorgung berücksichtigt werden.
Feststellung
der Mindestversorgungsanteile für die Gruppe der Nervenärzte
Der Landesausschuss der Ärzte und Krankenkassen für BadenWürttemberg mit Beschluss vom 21. Juni 2023 stellt gemäß § 101 Abs. 1 Satz 8 SGB V i. V. mit § 12 Abs. 5 Bedarfsplanungs-Richtlinie fest, dass in den nachstehenden Planungsbereichen der Mindestversorgungsanteil von jeweils 50 Prozent der Differenz aus dem Versorgungsanteil in Höhe von 100 Prozent der regionalen Verhältniszahl und der tatsächlichen Anzahl der Nervenärzte sowie der Ärzte mit doppelter Facharztanerkennung in den Gebieten Neurologie und Psychiatrie einerseits für Neurologen und andererseits für Psychiater sowie Fachärzte für Psychiatrie und Psychotherapie noch nicht ausgeschöpft ist. Weiterhin ist für die Nervenärzte sowie die Ärzte mit doppelter Facharztanerkennung in den Gebieten Neurologie und Psychiatrie ein Mindestversorgungsanteil in Höhe von 25 Prozent noch nicht ausgeschöpft:
Nervenärzte sowie Ärzte mit doppelter Facharztanerkennung in den Gebieten Neurologie und Psychiatrie: Freudenstadt, Hohenlohekreis. Psychiater: Calw, Freudenstadt, Hohenlohekreis, Ludwigsburg, Main-TauberKreis, Schwäbisch Hall.
Der Zulassungsausschuss darf bis zur Höhe der in den Planungsblättern ausgewiesenen Anzahl Zulassungen erteilen. Zulassungen nach § 101 Abs. 1 Satz 1 Nr. 4
ÄBW 07 | 2023 463 Bekanntmachungen
SGB V und Anstellungen nach § 101 Abs. 1 Satz 1 Nr. 5 SGB V sind dabei jeweils vorrangig umzuwandeln, wobei die Zulassungen nach Nr. 4 den Anstellungen voran gehen. Maßgeblich für die Beendigung der Zulassungsund Leistungsbegrenzung ist die Reihenfolge der jeweils längsten Dauer der gemeinsamen Berufsausübung oder der Anstellung. Ist danach der vorgesehene Mindestversorgungsanteil noch nicht ausgeschöpft, ist über entsprechende Anträge auf (Neu-)Zulassung zu entscheiden, die mit den nach § 18 Ärzte-ZV erforderlichen vollständigen Unterlagen innerhalb einer Bewerbungsfrist bis einschließlich 16. August 2023 beim jeweils zuständigen Zulassungsausschuss eingegangen sind. Die Entscheidung erfolgt nach pflichtgemäßem Ermessen unter Berücksichtigung der beruflichen Eignung, der Dauer der bisherigen ärztlichen/psychotherapeutischen Tätigkeit, des Approbationsalters und der Dauer der Eintragung in die Warteliste für den jeweiligen Planungsbereich. Bei hiernach gleicher Eignung von Bewerbern soll die räumliche Wahl des Vertragsarztes/-psychotherapeuten im Hinblick auf die bestmögliche Patientenversorgung, die Entscheidung nach Versorgungsgesichtspunkten sowie die Belange von Menschen mit Behinderung beim Zugang zur Versorgung berücksichtigt werden.
Feststellung der Mindestversorgungsanteile für die Gruppe der Fachinternisten
Der Landesausschuss der Ärzte und Krankenkassen für BadenWürttemberg stellt mit Beschluss vom 21. Juni 2023 gemäß § 101 Abs. 1 Satz 8 SGB V i. V. mit § 13 Abs. 6 Nr. 1 BedarfsplanungsRichtlinie fest, dass in den nachstehenden Planungsbereichen für die Rheumatologen ein Mindestversorgungsanteil in Höhe von 8 Prozent noch nicht ausgeschöpft ist:
Rheumatologen: Region Heilbronn-Franken, Region Hochrhein-Bodensee, Region Nordschwarzwald, Region Ostwürttemberg, Region Schwarzwald-Baar-Heuberg, Region Stuttgart.
Der Zulassungsausschuss darf bis zur Höhe der in den Planungsblättern ausgewiesenen Anzahl Zulassungen erteilen. Zulassungen nach § 101 Abs. 1 Satz 1 Nr. 4 SGB V und Anstellungen nach § 101 Abs. 1 Satz 1 Nr. 5 SGB V sind dabei jeweils vorrangig umzuwandeln, wobei die Zulassungen nach Nr. 4 den Anstellungen voran gehen. Maßgeblich für die Beendigung der Zulassungs- und Leistungsbegrenzung ist die Reihenfolge der jeweils längsten Dauer der gemeinsamen Berufsausübung oder der Anstellung. Ist danach der vorgesehene Mindestversorgungsanteil noch nicht ausgeschöpft, ist über entsprechende Anträge auf (Neu-)Zulassung zu entscheiden, die mit den nach § 18 Ärzte-ZV erforderlichen vollständigen Unterlagen innerhalb einer Bewerbungsfrist bis einschließlich 16. August 2023 beim jeweils zuständigen Zulassungsausschuss eingegangen sind. Die Entscheidung erfolgt nach pflichtgemäßem Ermessen unter Berücksichtigung der beruflichen Eignung, der Dauer der bisherigen ärztlichen/psychotherapeutischen Tätigkeit, des Approbationsalters und der Dauer der Eintragung in die Warteliste für den jeweiligen Planungsbereich. Bei hiernach gleicher Eignung von Bewerbern soll die räumliche Wahl des Vertragsarztes/-psychotherapeuten im Hinblick auf die bestmögliche Patientenversorgung, die Entscheidung nach Versorgungsgesichtspunkten sowie die Belange von Menschen mit Behinderung beim Zugang zur Versorgung berücksichtigt werden.
Feststellung der Höchstversorgungsanteile für die Gruppe der Fachinternisten
Der Landesausschuss der Ärzte und Krankenkassen für BadenWürttemberg stellt mit Beschluss vom 21. Juni 2023 gemäß § 101 Abs. 1 Satz 8 SGB V i. V. mit § 13 Abs. 6 Nr. 2 bis 5 BedarfsplanungsRichtlinie fest, dass in den nachstehenden Planungsbereichen für Kardiologen ein Höchstversorgungsanteil in Höhe von 33 Prozent, für Gastroenterologen ein Höchstversorgungsanteil in Höhe von 19 Prozent, für Pneumologen ein Höchstversorgungsanteil inHöhe von 18 Prozent und für Nephrologen ein Höchstversorgungsanteil in Höhe von 25 Prozent erreicht bzw. überschritten ist:
Kardiologen: Region Bodensee-Oberschwaben, Region Donau-Iller, Region Heilbronn-Franken, Region Hochrhein-Bodensee, Region Mittlerer Oberrhein, egion Neckar-Alb, Region Rhein-Neckar, Region Schwarzwald-Baar-Heuberg, Region Stuttgart, Region Südlicher Oberrhein.
Gastroenterologen: Region Bodensee-Oberschwaben, Region Donau-Iller, Region Mittlerer Oberrhein, Region Neckar-Alb, Region Nordschwarzwald, Region Rhein-Neckar, Region Schwarzwald-Baar-Heuberg, Region Stuttgart.
Pneumologen: Region Donau-Iller, Region Hochrhein-Bodensee, Region Ostwürttemberg, Region Rhein-Neckar.
Nephrologen: Region Mittlerer Oberrhein, Region Neckar-Alb, Region Nordschwarzwald, Region Rhein-Neckar, Region Schwarzwald-Baar-Heuberg, Region Südlicher Oberrhein.
Der Zulassungsausschuss hat bei Zulassungen und Nachbesetzungen eines Fachinternisten sicherzustellen, dass die Höchstversorgungsanteile nicht überschritten werden.
Der Landesausschuss der Ärzte und Krankenkassen für BadenWürttemberg stellt mit Beschluss vom 21. Juni 2023 gemäß § 101 Abs. 1 Satz 8 SGB V i. V. mit § 13 Abs. 6 Nr. 2 bis 5 BedarfsplanungsRichtlinie fest, dass in den nachstehenden Planungsbereichen für Kardiologen ein Höchstversorgungsanteil in Höhe von 33 Prozent, für Gastroenterologen ein Höchstversorgungsanteil in Höhe von 19 Prozent, für Pneumologen ein Höchstversorgungsanteil in Höhe von 18 Prozent und für Nephrologen ein Höchstversorgungsanteil in Höhe von 25 Prozent noch nicht erreicht ist:
Kardiologen: Region Nordschwarzwald, Region Ostwürttemberg.
Gastroenterologen: Region Heilbronn-Franken, Region Hochrhein-Bodensee, Region Ostwürttemberg, Region Südlicher Oberrhein.
Pneumologen: Region Bodensee-Oberschwaben, Region Heilbronn-Franken, Region Mittlerer Oberrhein, Region Neckar-Alb, Region Nordschwarzwald, Region Schwarzwald-Baar-Heuberg, Region Stuttgart, Region Südlicher Oberrhein.
Nephrologen: Region Bodensee-Oberschwaben, Region Donau-Iller, Region Heilbronn-Franken, Region Hochrhein-Bodensee, Region Ostwürttemberg, Region Stuttgart.
Der Zulassungsausschuss hat bei Zulassungen und Nachbesetzungen eines Fachinternisten sicherzustellen, dass die Höchstversorgungsanteile nicht überschritten werden.
Stuttgart, 21. Juni 2023
Landesausschuss der Ärzte und Krankenkassen für Baden-Württemberg
Dr. Felix Tausch Vorsitzender
464 ÄBW 07 | 2023 Bekanntmachungen
Landesärztekammer
Baden-Württemberg
Geschäftsstelle:
Jahnstraße 40
70597 Stuttgart (Degerloch)
Telefon (07 11) 7 69 89-0
Fax (07 11) 7 69 89-50
Weitere Infos unter www.laek-bw.de
Archiv-Web-Seminar „ePA-Fortbildung“
Termin:
1. Juli 2023 bis 31. Dezember 2023
Die Landesärztekammer möchte mit dieser hoch qualifiziert besetzten Fortbildung ihren Teil dazu beitragen, die Möglichkeiten der elektronischen Patientenakte (ePA) den Ärztinnen und Ärzten näher zu bringen und wichtige Informationen zur Anwendung zu vermitteln.
Neben einer allgemeinen Vorstellung des Aufbaus und der Funktionen der ePA wird zunächst aus ärztlicher Sicht ein Blick auf die Einsatzmöglichkeiten geworfen. Anschließend wird die ePA einer juristischen Betrachtung unterworfen. Die abschließende Frage- und Antwortrunde hat das Ziel, alle mit der ePA verbundenen Fragen, einschließlich Haftungsfragen, zu beantworten.
Seit Beginn des Jahres 2021 sind die gesetzlichen Krankenkassen verpflichtet, ihren Mitgliedern eine elektronische Patientenakte kostenlos als App zur Verfügung zu stellen. Dabei muss der Versicherte selbst aktiv werden und bei seiner Krankenkasse zunächst einen Zugang für die Nutzung der ePA beantragen (opt-in-Verfahren).
Fehlende technische Voraussetzungen in den Praxen und Kliniken, ein gegenwärtig minimalistischer inhaltlicher Aufbau, fehlende elektronische Gesundheitskarten der Generation 2 bei den Patienten erschweren die flächendeckende Verbreitung und Anwendung der ePA. Die tatsächlichen Nutzerzahlen sind daher bis heute äußerst gering;
sie liegen derzeit bei zirka 0,4 Prozent aller gesetzlich Versicherten. Dennoch soll die ePA ein zentraler Baustein des künftigen Gesundheitswesens werden. Der Sachverständigenrat zur Begutachtung der Entwicklung im Gesundheitswesen hat sich in seinem Gutachten für den flächendeckenden Einsatz der ePA ausgesprochen, da durch den zeitnahen Zugang zu strukturierten und konsistenten Informationen eine bedarfsgerechte und koordinierte Versorgung ermöglicht werden kann. Die neue Bundesregierung sieht in ihrem Koalitionsprogramm vor, die Nutzung der ePA durch die Umstellung auf ein opt-out-Verfahren zu fördern. Die zweite Ausbaustufe der ePA, inklusive eines feingranularen Rechtesystems, steht für das Jahr 2022 an. Es ist daher davon auszugehen, dass die Zahl der Patienten, die eine ePA nutzen wollen, in den nächsten Wochen und Monaten steigen wird. Aufgrund eines bestehenden EU React Förderprojekts wird diese mit zwei Punkten anerkannte Fortbildung für Ärztinnen und Ärzte kostenfrei angeboten.
Programm:
Begrüßung & Einleitung
Anmoderation Ärztekammer
Modul 1: Einführung in die Thematik ePA (Bedarf, Nutzen etc.) aus Sicht eines Arztes.
Modul 2: Erläuterung der ePA (Funktionsweise, Sicherheit, „ePA-Demonstrator“ etc.)
Modul 3: Erläuterung juristischer Fragestellungen zur ePA (Haftung, Datenschutz etc.) durch einen Juristen.
Modul 4: Fragen & Diskussion unter Moderation der Ärztekammer.
Teilnahmebetrag:
Die Veranstaltung ist kostenfrei.
Fortbildungspunkte:
Die Veranstaltung ist mit 2 Punkten auf das Fortbildungszertifikat der Landesärztekammer BadenWürttemberg anerkannt.
Anmeldung:
ausschließlich online auf der Website der Landesärztekammer
Baden-Württemberg:
www.aerztekammer-bw.de/fobi
Ansprechpartner: Landesärztekammer Baden-Württemberg Abteilung Fortbildung und Qualitätssicherung, Herr Mangold Jahnstr. 40, 70597 Stuttgart
Telefon (07 11) 7 69 89-46 00
Fax (07 11) 7 69 89-88 46 00
E-Mail: fortbildungen@laek-bw.de
Homepage: www.aerztekammer-bw.de
Archiv-Web-Seminar „Medizindidaktische Fortbildung für Moderatoren, Tutoren, Referenten und Kursleiter“
Ein Archiv-Web-Seminar der Landesärztekammer BadenWürttemberg. Aufzeichnung der neokom.tv, Video- und E-Learning-Agentur GmbH, Weidachstr. 5, 70597 Stuttgart
Termin;
1. Juli 2023 bis 31. Dezember 2023
In diesem Seminar wollen wir Ihnen einen praktischen Leitfaden für die Entwicklung und Durchführung professioneller und wirksamer Live-Online-Seminare für medizinische Fachkreise an die Hand geben, mit der Sie zum Beispiel Vorträge auf virtuellen Medizinkongressen, akkreditierte Online-Fortbildungen, aber auch virtuelle Arbeitsgruppen und Expertenrunden zukünftig effektiver und deutlich entspannter halten können.
Die Teilnahme lohnt sich für Sie vor allem, wenn Sie in kurzer Zeit einen Online-Vortrag gestalten oder vorhandene Präsentationsunterlagen für den Einsatz in LiveOnline-Events optimieren möchten, um eine maximale Wirkung zu erzielen. Sie erhalten einen Überblick über den Ablauf eines professionellen Live-Online-Seminars, die Zusammenarbeit mit Live-Online-Moderatoren und weiteren Helfern und dem Einsatz der notwendigen Technik von Webcam bis zum digitalen Whiteboard. Zudem erfahren Sie, wie Sie Ihren Arbeitsplatz für LiveOnline-Seminare ergonomisch einrichten und vor der Webcam gleichzeitig eine gute Figur machen. Dabei schauen wir uns aber
nicht nur die technischen Voraussetzungen zur Durchführung effektiver Live-Online-Seminare an. Besonders beschäftigen wir uns auch mit der Frage, wie Sie im Live-Online-Seminar eine Verbindung zu Ihren Teilnehmern herstellen und einen echten, interaktiven Austausch erreichen können.
Programm:
Modul 1:
Technische Grundlagen Modul 1 behandelt die technischen Grundlagen für die Durchführung von Live-Online-Veranstaltungen.
Die Teilnehmer lernen technische Hintergründe und Funktionen von VC- Systemen mit ihren Rollenmodellen und Aufgabenverteilungen kennen und erhalten Tipps für die Auswahl der richtigen Technik und der Einrichtung eines eigenen Online-SeminarArbeitsplatzes
Modul 2: Live-Online-Moderation
Modul 2 behandelt Ablauf und Dramaturgie von Live-OnlineVeranstaltungen und richtet sich sowohl an Moderatoren wie auch an Referenten.
Sie lernen die einzelnen Phasen einer spannenden und abwechslungsreichen Veranstaltung kennen und können eigene Veranstaltungskonzepte entwickeln.
Modul 3: Inhalte entwickeln und gestalten
Die Präsentation ist im OnlineVortrag – neben der Stimme des Referenten – das wichtigste Informationsmedium. Gleichzeitig ist die Vortragssituation für den Referenten eine völlig andere wie im Präsenzvortrag: Er präsentiert ohne direktes Feedback vom Publikum alleine vor der Linse der Kamera.
In Modul 3 lernen Sie, wie Sie ansprechende, aktivierende und unterhaltende Vortragsfolien gestalten und souverän vortragen.
Modul 4:
Interaktionen gekonnt einsetzen
In diesem Modul lernen Sie, die interaktiven Funktionen des VCSystems, wie Whiteboards, Umfragen, Polls u. v. m. sinnvoll und für verschiedene Phasen im LiveOnline-Event einzusetzen.
ÄBW 07 | 2023 465 Bekanntmachungen
Teilnahmebetrag:
Die Veranstaltung ist kostenfrei. Fortbildungspunkte: Die Veranstaltung ist mit 3 Punkten auf das Fortbildungszertifikat der Landesärztekammer BadenWürttemberg anerkannt.
Anmeldung:
ausschließlich online auf der Website der Landesärztekammer BadenWürttemberg: www.aerztekammerbw.de/fobi
Ansprechpartner:
Landesärztekammer
BadenWürttemberg
Abteilung Fortbildung und Qualitätssicherung, Herr Mangold
Jahnstr. 40, 70597 Stuttgart
Telefon (07 11) 7 69 89-46 00
Fax (07 11) 7 69 89-88 46 00
E-Mail: fortbildungen@laek-bw.de
Homepage: www.aerztekammer-bw.de
Online-Infoveranstaltung zum elektronischen Logbuch (eLogbuch)
Für weiterbildungsbefugte
Ärztinnen und Ärzte
Eine Veranstaltung der Landesärztekammer Baden-Württemberg
Termin:
Montag, 24. Juli 2023 18.30–20.00 Uhr
In dieser Veranstaltung wird über Inhalt und Funktionsweise des elektronischen Logbuches informiert. Die Veranstaltung richtet sich speziell an weiterbildungsbefugte Ärztinnen und Ärzte. Es wird Aufbau und Anwendung des eLogbuchs dargestellt. Die Veranstaltung soll insbesondere dazu beitragen, Unsicherheiten im Umgang mit dem eLogbuch auszuräumen und die verpflichtende Dokumentation im eLogbuch zu erleichtern.
Im Anschluss an den Vortrag von Herr Zolg ist Zeit, Ihre Fragen zu stellen und zu diskutieren.
Programm:
Moderation:
Ulrike Hespeler, Landesärztekammer Baden-Württemberg
Begrüßung und Einführung
Grußwort
Dr. med. Wolfgang Miller, Präsident der Landesärztekammer
Baden-Württemberg
Demonstration des eLogbuchs
Vortrag und Diskussion
André R. Zolg, M. Sc., Referent, Bundesärztekammer, Dezernat 2
Fortbildungspunkte:
Die Veranstaltung ist mit 2 Punkten auf das Fortbildungszertifikat der Landesärztekammer Baden-Württemberg anerkannt.
Teilnahmebetrag:
Die Veranstaltung ist kostenfrei.
Anmeldung: ausschließlich online auf der Webseite der Landesärztekammer Baden-Württemberg: www.aerztekammer-bw.de/fobi
Ansprechpartner: Landesärztekammer
Baden-Württemberg
Abteilung Fortbildung und Qualitätssicherung, Frau Hagdorn
Jahnstr. 40, 70597 Stuttgart
Telefon (07 11) 7 69 89-830
Fax (07 11) 7 69 89-88 08 30
E-Mail: fortbildungen@laek-bw.de
Homepage: www.aerztekammer-bw.de
Online-Infoveranstaltung zum elektronischen Logbuch (eLogbuch)
Für Ärztinnen und Ärzte in Weiterbildung
Eine Veranstaltung der Landesärztekammer
Baden-Württemberg
Termin:
Donnerstag, 27. Juli 2023 18.30–20.00 Uhr
In dieser Veranstaltung wird über Inhalt und Funktionsweise des elektronischen Logbuches informiert. Die Veranstaltung richtet sich speziell an Ärztinnen und Ärzte in Weiterbildung. Es wird Aufbau und Anwendung des eLogbuchs dargestellt. Die Veranstaltung soll insbesondere dazu beitragen, Unsicherheiten im Umgang mit dem eLogbuch auszuräumen und die verpflichtende Dokumentation im eLogbuch zu erleichtern.
Im Anschluss an den Vortrag von Herr Zolg ist Zeit, Ihre Fragen zu stellen und zu diskutieren.
Programm:
Moderation: Ulrike Hespeler, Landesärztekammer Baden-Württemberg
Begrüßung und Einführung
Grußwort
Dr. med. Wolfgang Miller, Präsident der Landesärztekammer Baden-Württemberg
Demonstration des eLogbuchs
Vortrag und Diskussion
André R. Zolg, M. Sc., Referent, Bundesärztekammer, Dezernat 2
Fortbildungspunkte: Die Veranstaltung ist mit 2 Punkten auf das Fortbildungszertifikat der Landesärztekammer BadenWürttemberg anerkannt.
Teilnahmebetrag: Die Veranstaltung ist kostenfrei.
Anmeldung: ausschließlich online auf der Webseite der Landesärztekammer BadenWürttemberg: www.aerztekammerbw.de/fobi Ansprechpartner: Landesärztekammer BadenWürttemberg Abteilung Fortbildung und Qualitätssicherung, Frau Hagdorn
Jahnstr. 40, 70597 Stuttgart
Telefon (07 11) 7 69 89830
Fax (07 11) 7 69 8988 08 30
EMail: fortbildungen@laekbw.de
Homepage: www.aerztekammerbw.de
Online-Symposium „Substitutionsbehandlung opioidabhängiger Menschen“
Eine Veranstaltung des Ausschusses „Suchtmedizin“ der Landesärztekammer Baden-Württemberg
Termin:
Mittwoch, 22. November 2023 10.00–16.00 Uhr
Unter den Suchtstoffen ist nach wie vor bezogen auf das individuelle Risiko, Heroin die „gefährlichste“ Substanz. Bei keiner anderen legalen oder illegalen Droge ist der soziale Schaden, die Abhängigkeitsentwicklung und
der physische Schaden für den Einzelnen so hoch wie bei dem Konsum von Heroin. Die Zahl der Drogentoten ist im vergangenen Jahr erneut angestiegen. Dabei stehen über die Substitutionsbehandlung wirksame Behandlungsmaßnahmen zur Verfügung. In unserem diesjährigen Suchtsymposium geben wir einen Überblick über die state of the art Behandlung, den Rechtsrahmen, die Honorierung, bisherige und innovative Versorgungsmodelle.
Programm:
Einführung und Moderation
Dr. med. Paula Hezler-Rusch Vorsitzende des Ausschusses „Suchtmedizin“ der Landesärztekammer Baden-Württemberg
Anette Henninger
Ärztliche Leitung Abteilung Fortbildung und Qualitätssicherung der Landeärztekammer BadenWürttemberg
Begrüßung
Dr. med. Wolfgang Miller
Präsident der Landesärztekammer Baden-Württemberg
Grußwort
Minister Manne Lucha MdL Ministerium für Soziales, Gesundheit und Integration Baden-Württemberg
state of the art der Opioidagonistentherapie –Anregungen aus der Schweiz Vortrag und Diskussion
Rechtsvorschriften:
BtmVV und Bundesärztekammer Richtlinie
Impulsvortrag
Qualität der Substitution
Die Arbeit der QS-Kommission der KV
Impulsvortrag
Mittagspause
– Verschiedene Blickwinkel der Substitution –Modellprojekt videogestützte Substitution
Sicht der Psychosozialen Beratungs- und ambulanten Behandlungsstellen für Suchtgefährdete und Suchtkranke (PSB)
466 ÄBW 07 | 2023
Bekanntmachungen
Impulsvortrag
Substitutionsambulanz an einem Klinikum –
Möglichkeiten der multiprofessionellen Vernetzung Impulsvortrag
Substitution in der niedergelassenen Arztpraxis
Impulsvortrag
Fördermaßnahmen der KV Impulsvortrag
Pause
Podiumsgespräch –Die Zukunft der Substitutionsbehandlung opioidabhängiger Menschen
Abschluss
Anmeldung:
ausschließlich über das Portal der Landesärztekammer bis zum 20. 11. 2023 möglich: www.aerztekammer-bw.de/fobi
Unkostenbeitrag:
Die Teilnahme an der Veranstaltung ist kostenfrei Fortbildungspunkte:
Die Veranstaltung ist mit 6 Punkten auf das Fortbildungszertifikat der Landesärztekammer BadenWürttemberg anerkannt.
Ansprechpartner: Landesärztekammer Baden-Württemberg
Abteilung Fortbildung und Qualitätssicherung, Frau Hagdorn
Jahnstr. 40, 70597 Stuttgart
Telefon (07 11) 7 69 89-830
Fax (07 11) 7 69 89-88 08 30
E-Mail: fortbildungen@laek-bw.de
Refresherkurs
„Verkehrsmedizinische Begutachtung“ für Fachärzte mit „Verkehrsmedizinischer Qualifikation“
Eine Live-Online-Veranstaltung der Landesärztekammer Baden-Württemberg
Termin:
Samstag, 9. Dezember 2023 9.30–16.00 Uhr
Die Landesärztekammer BadenWürttemberg bietet seit 1999 den Kurs zur „Verkehrsmedizinischen Begutachtung“, auf Basis des 16-Stunden-Curriculums der Bundesärztekammer, an. 2016 erfolgte eine Überarbeitung des
Curriculums. Neue wissenschaftliche Erkenntnisse und inhaltlich erweiterte europäische Regelungen, die sich auf die deutsche Fahrerlaubnisverordnung (FeV) auswirken, sowie die als notwendig erachtete Verbesserung der Gutachtenqualität, machten diese erforderlich.
Der Stundenumfang der verkehrsmedizinischen Qualifikation nach § 11 Abs. 2 Satz 3 Nr. 1 FeV hat sich dadurch von 16 auf 24 (Modul I bis IV) erhöht.
Aufgrund der sukzessiven Änderungen und Ergänzungen der Fahrerlaubnis-Verordnung (FeV) und der Begutachtungsleitlinien der Bundesanstalt für Straßenwesen BASt, bietet die Landesärztekammer Baden-Württemberg einen eintägigen Refresherkurs zur verkehrsmedizinischen Begutachtung an.
Die Fortbildung richtet sich vorrangig an Fachärzte die bereits die „Verkehrsmedizinische Qualifikation“ vor 2017 erworben haben und sich gerne über rechtliche und medizinische Entwicklungen/ Änderungen/Ergänzungen in der verkehrsmedizinischen Begutachtung informieren möchten.
Programm:
9.30–9.40 Uhr
Begrüßung – Einführung –Moderation
Anette Henninger
Fachärztin, Leiterin Abteilung Fortbildung und Qualitätssicherung der Landesärztekammer
Baden-Württemberg, Stuttgart
9.40–10.40 Uhr
Rechtliche Entwicklungen und Änderungen auf EU- und Bundesebene
Fahrerlaubnis-Verordnung
(FeV) und Begutachtungsleitlinien zur Kraftfahreignung
Dr. med. Almut Schönermarck Freiberufliche verkehrsmedizinische Gutachterin, München
10.40–12.40 Uhr
Entwicklungen – Änderungen –Ergänzungen aus medizinischer Sicht auf Basis der Begutachtungsleitlinien zur Kraftfahreignung
Dr. med. Marcus Pandur
Freiberuflicher MPU-Gutachter im Auftrag der pima-mpu GmbH, Oberschleißheim
12.40–13.10 Uhr
Mittagspause
13.10–14.10 Uhr
Medizinisches Cannabis und Fahreignung
Dr. med. Marcus Pandur
14.10–15.40 Uhr
Gutachtenerstellung
Aktualisierte Grundlagen und praktische Übungen
Dr. med. Kirsten M. Stein selbstständig, öffentlich bestellte Gerichtsärztin, Eppelheim
15.40–16.00 Uhr
Resümee
Anette Henninger
Landesärztekammer
Baden-Württemberg
Anmeldung:
Anmeldung erforderlich!
ausschließlich online über das Portal der Landesärztekammer: www.aerztekammer-bw.de/fobi
Teilnehmerbeitrag: 160,– Euro
Fortbildungspunkte:
Die Veranstaltung ist mit 8 Punkten auf das Fortbildungszertifikat der Landesärztekammer
Baden-Württemberg anerkannt.
Kontakt:
Landesärztekammer
Baden-Württemberg

Abteilung Fortbildung und Qualitätssicherung, Frau Schreck
Jahnstraße 40, 70597 Stuttgart
Telefon (07 11 ) 7 69 89-426
Fax (07 11) 7 69 89-88 04 26
E-Mail: fortbildungen@laek-bw.de
Homepage: www.aerztekammer-bw.de
Fortbildungen der Bezirksärztekammer Nordwürttemberg

Aus Gründen der besseren Lesbarkeit wird auf die gleichzeitige Verwendung der Sprachformen männlich, weiblich und divers (m/w/d) verzichtet. Sämtliche Personenbezeichnungen gelten gleichermaßen für alle Geschlechter.
Notfalltraining in Ihrer Arztpraxis
Jemand wird im Wartezimmer bewusstlos, ein Patient erleidet einen Schlaganfall oder im schlimmsten Fall einen HerzKreislauf-Stillstand. Notfälle passieren!
Sind Sie darauf vorbereitet?
Wir unterstützen Sie bei der Vorbereitung in Ihrer Praxis. Unsere Trainer besprechen mit Ihnen den Ablauf im Notfall, geben Tipps zu Ihrer Ausstattung und üben mit Ihnen und Ihrem Team Notfallsituationen direkt vor Ort. Ziel des Trainings ist es, höhere Sicherheit in der Versorgung von Notfallpatienten zu vermitteln, die notfallmedizinischen Kenntnisse aufzufrischen und Ihr Personal als Einheit agieren zu lassen. Vom Erkennen eines Notfallpatienten bis zur Übergabe an den Notarzt wird die Behandlung und Organisation durchgesprochen und praktisch umgesetzt. Durch die Übung wird das Erlernte gefestigt.
Termin:
individuell auf Anfrage/ Zeitrahmen 4 Stunden
Zielgruppe: Ärzte aller Fachrichtungen, Praxisteam Ansprechpartner und
ÄBW 07 | 2023 467 Bekanntmachungen Geschäftsstelle: Jahnstraße 5 70597 Stuttgart (Degerloch) Telefon (07 11) 7 69 81-0 Fax (07 11) 7 69 81-5 00
Anmeldung: Fachbereich
Arbeitsschutz & Notfallmedizin, Jahnstr. 5, 70597 Stuttgart, Telefon (07 11) 7 69 81-212, Fax (07 11) 7 69 81-500, E-Mail: notfallmedizin@baek-nw.de
Teilnehmerbeitrag:
Die Kosten für ein Notfalltraining mit max. 10 Teilnehmern (größere Gruppen auf Anfrage) belaufen sich auf 220,– Euro zzgl. Fahrtkosten von 0,30 Euro/km.
Veranstaltungsort: in Ihrer Praxis Änderungen bleiben vorbehalten.
Alternativbetreuung
Sie wünschen sich eine einfache und effektive Umsetzung des Arbeitsschutzes in Ihrer Praxis?
Mit der Alternativbetreuung haben Sie in diesem Bereich ein Angebot, das speziell auf niedergelassene Ärzte zugeschnitten ist. Sie als Praxisinhaber kennen die Stärken und Schwächen Ihrer Praxis am besten und können mit dieser Form der Betreuung den Arbeitsschutz weitestgehend selbst übernehmen und nach Ihrem individuellen Bedarf gestalten. Zudem können Sie die Synergie mit Ihrem QM-System nutzen, in dem viele Vorgaben des Arbeitsschutzes bereits umgesetzt sind. Die Alternativbetreuung wird in Kooperation mit der Berufsgenossenschaft für Gesundheit und Wohlfahrtspflege angeboten.
Unsere Leistungen:
• Erstschulung zu Beginn der Alternativbetreuung als „Motivations- und Informationsmaßnahme“ mit Tipps und Hilfen zur Umsetzung in der Praxis
• Begehung Ihrer Praxis durch einen Arbeitsschutzexperten –auf Wunsch oder bei konkretem Bedarf
• Beratung bei Arbeitsschutzfragen
• Unterstützung bei anlassbezogener Betreuung, telefonisch oder vor Ort
• Fortbildungsschulung, die innerhalb von 5 Jahren zur Aktualisierung Ihrer Arbeitsschutzkenntnisse vorgeschrieben ist Diese Leistungen sind mit der Jahresgebühr für Einzel- oder Gemeinschaftspraxen abgedeckt. Die arbeitsmedizinische Vorsorgeuntersuchung ist kein Bestand-
teil der Alternativbetreuung und muss gesondert veranlasst werden.
Termin: online
Mittwoch, 18. Oktober 2023 17.00–22.00 Uhr
Zielgruppe:
Niedergelassene Ärzte
Anmeldung:
www.baek-nw.de/akademie
Ansprechpartner: Fachbereich Arbeitsschutz, Jahnstr. 5, 70597 Stuttgart, Telefon (07 11) 7 69 81-212, Fax (07 11) 7 69 81-500,
E-Mail: arbeitsschutz@baek-nw.de
Teilnehmerbeitrag: Jahresbeitrag 99,– Euro inkl. MwSt.
Veranstaltungsort:
Online-Seminarraum
Bezirksärztekammer
Nordwürttemberg, Jahnstraße 5, 70597 Stuttgart Fortbildungspunkte: 8 Punkte Änderungen bleiben vorbehalten.
Antibiotic-Stewardship (ABS) –Beauftragter Arzt
Fortbildungsangebot der Bezirksärztekammern Nordwürttemberg und der Bezirksärztekammer Südbaden in Zusammenarbeit mit dem Deutschen Beratungszentrum für Hygiene Krankenhausinfektionen und Antibiotikaresistenzen haben in den vergangenen Jahren stark zugenommen. Ein rationaler und effektiver Einsatz von Antibiotika kann den Problemen der Resistenzentwicklung entgegenwirken und zu einer verbesserten Patientensicherheit führen. Die Bundesregierung hat dafür die Deutsche Antibiotika-Resistenzstrategie (DART) entwickelt, die neben der Prävention nosokomialer Infektionen auf die Bekämpfung von Antibiotikaresistenzen durch einen rationalen Einsatz von Antiinfektiva, dem Antibiotic Stewardship (ABS), abzielt. Der Kurs zum ABS-beauftragten Arzt, der nach dem Curriculum der Bundesärztekammer aufgebaut ist, ermöglicht Ihnen, Ihre Kenntnisse und Erfahrungen in rationaler Antiinfektivastrategie aufzufrischen und zu vertiefen. ABS-beauftragte Ärzte können
als abteilungsbezogene Ansprechpartner für Fragen rund um einen rationalen Antibiotikaeinsatz im Krankenhaus als Anlaufstelle fungieren. Der Kurs behandelt unter anderem:
• Antiinfektiva: Grundlagen und Bandbreite
• Pharmakokinetik und Wechselwirkungen von Antiinfektiva
• Infektions- und Resistenzepidemiologie
• Strategien zur Sicherung rationaler Antibiotika-Anwendung im Krankenhaus
• Perioperative Antibiotikaprophylaxe und Infektionsmanagement
Die Fortbildung besteht aus 20 Unterrichtseinheiten (UE) im Selbststudium (E-Learning) sowie zwei Online-Seminaren. Das E-Learning muss vor den Präsenztagen abgeschlossen sein. Der Kurs wird in Zusammenarbeit mit dem Deutschen Beratungszentrum für Hygiene (BZH GmbH) in Freiburg durchgeführt. Die Befähigung zum ABS-beauftragten Arzt kann bereits im Rahmen der Weiterbildungszeit erworben werden.
Termine BÄK Nordwürttemberg:
Online-Phase, Archiv-Web-Seminar
Dienstag, 29. August 2023 –Sonntag, 19. November 2023
Onlineseminartag: Montag, 20. November 2023
9.00–18.45 Uhr
Onlineseminartag: Dienstag, 21. November 2023
8.00–17.00
Anmeldung: www.baek-nw.de/akademie Ansprechpartner: Fachbereich Fortbildung, Jahnstr. 5, 70597 Stuttgart, Telefon (07 11) 7 69 81-211, Fax (07 11) 7 69 81-500, E-Mail: fortbildung@baek-nw.de Veranstaltungsort: online
Termine Akademie für ärztliche Fortund Weiterbildung Südbaden: Online-Phase, Archiv-Web-Seminar:
Montag, 3. Juli –Mittwoch, 18. Oktober 2023
Onlineseminartag:
Donnerstag, 19. Oktober 2023
9.00–18.45 Uhr
Onlineseminartag:
Freitag, 20. Oktober 2023
8.00–17.00 Uhr
Anmeldung: www.baek-sb.de/akademie
Ansprechpartner:
Akademie für ärztliche Fort- und Weiterbildung Südbaden, Telefon (07 61) 6 00-47 37, Fax (07 61) 6 00-47 44, E-Mail: akademie@baek-sb.de
Veranstaltungsort:
Haus der Ärzte, Sundgauallee 27, 79114 Freiburg oder online
Zielgruppe:
Klinikärzte aller Fachrichtungen
Teilnehmerbeitrag: 700,– Euro Fortbildungspunkte: 60 Punkte Änderungen bleiben vorbehalten.
Update 23 –
Online-Veranstaltungsreihe
Im Rahmen unserer neuen Veranstaltungsreihe „Update 23“ erhalten Sie einen kurzen und informativen Einblick in brandaktuelle Themen.
Nach unserer Auftaktveranstaltung im Juni 2023 mit dem Titel „Medizin in heißen Zeiten: Hitzeschutz in Klinik und Praxis“
möchten wir Ihnen bereits jetzt die geplanten nächsten Termine mitteilen. Die Schwerpunktthemen werden zu gegebener Zeit veröffentlicht.
Diese Veranstaltung findet online statt und kann von zu Hause aus mitverfolgt werden.
Termine:
In Planung:
20. September 2023
13. Dezember 2023
jeweils Mittwoch, 19.00–20.30 Uhr
Zielgruppe:
Ärzte aller Fachrichtungen
Anmeldung: www.aerztekammer-bw.de/ akademie-baek-nw
Ansprechpartner:
Fachbereich Fortbildung, Jahnstr. 5, 70597 Stuttgart, Telefon (07 11) 7 69 81-211
Fax (07 11) 7 69 81-500, E-Mail: fortbildung@baek-nw.de
468 ÄBW 07 | 2023 Bekanntmachungen
Teilnehmerbeitrag: 20,– Euro Veranstaltungsort: online Fortbildungspunkte: 2 Punkte Änderungen bleiben vorbehalten.
8. ISTN –Interdisziplinärer Stuttgarter Tag der Notfallmedizin –online oder Präsenz
Jeder Patient ist interdisziplinär, sobald er verschiedene Symptome aufzeigt. Erst mit einer Diagnosestellung wird er einer Fachdisziplin zugeordnet. Der Weg vom Symptom zur Diagnose ist dabei elementar und nicht immer eindeutig. Wer begleitet die Patienten auf diesem Weg?
Das sind im ambulanten Bereich die Hausärzte. Im stationären Bereich nehmen diese Rolle die Notfallmediziner in einer interdisziplinären Notfallambulanz wahr. Seien sie gespannt auf praktische Fallbeispiele die die Interdisziplinarität zwischen den Fachrichtungen beleuchten und die Zusammenarbeit zwischen ambulanter und stationärer Medizin voranbringen. Zudem haben Sie die Möglichkeit, vorab eigene Fälle zu nennen, welche anschließend im Plenum behandelt werden.
Diese Veranstaltung wird live übertragen und kann von zu Hause aus online mitverfolgt werden.
Termin:
Samstag, 23. September 2023
9.00–13.00 Uhr
Zielgruppe:
Ärzte aller Fachrichtungen, Ärzte in Weiterbildung
Anmeldung: www.baek-nw.de/akademie
Ansprechpartner:
Fachbereich Fortbildung, Jahnstr. 5, 70597 Stuttgart, Telefon (07 11) 7 69 81-211, Fax (07 11) 7 69 81-500, E-Mail: fortbildung@baek-nw.de
Teilnehmerbeitrag: 40,– Euro
Veranstaltungsort:
Bezirksärztekammer
Nordwürttemberg, Jahnstraße 5, 70597 Stuttgart oder online
Fortbildungspunkte: 5 Punkte
Änderungen bleiben vorbehalten.
Notfallfachkraft in der Arztpraxis
Erwerben Sie besondere Fachund Handlungskompetenzen bei Notfällen und werden Sie zu einem unverzichtbaren Ansprechpartner für Ihren Arbeitgeber!
Mit der Fortbildung zur Notfallfachkraft qualifizieren Sie sich auf dem Gebiet der Notfallmedizin, des Notfallmanagements und der Gefahrenabwehr und werden somit zum Spezialisten und kompetenten Ansprechpartner in diesem bedeutenden Bereich einer Arzt- oder Notfallpraxis. In insgesamt 5 Modulen aktualisieren Sie Ihre Fähigkeiten bei der Ersten Hilfe, trainieren die Wiederbelebung und verschiedene Notfallsituationen, zudem lernen Sie die Grundsätze der Gefahrenabwehr und die Organisation von Abläufen bei der Notfallversorgung kennen. Mit Ihren Kompetenzen bieten Sie Ihrem Arbeitgeber zudem die Möglichkeit, einen Teil der Verpflichtungen, die sich aus den berufsgenossenschaftlichen Regelungen oder den Arbeitsschutzgesetzen ergeben, abzudecken.
Inhalte und Umfang:
Die Fortbildung zur Notfallfachkraft setzt sich aus den folgenden
5 Modulen zusammen:
Modul 1: Erste-Hilfe-Grundausbildung (16 UE)
Modul 2: Erste-Hilfe-Training
„Reanimation“ (9 UE)
Modul 3: Erste-Hilfe-Training
„Praxisfälle“ (8 UE)
Modul 4: Seminar „Brandschutz“ (4 UE)
Modul 5: Seminar „Notfallmanagement“ (8UE)
Abschluss: Nach Abschluss aller
5 Module innerhalb von 2 Jahren erhalten Sie das Zertifikat Notfallfachkraft in der Arztpraxis. Eine regelmäßige Teilnahme an der Fortbildung „Notfallfachkraft: Fresh-up“ wird empfohlen, um die erworbenen Kenntnisse und Fähigkeiten aktuell zu halten. Die Module der Notfallfachkraft können unabhängig voneinander bzw. einzeln belegt werden; Sie erhalten dann kein Zertifikat, jedoch eine Teilnahmebescheinigung zum jeweils besuchten Modul.
Veranstaltungstermine:
Modul 1:
Erste-Hilfe-Grundausbildung
Samstag/Sonntag,
23./24. September 2023
jeweils 9.00–16.30 Uhr
Fresh-Up
Samstag, 14. Oktober 2023
9.00–17.00 Uhr
Modul 3:
Erste-Hilfe-Training
„Praxisfälle“
Samstag, 21. Oktober 2023
12.00–19.15 Uhr
Modul 4:
Seminar „Brandschutz“
Samstag, 21. Oktober 2023
8.30–11.30 Uhr
Fortbildungskosten:
Modul 1 (Erste-Hilfe-Grundausbildung): 35,– Euro
Modul 2 (Erste-Hilfe-Training
„Reanimation“): 45,– Euro
Modul 3 (Erste-Hilfe-Training
„Praxisfälle“): 45,– Euro
Modul 4 (Seminar „Brandschutz“): 45,– Euro Modul 5 (Seminar „Notfallmanagement“): 65,– Euro Teilnahmevoraussetzung: Medizinische Fachangestellte (auch schon während der Ausbildung möglich)
Anerkennungen:
Eine Anerkennung bisheriger Kurse erfolgt im Rahmen einer Einzelfallprüfung. Zur Prüfung reichen Sie eine maximal 2 Jahre alte Bescheinigung per E-Mail ein (notfallmedizin@baek-nw.de). Generell ist zu beachten, dass maximal 2 Module anerkannt werden. Ein Erste-Hilfe-Kurs mit 16 UE kann auf das Modul 1 angerechnet werden, ein Sanitätskurs auf die Module 1 und 2 und die Fortbildung zur Fachwirtin auf die Module 1 und 5.
Kontakt:
Fachbereich Arbeitsschutz und Notfallmedizin, Jahnstraße 5, 70597 Stuttgart, Telefon (07 11) 7 69 81-212, Fax (07 11) 7 69 81-500, E-Mail: notfallmedizin@baek-nw.de
Anmeldung:
Melden Sie sich zu Ihrer Wunschfortbildung über folgenden Link an: www.baek-nw.de/akademie Änderungen bleiben vorbehalten.
Seminar zur Leitenden Notärztin/ zum Leitenden Notarzt
Reagieren Sie sicher und strukturiert bei Großschadensfällen.
Als Leitender Notarzt (LNA) übernehmen Sie zentrale Aufgaben beim Massenanfall Verletzter sowie bei außergewöhnlichen Notfällen und Gefahrenlagen. Sie leiten, koordinieren und über wachen alle medizinischen Maßnahmen am Schadensort.
Natürlich darf hier auch die Kommunikation mit anderen Organisationen nicht zu kurz kommen, da sie essentiell für Ihre Tätigkeit als Leitender Notarzt ist.
In unserem Seminar lernen Sie einerseits die theoretischen Aspekte der Kommunikation und Vorgehensweisen kennen. Durch verschiedene (Plan-)Übungen gewinnen Sie andererseits einen Einblick in die praktische Arbeit eines LNAs. Namhafte Referenten berichten zudem in ihren Vorträgen und Übungen über ihre eigenen Erfahrungen bei Großschadensfällen.
Die angebotene Fortbildung wird nach den Empfehlungen der Bundesärztekammer und der DIVI an der Landesfeuerwehrschule in Bruchsal durchgeführt. Für weitere Informationen zur Erlangung der Fachkunde Leitender Notarzt wenden Sie sich gerne an uns.
Termin: 25.–29. September 2023 (Mo–Fr)
Zielgruppe: Ärzte, die die Qualifikation zum Leitenden Notarzt erlangen möchten
Anmeldung: www.baek-nw.de/akademie Ansprechpartner: Fachbereiche Fortbildung & Arbeitsschutz und Notfallmedizin, Jahnstr. 5, 70597 Stuttgart, Telefon (07 11) 7 69 81-211, Fax (07 11) 7 69 81-500, E-Mail: fortbildung@baek-nw.de Veranstaltungsort: Landesfeuerwehrschule Baden-Württemberg, Im Wendelrot 10, 76646 Bruchsal Teilnahmegebühr: 820,– Euro Fortbildungspunkte: 40 Punkte Änderungen bleiben vorbehalten.
ÄBW 07 | 2023 469 Bekanntmachungen
32. Psychosomatischer Tag –online oder Präsenz
Sie können keine körperliche Ursache der Beschwerden
Ihres Patienten feststellen?
Sie vermuten, dass hinter den somatischen Beschwerden
ein psychisches Leiden steckt?
Für eine umfassende Behandlung
Ihrer Patienten ist eine kontinuierliche Auffrischung und Erweiterung Ihrer Kenntnisse im Fachgebiet der Psychosomatischen Medizin essentiell. Bereits während der Weiterbildung kristallisiert sich die Bedeutung fundierter psychosomatischer Kenntnisse heraus.
Um diese weiter zu vertiefen, laden wir Sie zum 32. Psychosomatischen Tag ein. Aufgrund der guten Vorerfahrungen der letzten Jahre bieten wir erneut eine Hybridveranstaltung an. Neben dem Curriculum Psychosomatische Grundversorgung bietet der Psychosomatische Tag
Ihnen seit 32 Jahren topaktuelle und spannende Themen mit hervorragenden Referenten, damit Sie Ihre Fachkenntnisse über das Wechselspiel zwischen Körper und Psyche erweitern können. Das Schwerpunktthema ist:
„Psychosoziale Medizin in Zeiten des Umbruches“, mit voraussichtlichen Themen:
• Dr. Google und die Auswirkung auf die ärztlich-therapeutische Beziehung
• Interkulturelle Psychosomatik
• Psychische Folgen des Klimawandels
Die Teilnahme am Psychosomatischen Tag kann auf die curriculare Fortbildung Psychosomatische Grundversorgung angerechnet werden.
Termin:
Samstag, 7. Oktober 2023
9.00–16.15 Uhr
Zielgruppe:
Ärzte aller Fachrichtungen
Anmeldung:
www.baek-nw.de/akademie
Ansprechpartner:
Fachbereich Fortbildung, Jahnstr. 5, 70597 Stuttgart, Telefon (07 11) 7 69 81-211, Fax (07 11) 7 69 81-500,
E-Mail: fortbildung@baek-nw.de
Teilnehmerbeitrag: 98,– Euro Veranstaltungsort: Bezirksärztekammer Nordwürttemberg, Jahnstraße 5, 70597 Stuttgart oder online Fortbildungspunkte: 8 Punkte Änderungen bleiben vorbehalten.
Baustein Psychotherapie (tiefenpsychologisch fundiert) –Kurs I
Erweitern Sie Ihre Kenntnisse für unbewusste, seelische Vorgänge und finden Sie dadurch effizienter Zugang zur inneren Situation des Patienten und zur Dynamik des psychotherapeutischen Dialogs.
Nach den Richtlinien der Landesärztekammer Baden-Württemberg sind theoretische und praktische Bausteine für die Weiterbildung zum Facharzt für Psychiatrie und Psychotherapie, Kinder- und Jugendpsychiatrie und -psychotherapie, Psychosomatische Medizin und Psychotherapie sowie zur Erlangung der Zusatzbezeichnung Psychotherapie erforderlich.
Hierfür wird 2023 der Kurs I (I bis III) angeboten.
Diese spannenden Themenbereiche erwarten Sie u. a.:
Entwicklungspsychologie
– Abwehrmechanismen
– Grundlagen der Verhaltenstherapie
– Grundzüge der Operationalisierten Psychodynamischen Diagnostik
Wirkfaktoren in der Psychotherapie
– Unbewusstes und Traumdeutung
– Übertragung/Gegenübertragung
Durchführung mit Fallsupervision, Technik sowie Theorieseminaren mit praktischem Charakter.
Termin:
8.–13. Oktober 2023
Sonntag bis Freitag, jeweils ganztags
Zielgruppe: Ärzte in Weiterbildung zum
Facharzt für Psychiatrie und Psychotherapie, Kinder- und Jugendpsychiatrie und Psychotherapie, Psychosomatische Medizin und Psychotherapie sowie in Zusatzweiterbildung Psychotherapie
Anmeldung: www.baek-nw.de/akademie Ansprechpartner: Fachbereich Fortbildung, Jahnstr. 5, 70597 Stuttgart, Telefon (07 11) 7 69 81-211, Fax (07 11) 7 69 81-500, E-Mail: fortbildung@baek-nw.de Teilnehmerbeitrag: 690,– Euro inkl. Seminarunterlagen, zzgl. Verpflegung und Übernachtung (falls gewünscht)
Veranstaltungsort: Tagungshaus Kloster Heiligkreuztal, Am Münster 7, 88499 Altheim Fortbildungspunkte: 55 Punkte Änderungen bleiben vorbehalten.
Fit für den Notfall –Der Kindernotfall
Wissen Sie, wie ein Kind im Notfall richtig behandelt werden muss?
Notfälle mit Kindern stellen immer besondere Herausforderungen dar:
• Wie beurteile ich die Vitalparameter des Kindes?
• Wie muss ich Sauerstoff verabreichen?
• Welche ist die richtige Dosierung der Notfallmedikamente?
• Welches sind die häufigsten Kindernotfälle?
All diese Fragen und mehr beantworten wir Ihnen gerne in unserem Seminar „Der Kindernotfall“. Nach einem theoretischen Teil steigen Sie direkt in die Praxis ein und können das Erlernte an Übungsphantomen in verschiedenen Altersklassen anwenden. Die Teilnehmerzahl ist begrenzt.
Termin: Mittwoch, 11. Oktober 2023 18.00–22.00 Uhr
Zielgruppe: Ärzte aller Fachrichtungen Anmeldung: www.aerztekammer-bw.de/ akademie-baek-nw
Ansprechpartner: Fachbereich Arbeitsschutz und Notfallmedizin, Jahnstr. 5, 70597 Stuttgart, Telefon (07 11) 7 69 81-212, Fax (07 11) 7 69 81-500, E-Mail: notfallmedizin@baek-nw.de Teilnehmerbeitrag: 65,– Euro Veranstaltungsort: Bezirksärztekammer Nordwürttemberg, Jahnstraße 5, 70597 Stuttgart Fortbildungspunkte: 7 Punkte Änderungen bleiben vorbehalten.
Curriculum –Psychosomatische Grundversorgung
Erweitern Sie Ihre Kenntnisse, Fertigkeiten und Einstellungen bei der Gestaltung der ArztPatienten-Beziehung, in der frühzeitigen und zutreffenden Diagnose psychischer und psychosomatischer Störungen und bei der Weitervermittlung der Patienten in eine fachspezifische Behandlung. Im Laufe dieses Kurses erlernen Sie grundlegende theoretische Konzepte der Psychosomatik, wichtige Aspekte der ärztlichen Gesprächsführung mit psychosomatischen Patienten und Sie erhalten eine Einführung in die Balintgruppenarbeit. Diese Kompetenzen ermöglichen Ihnen, psychische, funktionelle, psychosomatische und somatopsychische Erkrankungen besser zu erkennen, im Rahmen Ihres Fachgebietes durch verbale Inter ventionen zu behandeln und wichtige Weichenstellungen zum Wohle Ihrer Patienten vorzunehmen. Der 80-stündige Kurs richtet sich nach dem Curriculum „Psychosomatische Grundversorgung“ der Bundesärztekammer aus dem Jahr 2001 und erfüllt die inhaltlichen Anforderungen der KBV (nach den Ziffern 35100 und 35110 des EBM) und der aktuellen Weiterbildungsordnung der Landesärztekammer Baden-Württemberg.
Themenschwerpunkte:
• Definition und Perspektiven der Psychosomatik
• die Entstehung von psychosomatischen und psychischen Erkrankungen psychotherapeutische Verfahren und Institutionen
470 ÄBW 07 | 2023 Bekanntmachungen
–
–
• Patienten mit Persönlichkeitsstörungen, Angststörungen und Psychosomatosen Suchtbehandlung
• somatopsychische Störungen
• chronische Erkrankungen und Palliativmedizin
• Angst-, Ess- sowie Sexualstörungen
• Dissoziative Störungen,
• Suizidalität
Terminauswahl:
jeweils Samstag, 9.00–16.15 Uhr
14. Oktober 2023
25. November 2023
9. Dezember 2023
Termine sind einzeln buchbar. Der Einstieg ist auch unterjährig möglich, etwaig nicht besuchte Termine können im Folgejahr absolviert werden.
Zielgruppe:
Ärzte aller Fachrichtungen
Anmeldung:
www.baek-nw.de/akademie
Ansprechpartner:
Fachbereich Fortbildung, Jahnstr. 5, 70597 Stuttgart, Telefon (07 11) 7 69 81-211, Fax (07 11) 7 69 81-500,
E-Mail: fortbildung@baek-nw.de
Teilnehmerbeitrag: 98,– Euro
Veranstaltungsort:
Bezirksärztekammer
Nordwürttemberg, Jahnstraße 5, 70597 Stuttgart
Fortbildungspunkte:
8 Punkte je Termin
Änderungen bleiben vorbehalten.
Akutfälle aller Fachgebiete
Sie sind seit vielen Jahren ärztlich tätig, in der eigenen Praxis oder als Vertreter, im Notfalldienst oder auch in der Klinik?
Sie möchten sich auf dem Laufenden halten und interessieren sich für Neuerungen in der Medizin auch fachgebietsübergreifend? Sie sind vielleicht schon im Ruhestand?
Dann ist die Fortbildung Akutfälle aller Fachgebiete ideal, um Ihr Know-how zu erweitern und auf den neuesten Stand zu bringen, denn: Sobald Sie im Notfalldienst tätig sind, werden Sie mit Patientenbeschwerden aus nahezu allen Bereichen der Medizin konfrontiert. Entsprechend erhalten Sie einen kompakten Über-
blick vom Auge bis zum Zeh, von der Haut bis zum Darm. Wir vermitteln Ihnen die wichtigsten Informationen zu Krankheits-/ Notfallbildern folgender Bereiche:
• Kardiologie
• Pädiatrie
• Neurologie (u. a. Schlaganfall, Schwindel, Migräne)
• HNO (u. a. Nasenbluten, Entzündungen)
• Abdomen
• Chirurgische Notfälle
• Gynäkologie (u. a. Blutungen) Anhand von detaillierten Fallbeispielen und Vorträgen werden Ihnen die aktuellen Diagnostikund Therapieempfehlungen zu relevanten Krankheitsbildern nahegebracht. In praktischen Übungen können Sie Ihre Fähigkeiten und Ihr Wissen auffrischen. Selbstverständlich wird auf lebensbedrohliche Situationen bis hin zur Reanimationspflicht eingegangen. Sie haben schon länger keinen Blasenkatheter mehr gelegt oder eine Reanimation mit Hilfsmitteln durchgeführt? Beides können Sie hier am Phantom üben. Darüber hinaus werden wichtige organisatorische Fragen des Notfalldienstes in BadenWürttemberg geklärt.
Kombination aus Online- und Präsenzseminaren
1. Tag / 2. Tag: Online-Seminare von zu Hause oder Ihrer Praxis
3. Tag: praktische Unterweisungen in Kleingruppen sowie weitere Fachvorträge in der Bezirksärztekammer Nordwürttemberg
Termin:
20.–22. Oktober 2023
Freitagnachmittag bis Sonntagmittag
Zielgruppe: Ärzte aller Fachrichtungen, Ärzte in Weiterbildung
Anmeldung:
www.baek-nw.de/akademie
Ansprechpartner:
Fachbereich Fortbildung, Jahnstr. 5, 70597 Stuttgart, Telefon (07 11) 7 69 81-211, Fax (07 11) 7 69 81-500,
E-Mail: fortbildung@baek-nw.de
Teilnehmerbeitrag: 250,– Euro
Veranstaltungsort: online und Bezirksärztekammer Nordwürttemberg, Jahnstraße 5, 70597 Stuttgart
Fortbildungspunkte: 28 Punkte Änderungen bleiben vorbehalten. Onlinefortbildung – Beratung zur Patientenverfügung und gesundheitliche Vorausplanung –eine Aufgabe für Hausärzte
Die Patientenverfügung und Vorsorgevollmacht ist eine wichtige Möglichkeit für Ihre Patienten, ihr Recht auf Selbstbestimmung wahrzunehmen und eigenständig zu entscheiden, welche medizinischen und lebenserhaltenden Maßnahmen ergriffen werden sollen, wenn sie im Ernstfall dazu nicht mehr in der Lage sind. Die ärztliche Beratung zur Patientenverfügung ist ein anspruchsvolles und sensibles Thema, bei dem Sie als Arzt ethische, rechtliche und medizinische Gesichtspunkte berücksichtigen müssen. Im Rahmen dieses Seminars werden nachfolgende Fragestellungen zur Patientenverfügung und Vorsorgevollmacht geklärt und diskutiert, um Ihnen praktische Hilfestellungen für Ihren Praxisalltag an die Hand zu geben:
• Wie können Sie Patienten bestmöglich zum Thema Patientenverfügung und Vorsorgevollmacht beraten?
• Welche Bedeutung und welche Konsequenzen haben Vorsorgevollmachten und Patientenverfügungen in Ihrer praktischen ärztlichen Tätigkeit?
• Wie sind die gesetzlichen Regelungen zur Patientenverfügung?
Innerhalb der Veranstaltung wird der Inhalt der relevanten Gesetze besprochen und ein evaluiertes und seit Jahren erprobtes regionales Beratungsangebot der Esslinger Initiative e. V. vorgestellt. Die konkreten Inhalte des Programmes werden noch bekanntgegeben.
Termin: Freitag, 27. Oktober 2023 13.30–17.00 Uhr
Zielgruppe: Ärzte aller Fachrichtungen
Anmeldung:
www.baek-nw.de/akademie
Ansprechpartner:
Fachbereich Fortbildung, Jahnstr. 5, 70597 Stuttgart, Telefon (07 11) 7 69 81-211, Fax (07 11) 7 69 81-500, E-Mail: fortbildung@baek-nw.de
Teilnehmerbeitrag: 60,– Euro Veranstaltungsort: Online-Seminarraum Fortbildungspunkte: 4 Punkte Änderungen bleiben vorbehalten.
Gelbfieberimpfung –Fortbildung für Ärzte –online oder Präsenz
Die Reisemedizin soll Reisenden allgemein, sowie chronisch Kranken, eine umfassende Vorbereitung für ihre Reise liefern. Sie beinhaltet dabei weit mehr als nur eine Beratung und die anschließende Durchführung von Schutzimpfungen gegen z. B. Hepatitis, invasive Meningokokken-Erkrankungen und Typhus.
Neben Informationen zur Durchführung von Gelbfieberimpfungen, zur Zulassung als Gelbfieberimpfstelle und dem epidemiologischen Kontext der Endemiegebiete, stehen die aktuelle Weltseuchenlage, Reiseimpfungen sowie neue Impfstoffe und Impfrisiken im Mittelpunkt der Veranstaltung.
Das Seminar wendet sich vorzugsweise an Ärzte, die in BadenWürttemberg bereits als Gelbfieberimpfstelle registriert sind. Darüber hinaus können alle, die sich in ihrer täglichen Praxis mit reisemedizinischen Fragestellungen befassen ebenso teilnehmen, wie an diesen Themen interessierte Ärzte aller Fachrichtungen. Diese Veranstaltung wird live übertragen und kann von zu Hause aus online mitverfolgt werden.
Diese Fortbildung wird vom Regierungspräsidium Stuttgart für die Fortgeltung erteilter Ermächtigungen zur Gelbfieberimpfung anerkannt.
Termin:
Samstag, 28. Oktober 2023 9.00–16.30 Uhr
ÄBW 07 | 2023 471 Bekanntmachungen
Zielgruppe:
Ärzte aller Fachrichtungen
Anmeldung:
www.baek-nw.de/akademie
Ansprechpartner:
achbereich Fortbildung, Jahnstr. 5, 70597 Stuttgart, Telefon (07 11) 7 69 81-211, Fax (07 11) 7 69 81-500, E-Mail: fortbildung@baek-nw.de
Teilnehmerbeitrag: 50,– Euro
Veranstaltungsort: Bezirksärztekammer
Nordwürttemberg, Jahnstraße 5, 70597 Stuttgart oder online
Fortbildungspunkte: 9 Punkte Änderungen bleiben vorbehalten.
Orthopädie und Unfallchirurgie kompakt – für Fachärzte, Facharztanwärter und Interessierte
Sie befinden sich in der Weiterbildung und möchten einen kompakten Überblick über wichtige Themen erhalten? Sie sind bereits fachärztlich tätig und möchten die relevanten Neuerungen erfahren?
Das Seminar richtet sich sowohl an Assistenzärzte, die sich in der Vorbereitung zur Facharztprüfung Orthopädie/Unfallchirurgie befinden als auch an Fachärzte, die die Veranstaltung zum Auffrischen und zur Wiederholung ihres Wissens über relevante klinische Themen aus der Orthopädie und Unfallchirurgie nutzen möchten. Namhafte Referenten präsentieren relevante Themenbereiche mittels interaktiver Vorträge. Die Aufteilung in Kleingruppen am Nachmittag rundet das Angebot ab. Hierbei wird sich eine Gruppe speziell mit der Prüfungsvorbereitung beschäftigen, in den weiteren Gruppen werden Fallbeispiele und Kasuistiken aus dem Klinik- und Praxisalltag besprochen und diskutiert.
Termin:
Samstag 11. November 2023
9.00–16.15 Uhr
Zielgruppe: Facharztanwärter/-innen in der Orthopädie/Unfallchirurgie, Fachärzte, Interessierte Ärzte Anmeldung: www.baek-nw.de/akademie
Ansprechpartner: Fachbereich Fortbildung, Jahnstr. 5, 70597 Stuttgart, Telefon (07 11) 7 69 81-211, Fax (07 11) 7 69 81-500, E-Mail: fortbildung@baek-nw.de Teilnehmerbeitrag: 120,– Euro (regulär), 90,– Euro (für Ärzte in Weiterbildung)

Veranstaltungsort: Bezirksärztekammer Nordwürttemberg, Jahnstraße 5, 70597 Stuttgart Fortbildungspunkte: 9 Punkte Änderungen bleiben vorbehalten.
Termin: Samstag, 18. November 2023
9.00–14.45 Uhr
In Zusammenarbeit mit dem Zentrum für Infektiologie –dem Netzwerk infektiologisch tätiger Ärzte aus Klinik, Praxis und Labor – bietet die Bezirksärztekammer Nordwürttemberg den Stuttgarter Tag für Infektiologie an.
Hier erfahren Sie Neuigkeiten zu aktuellen Herausforderungen und vertiefen Ihre Kenntnisse in Prävention, Diagnostik und Therapie von Infektionen. Die Veranstaltung zielt darauf ab, Ihre Kompetenz für Fragestellungen im vielfältigen Bereich der Infektiologie zu stärken.
Die Veranstaltung widmet sich jährlich einem aktuellen Schwerpunktthema, welches auf der Homepage, im Ärzteblatt BadenWürttemberg und über den Mailingservice im Vorfeld bekannt gegeben wird.
Wir laden Sie herzlich zu diesem spannenden Tag mit viel Raum für Diskussion ein und begrüßen Sie auch im Namen unseres Kooperationspartners Zentrum für Infektiologie Stuttgart (ZIS)! Diese Veranstaltung wird live übertragen und kann von zu Hause aus online mitverfolgt werden.
Die Teilnahme an dieser Veranstaltung in Kombination mit der Teilnahme am „15. Nordwürttemberger Impftag“ am 8. Juli 2023 ist vom Regierungspräsidium Stuttgart für die Fortgeltung erteilter Ermächtigungen zur Gelbfieberimpfung anerkannt.
Zielgruppe: Ärzte aller Fachrichtungen Anmeldung: www.baek-nw.de/akademie Ansprechpartner: Fachbereich Fortbildung, Jahnstr. 5, 70597 Stuttgart, Telefon (07 11) 7 69 81-211, Fax (07 11) 7 69 81-500, E-Mail: fortbildung@baek-nw.de Teilnehmerbeitrag: 20,– Euro Veranstaltungsort: Bezirksärztekammer Nordwürttemberg, Jahnstraße 5, 70597 Stuttgart und online Fortbildungspunkte: 6 Punkte Änderungen bleiben vorbehalten.
Bezirksberufsgericht für Ärzte in Stuttgart
Durch Verfügung des Ministeriums für Soziales, Gesundheit und Integration Baden-Württemberg vom 13.06.2023 – Az. 31-5415.4002/0001 – wurde im Einvernehmen mit dem Justizministerium Baden-Württemberg gemäß § 21 Abs. 4 i.V.m. § 8 Abs. 2 des Heilberufe-Kammergesetzes i. d. F. vom 16. März 1995 (GBl. S. 314), zuletzt geändert durch Artikel 11 der 10. Anpassungsverordnung vom 21. Dezember 2021 (GBl. 2022, S. 1, 2) mit Wirkung vom 15. Juni 2023 für die Dauer von 5 Jahren
Herr Dr. med. Askan Hendrischke Aalen
zum 1. ärztlichen Beisitzer des Bezirksberufsgerichts für Ärzte in Stuttgart bestellt.
Kassenärztliche Vereinigung
Baden-Württemberg
Die zur Nachbesetzung ausgeschriebenen Vertragsarztsitze für alle Fachgruppen und für alle Planungsbereiche in BadenWürttemberg mit Zulassungsbeschränkungen finden Sie auf der Website der Kassenärztlichen Vereinigung Baden-Württemberg www.kvbawue.de / praxissitze
Nach der seit 1. Januar 2013 geltenden Rechtslage muss der Antrag zur Nachbesetzung eines Vertragsarztsitzes beim Zulassungsausschuss gestellt werden. Dieser entscheidet, ob der Vertragsarztsitz in einem Planungsbereich, für den Zulassungsbeschränkungen angeordnet sind, weitergeführt werden soll. Sofern dies der Fall ist, hat die Kassenärztliche Vereinigung den Vertragsarztsitz unverzüglich auszuschreiben.
472 ÄBW 07 | 2023 Bekanntmachungen
12. Stuttgarter Tag für Infektiologie – online oder Präsenz
Bezirksärztekammer
Nordbaden
Fortbildungen der Bezirksärztekammer Nordbaden

Zu unseren Fortbildungen können Sie sich über den nachfolgenden
Link anmelden:
http://www.baek-nb.de/akademie
Bitte melden Sie sich zu unseren Fortbildungsveranstaltungen über das Seminarverwaltungsprogramm (SVmed) der Landesärztekammer an:
https://kurse.aerztekammer-bw.de
chosomatik. Gleichzeitig sollen psychosomatische Kompetenzen dabei helfen, die Patient-ArztBeziehung positiv zu gestalten. Deshalb bietet die Bezirksärztekammer Nordbaden den 80-Stunden-Kurs „Psychosomatische Grundversorgung“ nach dem Curriculum der Bundesärztekammer an. Dabei sollen die Kenntnisse und Kompetenzen mit jeweils ausgewogenen Anteilen von Theorie, Fallbeispielen, Übungen sowie patientenzentrierter Selbsterfahrung in im Kurs integrierten Balint-Gruppen vermittelt werden. Aufgeteilt sind die 80 Unterrichtseinheiten auf Zweitageskurse zu je 16 Unterrichtseinheiten, die über ein halbes Jahr verteilt werden. Dabei ist die Absolvierung von fünf Wochenenden erforderlich, um die Qualifikation zu erwerben. Die Kursweiterbildung „Psychosomatische Grundversorgung“ ist in einigen Fachgebieten nach der Weiterbildungsordnung vorgeschrieben und erfüllt die inhaltlichen Anforderungen der KV zur Abrechnung der EBM-Ziffern 35100 und 35110.
Kursinhalte werden u. a. sein:
• Psychopathologie, PsychoSoziales Krankheitsmodell
• Somatoforme Störungen und Schmerz
• Depressionen, Angststörungen
Die Termine für 2024 geben wir in Kürze frei.
Die Wochenenden können unabhängig voneinander gebucht werden.
Ersatztermine (online): Gerne möchten wir die Möglichkeit geben, einen evtl. versäumten Kurstag nachzuholen. Die drei Ersatztermine können deswegen auch unabhängig voneinander gebucht werden: Theorie und Gesprächsführung plus einmal Balintgruppe ersetzen einen Freitag, plus zweimal Balintgruppe einen Samstag.
Die Balintgruppe ist Teilnehmenden des 80-Stunden-Kurses
„Psychosomatische Grundversorgung“ in Karlsruhe vorbehalten, um kontinuierliche Balintgruppenarbeit zu gewährleisten.
Mittwoch, 19. Juli 2023
18.30–20.00 Uhr
2 UE Balintgruppe
Gebühr: 40,– Euro
Mittwoch, 26. Juli 2023
15.30–17.00 Uhr
2 UE Balintgruppe
Gebühr: 40,– Euro
Freitag, 28. Juli 2023
14.00–ca. 18.30 Uhr
2 UE Theorie (Thema: Burnout)
3 UE Gesprächsführung
der seit 2018 geltenden Neufassung des Mutterschutzgesetzes (MuSchG) in Kraft getreten sind, und Sie sollten wissen, an wen Sie sich wenden können, wenn Sie (oder Ihre Partnerin) schwanger werden.
Wir möchten Sie deswegen bei unserem Live-Web-Seminar ausführlich informieren.
Thematisiert werden u. a. die nach dem MuSchG erforderliche Gefährdungsbeurteilung jedes Arbeitsplatzes in stationärem und ambulantem Bereich, wann und in welcher Form ein Beschäftigungsverbot ausgesprochen werden kann oder muss, wie Sie Ihre Weiterbildung auch in Teilzeit fortführen können – und wie der Alltag in Klinik und Praxis mit Kind(ern) aussehen kann.
Es erwarten Sie Vorträge von Vertretern der relevanten Bereiche. Am Ende der Veranstaltung ist ausreichend Zeit für Ihre Fragen eingeplant.
Termin:
Montag, 24. Juli 2023
18.00–ca. 21.45 Uhr
Veranstaltungsort: online
ReferentInnen: Corinna Ernle, Niedergelassene Fachärztin für Allgemeinmedizin, Erolzheim
Bei Rückfragen stehen wir Ihnen gerne zur Verfügung.
Bezirksärztekammer Nordbaden, Akademie für Ärztliche Fortbildung, Zimmerstr. 4, 76137 Karlsruhe, Telefon (07 21) 1 60 24-131/-132, Fax (07 21) 1 60 24-333, E-Mail: fortbildungsakademie@baek-nb.de
Psychosomatische Grundversorgung
Wochenendkurse (80-Std.-Kurs nach dem Curriculum der Bundesärztekammer)
Die enge Verflechtung von Körper und Psyche macht sich in vielen medizinischen Fachgebieten bemerkbar. Um die Zusammenhänge zu verstehen und entsprechende Krankheitsbilder sowohl richtig zu diagnostizieren als auch zu therapieren, bedarf es erweiterter Kenntnisse und Fähigkeiten im Bereich der Psy-
• Suchterkrankungen
• Ess- und Schlafstörungen
• Schmerz des Bewegungsapparates
• Psychoonkologie
• Krisenintervention
• Ärztliche Gesprächsführung
Letzter Termin 2023:
Freitag, 14. Juli 2023
14.00–ca. 20.30 Uhr
Samstag, 15. Juli 2023
9.00–ca. 17.45 Uhr
Wissenschaftliche Leitung: Prof. Dr. med. Michael Berner, Direktor der Klinik für Psychiatrie und Psychotherapeutische Medizin, Städtisches Klinikum
Karlsruhe
Dr. med. Elisabeth Daikeler, Fachärztin für Psychotherapeutische Medizin, Psychiatrie und Psychotherapie

Gebühr: 70,– Euro Veranstaltungsort: Bezirksärztekammer Nordbaden, Zimmerstr. 4, 76137 Karlsruhe Zielgruppe:
Ärztinnen und Ärzte aller Fachrichtungen und in Weiterbildung Gebühr: 250,– Euro pro Wochenende, inkl. Verpflegung Fortbildungspunkte: 16 Punkte pro Wochenende
Anmeldung: www.baek-nb.de/akademie
Schwangerschaft und Mutterschutz für Ärztinnen: Tipps, Tricks und was es zu beachten gilt Web-Seminar
Sie sind Ärztin in Weiterbildung oder junge Fachärztin und schwanger? Oder planen eine Schwangerschaft für die nächste Zukunft? Oder Sie sind junger Vater in spe? Dann sollten Sie sich mit den gesetzlichen Regelungen frühzeitig beschäftigen, die mit
Dr. med. Sabine Ewerbeck, Fachärztin für Allgemeinmedizin, Betriebsmedizin, Stv. Leitung des Betriebsärztlichen Dienstes des Universitätsklinikums Heidelberg
Dr. med. Caroline Fortmann, Fachärztin für Kinderchirurgie, Medizinische Hochschule
Hannover
Kai-Uwe Gläss, Leitung Referat
54.3 – Fachgruppe Mutterschutz Regierungspräsidium Stuttgart
Carsten Mohrhardt, Facharzt für Orthopädie und Unfallchirurgie, Vorsitzender des Weiterbildungsausschusses der Bezirksärztekammer Nordbaden
Rechtsanwältin (Syndikusrechtsanwältin) Christine Nic, Landesverband Baden-Württemberg des Marburger Bunds
ÄBW 07 | 2023 473 Bekanntmachungen
Karlsruhe
(07 21) 1 60 24-0
(07 21) 1 60 24-2 22
Geschäftsstelle: Zimmerstraße 4 76137
Telefon
Fax
Wissenschaftliche Leitung und Moderation:
Maylis Jungwirth, Fachärztin für Kinder- und Jugendmedizin, Zentrum für Kinder- und Jugendmedizin, Neonatologie, Universitätsklinikum Heidelberg
Zielgruppe: Ärztinnen und Ärzte aller Fachrichtungen, insbesondere in Weiterbildung
Gebühr: 20,– Euro
Fortbildungspunkte: 4 Punkte
Anmeldung: www.baek-nb.de/akademie
Medizinische Notfälle an Bord von Flugzeugen Teil 2: Case Reports
Web-Seminar
In Teil 2 der Fortbildungsreihe „Notfälle an Bord von Flugzeugen“ werden die theoretischen Grundlagen aus dem ersten Teil des Seminars auf Fallbeispiele angewandt. Hierbei können Sie reale Notfälle diskutieren und Strategien für Vorgehensweisen, Entscheidungsfindung und Therapie im Ernstfall entwickeln.
Termin:
Dienstag, 19. September 2023
18.00–ca. 20.15 Uhr
Referenten: PD Dr. med.
Christopher Neuhaus, stellv. Direktor der Klinik für Anästhesiologie, Universitätsklinikum
Heidelberg, Mitglied im Vorstand der Deutschen Gesellschaft für Luft- und Raumfahrtmedizin e. V. Julius Springer, Senior First Officer A380, CRM-Trainer, Deutsche Lufthansa AG
Wissenschaftliche Leitung: PD
Dr. med. Christopher Neuhaus
Veranstaltungsort: online
Zielgruppe: Ärztinnen und Ärzte aller Fachrichtungen, die bereits
Teil 1 absolviert haben
Gebühr: 30,– Euro
Fortbildungspunkte: 3 Punkte
Anmeldung:
www.baek-nb.de/akademie
Klinische SonographieFortbildungsreihe
Die Ultraschalluntersuchung ist eine relativ preiswerte, nebenwirkungsarme und aussagefähige diagnostische Methode. Sie ist aber in besonderem Maße von der Kompetenz des Sonogra-
pheurs abhängig. In unserer Reihe können Sie Ihre sonographischen Grundkenntnisse vertiefen. Nach einer kurzen Einführung werden klinische Kasuistiken vorgestellt mit Demonstration sonographischer Befunde im klinischen Kontext (Anamnese, Labor, radiologische Schnittbildgebung etc.).
Indikationszeitpunkte, diagnostische Aussagekraft, technische Möglichkeiten, Grenzen und Akzeptanz der Ultraschalldiagnostik sollen kritisch gewürdigt werden. Im Anschluss können Sie eigene sonographische Problemfälle diskutieren, Ihre praktischen Kenntnisse erweitern und in gegenseitiger Untersuchung mit Ultraschallgeräten unter Anleitung üben.
Diese Fortbildungsreihe ist eine Kooperationsveranstaltung der Bezirksärztekammer Nordbaden mit den ViDia Christlichen Kliniken Karlsruhe.
Termine:
jeweils Mittwoch, 16.00–ca. 20.00 Uhr
20. September 2023
Sonographische Beiträge bei der Diagnostik von Tumoren und Metastasen im klinischen Kontext (Cervikal, thorakal, abdominell, Weichteile)
8. November 2023
Sonographische Beiträge bei der Diagnostik von Lymphomen im klinischen Kontext
Referenten: Dr. med. Karl-Heinz Seitz, Oberarzt der Medizinischen Klinik I, Städtisches Klinikum Karlsruhe
Dr. med. Andreas Weimer, Facharzt für Innere Medizin, FK Sonographie der abdominellen und retroperitonealen Gefäße in der Inneren Medizin, Sonographie der extrakraniellen hirnversorgenden Gefäße in der Inneren Medizin
Wissenschaftliche Leitung: Dr. med. Karl-Heinz Seitz
Veranstaltungsort:
ViDia Christliche Kliniken Karlsruhe, Standort Diakonissenkrankenhaus Rüppurr, Diakonissenstraße 28, 76199 Karlsruhe (Veranstaltungssaal)
Zielgruppe: Ärztinnen und Ärzte – in klinischer Ausbildung, zur Vertiefung bestimmter Themen – in Niederlassung, zur Auffrischung ihrer Kenntnisse
Gebühr: je Termin 70,– Euro für Ärztinnen und Ärzte in Weiterbildung/80,– Euro für Fachärztinnen und Fachärzte inkl. Verpflegung
Fortbildungspunkte: je Termin 8 Punkte, mit Lernerfolgskontrolle
Anmeldung: www.baek-nb.de/akademie
Häusliche Gewalt –vom Verdacht zur Hilfe Hybrid-Veranstaltung
Gewalterfahrungen spielen sich in den allermeisten Fällen in den eigenen vier Wänden ab. Zu 80 Prozent sind davon Frauen betroffen.
Aber was ist zu tun, wenn Sie den Verdacht haben, eine Patientin (oder ein Patient) sei Opfer häuslicher Gewalt? Welche Anlaufstellen und Hilfsangebote gibt es, um Wege aus der Gewaltspirale zu finden?
Mit unserer Fortbildung wollen wir Sie dabei unterstützen, adäquate Antworten auf diese und weitere Fragen rund um das Thema häusliche Gewalt zu finden. Die Fortbildung wird im HybridFormat angeboten.
Programm:
Begrüßung und Einführung
Dr./Univ. Pisa Susanna ColopiGlage
„Eine Übersicht zur häuslichen Gewalt in Deutschland“
Bianca Biwer
„Symptome häuslicher Gewalt erkennen“
Bianca Biwer
Vorstellung der Beratungsstelle bei „Gewalt im Sozialen Nahraum“
Selina Sommer, B. A.
Rechtsmedizinische Aspekte häuslicher Gewalt
Prof. Dr. med. univ. Kathrin Yen
Hilfsangebote/Opfer-Beratungsstellen in Nordbaden
Verena Meister
Termin:
Samstag, 23. September 2023
9.15–ca. 13.30 Uhr
Referenten: Bianca Biwer, Bundesgeschäftsführerin
Weißer Ring, Mainz
Dr./Univ. Pisa Susanna ColopiGlage, Niedergelassene Fachärztin für Allgemeinmedizin, Vizepräsidentin der Bezirksärztekammer Nordbaden, Vorsitzende der Ärzteschaft Karlsruhe
Verena Meister, Gleichstellungsbeauftragte der Stadt Karlsruhe Selina Sommer, Bachelor of Arts
Soziale Arbeit, Anti-GewaltTraining für Frauen, Verein für Jugendhilfe Karlsruhe e. V.
Prof. Dr. med. univ. Kathrin Yen, Ärztliche Direktorin des Instituts für Rechts- und Verkehrsmedizin, Universitätsklinikum Heidelberg
Wissenschaftliche Leitung
und Moderation: Dr./Univ. Pisa Susanna Colopi-Glage
Veranstaltungsort:
Bezirksärztekammer Nordbaden, Zimmerstr. 4, 76137 Karlsruhe oder online
Zielgruppe: Ärztinnen und Ärzte aller Fachrichtungen
Gebühr: 35,– Euro inkl. Verpflegung
Fortbildungspunkte: 5 Punkte beantragt
Anmeldung: www.baek-nb.de/akademie
Train the Trainer – KWBW Modul für WBB für Allgemeinmedizin Web-Seminar
Dieses Seminar ist ein Angebot an alle Fachärztinnen und Fachärzte, die als Weiterbilder Ärztinnen und Ärzte in Weiterbildung zum Facharzt für Allgemeinmedizin anleiten (also Hausärztinnen und Hausärzte und die Kolleginnen und Kollegen, die ÄiW für Allgemeinmedizin im Rahmen einer Rotation weiterbilden). Dieses Seminar soll Ihnen Hinweise geben zu den Besonderheiten der ambulanten Weiterbildung mit der neuen kompetenzbasierten Weiterbildungsordnung. Es wird ein Strukturmodell für die WB der ÄIW vorgestellt und die Übertragung auf die eigene Praxis erarbeitet. Zudem werden das Kompetenzzentrum Weiterbildung Baden-Württem-
474 ÄBW 07 | 2023 Bekanntmachungen
berg (KWBW), die Weiterbildung im Verbund sowie die KWBW Verbundweiterbildung plus (www.kwbw.de) vorgestellt.
Das KWBW-Modul versteht sich als Zusatzmodul zu einem Train
The Trainer-Seminar in einem der Bezirke (in Karlsruhe am 14. 10. 2023). Wenn Sie beide Veranstaltungen besuchen, können Sie als Weiterbilder die P1-Pauschale abrechnen.
Kursinhalte:
• Einführung in das Thema WB Allgemeinmedizin, Erfahrungsaustausch als WBB
• Besonderheiten in der ambulanten WB Allgemeinmedizin
• Gemeinsam Weiterbilden in der KWBW Verbundweiterbildung plus
• Weiterbilden im KWBW – Förderung, Anträge, P1-Pauschale, Online-Netzwerke
• Struktur der Weiterbildung in der täglichen Praxis
Termin:
Freitag, 13. Oktober 2023
16.00–20.00 Uhr
Referenten: Dr. med. Martina
Bischoff, Lehrkoordinatorin Allgemeinmedizin Freiburg, Koordinatorin KWBW Freiburg
Dr. med. Simon Schwill, Leitung
KWBW
Wissenschaftliche Leitung:
Dr. med. Simon Schwill, MME, Universitätsklinikum Heidelberg
Veranstaltungsort: online
Zielgruppe: Hausärztinnen und Hausärzte und die Kolleginnen und Kollegen, die ÄiW für Allgemeinmedizin im Rahmen einer Rotation weiterbilden
Gebühr: 60,– Euro
Fortbildungspunkte: 5 Punkte
Anmeldung: www.baek-nb.de/akademie
Train the Trainer Kurs –für Weiterbilder
Angesichts der neuen Weiterbildungsordnung einerseits und einer zu geringen Anzahl an Ärztinnen und Ärzten in Weiterbildung andererseits wird es zunehmend wichtig, die Weiterbildung
im ambulanten und stationären Sektor strukturiert und effizient zu gestalten und nach modernen Qualitätskriterien zu optimieren. Unser Kurs unterstützt Sie als Weiterbilder bei der täglichen Arbeit mit den ÄiW. Vermittelt werden wichtige Neuerungen der WBO samt eLogbuch sowie grundlegende Rahmenbedingungen organisatorischer und rechtlicher Natur. Workshops zu Curriculumserstellung und Feedbackgesprächen sollen zusätzlich wichtige Hilfestellung leisten. Angesprochen sind alle Fachärztinnen und Fachärzte, die als Weiterbilder Ärztinnen und Ärzte in Weiterbildung beschäftigen oder dies künftig tun wollen. Falls Sie ÄiW zum Facharzt für Allgemeinmedizin anleiten, auch im Rahmen einer Rotation, und Interesse an der Teilnahme an der KWBW-Verbundweiterbildung plus haben, können Sie am 13. Oktober ein ergänzendes KWBW-Modul online besuchen. Es legt den Schwerpunkt auf die Vernetzung und den Austausch der Teilnehmerinnen und Teilnehmer. Bitte sprechen Sie uns bei Interesse an.
Die beiden Termine sind unabhängig voneinander buchbar; da sie sich aber inhaltlich ergänzen, empfehlen wir den Besuch beider Module.
Termin:
Samstag, 14. Oktober 2023
9.00–ca. 17.30 Uhr
Wissenschaftliche Leitung
und Moderation: Dr./Univ. Pisa Susanna Colopi-Glage, niedergelassene Fachärztin für Allgemeinmedizin, Vizepräsidentin der Bezirksärztekammer
Nordbaden
Referenten: Dr. med. Folkert Fehr, Niedergelassener Facharzt für Kinder- und Jugendmedizin, Sinsheim, Arbeitsausschuss des Weiterbildungsausschusses der Bezirksärztekammer Nordbaden
Dr. med. Nicole Geiger, Oberärztin Klinik für Allgemein-, Viszeral-, Gefäß- und Shuntchirurgie, GRNKlinik Schwetzingen, Vorstandsmitglied der Akademie für ärztliche Fortbildung der Bezirksärztekammer Nordbaden
Ass. jur. Andreas Maier LL. M., Niederlassungs- und Kooperati-
onsberatung, Kassenärztliche Vereinigung Baden-Württemberg
Prof. Dr. med. Thomas Rabenstein, Chefarzt Team Gastroenterologie, Klinik für Innere Medizin, Diakonissen-Stiftungs-Krankenhaus Speyer Dipl.-Verwaltungswirt (FH) Otto Schmidt, Leiter des Sachgebietes ärztliche Weiterbildung der Bezirksärztekammer Nordbaden
Dr. med. Axel Schöttler, Oberarzt Klinik für Allgemein- und Visceralchirurgie, Städtisches Klinikum Karlsruhe, FA für Chirurgie, Visceralchirurgie und spezielle Visceralchirurgie
N. N.
Veranstaltungsort: Bezirksärztekammer Nordbaden, Zimmerstr. 4, 76137 Karlsruhe Zielgruppe: Fachärztinnen und Fachärzte, die als Weiterbilder Ärztinnen und Ärzte in Weiterbildung beschäftigen oder dies künftig tun wollen.
Gebühr: 110,– Euro, inkl. Verpflegung Fortbildungspunkte: 11 Punkte Anmeldung: www.baek-nb.de/akademie
Fit für die Notfallambulanz und den ersten Dienst Fortbildung für Weiterbildungsassistenten
Wer kennt sie nicht, die Aufregung vor dem ersten Nachtdienst in der Klinik oder dem ersten Notdienst. Habe ich alles richtig gemacht? Wann muss ich den Oberarzt rufen? Ist eine ambulante Behandlung möglich oder muss stationär eingewiesen/aufgenommen werden, gar auf die Intensivstation? Solche und ähnliche Fragen müssen oft einsam und zunehmend ohne ausreichende Vorbereitung beantwortet werden. Das Seminar möchte einen Beitrag zur besseren Ausbildung in diesem Bereich leisten.
Die häufigsten Erkrankungen und Notfälle sollen anhand von lehrreichen Fallbeispielen aus dem Ambulanz- und Stationsalltag dargestellt und interaktiv mit Ihnen das sinnvolle diagnostische und therapeutische Vorgehen besprochen werden.
Das Seminar wird in diesem Jahr erstmals 2-tägig durchgeführt.
Am Freitagnachmittag erwarten Sie Fachvorträge, die am Samstag mit Kasuistiken zu verschiedenen Themen ergänzt werden. In Form von praktischen Übungen können Sie zudem Ihr erlerntes Wissen vertiefen. Zusätzlich wird ausreichend Zeit für Fragen und Diskussion bleiben. Bringen Sie auch Ihre eigenen Fälle – zumindest aus dem Gedächtnis –mit.
Teilnehmende an den „Willkommensabenden für neuapprobierte Ärztinnen und Ärzte“ der Bezirksärztekammer Nordbaden im Jahr 2022 oder 2023 (nächste Termine: Karlsruhe 28. 6. 2023, Heidelberg 11. 10. 2023) erhalten rabattierten Zugang zur Fortbildung.
Das detaillierte Programm finden Sie auf unserer Homepage unter dem unten angegebenen Link.
Termin:
Freitag, 20. Oktober 2023
14.00–ca. 18.30 Uhr und Samstag, 21. Oktober 2023
9.00–ca. 16.30 Uhr
Referenten: Dr. med. Joachim Aspacher, Sektionsleiter Gastroenterologie, Klinik für Innere Medizin, SRH-Klinikum KarlsbadLangensteinbach
Dr. med. Wolf Esser, ehem. ltd. Oberarzt, Neurologische Klinik, Städtisches Klinikum Karlsruhe
Dr. med. Christian Feindel, Oberarzt der Klinik für Innere Medizin, stellv. Leiter ZNA, SRH-Klinikum Karlsbad-Langensteinbach
Dott. Aldo Marano, ltd. Oberarzt der Klinik für Gastroenterologie, Fürst-Stirum-Klinik Bruchsal
Dr. med. Peter Matheiowetz, Sektionsleiter Ultraschallzentrum und Sektionsleiter Diabetologie, St. Josefskrankenhaus Heidelberg
Prof. Dr. med. Martin Hausberg, Direktor der Medizinischen Klinik I (Allgemeine Innere Medizin, Nephrologie, Rheumatologie und Pneumologie), Städtisches Klinikum Karlsruhe
Giw Nayebagha, Oberarzt der Klinik für Kardiologie, Intensivmedizin und Angiologie, ViDia Christliche Kliniken Karlsruhe, Standort St. Vincentius-Kliniken
ÄBW 07 | 2023 475 Bekanntmachungen
Dr. med. Ralph Oberacker, Chefarzt der Klinik für Innere Medizin, Sektionsleiter Kardiologie, SRHKlinikum Karlsbad-Langensteinbach
Prof. Dr. med. Matthias Weisbrod, Chefarzt der Klinik für Psychiatrie und Psychotherapie, SRH-Klinikum Karlsbad-Langensteinbach
Wissenschaftliche Leitung: Dr. med. Joachim Aspacher
Veranstaltungsort: Bezirksärztekammer Nordbaden, Zimmerstr. 4, 76137 Karlsruhe
Zielgruppe: Ärztinnen und Ärzte in Weiterbildung
Gebühr: 170,– Euro ohne Rabatt, 119,– Euro mit Rabatt, inkl. Verpflegung
Fortbildungspunkte: 14 Punkte
Anmeldung: www.baek-nb.de/akademie
EKG in der hausärztlichen Versorgung
Die manuelle Auswertung des Elektrokardiogramms ist trotz Computerprogrammen noch immer unentbehrlich. Wünschen auch Sie sich mehr Sicherheit bei der Interpretation von EKGKurven?
In unserem Seminar werden zunächst die Grundlagen der EKGBefundung aufgefrischt und im Hinblick auf Klinik und hausärztliche Versorgung aktualisiert. Die Referenten erläutern mögliche Störfaktoren bei der EKG-Ableitung und zeigen spezifische Veränderungen bei den häufigen Herzerkrankungen und bei Notfällen auf. Thematisch in Module gegliedert erlernen Sie interaktiv die Grundlagen der EKG-Diagnostik, was Struktur- und Rhythmusanomalien anbelangt. Sie werden selbst EKGs auswerten und können diese anschließend im Plenum diskutieren.
Lernziel des Seminars ist, sich durch praktische Übungen anhand von Fallbeispielen mehr Sicherheit und Routine in der EKG-Auswertung anzueignen. Die praktische Anwendbarkeit für die hausärztliche Versorgung steht im Mittelpunkt dieser Fortbildung. Grundlagen aus dem Studium werden vorausgesetzt.
Termin:
Samstag, 18. November 2023
9.00–ca. 16.00 Uhr
Referenten und wissenschaftliche Leitung: Giw Nayebagha, Oberarzt der Klinik für Kardiologie, Angiologie, Intensivmedizin, ViDia Christliche Kliniken
Karlsruhe, Standort St. VincentiusKliniken
Dr. med. Gerd Ringwald, niedergelassener Facharzt für Innere Medizin, SP Kardiologie, Kardiologie im Friedrichspalais, Zentrum für Herz-KreislaufErkrankungen Bruchsal
Veranstaltungsort: Bezirksärztekammer Nordbaden, Zimmerstr. 4, 76137 Karlsruhe Zielgruppe: niedergelassene Fachärztinnen und Fachärzte für Allgemeinmedizin und Innere Medizin
Gebühr: 120,– Euro inkl. Verpflegung
Fortbildungspunkte: 10 Punkte
Anmeldung: www.baek-nb.de/akademie
Wertschätzende Kommunikation für medizinische Fachangestellte Workshop
In Zeiten überfüllter Praxen und eines teils erhöhten Erwartungsdrucks spielt der Erstkontakt eine entscheidende Rolle für das weitere Verhältnis zwischen Arzt(praxis) und Patienten. Hier wirkt sich die kommunikative Kompetenz von Medizinischen Fachangestellten außerordentlich positiv aus. Durch eine gelingende Kommunikation kann aber nicht nur der Kontakt mit Patienten bzw. deren Angehörigen positiver gestaltet, sondern auch die Kooperationsfähigkeit im Team gestärkt werden.
In unserem Workshop lernen Sie die „Wertschätzende Kommunikation“ als eine Methode, mit anderen einfühlend und zugleich geradlinig zu kommunizieren. Sie erleben, wie Sie berufliche Beziehungen so gestalten können, dass sie von Wertschätzung und Vertrauen geprägt sind. Auf der Grundlage eigener Beispiele aus ihrem beruflichen Alltag trainieren Sie unter Anleitung einer qualifizierten und erfahrenen Trainerin ganz praxisnah
(interaktiv, Rollenspiele, Fallbearbeitung) ein professionelles Kommunikationsverhalten. So lernen Sie, Ihre Fähigkeit zur Empathie zu erweitern und auch in schwierigen, emotionsgeladenen Situationen eine wertschätzende Haltung einzunehmen. Der Nutzen für die Teilnehmenden sowie letztlich für die Praxis zeigt sich in mehr Kooperation, größerer persönlicher Stabilität, effizienterer Zielerreichung und empathischerem Kontakt zu Patienten und deren Angehörigen.
Termin: Donnerstag, 23. November 2023
14.00–ca. 17.15 Uhr und Freitag, 24. November 2023
8.30–ca. 16.00 Uhr
Referentin: Birgit Brand-Hörsting, Trainerin Wertschätzende Kommunikation (nach Dr. M. Rosenberg) Veranstaltungsort: Bezirksärztekammer Nordbaden, Zimmerstr. 4, 76137 Karlsruhe Zielgruppe: Medizinische Fachangestellte Gebühr: 175,– Euro inkl. Verpflegung
Anmeldung: www.baek-nb.de/akademie Die Teilnehmerzahl ist auf 16 Personen begrenzt!
Erfolgreicher kommunizieren
Ob Einzelgespräche, Meetings oder konkrete Arbeitssituationen in hierarchisch unterschiedlichen Konstellationen: Für den Erfolg oder Misserfolg im Gespräch mit anderen Ärztinnen und Ärzten ist die Art der Kommunikation und des Auftretens manchmal entscheidender als die Sachkompetenz: Die notwendige Überzeugungskraft, Souveränität und Glaubwürdigkeit hängen in hohem Maße von sprachlichem Ausdrucksvermögen, Körpersprache, Stimme, psychologischem Geschick, Rollenverständnis und innerer Haltung ab. Insgesamt stellt die Kommunikationsfähigkeit einen wesentlichen Aspekt persönlicher Sozialkompetenz dar, die gerade im beruflichen Alltag immer unverzichtbarer wird.
In diesem Workshop wird bei maximal 7 Teilnehmenden sehr individuell auf die persönlichen sprecherischen und sprachlichen Voraussetzungen eingegangen. Unter Wahrung ihrer Sprecherpersönlichkeit und unterstützt durch Videoanalysen und Simulationen, werden anhand konkreter beruflicher Situationen und von Beispielen Ihre Stärken hervorgehoben und eventuelle Schwächen abgemildert.
Termine:
Freitag, 8. Dezember 2023
14.00–18.30 Uhr und
Samstag, 9. Dezember 2023
9.00–13.30 Uhr
(nur noch Warteliste)
Freitag, 2. Februar 2024
14.00–18.30 Uhr und
Samstag, 3. Februar 2024
9.00–13.30 Uhr
Freitag, 29. November 2024
14.00–18.30 Uhr und Samstag, 30. November 2024
9.00–13.30 Uhr
Referentin: Wilma Küspert, sprechwissenschaftliche Beratung, Training, Coaching Wissenschaftliche Leitung: Prof. Dr. med. Nicola BuhlingerGöpfarth, niedergelassene Fachärztin für Allgemeinmedizin, Pforzheim
Veranstaltungsort: Bezirksärztekammer Nordbaden, Zimmerstr. 4, 76137 Karlsruhe Zielgruppe: Ärztinnen und Ärzte aller Fachrichtungen
Gebühr: 325,– Euro inkl. Verpflegung
Fortbildungspunkte: 14 Punkte
Anmeldung: www.baek-nb.de/akademie Die Teilnehmerzahl ist auf 7 Personen begrenzt!
476 ÄBW 07 | 2023 Bekanntmachungen
Bezirksärztekammer
Südbaden
Geschäftsstelle:
Sundgauallee 27
79114 Freiburg/Br.
Telefon (07 61) 6 00 47-0
Fax (07 61) 89 28 68
Akademie für ärztliche Fort- und Weiterbildung Südbaden
Im Zusammenhang mit der Corona-Pandemie behalten wir uns weiterhin vor, Fortbildungen ggf. kurzfristig abzusagen bzw. unsere Veranstaltungen als Web-Seminare durchzuführen. Bitte informieren Sie sich zum aktuellen Stand auf der Homepage bzw. telefonisch oder per Mail, ob und in welcher Form die Fortbildung stattfindet. Alle unsere Veranstaltungen sind von der Landesärztekammer BW anerkannt und auf das Fortbildungszertifikat anrechenbar.
Bitte melden Sie sich zu unseren Fortbildungsveranstaltungen
über Ihr Dashboard auf den Seiten der Landesärztekammer an. Unser Fortbildungsangebot finden Sie unter folgendem Link: www.baek-sb.de/akademie
systematisch weiter zu vertiefen und aufzufrischen.
Nach Ableistung des Kurses verfügen die Teilnehmer über folgende Kenntnisse/Befähigungen zur Behandlung von Kindern/Erwachsenen:
– Kenntnisse zu Antiinfektiva: Spektrum, Pharmakokinetik, Wechselwirkungen
– Grundlagen der medizinischen Mikrobiologie und der antimikrobiellen Resistenztestung
– Kenntnis und Implementierung einschlägiger Therapieleitlinien
– Beteiligung und Unterstützung von Kommunikationsstrukturen, Schulungen
– Kenntnisse und Befähigung zu Anwendungen beim Infektionsmanagement
Die Befähigung zum ABS-beauftragten Arzt kann bereits im Rahmen der Weiterbildungszeit erworben werden. Der Kurs wird als Blended Learning mit 20 E-Learning-Einheiten und daran anschließenden 2 Live-Online Seminartagen mit nochmals 20 Lerneinheiten durchgeführt. Die E-Learning-Einheiten müssen vor den jeweiligen Live-Online Seminartagen absolviert werden, sie schließen jeweils einzeln mit einer Lernerfolgskontrolle ab. Eine zusätzliche Prüfung vor oder an den LiveOnline Seminartagen erfolgt nicht.
Termin:
E-Learning (Selbstlernphase): ab Montag, 3. Juli 2023
Live-Online Seminar: 19. und 20. Oktober 2023
Zeit: Donnerstag, 9.00 s.t.–ca. 18.45 Uhr
Antibiotic Stewardship (ABS) –Blended Learning (online)
Leitung: Prof. Dr. med. Sebastian Schulz-Stübner, Deutsches Beratungszentrum für Hygiene (BZH GmbH), Freiburg
Der nach dem Curriculum der Bundesärztekammer gestaltete Kurs zum ABS-beauftragten Arzt stellt für die in klinischen Einrichtungen tätigen Ärzte ein Angebot dar, um ihre vorhandenen Kenntnisse und Erfahrungen in rationaler Antiinfektivastrategie
Freitag, 8.00 s.t.–ca. 17.00 Uhr
Ort: online
Entgelt: 700,– Euro
Fortbildungspunkte: 60
Berufsrecht

Leitung: Dr. med. Paula HezlerRusch, Präsidentin der Bezirksärztekammer Südbaden
Klagen von Patienten und Patientinnen, Angehörigen, von Kolleginnen und Kollegen, aber auch
aus Apotheken, Behörden, Gerichten, Polizei landen bei der Kammer. Die Eingänge werden dort geprüft und ggf. dem Kammeranwalt zugeleitet. Dieser ermittelt und erhebt, wenn sich die Sachlage entsprechend darstellt, ein berufswidriges Verhalten im Raum steht, Klage beim Berufsgericht. Eindeutige Straftatbestände werden an die zuständige Staatsanwaltschaft weitergeleitet. In den letzten Monaten betraf dies z. B. insbesondere Atteste zur Befreiung vom Tragen eines Mund-Nasen-Schutzes ohne hinreichend begründeten Hintergrund. Klagen gehen ein wegen Zwistigkeiten, unkollegialem Verhalten, subjektiv erlebter Ungerechtigkeit, oder wegen erlebter Falschbehandlung. Detaillierte Informationen finden Sie auf der Webseite dieser Veranstaltung.
Termin:
Donnerstag, 18. Januar 2024 Zeit: 18.30 s.t.–ca. 20.45 Uhr
Ort: online
Entgelt: 40,– Euro Fortbildungspunkte: 3
Der erste Notdienst –kompetent handeln im ärztlichen Bereitschaftsdienst
Leitung: Dr. med. Martina Bischoff, Fachärztin für Allgemeinmedizin, Dr. med. Gisa Weißgerber, Fachärztin für Innere Medizin Im ärztlichen Bereitschaftsdienst haben Ärztinnen und Ärzte mit allen Themengebieten der Medizin zu tun. Zumeist kennen Sie die Patientinnen und Patienten und deren Vorgeschichte nicht und stehen vor der Herausforderung die adäquaten medizinischen Entscheidungen treffen zu müssen. In unserem zweitägigen Seminar erhalten Sie ein Update in der Erkennung, Zuordnung und Behandlung der häufigen medizinischen Problemstellungen im ärztlichen Bereitschaftsdienst. Die Veranstaltung richtet sich an Ärztinnen und Ärzte, die am ärztlichen Notfalldienst teilnehmen möchten, an (Wieder-)Einsteiger und an alle, die ihr Wissen aktualisieren wollen.
Detaillierte Informationen finden Sie auf der Webseite dieser Veranstaltung.

Termine:
18. November 2023 und 16. Dezember 2023

Zeit: jeweils Samstag, 9.00 s.t.–ca. 17.00 Uhr
Ort: im November im Haus der Ärzte, Sundgauallee 27, Freiburg, im Dezember online
Entgelt: 300,– Euro Fortbildungspunkte: 16
Der Weg zur Anerkennung der ausländischen Approbation in Deutschland
Ärztinnen und Ärzte, die nach Deutschland zuwandern, stehen vor der Aufgabe, sich innerhalb der deutschen Strukturen zurechtzufinden und das hiesige Gesundheitssystem kennenzulernen. In diesem Seminar erhalten Sie eine Zusammenschau der wichtigsten Voraussetzungen zur Anerkennung der ausländischen Approbation. Darüber hinaus werden die gesundheitlichen Versorgungsstrukturen Deutschlands und die wichtigsten Funktionen der Ärztekammer erläutert. Erfahrungsberichte von Ärzten und Ärztinnen aus EU-Staaten als auch aus Nicht-EU-Staaten mit praktischen Tipps zur Bewältigung der am häufigsten anzutreffenden Hürden runden die Veranstaltung ab. Selbstverständlich können Fragen gestellt werden. Die Veranstaltung richtet sich an Ärztinnen und Ärzte, die selbst nach Deutschland zugewandert sind und an solche, die ausländische Kollegen und Kolleginnen bei der Anerkennung der Approbation unterstützen wollen.
Termin:
Montag, 23. Oktober 2023
Zeit: 18.30–20.30 Uhr
Ort: Haus der Ärzte, Sundgauallee 27, Freiburg
Entgelt: kostenfrei –Anmeldung erforderlich
ÄBW 07 | 2023 477 Bekanntmachungen
Diagnostic Stewardship
Bekanntmachungen
Leitung: Prof. Dr. med. Sebastian Schulz-Stübner, Deutsches Beratungszentrum für Hygiene (BZH GmbH), Freiburg, Dr. med. Patrick Weißgerber
Die richtige mikrobiologische Diagnostik zum richtigen Zeitpunkt entscheidet in der Infektiologie nicht selten über den Therapieerfolg und das Schicksal des Patienten. Andererseits erzeugen unnötige Routineuntersuchungen Daten, die im schlimmsten Fall in nicht erforderlichen Therapien und Nebenwirkungen münden und darüber hinaus eine Verschwendung wertvoller Ressourcen darstellen. Unter dem „One Health“-Aspekt hat das sogenannte Diagnostic Stewardship daher auch einen großen Stellenwert bei der Prävention von Resistenzentwicklung und zum rationalen Einsatz von Antiinfektiva. Inhalte
– Diagnostic Stewardship als Teil von Antibiotic Stewardship und Qualitätssicherung
– Kritische Indikationsstellung
– Optimierung der Präanalytik
– Welche mikrobiologische Diagnostik für welchen Patienten
– Befundübermittlung und -interpretation
Termin:
Mittwoch, 6. März 2024 Zeit: 9.00 s.t.–ca. 18.00 Uhr
Ort: online
Entgelt: 180,– Euro
Fortbildungspunkte: 10 (beantragt)
Fit für den ersten Nachtdienst
Leitung: Dr. med. Julian Krehl, Dr. med. Melanie Mörsdorf-Kroll Diese Veranstaltung richtet sich an junge Ärztinnen und Ärzte, die im Nachtdienst eingesetzt sind und auch an Wiedereinsteiger, die ein Update möchten. Die ersten Nachtdienste sind oft eine Herausforderung. In dieser Veranstaltung werden häufige Notfälle und klassische Problemsituationen aus den ersten Diensten, wie z. B. Atemnot, Schmerz, allergische Reaktion, Delir usw.
kurz und prägnant in Kombination mit praktischen Tipps besprochen. Zudem erklärt ein Jurist, was die Pflichten und Rechte als Dienstarzt/-ärztin sind.
Termin:
Montag, 11. Dezember 2023
Zeit: 17.30 s.t.–ca. 22.00 Uhr
Ort: online
Entgelt: 30,– Euro
Fortbildungspunkte: 5
Hygienebeauftragter Arzt –Blended Learning (online)
Leitung: Prof. Dr. med. Sebastian Schulz-Stübner, Deutsches Beratungszentrum für Hygiene (BZH GmbH), Freiburg
Zum Hygienebeauftragten Arzt kann nur bestellt werden, wer über eine mindestens zweijährige Berufserfahrung verfügt und spezielle Kenntnisse auf dem Gebiet der Hygiene und der Infektionsprävention erworben hat. Die Mindestanforderung beinhaltet den Besuch eines vierzigstündigen Kurses nach dem Curriculum der Bundesärztekammer. Der Kurs entspricht dem Modul I der curriculären Fortbildung „Krankenhaushygiene“.
Regelmäßig bieten wir in Zusammenarbeit mit dem Deutschen Beratungszentrum für Hygiene (BZH) die curriculäre Fortbildung „Hygienebeauftragter Arzt“ als Blended Learning mit zwei LiveOnline Seminartagen in Kombination mit 20 E-Learning-Einheiten an.
Die E-Learning-Einheiten müssen vor den jeweiligen Live-Online Seminartagen absolviert werden, sie schließen jeweils einzeln mit einer Lernerfolgskontrolle ab. Eine zusätzliche Prüfung vor oder an den Präsenztagen erfolgt nicht.
Termine:
E-Learning (Selbstlernphase): ab Montag, 11. September 2023
Live-Online Seminar:
14. und 15. Dezember 2023
Zeit: Donnerstag, 9.00 s.t.–ca. 18.45 Uhr
Freitag, 8.00 s.t.–ca. 17.00 Uhr
Ort: online Entgelt: 700,– Euro Fortbildungspunkte: 60
Info zu Weiterbildung und Logbuch für Weiterbildungsbefugte
Leitung: Dr. med. Gisa Weißgerber, Vorsitzende des Weiterbildungsausschusses der Bezirksärztekammer Südbaden
Die Veranstaltung richtet sich an Weiterbildungsbefugte und an Kolleginnen und Kollegen, die eine Weiterbildungsbefugnis neu beantragen wollen. Die bisherigen Befugnisse nach WBO 2006 gelten noch für eine Übergangsfrist ab Bekanntmachung der neuen Weiterbildungsordnung zum 1. 7. 2020. Weiterbildungsbefugnisse können seit 1. 1. 2020 ausschließlich online und ausschließlich nach der WBO 2020 beantragt werden. Das Logbuch ist ab 1. 1. 2020 ebenfalls ausschließlich online zu führen, wenn die Weiterbildung ab 1. 1. 2020 begonnen wurde. Gerne wollen wir Ihnen die Neue Weiterbildungsordnung und das Logbuch vorstellen.
Kursinhalte:
Begrüßung
Dr. med. Paula Hezler-Rusch, Präsidentin der Bezirksärztekammer Südbaden
Formale und praktische Aspekte der Weiterbildung: Auf was muss ich achten?
Dr. med. Gisa Weißgerber, Vorsitzende des Weiterbildungsausschusses der Bezirksärztekammer
Südbaden
Neue WBO und E-Logbuch
Dr. med. Gisa Weißgerber, Vorsitzende des Weiterbildungsausschusses der Bezirksärztekammer
Südbaden
Live Demonstration des E-Logbuchs
Ulf Kester, Softwarearchitekt, Steadforce München
Termin:
Montag, 10. Juni 2024
Zeit: 19.00 s.t.–ca.21.00 Uhr
Ort: Haus der Ärzte, Sundgauallee 27, Freiburg
Entgelt: 30,– Euro
Fortbildungspunkte: 2
Info zu Weiterbildung und Logbuch für
Berufseinsteiger
Leitung: Dr. med. Gisa Weißgerber, Vorsitzende des Weiterbildungsausschusses der Bezirksärztekammer Südbaden
Dieses Seminar ist ein Angebot an alle, die frisch approbiert sind oder sich bereits in der Weiterbildung zum Facharzt befinden. Nach der Approbation erfolgt der Berufseinstieg als Assistenzarzt und damit beginnt für junge Ärztinnen und Ärzte die Facharztausbildung. Die Ausbildung zum Facharzt erfordert in der Regel 5 bis 6 Jahre Weiterbildungszeit, abhängig vom gewählten Fachbereich.
In dieser Veranstaltung wollen wir alle Fragen rund um Weiterbildung und Logbuch beantworten.
Kursinhalte:
Begrüßung
Dr. med. Paula Hezler-Rusch, Präsidentin der Bezirksärztekammer
Südbaden
Praktische Aspekte der Weiterbildung: Auf was muss ich achten?
Dr. med. Gisa Weißgerber, Vorsitzende des Weiterbildungsausschusses der Bezirksärztekammer
Südbaden
Formale Aspekte der Weiterbildung: Was benötige ich zur Beantragung des Facharzttitels?
Ass. iur. Robin Förster, Fachanwalt für Medizinrecht, Rechtsberater der Bezirksärztekammer
Südbaden
Erfahrungen aus Sicht der Weiterzubildenden
Dr. med. Sarah Wendel; Dr. med. Kristina Unteregger; Dr. med. Teresa Henle
Neue Weiterbildungsordnung und E-Logbuch
Dr. med. Gisa Weißgerber, Vorsitzende des Weiterbildungsausschusses der Bezirksärztekammer Südbaden
Termin:
Montag, 1. Juli 2024
Zeit: 18.00–ca. 21.00 Uhr
Ort: Haus der Ärzte, Sundgauallee 27, Freiburg
Entgelt: kostenfrei – Anmeldung
erforderlich
Fortbildungspunkte: 3
478 ÄBW 07 | 2023
Medizinische Hypnose für Ärzte Einführungskurs
Leitung: PD Dr. med. Uwe Ross, Freiburg
In diesem einführenden Workshop werden auf der Basis aktueller neurophysiologischer Erkenntnisse wirkungsvolle Adhoc-Interventionen der modernen Hypnose bei Schmerz- und somatoformen Störungen, Schlafstörungen, Spannungszuständen, nichtorganischen Schwindelbeschwerden und Tinnitus praktisch erfahrbar vermittelt. Wesentlicher Vorteil hypnotherapeutischer Ansätze in der Behandlung dieser Störungen ist, dass sie – konsequent ressourcen- und lösungsorientiert eingesetzt – vermehrt die unwillkürlich-unbewusste Erlebnisebene des Patienten einbeziehen und u. a. bei Schmerz objektivierbare psychobiologische Wirkungen entfalten. Die Teilnehmerinnen und Teilnehmer erwerben erste Einblicke und methodische Fertigkeiten in der Anwendung spezieller HypnoseTechniken zur Beschwerdeminderung und zur Aktivierung innerer Ressourcen bei psychosomatischen Störungen sowie bei Spannungszuständen, z. B. vor medizinischen Eingriffen.
Termin:
Samstag, 23. September 2023
Zeit: 9.00 s.t.–16.00 Uhr
Ort: Haus der Ärzte, Sundgauallee 27, Freiburg
Entgelt: 150,– Euro Fortbildungspunkte: 10
Medizinische Hypnose
Basiskurs (online)
Leitung: PD Dr. med. Uwe Ross, Freiburg
In diesem Online-Basiskurs zur Medizinischen Hypnose werden wirkungsvolle Ad-hoc-Interventionen der modernen Hypnose unmittelbar erlebbar trainiert, wie sie bei akuten und chronischen Schmerzen, somatoformen Störungen, Schlafstörungen, Stress- und Spannungszuständen, nichtorganischen Schwindelbeschwerden und Tinnitus wirksam eingesetzt werden.
Kursinhalte
Grundlagen, Indikationen und Kontraindikationen
– Ablauf, Prinzipien und Wirkungsweisen
– Hypnotischer Sprachgebrauch
– Diverse, grundlegende TranceInduktionstechniken
Hypnose-Interventionen zur Tiefenentspannung und Ressourcen-Aktivierung
Dieser Basiskurs mit 16 Unterrichtseinheiten bildet die Grundlage für hierauf aufbauende Kurse.
Medizinische Hypnose ist mit 2x16 Unterrichtseinheiten als Zweitverfahren im Rahmen der Weiterbildung Psychotherapie anerkannt.
Termin:
14. und 15. Juli 2023
Zeit: Freitag, 14.00 s.t.–19.30 Uhr Samstag, 9.00 s.t.–18.00 Uhr
Ort: online
Entgelt: 300,– Euro Fortbildungspunkte: 20
Workshop „Impfen“
Leitung: Dr. med. Rosemarie Mazzola, Freiburg; Prof. Dr. Markus Hufnagel, Freiburg Schutzimpfungen sind ein Bestandteil ärztlicher Vorsorge und moderner Krankheitsprävention. Für diese präventiven Maßnahmen ist eine sorgfältige medizinisch-epidemiologische NutzenRisiko-Bewertung auf der Basis der besten verfügbaren Evidenz erforderlich. Dazu gibt die Ständige Impfkommission (STIKO) ihre Empfehlungen zur Durchführung von Schutzimpfungen und anderen Maßnahmen der spezifischen Prophylaxe übertragbarer Krankheiten, die zeitnah aktualisiert werden. Sie dienen den obersten Landesgesundheitsbehörden als Grundlage für deren öffentliche Empfehlungen und bilden die Grundlage für die Entscheidung des Gemeinsamen Bundesausschusses (G-BA), ob eine Schutzimpfung als Pflichtleistung von der gesetzlichen Krankenkasse übernommen wird. Ziel dieses Seminars ist es, Sie über das aktuelle, evidenzbasierte Wissen zu den Schutzimpfun-
gen, den Empfehlungen bei Risikogruppen einschließlich Immundefizienz und über das Vorgehen und die zu beachtenden Vorschriften in der Praxis umfassend zu informieren.
Inhalt des Seminars:
– Grundlagen des Impfens, Epidemiologie-Impfstofftypen
– Impfsystem in Deutschland
– Impfpräventable Erkrankungen
– Risiken, Nebenwirkungen
– Impfen von Risikopatienten, Immundefizienz
Vorgehen in der Praxis
Diskussion von Fallbeispielen
Termine:
21. Oktober 2023
13. April 2024
Zeit: jeweils Samstag, 9.00 s.t.–ca. 15.30 Uhr
Ort: 2023 online, 2024 im Haus der Ärzte, Sundgauallee 27, Freiburg Entgelt: 100,– Euro Fortbildungspunkte: 7
Notfallmedizin
Notarztseminar zum Erwerb der Zusatzbezeichnung „Notfallmedizin“ in Freiburg
Leitung: Dr. med. Daniel Schmitz, Dr. med. Daniel Herschel, Kompetenzzentrum Notfallmedizin St. Josefskrankenhaus Freiburg, Matthias Ziegler B. A., DRK BW Das Seminar wird entsprechend dem Curriculum der Bundesärztekammer durchgeführt und ist bundesweit anerkannt. Die Teilnehmer erhalten eine qualitativ hochwertige Ausbildung im Bereich der Notfallmedizin auf Grundlage aktueller internationaler Richtlinien wie ERC und ATLS Algorithmen. Sichergestellt wird ein hoher Anteil an praktischen Übungen und Simulationen in kleinen Arbeitsgruppen. Einbezogen werden zudem alle an der Notfallversorgung beteiligten Organisationen wie Feuerwehr und Polizei.
Kursinhalte: – Grundlagen und Basistherapie
– Internistische Notfälle I und II
– Traumatologische Notfälle I und II
– Spezielle Notfälle und Einsatztaktik
Termin:
20.–28. November 2023
(Mo-Di, ohne Sonntag)
Zeit: 8.00 s.t.–ca. 18.30 Uhr
Ort: Berufsfeuerwehr
Entgelt: 1.300,– Euro Fortbildungspunkte: 80
Notarztseminar zum Erwerb der Zusatzbezeichnung „Notfallmedizin“ in Villingen-Schwenningen
Leitung: Prof. Dr. med. Bernhard Kumle, Direktor der Klinik für Akut und Notfallmedizin, Prof. Dr. med. Sebastian G. Russo, MaHM, DEAA, Direktor der Klinik für Anästhesiologie, Intensiv-, Notfall- und Schmerzmedizin, Dr. Manfred Kleimaier, Klinik für Anästhesie und Intensivmedizin, Schwarzwald-Baar Klinikum Villingen-Schwenningen Das Seminar wird entsprechend dem Curriculum der Bundesärztekammer durchgeführt und ist bundesweit anerkannt. Die Teilnehmer erhalten eine qualitativ hochwertige Ausbildung im Bereich der Notfallmedizin auf Grundlage aktueller internationaler Richtlinien wie ERC und ATLS Algorithmen. Sichergestellt wird ein hoher Anteil an praktischen Übungen und Simulationen in kleinen Arbeitsgruppen.
Kursinhalte:
– Grundlagen und Basistherapie
– Internistische Notfälle I und II
Traumatologische Notfälle I und II
– Spezielle Notfälle und Einsatztaktik
Termin:
16.–23. März 2024 (Sa–Sa) Zeit: 8.00 s.t.–ca. 18.30 Uhr
Ort: Schwarzwald-Baar Klinikum, Klinikstr. 11, 78052 Villingen-Schwenningen
Entgelt: 1.300,– Euro Fortbildungspunkte: 80
ÄBW 07 | 2023 479 Bekanntmachungen
–
–
–
–
–
Notfalltraining für Notärzte –Refresher-Kurs
Leitung: Dr. med. Daniel Schmitz, Dr. med. Christian Schaller, Dr. med. Daniel Herschel, Kompetenzzentrum Notfallmedizin St. Josefskrankenhaus Freiburg, Matthias Ziegler B. A., DRK BW Der Refresher-Kurs Notfalltraining für Notärzte wendet sich an Ärztinnen und Ärzte, die vor längerer Zeit die Zusatzqualifikation Notfallmedizin/Fachkundenachweis Rettungsdienst erworben haben und sich auf den Wiedereinstieg in die Notfallmedizin vorbereiten möchten oder für Ihre Tätigkeit in der Notfallmedizin ein praxisnahes „Update“ benötigen.
Kursinhalte:
Tag 1: Wiederholung der Grundlagen (Erstuntersuchung, Reanimation, Atemwegssicherung), Herzrhythmusstörungen und ihre Therapie
Tag 2: Kindernotfälle
Tag 3: Traumaversorgung
Tag 4: Chirurgische Skills, Notfallnarkose, Teaminteraktion und Crew Ressource Management
Lernformen: Vorträge, Diskussionen, Praxistraining, Fallbesprechungen
Wir empfehlen Ihnen alle 4 Tage zu besuchen, um Ihre Kenntnisse auf den aktuellen Stand zu bringen. Die Tage sind auch einzeln buchbar.
Termine:
Teil 1: 28. und 29. Juni 2024 (geplant)
Teil 2: 26. und 27. Juli 2024 (geplant)
Zeit: jeweils freitags und samstags, 9.00 s.t.–ca. 18.30 Uhr
Ort: DRK Landesschule
Baden-Württemberg gGmbH, Rimsinger Weg 15A
Entgelt: 250,– Euro/Tag
Fortbildungspunkte: 12 pro Tag
Notfalltraining für Ärzte
Leitung: Dr. med. Daniel Schmitz, Dr. med. Christian Schaller, Dr. med. Daniel Herschel, Kompetenzzentrum Notfallmedizin St. Josefskrankenhaus Freiburg, Matthias Ziegler B. A., DRK BW
Grundkurs Medizinische Notfallsituationen können uns jeden Tag begegnen: in der Klinik, in unserer Praxis oder aber auf der Straße. Im entscheidenden Moment die richtigen Maßnahmen zu ergreifen und mit der lebensnotwendigen Therapie zu beginnen, gehört zu dem Anspruch, dem sich im Alltag jeder Arzt und jede Ärztin stellen muss.
In diesem Tagesseminar wird Ihnen das Handwerkszeug für eine erfolgreiche Notfallversorgung vermittelt. Anhand von kurzen Vorträgen, praktischen Unterweisungen und realitätsnahen Übungen können Sie Ihr Notfallwissen auf den neuesten Stand der Empfehlungen bringen und erlernen die richtigen Schritte der ärztlichen Erstversorgung und Notfallbehandlung.
Kursinhalte:
Grundlagen der Notfallversorgung, Reanimation, Beatmung und Atemwegssicherung, typische Notfallsituationen, Medikamentenapplikation, Teamführung und Notfallmanagement
Termin:
Samstag, 21. Oktober 2023
Zeit: 9.00 s.t.–17.00 Uhr
Ort: DRK Landesschule
Baden-Württemberg gGmbH, Rimsinger Weg 15A, Freiburg
Entgelt: 250,– Euro Fortbildungspunkte: 11
Themengebiet „Unfall“ –Traumatologische Notfälle
Notfälle aus dem Bereich „Unfall“ spielen sowohl im Straßenverkehr, in heimischer Umgebung oder beim Sport eine bedeutende Rolle.
In diesem Tagesseminar erhalten Sie einen Überblick über die typischen traumatologischen Notfallbilder. Anhand von kurzen Vorträgen, praktischen Unterweisungen und realitätsnahen Übungen können Sie Ihr Notfallwissen auf den neuesten Stand der Empfehlungen bringen und erlernen die richtigen Schritte der Notfallbehandlung bei Unfällen.
Voraussetzung für die Teilnahme am Kurs ist der Besuch des Grundkurses oder vergleichbare Kenntnisse.
Kursinhalte:
Grundlagen der Notfallversorgung, strukturierte Untersuchung des Traumapatienten, Traumamechanismen, typische Verletzungsmuster, Erstversorgung und Immobilisation
Termin:
Samstag, Februar 2025 (geplant)
Zeit: 9.00 s.t.–17.00 Uhr
Ort: DRK Landesschule Baden-Württemberg gGmbH, Rimsinger Weg 15A, Freiburg Entgelt: 250,– Euro Fortbildungspunkte: 11
Themengebiet „Herz“ –Kardiologische Notfälle
Notfälle aus dem Bereich „Kardiologie“ stellen eine häufige Notfallkategorie dar. In diesem Tagesseminar erhalten Sie einen Überblick über die typischen kardiologischen Notfallbilder. Anhand von kurzen Vorträgen, praktischen Unterweisungen und realitätsnahen Übungen können Sie Ihr Notfallwissen auf den neuesten Stand der Empfehlungen bringen und erlernen die richtigen Schritte der Notfallbehandlung bei kardiologischen Notfällen.
Voraussetzung für die Teilnahme am Kurs ist der Besuch des Grundkurses oder vergleichbare Kenntnisse.
Kursinhalte:
Grundlagen der Notfallversorgung, Reanimation, Herzrhythmusstörungen, Herzinfarkt, akute Herzinsuffizienz, hypertensiver Notfall
Termin:
Samstag, März 2024 (geplant) Zeit: 9.00 s.t.–17.00 Uhr
Ort: DRK Landesschule Baden-Württemberg gGmbH, Rimsinger Weg 15A, Freiburg Entgelt: 250,– Euro Fortbildungspunkte: 11
Themengebiet „Kind“ –Pädiatrische Notfälle
Notfälle aus dem Bereich „Pädiatrie“ stellen eine besondere Herausforderung für jeden Arzt/jede Ärztin dar.
In diesem Tagesseminar erhalten Sie einen Überblick über die typischen pädiatrischen Notfallbilder. Anhand von kurzen Vorträgen, praktischen Unterweisungen und realitätsnahen Übungen können Sie Ihr Notfallwissen auf den neuesten Stand der Empfehlungen bringen und erlernen die richtigen Schritte der ärztlichen Erstversorgung und Notfallbehandlung bei Notfällen rund um Kinder.
Voraussetzung für die Teilnahme am Kurs ist der Besuch des Grundkurses oder vergleichbare Kenntnisse.
Kursinhalte:
Grundlagen der Notfallversorgung beim Kind, Besonderheiten des kindlichen Organismus, typische Krankheitsbilder und Notfälle, typische Verletzungen bei Unfällen mit Kindern, Reanimation und Atemwegssicherung
Termin:
Samstag, 20. Juli 2024 (geplant)
Zeit: 9.00 s.t.–17.00 Uhr
Ort: DRK Landesschule Baden-Württemberg gGmbH, Rimsinger Weg 15A, Freiburg Entgelt: 250,– Euro Fortbildungspunkte: 11
Themengebiet
Neurologische Notfälle
In diesem Tagesseminar erhalten Sie einen Überblick über die typischen neurologischen Notfallbilder. Anhand von kurzen Vorträgen, praktischen Unterweisungen und realitätsnahen Übungen können Sie Ihr Notfallwissen auf den neuesten Stand der Empfehlungen bringen und erlernen die richtigen Schritte der ärztlichen Erstversorgung und Notfallbehandlung bei neurologischen Notfällen.
480 ÄBW 07 | 2023
Bekanntmachungen
Kursinhalte:
Grundlagen der Notfallversorgung, Besonderheiten bei neurologischen Notfällen, Typische Symptome und eindeutige Klassifizierung auch von schwer zu erkennenden neurologischen Notfällen, Neurologische Untersuchung und Möglichkeiten der Erstversorgung
Termin:
Samstag, 14. Oktober 2023
Zeit: 9.00 s.t.–17.00 Uhr
Ort: DRK Landesschule
Baden-Württemberg gGmbH, Rimsinger Weg 15A, Freiburg
Entgelt: 250,– Euro
Fortbildungspunkte: 11
Notfalltraining für Arzt und Praxisteam
Leitung: Dr. med. Stefan Leisinger, Maulburg
Durchführung: Jürgen Weber, SIMED, Freiamt
Im Praxisalltag kann es ganz unvorhersehbar zu verschiedensten Notfällen kommen. Es ist dann die Aufgabe des Praxisteams die Erstversorgung sicherzustellen, die Notfallmaßnahmen durchzuführen und lebensrettende Entscheidungen zu fällen. In diesem Tagesseminar werden Sie fit gemacht für den Notfall!
Kursinhalte:
– Grundlagen der Notfallversorgung, Reanimation – Beatmung und Atemwegssicherung
typische Notfallsituationen
– Teamführung und Notfallmanagement
Bitte beachten Sie: Teilnehmende (Arzt und MFA) müssen sich separat anmelden und dabei jeweils unseren AGB und Datenschutzbestimmungen zustimmen.
Termin:
Mittwoch, 13. September 2023
Zeit: 15.00 s.t.–19.00 Uhr
Ort: Haus der Ärzte, Sundgauallee 27, Freiburg
Entgelt: 100,– Euro pro Person
Fortbildungspunkte: 7
Palliativmedizin –Wochenendkurs (Basiskurs)
Leitung: Dr. med. Michael Sigler, Freiburg Der Basiskurs wird entsprechend den curricularen Vorgaben des Kursbuches Palliativmedizin der Bundesärztekammer und den Empfehlungen der Deutschen Gesellschaft für Palliativmedizin e. V. durchgeführt und ist bundesweit anerkannt.
Voraussetzungen zum Erwerb der Zusatzbezeichnung
Facharztanerkennung
– 40 Stunden Kurs-Weiterbildung gemäß § 4 Abs. 8 in Palliativmedizin
– Weiterbildungszeit: 12 Monate bei einem Weiterbildungsbefugten gemäß § 5 Abs. 1 Satz 2 oder anteilig ersetzbar durch 120 Stunden Fallseminar einschließlich Supervision
Seit 2003 treffen sich im Rahmen der vom Arbeitskreis Palliativmedizin Freiburg durchgeführten und von der Akademie für ärztliche Fort- und Weiterbildung der Bezirksärztekammer Südbaden getragenen palliativmedizinischen Basiskurse Ärztinnen und Ärzte aus den unterschiedlichsten Fachgruppen, aus Praxis und Klinik, zur gemeinsamen Fortbildung. Schwerpunkte des Seminars sind die von der Deutschen Gesellschaft für Palliativmedizin gegliederten Inhalte, nämlich Schmerztherapie und Symptomkontrolle, Kommunikation und Ethik in gut ausgewogenem Verhältnis. Ob der Basiskurs als Ausgangspunkt einer intensivierten Ausbildung zum Palliativmediziner, einer Orientierung oder einer Rekapitulation bereits bekannter Fakten dient, ist dabei nebensächlich – der Kurs soll allen Interessierten eine Hilfe im beruflichen (und vielleicht auch persönlichen) Alltag sein.
Termine: 20./21. Oktober 2023 und 10./11. November 2023 und 1./2. Dezember 2023 (Warteliste)
Zeit: freitags, 14.00 s.t.–18.30 Uhr samstags, 9.00 s.t.–18.30 Uhr
Ort: Caritas Tagungszentrum, Freiburg
Entgelt: 800,– Euro Fortbildungspunkte: 40
Palliativmedizin –Basisseminar Wochenkurs
Leitung: Prof. Dr. med. Dipl.-Theol. Dipl.-Caritaswiss. Gerhild Becker
MSc Palliative Care (King’s College London), Universitätsklinikum Freiburg, Lehrstuhl für Palliativmedizin
Der Basiskurs wird entsprechend den curricularen Vorgaben des Kursbuches Palliativmedizin der Bundesärztekammer und den Empfehlungen der Deutschen Gesellschaft für Palliativmedizin e. V. durchgeführt und ist bundesweit anerkannt.
Voraussetzungen zum Erwerb der Zusatzbezeichnung
– Facharztanerkennung
– 40 Stunden Kurs-Weiterbildung gemäß § 4 Abs. 8 in Palliativmedizin – Weiterbildungszeit: 12 Monate bei einem Weiterbildungsbefugten gemäß § 5 Abs. 1 Satz 2 oder anteilig ersetzbar durch 120 Stunden Fallseminar einschließlich Supervision
Kursinhalte und Ziele: – Vermittlung von medizinischen Kenntnissen und Fertigkeiten
– Reflexion der Angemessenheit diagnostischer und therapeutischer Maßnahmen
– Sensibilisierung für eine bedürfnisorientierte und vorausschauende Betreuung
– Vermittlung von Basiswissen in den Bereichen Ethik und Recht
– Sensibilisierung für existentielle, spirituelle und psychosoziale Bedürfnisse der Patienten und ihrer Angehörigen
Besonderheiten der Kommunikation
Termine:
4.–8. Dezember 2023 (online)
Zusatztermin!
5.–9 Februar 2024
Zeit: Montag–Freitag, 9.00 s.t.–ca. 17.30 Uhr
Ort: 2023 online, 2024 Haus der Ärzte, Sundgauallee 27, Freiburg
Entgelt: 800,– Euro
Fortbildungspunkte: 40
Palliativmedizin Fallseminar
Leitung: Prof. Dr. med. Dipl.-Theol. Dipl.-Caritaswiss. Gerhild Becker MSc Palliative Care (King’s College London), Lehrstuhl für Palliativmedizin, Universitätsklinikum Freiburg
Das Kursangebot wendet sich an Ärztinnen und Ärzte in Klinik und Praxis, die bereits den Basiskurs Palliativmedizin erfolgreich absolviert haben und sich in der Betreuung Schwerkranker und Sterbender besonders engagieren möchten.
Das Fallseminar ist multidisziplinär konzipiert und beachtet die Empfehlungen der Deutschen Gesellschaft für Palliativmedizin e. V. und der Bundesärztekammer, die in Zusammenarbeit mit anderen medizinischen Fachgesellschaften erarbeitet wurden. Weiterhin werden Kursinhalte des German Program in Palliative Care Education genutzt (Verbundprojekt der durch die Deutsche Krebshilfe geförderten Akademien für Palliativmedizin in Zusammenarbeit mit der Harvard Medical School, Center for Palliative Care, Boston, USA und der Christopherus Akademie, Interdisziplinäres Zentrum für Palliativmedizin der Universität München).
Das Fallseminar besteht aus 3 Modulen à 40 Kurseinheiten, die sich über jeweils fünf Tage erstrecken.
Modul 1
Der schwerkranke, sterbende Patient, sein soziales Umfeld und das behandelnde Team
Modul 2
Der individuelle Prozess des Sterbens im gesellschaftlichen Kontext
Modul 3
Professionelles Handeln in der Palliativmedizin
ÄBW 07 | 2023 481 Bekanntmachungen
–
–
–
Termine:
Bekanntmachungen
Modul 3: 16.–20. Oktober 2023 (Warteliste)
Modul 1: 3.–7. Juni 2024
Modul 2: 15.–19. Juli 2024
Modul 3: 14.–18. Oktober 2024
Zeit: jeweils Montag–Freitag, 9.00 s.t.–ca. 17.30 Uhr
Ort: i. d. R. Haus der Ärzte, Sundgauallee 27, Freiburg
Entgelt: 800,– Euro
Fortbildungspunkte: 120 (pro Modul 40 Punkte)
Prüferworkshop
Leitung: Dr. med. Paula HezlerRusch, Präsidentin der Bezirksärztekammer Südbaden
Prüferinnen und Prüfer in Facharztprüfungen müssen unterschiedlichste Anforderungen berücksichtigen. Ziel einer Prüfung ist es, die Kenntnisse und Fertigkeiten des Prüflings möglichst umfassend abzubilden, um zu einem objektiven und fairen Urteil zu gelangen. Die Prüfungsfragen sollten deshalb sowohl ein bestimmtes inhaltliches Spektrum abdecken als auch im Schwierigkeitsgrad variieren. Weiter muss natürlich auch jede Prüfung bestimmten formalen Ansprüchen gerecht werden. Dies alles ist vom Prüfungsgremium während der Prüfung „in Echtzeit“ umzusetzen.
Kursinhalte:
Rechtliche Aspekte bei der Abnahme von Prüfungen
Dr. med. Paula Hezler-Rusch, Präsidentin der Bezirksärztekammer
Südbaden
Prüfungsfragen entwickeln
Dr. med. Irmgard Streitlein-Böhme, Dr. med. Klaus Böhme MME, Abteilung für Allgemeinmedizin, Ruhr Universität Bochum
Prüfungssimulation
Dr. med. Irmgard Streitlein-Böhme, Dr. med. Klaus Böhme MME, Abteilung für Allgemeinmedizin, Ruhr Universität Bochum
Termin:
Freitag, 6. Oktober 2023
Zeit: 14.00 s.t.–ca. 18.00 Uhr
Ort: i. d. R. Haus der Ärzte
Sundgauallee 27, Freiburg
Entgelt: 100,– Euro
Fortbildungspunkte: 4
Psychosomatische Grundversorgung
Leitung: Prof. Dr. Mathias Berger, Universitätsklinik für Psychiatrie und Psychosomatik, Freiburg
Die aktuelle Weiterbildungsordnung schreibt für nahezu alle Fachgebiete den Erwerb von Kenntnissen in psychosomatischer Grundversorgung vor. Diese Qualifikation kann durch Teilnahme an den Kursen entsprechend den jeweiligen Vorgaben der WBO erworben werden. Die Vorgaben beinhalten beispielsweise für Kolleginnen und Kollegen in 5-jähriger Weiterbildung zum Facharzt für Allgemeinmedizin Kenntnisse über 80 Stunden Psychosomatik: 20 Std. Theorie, 30 Std. verbale Intervention sowie 30 Std. Balintgruppenarbeit. Diese werden durch den Besuch von 10 Tageskursen à 8 Stunden nach eigener Wahl nachgewiesen. Alternativ kann auch der Wochenkurs PGV mit 5 Tageskursen kombiniert werden.
Die Leistungen nach den EBMZiffern 35100/35110 (Theorieseminare, Reflexion der Arzt-Patient-Beziehung, verbale Interventionstechniken) dürfen nur von Ärzten erbracht werden, die eine Qualifikation durch Teilnahme an einem 80-stündigen Seminar erworben haben.
Im Rahmen der Verträge zur hausarztzentrierten Versorgung (HZV) ist das Seminar PGV für die Qualifikation Psychosomatik anrechenbar.
Tageskurse (8 Std.)
16. September 2023
Depressionen, Burnout
14. Oktober 2023
Psychoonkologie am Bsp. des Mammakarzinoms
27. Oktober 2023
Einführung in die patientenzentrierte Konsultation
Zeit: i. d. R. jeweils Samstag, 9.00 s.t.–16.00 Uhr
Ort: i. d. R. Haus der Ärzte, Sundgauallee 27, Freiburg
Entgelt: 150,– Euro pro Kurs
Fortbildungspunkte: jeweils 8 Wochenkurs (38 Std.):
Termin:
6.–10. November 2023
Zeit: Montag–Freitag, 9.00 s.t.–16.00 Uhr
Ort: online
Entgelt: 600,– Euro pro Kurs
Fortbildungspunkte: 38
Psychosomatische Grundversorgung
Wochenendkurs (50 Std.)
Leitung: Dr. med. Oliver Müller, Konstanz
Dieser Kurs zur psychosomatischen Grundversorgung orientiert sich an dem Musterkursbuch für die Psychosomatische Grundversorgung der Bundesärztekammer. Der Kurs bietet innerhalb von 6 Monaten 6 Ganztagesveranstaltungen. Im Rahmen der Verträge zur hausarztzentrierten Versorgung (HZV) ist das Seminar PGV für die Qualifikation Psychosomatik anrechenbar. Im gesamten Kurs sind folgende Stunden enthalten:
– Theorie: 20 Stunden
– Verbale Intervention: 30 Stunden
Die Inhalte der patientenzentrierten Selbsterfahrung (Balintgruppe) sind nicht in diese Seminare integriert, wir empfehlen die kontinuierliche Teilnahme an einer Balintgruppe am Heimatort. Seitens des WKR wird eine Balintgruppe für die Kursteilnehmer eröffnet.
Termine:
13. Januar 2024
10. Februar 2024
9. März 2024
13. April 2024
4. Mai 2024
8. Juni 2024
Zeit: i. d. R. jeweils Samstag, 9.00–16.30 Uhr
Ort: ZfP Reichenau, Kliniken
Schmieder Konstanz
Entgelt: 150,– Euro pro Kurstag
Fortbildungspunkte: 50 (für 6 Tage)
eLearning zur Diagnosestellung psychischer Störungen
Leitung: Prof. Dr. Mathias Berger
In diesem E-Learning im Themenbereich Psychosomatische Grundversorgung erfahren Sie, wie Sie effizient und kompetent die wichtigsten psychischen Störungen diagnostizieren können. Anhand von Video-Demonstrationen wird die Vorgehensweise bei verschiedenen Störungsbildern gezeigt. Sie bekommen Anleitungen für diagnostische Interviews zusätzlich als Download. Zur Unterstützung bei der praktischen Umsetzung können Sie einen Erfahrungsbericht einreichen und bekommen professionelles Feedback.
Nach Zahlungseingang steht Ihnen das E-Learning rund um die Uhr zur Verfügung. Die Bearbeitung dauert insgesamt ca. 6 Stunden und endet mit einem Multiple-Choice-Test. Das erfolgreichen abgeschlossene eLearning kombiniert mit dem Besuch der zusätzlich angebotenen online Balintgruppe wird wie ein Präsenz-Samstag anerkannt.
Termin: 24/7
Ort: online
Entgelt: 100,– Euro Fortbildungspunkte: 16
Details und Anmeldung: www.baek-sb.de/akademie Balintgruppen online
Leitung: Prof. Dr. Mathias Berger, Dr. Christian Klesse, PD Dr. med. Uwe Ross, Freiburg
Ort: online
Zeit: abends
Entgelt: 60,– Euro Fortbildungspunkte: jeweils 4
Termine, Details und Anmeldung: www.baek-sb.de/akademie
482 ÄBW 07 | 2023
Reisemedizin
Basisseminar Reisemedizin
gem. Curriculum der Bundesärztekammer (32 Std.) „Reisemedizinische Gesundheitsberatung“
Leitung: Dr. Rosemarie Mazzola, Freiburg; Prof. Dr. med. Winfried Kern, Freiburg
Das 32-stündige Seminar Reisemedizin vermittelt dem Arzt Basiswissen für eine qualifizierte, auf individuelle Bedürfnisse zugeschnittene reisemedizinische Beratung. In zwei Wochenendblöcken werden Grundlagen der Tropenmedizin behandelt, Gesundheitsrisiken im Zusammenhang mit Reisen aufgezeigt und die entsprechenden Vorsorgemaßnahmen besprochen. Aspekte der Flug-, Tauch- und Höhenmedizin sind ebenso Inhalt wie Erkrankungen bei Reiserückkehrern. In Ergänzung zu den Vor trägen wird aktuelles Lernund Informationsmaterial zur Verfügung gestellt und die Möglichkeit geboten, eigene „Problemfälle“ mit den Referenten zu erörtern.
Die Teilnehmer können im Seminar an einer Kenntnisprüfung teilnehmen. Bei erfolgreichem Abschluss erhalten Sie eine Teilnahmebescheinigung über die curriculare Fortbildung gem. dem BÄK Curriculum Reisemedizinische Gesundheitsberatung. Die Bezirksärztekammer Südbaden darf Ihren Mitgliedern auf Wunsch eine Urkunde über den erfolgreichen Abschluss der curricularen Fortbildung (cF) „Reisemedizinische Gesundheitsberatung“ ausstellen. Wenn Sie kein Mitglied der Bezirksärztekammer Südbaden sind, wenden Sie sich bitte mit der Teilnahmebescheinigung an die für Sie zuständige Ärztekammer.
Die Bescheinigung über die erfolgreiche Teilnahme an diesem Kurs wird für die Beantragung zur Zulassung als Gelbfieberstelle benötigt.
Termine:
Teil 1: 26. und 27. Januar 2024
Teil 2: 23. und 24. Februar 2024
Zeit: jeweils Freitag und Samstag, ganztägig
Ort: Haus der Ärzte, Sundgauallee 27, Freiburg
Entgelt: 600,– Euro Fortbildungspunkte: 32
Reisemedizin –Aufbaumodule zum Erwerb des Fachzertifikats der Deutschen Fachgesellschaft für Reisemedizin e. V. (DFR) (online)
Leitung: Dr. Rosemarie Mazzola, Freiburg; Prof. Dr. Winfried Kern, Freiburg
Die Reisemedizin versteht sich heute als fachgebietsübergreifende Disziplin. Eine umfassende Darstellung der vielseitigen Aspekte der Reisemedizin ist mit dem Basiszertifikat „Reisemedizinische Gesundheits-Beratung“ allein nicht mehr möglich. Daher hat die Deutsche Fachgesellschaft Reisemedizin (DFR) unter Berücksichtigung der Stellungnahmen internationaler Institutionen (WHO, ISTM) einen Kanon von Themen und Kenntnissen zusammengestellt, der „Reisemedizin“ nach heutigem Verständnis repräsentiert.
Diese Konzeption ist in ein 128 Stunden umfassendes Curriculum eingeflossen als „Fachzertifikat Reisemedizin“. Nach dem Erwerb des Basiszertifikates (32 Stunden) sind weitere 13 Aufbaumodule mit nochmals insgesamt 96 Stunden zu absolvieren, die jeweils einen speziellen Schwerpunkt der Reisemedizin zum Thema haben. Zu jedem Modul ist eine Lernerfolgskontrolle erforderlich. Anschließend kann bei der BÄK SB das Fachzertifikat Reisemedizin beantragt werden.
Die folgenden Aufbaumodule werden im Zweijahresrhythmus angeboten:
1: Geomedizinische Länderkunde/Schlangen und Gifttiere
2: Internationaler Tourismus und Reiserecht/Kreuzfahrt/Schifffahrtsmedizin/Praxis der reisemedizinischen Beratung
3: Flugreisemedizin/Klima und Klimabelastungen
4: Trekking und Höhenmedizin/ Haut-/Sonnenschutz
5: Tauchsportmedizin
6: Internationale Arbeitseinsätze/Langzeitaufenthalte
7: Risikogruppen und Reisen
8: Reisen mit chronischer Krankheit, Teil A
9: Reisen mit chronischer Krankheit, Teil B
10: Reisen mit chronischer Krankheit, Teil C
11: Unfälle und Reisemedizinische Assistance
12: Gesundheitsstörungen bei Reise-Rückkehrern
13: Ärztliche Reisebegleitung
14: Flucht und Migration (optional)
Ärzte und Ärztinnen, die sich nur für bestimmte Themen des Fachzertifikats interessieren, können selbstverständlich auch teilnehmen.
Ebenso können Inhaber von Gelbfieberimpfstellen die jährlich geforderten 8 Fortbildungspunkte mit diesen Seminaren erwerben. Eine Reihenfolge der Seminare (Basisseminar und Aufbaumodule) ist NICHT vorgeschrieben.
Termine 2023:
Module 1 und 2: 24./25. November 2023
Modul 13 und 14: 8./9. Dezember 2023
geplante Termine 2024: Module 4 und 11: 19./20. Januar
Module 6 und 12: 7./8. Juni
Module 3 und 5: 5./6. Juli
Module 7 und 8: 22./23. November
Module 9 und 10: 13./14. Dezember Zeit: ganztägig, jeweils Freitag und Samstag
Ort: online
Entgelt: 350,– Euro/Wochenende Fortbildungspunkte: je nach Modul 9 bis 18
Reisemedizin –Flucht und Migration (online)
Leitung: Dr. Rosemarie Mazzola, Freiburg; Prof. Dr. med. Winfried Kern, Freiburg
Die Teilnahme steht allen interessierten Ärztinnen und Ärzten offen.
Zunehmend werden Ärztinnen und Ärzte in Praxis und Klinik mit Flüchtlingen und Migranten konfrontiert und viele unserer Mitbürgerinnen und Mitbürger haben einen Migrationshintergrund. Sie bringen nicht nur Infektionskrankheiten mit, die in unseren Breiten nicht vorkommen. Sie haben auch häufig andere genetische Veranlagungen, die bei der Therapie wie auch bei der reisemedizinischen Beratung und Prophylaxeempfehlungen berücksichtigt werden müssen. Zudem kommen Sie aus einem anderen Kulturkreis, sodass das Wissen um die anderen Umgangsformen, die interkulturelle Kompetenz, auch für Ärztinnen und Ärzte immer wichtiger wird.
Termin:
Freitag, 9. Dezember 2023
Zeit: 9.00 s.t.–17.00 Uhr
Ort: online
Entgelt: 175,– Euro
Fortbildungspunkte: 9
Reisemedizin Refresher-Seminar
Leitung: Dr. Rosemarie Mazzola, Freiburg; Prof. Dr. med. Winfried Kern, Freiburg
Alles ändert sich ständig, so auch die Präsenz der Infektionserreger und die Empfehlungen in der Reisemedizin.
Besucher dieses Kurses erhalten einen Überblick über neue Entwicklungen auf dem Gebiet der Reisemedizin. So wird die aktuelle Weltseuchenlage vorgestellt und auf Änderungen bei den Empfehlungen zur Malariaprophylaxe und zur Impfprävention hingewiesen. Die Dozenten besprechen, auch anhand von Kasuistiken, interessante reiseund tropenmedizinische Themen. Darüber hinaus haben die Teilnehmer die Möglichkeit, eigene Fallbeispiele einzubringen und mit den Referenten und Kollegen zu diskutieren.
Dieses Refresher-Seminar wird von der Bezirksärztekammer Südbaden für die Verlängerung der Basiszertifikate und anteilig für die Verlängerung des Fachzertifikats anerkannt.
ÄBW 07 | 2023 483 Bekanntmachungen
Ebenso wird das Refresherseminar für die Verlängerung der Ermächtigung zur Gelbfieberimpfung anerkannt.
Seminarinhalt: – Aktuelle Weltseuchenlage
Aktuelle Malariasituation und -empfehlungen
Aktuelle Impfempfehlungen und neue Impfstoffe Weitere Themen werden ca. 4 Wochen vor Beginn veröffentlicht.
Termin:
Samstag, 16. März 2024 Zeit: 9.00 s.t.–18.45 Uhr
Ort: Haus der Ärzte, Sundgauallee 27, Freiburg
Entgelt: 150,– Euro Fortbildungspunkte: 13
Weiterbildungsseminar
Spezielle Schmerztherapie, 80 Std.
gemäß Curriculum der Bundesärztekammer
Leitung: Dr. med. Kristin Kieselbach, Univ.-Klinikum Freiburg, Interdisziplinäres Schmerzzentrum Die Zusatzweiterbildung „Spezielle Schmerztherapie“ umfasst in Ergänzung zu einer Facharztkompetenz die Erkennung und Behandlung chronisch schmerzkranker Patienten, bei denen der Schmerz seine Leit- und Warnfunktion verloren und einen selbstständigen Krankheitswert erlangt hat.
Zum Erwerb der Zusatzbezeichnung ist neben der Absolvierung einer Weiterbildungszeit von 12 Monaten bei einem Weiterbildungsbefugten gem. § 5 Abs. 1 der Besuch eines 80-stündigen Weiterbildungskurses erforderlich.
Der Gesamtkurs kann auch als Genehmigungsvoraussetzung zur Abrechnung von Leistungen i. R. der Qualitätssicherungsvereinbarung Akupunktur der KV Baden-Württemberg dienen.
Kursinhalte:
Block A: Grundwissen über Pathogenese, Diagnostik und Therapie von chronischen Schmerzen, Psychische Störun-
gen mit Leitsymptom Schmerz und psychosomatische Wechselwirkungen bei chronischen Schmerzzuständen
Block B: Medikamentöse Schmerztherapie/Neuropathische Schmerzen, Interventionelle und andere nicht-medikamentöse Verfahren in der Schmerztherapie – Kopfschmerz
Block C: Schmerzen bei vaskulären und viszeralen Erkrankungen, Schmerzen im Alter und bei Kindern und Jugendlichen, Tumorschmerz und Palliativmedizin
Block D: Muskuloskelettale Schmerzen, Rückenschmerz, Schulter-Nackenschmerz, Muskelschmerz, weit verbreitete Schmerzen (widespread pain), Fibromyalgie, Gelenkerkrankungen Die Blöcke sind einzeln buchbar.
Termine:
Block A und B:
17.–21. Juli 2023
Block C und D:
18.–22. September 2023
Zeit: Montag–Freitag, 9.00 s.t.–ca. 16.30 Uhr
Ort: Haus der Ärzte, Sundgauallee 27, Freiburg, ggf. online
Entgelt: 1.000,– Euro Fortbildungspunkte: 80
Suchtmedizin
Kursweiterbildung zur Erlangung der Zusatzbezeichnung
Suchtmedizinische Grundversorgung gem. WBO 2020
Leitung: Dr. Rüdiger Gellert, Freiburg, Dr. Friedemann Hagenbuch, Zentrum f. Psychiatrie
Emmendingen und Dr. Andreas
Jähne, Rhein-Jura Klinik
Bad Säckingen
Abhängigkeitserkrankungen begegnen beinahe täglich jeder Ärztin, jedem Arzt, ob in der Praxis oder im Krankenhaus tätig. Besonders der Substanzmissbrauch von Alkohol, Nikotin, stimulierenden Substanzen und auch Medikamenten bei Jugendlichen stellt eine Herausforderung für die Ärzteschaft dar. Suchtmedizin ist eine Querschnittsaufgabe für alle Fachgebiete, und sie ist keineswegs auf
Drogenabhängige beschränkt. Die Fähigkeit zum Erkennen einer möglichen Abhängigkeitserkrankung bzw. Gefährdung – sei es nun durch Alkohol, Medikamente oder Drogen – gehört zum notwendigen Rüstzeug aller Ärztinnen und Ärzte.
In der aktuellen Weiterbildungsordnung ist die Suchtmedizin als Zusatzweiterbildung geführt. Diese beinhaltet eine 50-stündige Kursweiterbildung sowie eine abschließende Prüfung.
Ärzte, die nach der Kursweiterbildung substituieren, können bei der Kassenärztlichen Vereinigung einen Antrag auf Erstattung des Teilnahmeentgeltes stellen.
Termine:
9.–13. Oktober 2023
26. Februar–1. März 2024
21.–25. Oktober 2024
Zeit: Montag–Freitag, 9.00 s.t.–18.00 Uhr
Ort: i. d. R. Haus der Ärzte, Sundgauallee 27, Freiburg
Entgelt: 800,– Euro Fortbildungspunkte: 50
Suchtmedizin – Sucht Update
Leitung: Dr. Rüdiger Gellert, Freiburg, Dr. Friedemann Hagenbuch, Zentrum f. Psychiatrie Emmendingen und PD Dr. Andreas Jähne, Rhein-Jura Klinik Bad Säckingen Aktuelle Aspekte der Suchtmedizin Um alle Inhaber dieses Zusatztitels sowie besonders am Thema Suchtmedizin interessierte Kolleginnen und Kollegen stets über aktuelle Entwicklungen auf diesem Fachgebiet zu informieren, bieten wir wieder ein Sucht Update an.
In prägnanten Kurzreferaten werden suchtmedizinische Themen mit viel Raum für Diskussion und Austausch dargestellt. Die Referenten arbeiten größtenteils in „badischen“ Einrichtungen, sodass auch Fragen der lokalen Kooperation thematisiert werden können. Zielgruppe der Veranstaltung sind neben Ärztinnen und Ärzten alle anderen Berufsgruppen, die sich im stationären
oder ambulanten Behandlungskontext mit Suchtfragen beschäftigen.
Termin:
Mittwoch, 15. November 2023 Zeit: 15.00 s.t.–18.15 Uhr
Ort: Haus der Ärzte, Sundgauallee 27, Freiburg Entgelt: kostenfrei, Anmeldung erforderlich
Fortbildungspunkte: 4
Suchtmedizinische Versorgung –Fortbildung für Nichtärztliche Medizinische Fachberufe (online)
Leitung: Dr. med. Paula HezlerRusch, Präsidentin der Bezirksärztekammer Südbaden 7 Prozent der erwachsenen Bevölkerung in Deutschland betreiben einen Alkoholmissbrauch oder sind alkoholabhängig. Zirka 3 Millionen gelten als medikamentenabhängig oder zumindest abhängigkeitsgefährdet. 600.000 Menschen sind abhängig von illegalen Drogen, konsumieren oder missbrauchen sie, davon sind 150.000 bis 180.000 opiatabhängig.
2015 hat die Bundesärztekammer in Zusammenarbeit mit der Deutschen Gesellschaft für Suchtmedizin ein Fortbildungscurriculum für die suchtmedizinische Versorgung erstellt. Der Verband der medizinischen Fachberufe war beteiligt.
Das Curriculum umfasst 60 Stunden. Die Inhalte sind auf den Wahlteil der Fachwirtin für ambulante Versorgung anrechenbar. Die Fortbildung wird von der Akademie für ärztliche Fort- und Weiterbildung der Bezirksärztekammer Südbaden in Zusammenarbeit mit der Bezirksärztekammer Nordwürttemberg angeboten.
4 der 60 Stunden sind über eine Hausarbeit abzuleisten, die dann Grundlage eines abschließenden Kolloquiums ist.
Zielgruppe:
Medizinische Fachangestellte, Mitarbeitende in Kliniken, Rehabilitationseinrichtungen, Justiz, Praxen, Ambulanzen, im öffentlichen Gesundheitsdienst und in Suchtberatungsstellen.
484 ÄBW 07 | 2023
Bekanntmachungen
–
–
Termine:
4 mal Freitag und Samstag 2025 (geplant)
Zeit: jeweils 9.00 s.t.–16.30 Uhr
Ort: online
Entgelt: 600,– Euro
Train the Trainer
KWBW-Modul (online)
Leitung: Dr. med. Martina Bischoff, KWBW Verbundweiterbildung plus, Freiburg Dieses Seminar ist ein Angebot an alle Fachärztinnen und Fachärzte, die Ärzte in Weiterbildung zum Facharzt für Allgemeinmedizin anleiten. Sie bekommen
Hinweise zu den Besonderheiten der ambulanten Weiterbildung mit der neuen kompetenzbasierten Weiterbildungsordnung.
Kursinhalte:

– Einführung in das Thema WB

Allgemeinmedizin, Erfahrungsaustausch als WBB
– Besonderheiten in der ambulanten WB Allgemeinmedizin
Gemeinsam Weiterbilden in der KWBW Verbundweiterbildung plus
– Weiterbilden im KWBW – Förderung, Anträge, P1-Pauschale, Online-Netzwerke
Struktur der Weiterbildung in der täglichen Praxis
Termin:
Diese Veranstaltung wird 2023 von der Bezirksärztekammer Nordbaden durchgeführt, siehe www.baek-nb.de/akademie.
Auskunft:
Information und Anmeldung: www.baek-sb.de/akademie Akademie für Ärztliche Fortund Weiterbildung Südbaden, Sundgauallee 27, 79114 Freiburg, Telefon (07 61) 6 00-4751/4752/4753, Fax (07 61) 6 00-4757,
E-Mail: akademie@baek-sb.de Bei Rückfragen stehen wir Ihnen gerne zur Verfügung. Änderungen bleiben vorbehalten.
Bezirksärztekammer
Südwürttemberg
Geschäftsstelle: Haldenhaustraße 11
Kurse der Bezirksärztekammer Südwürttemberg
Rhetorik-Seminar: Diskutieren und Argumentieren
Gespräche und Verhandlungen sind Teil des ärztlichen Alltags, sei es in Teamsitzungen, bei Mitarbeitergesprächen oder wichtigen Vertragsverhandlungen. Und auch in Diskussionen und Debatten sollten Sie ihren Standpunkt vertreten und erklären können. In dem Seminar lernen Sie grundlegende Mechanismen der Dialogrhetorik kennen. Sie üben selbstsicher aufzutreten und Ihren eigenen Standpunkt glaubwürdig und überzeugend darzustellen.
Als Teilnehmer und Teilnehmerin dieses Seminars erfahren und üben Sie, wie Sie sich auf eine Diskussion oder Verhandlung vorbereiten, wie Sie anschaulich und überzeugend argumentieren und wie Sie Ihren Standpunkt selbstbewusst vertreten. Dabei verbinden sich praktische Gesprächs- und Verhandlungsszenarien mit Videoanalysen und individuellem Feedback sowie praxisgerechten Einblicken in aktuelle Erkenntnisse der Rhetorik und Kommunikationswissenschaft.
Termin:
Samstag, 22. Juli 2023 9.00–17.00 Uhr (Anmeldungs-Nr. 34/2023)
Leitung: Prof. Dr. Olaf Kramer, Professor für Rhetorik und Wissenskommunikation, Universität Tübingen
Seminarinhalt:
• Eine Argumentation logisch aufbauen
• Sich verständlich ausdrücken
• Die richtigen Fragen stellen
• Aktiv zuhören
• Fair argumentieren
• Unfaire Argumente abwehren
• Positiv formulieren
• Passende Körpersignale senden
• Mit Diskussionspartnern respektvoll umgehen
Ort: Ärztehaus, Haldenhaustr. 11, 72770 Reutlingen
Gebühr: 120,– Euro Punkte: 11
Anmeldung: :
Impfseminar
Impfungen gehören zu den wichtigsten und effektivsten Präventionsmaßnahmen in der Medizin. Sie haben wesentlich zur Erhöhung der Lebenserwartung durch das Zurückdrängen gefährlicher Infektionskrankheiten beigetragen. Und dennoch bedarf es nach wie vor vieler Bemühungen, um bestehende Impflücken zu schließen und alle Patientinnen und Patienten davon zu überzeugen, dass empfohlene Impfungen die beste und effizienteste Möglichkeit bieten, sich vor Erkrankungen zu schützen. Dabei tragen die impfenden Ärztinnen und Ärzte eine besondere Verantwortung.
Dieses Impfseminar, das sich am Impf-Curriculum der Bundesärztekammer ausrichtet, soll Sie dabei unterstützen, beim Thema Impfen auf dem Laufenden zu bleiben. In diesem Seminar:
• vertiefen Sie Ihr Fachwissen zu den Eckpfeilern und Rahmenbedingungen des Impfens
• werden Sie auf den neuesten Stand von Empfehlungen und Entwicklungen gebracht
• setzen Sie sich mit Impfungen von speziellen Personengruppen auseinander
• erwerben Sie aktuelle Informationen zu Impfstoffen und Impfempfehlungen
• werden Sie zu den Verordnungs- und Abrechnungsmodalitäten informiert
Das Seminar soll aber nicht nur der reinen Informationsvermittlung dienen. Es soll auch genügend Raum zum fachlichen Austausch und zur Beantwortung von Fragen bieten.
! Dieses Seminar ist vom Landesgesundheitsamt Baden-Württemberg für die Fortgeltung erteilter Ermächtigungen zur Gelbfieberimpfung anerkannt.
Termin:
Samstag, 16. September 2023 9.00–16.30 Uhr (Anmeldungs-Nr. 25/2023)
Leitung: Dr. med. Sophia Blankenhorn, Präsidentin der Bezirksärztekammer Südwürttemberg
Ort: Ärztehaus, Haldenhaustr. 11, 72770 Reutlingen
Gebühr: 80,– Euro
Punkte: 8
Anmeldung::
Qualifikation Tabakentwöhnung –Grundkurs
Der Grundkurs zur „Qualifikation Tabakentwöhnung“ besteht aus 20 Unterrichtseinheiten (UE) und vermittelt den Teilnehmenden umfassendes Faktenwissen zum Thema Tabaksucht und -entwöhnung. In allen Phasen des Kurses werden die Teilnehmenden tutoriell begleitet.
Lerninhalte des Grundkurses
• Das Tabakproblem im gesellschaftlichen Kontext, Strategien der Tabakkontrollpolitik und ärztliche Interventionsmöglichkeiten
• Gesundheitliche Folgen des Tabakkonsums und des Rauchstopps
• Grundlagen der Tabakabhängigkeit und allgemeine Diagnostik
• Methoden der Tabakentwöhnung – Medikamentöse Strategien
• Methoden der Tabakentwöhnung – Niederschwellige Verfahren
• Patientenansprache, Diagnostik und Intervention bei verschiedenen Zielgruppen
• Übungen zur Motivierenden Gesprächsführung
ÄBW 07 | 2023 485 Bekanntmachungen
72770 Reutlingen Tel. (0 71 21) 9 17-24 15/-24 16 Fax (0 71 21) 9 17-24 00
–
–
• Methoden der Tabakentwöhnung – Psychotherapeutische Strategien
• Implementierung der Tabakentwöhnung am ärztlichen Arbeitsplatz
Die Teilnahme am Grundkurs befähigt zur Einzeltherapie.
Termine:
Freitag, 15. September 2023
9.00–16.30 Uhr
Samstag, 16. September 2023
9.00–16.30 Uhr
Sonntag, 17. September 2023
9.00–12.00 Uhr (Anmeldungs-Nr. 31/2023)
Leitung: Prof. Dr. med. Anil Batra, Stellv. Ärztlicher Direktor, Leiter der Sektion Suchtmedizin und Suchtforschung, Universitätsklinik für Psychiatrie und Psychotherapie, Tübingen
Ort: Ärztehaus, Haldenhaustr. 11, 72770 Reutlingen
Gebühr: 350,– Euro
Punkte: 20
Anmeldung::
Qualifikation Tabakentwöhnung –
Aufbaukurs
Der fakultative Aufbaukurs, der 8 Unterrichtseinheiten (UE) umfasst, basiert auf anerkannten Programmen zur Tabakentwöhnung (nach § 20 SGBV)
Zu den Lerninhalten des Aufbaukurses gehören:
• Konzeption und Organisation
eines strukturierten Programms (Stundenaufbau mit Zielen, Methoden und Inhalten)
• Ablauf und Wirkungsweise von Gruppenprozessen
• Anleitung und Moderation einer Gruppe
• Förderung der Motivation und Aktivität
• Umgang mit schwierigen Gruppensituationen
! Voraussetzung für die Teilnahme am Aufbaukurs ist die erfolgreiche Teilnahme am Grundkurs zur „Qualifikation Tabakentwöhnung“.
! Die Teilnahme am Aufbaukurs befähigt zur Durchführung von Tabakentwöhnungsprogrammen im Gruppensetting.
Termin:
Samstag, 30. September 2023
9.00–16.30 Uhr (Anmeldungs-Nr. 32/2023)
Leitung: Prof. Dr. med. Anil Batra, Stellv. Ärztlicher Direktor, Leiter der Sektion Suchtmedizin und Suchtforschung, Universitätsklinik für Psychiatrie und Psychotherapie, Tübingen
Christina Zeep, Diplom-Psychologin, Mitarbeiterin der Sektion für Suchtmedizin und Suchtforschung, Universitätsklinik für Psychiatrie und Psychotherapie, Tübingen
Ort: Ärztehaus, Haldenhaustr. 11, 72770 Reutlingen
Gebühr: 140,– Euro
Punkte: 8
Anmeldung::
Lerninhalte:
• Grundlagen der Palliativmedizin
• Grundsätze der Behandlung belastender Beschwerden insbesondere Schmerztherapie
• Psycho-Soziale Aspekte der Palliativmedizin und Selbstreflexion
• Rechtliche, ethische und spirituelle Fragestellungen in der Palliativsituation
• Symptomlinderung palliativmedizinischer Krankheitsbilder
Termin: 21.–25. September 2023 (Do–Mo) (Anmeldungs-Nr. 6/2023)
Leitung: Dr. med. Christina Paul, Tropenklinik Paul-Lechler-Krankenhaus, Oberärztin Palliativstation, Ärztliche Leiterin Tübinger Projekt Häusliche Betreuung Schwerkranker
Ort: Hotel Fortuna, Carl-ZeissStraße 75, 72770 Reutlingen
Gebühr: 700,– Euro
Punkte: 40
Anmeldung::
40-Stunden-Kurs „Palliativmedizin“ nach der Weiterbildungsordnung
Im Grundkurs, der 40 Unterrichtseinheiten (UE) umfasst, stärken die Kursteilnehmer und -teilnehmerinnen ihre ganzheitliche Sicht auf die Patienten. Sie üben sich in der palliativen Grundhaltung, die neben körperlichen Symptomen und Einschränkungen bei schwerkranken Menschen vor allem auch psychosoziale, spirituelle und ethische Aspekte berücksichtigt.
Sie werden dafür sensibilisiert, dass palliativmedizinische Betreuung nicht als Krisenintervention, sondern als ein länger andauernder Prozess, in dem vorausschauende Behandlungsplanungen und Begleitung von großer Bedeutung sind, verstanden werden muss.
Das Erlernen der Techniken der personen- und anlassbezogenen Gesprächsführung, von unterschiedlichen Beratungs- und Kommunikationsmethoden sowie Bewältigungs- und Anpassungsstrategien stehen außerdem auf dem Programm.
Fallseminare Palliativmedizin
In der Palliativmedizin geht es um die ganzheitliche Behandlung von Menschen mit einer unheilbaren, fortschreitenden Erkrankung und begrenzter Lebenserwar tung. Mit der Weiterbildungsordnung 2006 der Landesärztekammer Baden-Württemberg wurde die Zusatzbezeichnung „Palliativmedizin“ eingeführt. Zu ihrem Erwerb ist u. a. das Absolvieren eines Grundkurses (40 Unterrichtseinheiten) sowie eine 12monatige stationäre Tätigkeit bei einem Weiterbildungsbefugten oder 120 Unterrichtseinheiten (UE) im Rahmen von Fallseminaren inkl. Supervision erforderlich. Für Ärzte, die sich für den Besuch von Fallseminaren entschieden haben, werden die dafür notwendigen Module I bis III mit jeweils 40 UE angeboten. Diese Module sind nach dem Curriculum
der Bundesärztekammer und den Empfehlungen der Deutschen Gesellschaft für Palliativmedizin
e. V. strukturiert.
Modul I (40 UE):
Der schwerkranke, sterbende Patient, sein soziales Umfeld und das behandelnde Team
• Kommunikation, psychosoziale Aspekte, soziales Umfeld, Symptomkontrolle
Modul II (40 UE):
Der individuelle Prozess des Sterbens im gesellschaftlichen Kontext
• Ethik, Trauer, Symptomkontrolle Modul III (40 UE):
Professionelles Handeln in der Palliativmedizin
• Bearbeitung komplexer Fragestellungen aus dem palliativmedizinischen Arbeitsfeld anhand von Fallbeispielen
Termine:
Modul I:
2.–5. März 2024 (Sa–Di)
Modul II:
6.–9. März 2024 (Mi–Sa) (Anmeldungsnummer 2/2024)
Gebühr Module I und II: 700,– Euro je Modul Modul III:
24.–27. April 2024 (Mi–Sa) (Anmeldungsnummer 3/2024)
Gebühr Modul III: 700,– Euro
Leitung: Dr. med. Christina Paul, Tropenklinik Paul-Lechler-Krankenhaus, Oberärztin Palliativstation, Ärztliche Leiterin Tübinger
Projekt Häusliche Betreuung
Schwerkranker
Ort: Ärztehaus, Haldenhaustr. 11, 72770 Reutlingen
Punkte: je Modul 40
Anmeldung::
Suchtmedizinische Grundversorgung
Seminar zum Erwerb der Zusatzbezeichnung Suchtmedizin (50 h) gemäß (Muster-) Kursbuch Suchtmedizinische Grundversorgung der Weiterbildungsordnung der Landesärztekammer BadenWürttemberg (WBO 2020)
486 ÄBW 07 | 2023 Bekanntmachungen
Die Zusatzweiterbildung Suchtmedizinische Grundversorgung umfasst in Ergänzung zu einer Facharztkompetenz die Vorbeugung, Erkennung, Behandlung und Rehabilitation von Krankheitsbildern im Zusammenhang mit dem schädlichen Gebrauch suchterzeugender Stoffe und nicht-stoffgebundener Suchterkrankungen. Die Themenschwerpunkte umfassen:
• Ätiologie von Suchtkrankheiten und deren Vorbeugung, Erkennung, Behandlung und Rehabilitation
• Pharmakologie suchterzeugender Stoffe:
– Entzugs- und Substitutionsbehandlung
– Kriseninterventionen
– Erkennung psychiatrischer und somatischer Erkrankungen im Zusammenhang mit Suchterkrankungen und Indikationsstellung zur weiterführenden Behandlung Neben den genannten Theorieinhalten werden Schwerpunkte in der Praxisarbeit, motivierenden Gesprächsführung, auf dem Erwerb von Fertigkeiten in der Motivationsbehandlung sowie in Themenbereichen wie nichtstoffgebundene Abhängigkeiten und Tabakabhängigkeit vermittelt. Zielgruppe sind alle Fachärzte im ambulanten und stationären Bereich sowie Weiterbildungsassistenten mit Interessensgebieten im Bereich der Suchtmedizin. Voraussetzungen zum Erwerb der Zusatzbezeichnung Suchtmedizinische Grundversorgung in Baden-Württemberg sind:
• Facharztanerkennung
• 50 Stunden Kurs-Weiterbildung
• Abschließende Prüfung bei der Ärztekammer
• Termin: 25.–29. September 2023 (Mo–Fr) (Anmeldungs-Nr. 30/2023)
Leitung: Prof. Dr. med. Anil Batra, stellv. Ärztlicher Direktor, Universitätsklinik für Psychiatrie und Psychotherapie, Tübingen
Ort: Universitätsklinik für Psychiatrie und Psychotherapie, Calwer Str. 14, 72076 Tübingen
Gebühr: 875,– Euro (inkl. Skripten und Verpflegung)
Punkte: 50
Anmeldung::
EKG-Basisseminar
In diesem Seminar werden die Grundlagen der EKG-Befundung vermittelt, mögliche Störfaktoren bei der EKG-Ableitung besprochen und die typischen Veränderungen bei häufigen Herzerkrankungen dargestellt. Anschließend können die Teilnehmer in kleinen Gruppen an Fallbeispielen selbst EKGs auswerten und die Ergebnisse werden im Plenum diskutiert. Am Nachmittag steht die Rolle des EKGs in der Praxis im Mittelpunkt und es werden an Kasuistiken EKG-Bilder bei chronischen Herzerkrankungen und bei Notfällen vorgestellt.
Termin:
Samstag, 30. September 2023 9.00–16.50 Uhr (Anmeldungs-Nr. 24/2023)
Ort: Ärztehaus, Haldenhaustr. 11, 72770 Reutlingen
Gebühr: 80,– Euro
Punkte: 11
Anmeldung:: Baustein Psychotherapie (Verhaltenstherapie) im Facharzt für Psychiatrie und Psychotherapie – Kurs II
Die Bezirksärztekammer Südwürttemberg führt in Zusammenarbeit mit der Universitätsklinik für Psychiatrie und Psychotherapie die Kurse für den Erwerb des Facharztes für Psychiatrie und Psychotherapie sowie für die Zusatzbezeichnung Psychotherapie durch.
Gemäß den Richtlinien der Landesärztekammern sind dafür theoretische und praktische Bausteine erforderlich. Dazu werden drei
Blockkurse mit je 50 Stunden angeboten, welche – thematisch aufeinander aufbauend – im Abstand von einem Jahr durchgeführt werden. Die Fort- und Weiterbildungswochen sind also so aufgebaut, dass die Teilnehmenden die Möglichkeit erhalten, innerhalb von 3 Jahren die psychotherapeutische Weiterbildung komplett abzuschließen.
Die Kurse werden jedes Jahr an drei verschiedenen Standorten durchgeführt, sodass in jedem Jahr alle Kursteile entweder in Hornberg (Schwarzwald), Bamberg oder auf Borkum angeboten werden. Die einzelnen Module umfassen Theoriekurse, Entspannungsverfahren, Selbsterfahrung und Fallsupervision und decken damit wichtige Inhalte entsprechend den Anforderungen der Richtlinien der Landesärztekammer Baden-Württemberg ab.
Termin:
1.–7. Oktober 2023 (So–Sa) (Anmeldungs-Nr. 27/2023)
Leitung: Prof. Dr. med. Anil Batra, stellv. Ärztlicher Direktor, Universitätsklinik für Psychiatrie und Psychotherapie, Tübingen
Ort: Hotel Schloss Hornberg, Auf dem Schlossberg 1, 78132 Hornberg
Gebühr: 875,– Euro (Kosten für Unterkunft und Verpflegung sind in der Kursgebühr nicht enthalten.)
Punkte: 63
Anmeldung: :
betroffen – Tendenz steigend. Die Ursachen dieser Beschwerden sind sehr vielfältig. Man unterscheidet über 300 voneinander abgrenzbare Krankheitsbilder mit unterschiedlichen Ursachen und Verläufen. Dazu gehören u. a. degenerative Erkrankungen des Bewegungssystems, entzündlich rheumatische Erkrankungen sowie auch Stoffwechselerkrankungen. Diese Krankheitsbilder führen meist zu chronischen Schmerzen und Funktionseinschränkungen und beeinträchtigen wesentlich die Lebensqualität. Mit diesem Seminar möchten (und können) wir nicht alle Details der Erkrankungen und des rheumatischen Formenkreises erörtern. Ziel ist es, Ihnen einen praxisnahen Überblick über die häufigsten rheumatischen Erkrankungen zu geben, um so die häufigsten entzündlich-rheumatischen Erkrankungen im Praxisalltag sicherer erkennen und gezielt behandeln zu können – und das in enger Zusammenarbeit von Hausärztinnen/Hausärzten, Rheumatologen und anderen Fachärztinnen und -ärzten.
Termin:
Samstag, 14. Oktober 2023 9.00–14.15 Uhr (Anmeldungs-Nr. 18/2023)
Leitung: Dr. med. Sophia Blankenhorn, Präsidentin der Bezirksärztekammer Südwürttemberg
Gebühr: 60,– Euro Punkte: 6
Anmeldung::
Seminarreihe Allgemeinmedizin: Rheuma: Erkrankung mit vielen Gesichtern – Web-Seminar
Schmerzhafte Erkrankungen des Bewegungsapparates (an Wirbelsäule, Gelenken, Knochen, Muskeln, Sehnen und Bändern) werden umgangssprachlich als Rheuma bezeichnet. Jüngsten Schätzungen zufolge sind 1,5 bis 2,1 Millionen Erwachsene von einem der vielen Krankheitsbilder
Vorbereitung Fachgespräch Allgemeinmedizin & Pädiatrie
Die Facharztanerkennung ist ein wichtiger Schritt im ärztlichen Werdegang. Sie ist das Ende eines oft langen Weges in der ärztlichen Weiterbildung, und viele von Ihnen möchten sich auf die dazu gehörige mündliche Prüfung optimal vorbereiten.
Dieses Seminar richtet sich daher an Ärztinnen und Ärzte in fort-
ÄBW 07 | 2023 487 Bekanntmachungen
geschrittener Weiterbildung in der Allgemeinmedizin oder in der Kinder- und Jugendmedizin. Es dient nicht dazu, Wissenslücken zu schließen, sondern soll Ihnen die organisatorischen Abläufe erläutern und es Ihnen erlauben, sich in realistischen Prüfungssimulationen auf die FacharztPrüfung vorzubereiten. In diesem Seminar wird zunächst allen Teilnehmenden der formale Ablauf eines solchen Fachgespräches vorgestellt und an einem Fallbeispiel ausführlich und prüfungsnah demonstriert. Nach dem gemeinsamen allgemeinen Teil werden die Teilnehmenden in die beiden Fachgruppen (Allgemeinmedizin oder Pädiatrie) aufgeteilt. Dort werden unter der Leitung von erfahrenen Prüfern des jeweiligen Faches in kleinen Gruppen fachspezifische Kasuistiken vorgestellt und bearbeitet. Es werden unter aktiver Beteiligung der Teilnehmenden Fachgespräche simuliert und gemeinsam reflektiert. Hilfreiche Tipps aus der Sicht der Prüfenden runden den Abend ab.
Das Seminar zur Vorbereitung auf das Fachgespräch Allgemeinmedizin hat sich in den letzten Jahren immer einer großen Beliebtheit erfreut, und wir haben uns nun entschlossen, es auch für die Pädiatrie anzubieten. Wir freuen uns auf eine interessante und intensive Veranstaltung in kleinen Gruppen und auf Ihre Teilnahme!
Termin:
Freitag, 27. Oktober 2023
17.00–21.30 Uhr
(Anmeldungs-Nr. 44/2023, 45/2023)
Leitung: Dr. med. Dipl.-Phys.
Manfred Eissler, Facharzt für Allgemeinmedizin, Reutlingen
Ort: Ärztehaus, Haldenhaustr. 11, 72770 Reutlingen
Gebühr: 150,– Euro
Punkte: 7
Anmeldung::
Refresher Palliativmedizin „Orchideenfälle“ in der Palliativmedizin
Zielgruppe dieses Seminars sind Ärztinnen und Ärzte, die bereits die Kurs-Weiterbildung Palliativmedizin (Grundkurs, 40 UE) absolviert haben, sowie palliativmedizinisch Interessierte aller Fachrichtungen.
Ziel des Seminars ist es,
• Sie auf den aktuellen medizinischen und pflegerischen Stand in ausgewählten Themen der Palliativmedizin zu bringen
• einen eigenen Fall, der Sie umtreibt, in geschütztem Rahmen unter Supervision für sich zu klären
• Ihnen die Gelegenheit zu geben, in kleinen Gruppen die Fragen und Probleme des Arbeitsalltags fallorientiert und praxisnah zu diskutieren
• sich mit Kollegen auszutauschen und Ihnen neue positive Impulse für die tägliche Arbeit zu geben
• einen geschützten Rahmen für die Reflexion des eigenen Arbeitsalltags zu bieten
Termin:
Samstag, 28. Oktober 2023 9.00–16.30 Uhr (Anmeldungs-Nr. 10/2023)
Leitung: Dr. med. Christina Paul, Tropenklinik Paul Lechler Krankenhaus, Oberärztin Palliativstation, Ärztl. Leiterin Tübinger Projekt Häusliche Betreuung Schwerkranker
Ort: Ärztehaus, Haldenhaustr. 11, 72770 Reutlingen
Gebühr: 150,– Euro
Punkte: 8
Die Seminarteilnahme kann als Nachweis zur palliativmedizinischen Fortbildung für die Abrechnung von Leistungen der Allgemeinen Ambulanten Palliativversorgung (AAPV) gem. Vereinbarung zwischen dem GKVSpitzenverband und der Kassenärztlichen Bundesvereinigung nach § 87 Abs. 1b SGB V zur besonders qualifizierten und koordinierten palliativmedizinischen Versorgung vom 29. 11. 2016 verwendet werden.
Die Veranstaltung wird als Fortbildung ebenfalls im Rahmen der „Onkologie-Vereinbarung“ vom 01. 10. 2021 (gem. § 7) von der KV BW anerkannt.
Anmeldung:: Self Care matters
Selbstfürsorge und Burnout –Prävention im medizinischen Alltag –Web-Seminar
Gespräche und Verhandlungen sind Teil des ärztlichen Alltags, sei es in Teamsitzungen, bei Mitarbeitergesprächen oder wichtigen Vertragsverhandlungen. Und auch in Diskussionen und Debatten sollten Sie ihren Standpunkt vertreten und erklären können. In dem Seminar lernen Sie grundlegende Mechanismen der Dialogrhetorik kennen. Sie üben selbstsicher aufzutreten und Ihren eigenen Standpunkt glaubwürdig und überzeugend darzustellen. Als Teilnehmer und Teilnehmerin dieses Seminars erfahren und üben Sie, wie Sie sich auf eine Diskussion oder Verhandlung vorbereiten, wie Sie anschaulich und überzeugend argumentieren und wie Sie Ihren Standpunkt selbstbewusst vertreten. Dabei verbinden sich praktische Gesprächs- und Verhandlungsszenarien mit Videoanalysen und individuellem Feedback sowie praxisgerechten Einblicken in aktuelle Erkenntnisse der Rhetorik und Kommunikationswissenschaft.
Termin:
Samstag, 18. November 2023 9.00–12.30 Uhr (Anmeldungs-Nr. 67/2023)
Leitung: Dr. Beate Harder, Fortbildungsbeauftragte Bezirksärztekammer Südwürttemberg
Gebühr: 40,– Euro
Punkte: 4
Anmeldung::
Blitzlicht: Online-Seminarreihe zu aktuellen Themen in der Medizin
Manche Themen in der Medizin werden plötzlich aktuell und/ oder gewinnen an Bedeutung. In dieser neuen Seminarreihe, wollen wir uns genau solchen „Blitzlicht-Themen“ widmen.
Dazu bitten wir ausgewiesene Expertinnen und Experten, ein aktuelles Thema gezielt zu beleuchten, und laden Sie anschließend zu kollegialem Austausch und reger Diskussion ein. Diese Seminarreihe ist bewusst im Online-Format angelegt, um Ihnen so die Möglichkeit zu geben, sie gut in Ihren Arbeitsalltag zu integrieren.
Das PostCOVID Syndrom bei Kindern und Jugendlichen
In diesem Blitzlicht-Seminar wollen wir den Fokus auf das Krankheitsbild PostCOVID bei Kindern und Jugendlichen richten. Mit Frau Prof. Dr. Behrens haben wir dafür die Leiterin der Spezialsprechstunde für PostCOVID der Kinderpoliklinik der Technischen Universität München gewinnen können. Sie wird uns aus erster Hand mehr zum Krankheitsbild PostCOVID und die Differentialdiagnose bei Kindern berichten.
Programm:
19.30–20.45 Uhr
Das PostCOVID Syndrom bei Kindern und Jugendlichen Prof. Dr. med. Uta Behrends, Fachärztin für Kinder- und Jugendmedizin, Schwerpunkt KinderHämatologie und -Onkologie, Klinik für Kinder- und Jugendmedizin, Klinikum rechts der Isar der TU München
20.45–21.00 Uhr Austausch und Diskussion
Termin:
Donnerstag, 23. November 2023
19.30–21.00 Uhr
(Anmeldungs-Nr. 65/2023)
Leitung: Dr. med. Sophia Blankenhorn, Präsidentin der Bezirksärztekammer Südwürttemberg
Gebühr: keine
Punkte: 2
Anmeldung::
488 ÄBW 07 | 2023 Bekanntmachungen
Stressbewältigung durch Achtsamkeit
Die wachsende berufliche Belastung und die unverändert schwierigen Arbeitsbedingungen für Ärztinnen und Ärzte sind unbestritten. Die physischen und psychischen Anforderungen, die durch den Umgang mit kranken und sterbenden Menschen, durch den permanenten Zeitdruck und die ökonomischen Herausforderungen entstehen, führen zu einer zunehmenden Verschärfung der angespannten Situation. Das erfahrungsorientierte Seminar „Stressbewältigung durch Achtsamkeit“ basiert auf dem „Mindfulness-Based Stress Reduction Programm“ (MBSR). Dieses Programm wurde Ende der siebziger Jahre in den USA von Prof. Dr. Jon Kabat-Zinn an der Universitätsklinik von Massachusetts entwickelt. Inzwischen belegen zahlreiche wissenschaftliche Studien die Wirksamkeit dieses Programms.
Grundlage des Seminars ist die intensive Schulung der Achtsamkeit im Alltag und in der Stille. Achtsamkeit bedeutet, die Aufmerksamkeit immer wieder zum gegenwärtigen Moment zurückzubringen.
Durch geleitete Meditationen und sanfte Körperübungen lernen die Teilnehmerinnen und Teilnehmer, Atmung, Körperempfindungen, Gedanken und Gefühle wahrzunehmen ohne sie zu bewerten. Die Praxis der Achtsamkeit befähigt dazu, die gewohnheitsmäßigen Verhaltensweisen im Umgang mit innerem und äußerem Stress, mit Krankheiten und Schwierigkeiten zu erkennen. Die Teilnehmerinnen und Teilnehmer lernen immer wieder innezuhalten und den Herausforderungen des Lebens mit mehr Ruhe, Klarheit und Akzeptanz zu begegnen.
Ziele des Seminars sind:
• Verständnis für die Grundlagen der Achtsamkeitspraxis zu bekommen
• eigene Erfahrungen mit Achtsamkeits-Übungen zu machen
• Anregungen zu erhalten, um Achtsamkeit in den eigenen Alltag bzw. Berufsalltag zu integrieren
• ein Behandlungskonzept kennenzulernen, das auch bei den Patienten zur Anwendung kommen kann
Termin: Samstag, 2. Dezember 2023 9.00–16.45 Uhr (Anmeldungs-Nr. 22/2023)
Leitung: Dr. med. Sophia Blankenhorn, Präsidentin der Bezirksärztekammer Südwürttemberg
Ort: Ärztehaus, Haldenhaustr. 11, 72770 Reutlingen
Gebühr: 200,– Euro inkl. Verpflegung, Skript und Yoga-Matte
Punkte: 10
Anmeldung: :
Psychopathologie kompakt
Ein Arzt führt im Laufe seines Berufslebens ungefähr 200.000 Gespräche und sollte dabei auch immer psychosomatische Aspekte hinsichtlich der Diagnosefindung berücksichtigen.
Wie schwierig es im praktischen Alltag ist, zusätzlich zur medizinischen Anamnese, noch einen adäquaten psychischen Befund zu formulieren, vor allem im Hinblick auf die begrenzte Zeitspanne eines Arzt-Patienten-Gesprächs, kennen Sie nur zu gut. Der starke Anstieg einiger psychischer Krankheiten, nicht zuletzt durch die Corona-Pandemie, hat jedoch zu einem drastischen Umdenken und zur Berücksichtigung von Störungen der Elementarfunktionen (Aufmerksamkeit, Auffassung, Konzentration, Affektivität, Antrieb, Merkfähigkeit/ Gedächtnisstörungen, etc.) geführt, um zielgerichtet psychosomatische und psychiatrische Symptome und somit dahinterstehende Syndrome (Krankheitsbilder) zu erkennen.
So sind z. B. die Fälle von Depressionen und Angststörungen weltweit allein im ersten Pandemie -
jahr um 25 Prozent gestiegen (WHO) – Tendenz weiterhin steigend. Vor allem Depressionen gehören zu den am häufigsten und hinsichtlich ihrer Schwere am meisten unterschätzten Erkrankungen, ebenso hinsichtlich ihrer Suizidrate. Die Mehrheit der Suizide erfolgt vor dem Hintergrund einer zu spät erkannten oder einer unzureichend behandelten Depression. Häufig ist der vertraute Arzt der erste Ansprechpartner für die Diagnose und Behandlung von Depressionen und beschäftigt sich auch mit dem psychischen Befund. Daher sind die geschulte klinische Beobachtung und die sorgfältige Anamneseerhebung von größter Bedeutung.
Dieses Seminar beschäftigt sich mit den beiden Fragestellungen:
• Wie erkenne ich als Medizinerin und Mediziner psychische Störungsbilder im Arztgespräch?
• Welche Rückschlüsse ziehe ich aus auffälligen Verhaltensweisen?
Ferner werden im Seminar
folgende Themen besprochen:
• Einweisung in psychiatrische/ psychotherapeutische/psychosomatische Untersuchungen und Befunderhebungen
• Vorstellung verschiedener psychischer Störungsbilder, mit den Schwerpunkten Depression und Persönlichkeitsstörung
• Entscheidung für ein ambulantes oder stationäres Setting und Auswahl geeigneter Therapiemethoden
Termin:
Samstag, 9. Dezember 2023 9.00–16.15 Uhr (Anmeldungs-Nr. 68/2023)
Leitung: Dr. med. Sophia Blankenhorn, Präsidentin der Bezirksärztekammer Südwürttemberg
Ort: Ärztehaus, Haldenhaustr. 11, 72770 Reutlingen
Gebühr: 120,– Euro
Punkte: 8
Anmeldung: :
Train the Trainer –Web-Seminar
Die Anforderungen an eine gute ärztliche Weiterbildung und damit auch an die Weiterbildungsbefugten in allen Fachgebieten wachsen stetig und sind einem ständigen Wandel unterworfen. Medizinische Exzellenz ist ein wichtiger Baustein für gute Weiterbildung, aber Fachwissen allein macht noch keinen guten Weiterbilder.
Das „Train the Trainer“-Seminar richtet sich an Weiterbilder aller Fachrichtungen und bietet ihnen praxisnahe Informationen und Tipps zur Planung und Durchführung der Weiterbildung.
Im ersten Teil des Seminars werden ausführlich und praxisnah die formalen und rechtlichen Aspekte der im Jahr 2020 in Kraft getretenen Weiterbildungsordnung vermittelt.
Im Fokus des zweiten Teils liegen didaktische Themen. So werden u. a. kompetenzbezogene didaktische und methodische Grundlagen der Weiterbildung oder das systematische lernfördernde Feedback behandelt.
Termin:
Samstag, 9. Dezember 2023 9.00–16.15 Uhr (Anmeldungs-Nr. 38/2023)
Leitung: Dr. Sophia Blankenhorn, Vizepräsidentin der Bezirksärztekammer Südwürttemberg
Gebühr: 80,– Euro
Punkte: 8
Anmeldung::
ÄBW 07 | 2023 489 Bekanntmachungen
Vorankündigung:
Das aktuelle Thema: Kinderschutz –Web-Seminar
Gespräche und Verhandlungen sind Teil des ärztlichen Alltags, sei es in Teamsitzungen, bei Mitarbeitergesprächen oder wichtigen Vertragsverhandlungen. Und auch in Diskussionen und Debatten sollten Sie ihren Standpunkt vertreten und erklären können.
In dem Seminar lernen Sie grundlegende Mechanismen der Dialogrhetorik kennen. Sie üben selbstsicher aufzutreten und Ihren eigenen Standpunkt glaubwürdig und überzeugend darzustellen.
Als Teilnehmer und Teilnehmerin dieses Seminars erfahren und üben Sie, wie Sie sich auf eine Diskussion oder Verhandlung vorbereiten, wie Sie anschaulich und überzeugend argumentieren und wie Sie Ihren Standpunkt selbstbewusst vertreten.
Anzeige
Dabei verbinden sich praktische Gesprächs- und Verhandlungsszenarien mit Videoanalysen und individuellem Feedback sowie praxisgerechten Einblicken in aktuelle Erkenntnisse der Rhetorik und Kommunikationswissenschaft.
Termin: Dienstag, 12. Dezember 2023 19.00–21.30 Uhr (Anmeldungs-Nr. 70/2023)
Leitung: Dr. med. Joachim Suder, Facharzt für Kinder- und Jugendmedizin, Tübingen
Auskunft/Anmeldung: Akademie für Ärztliche Fortbildung bei der Bezirksärztekammer Südwürttemberg, Haldenhaustr. 11, 72770 Reutlingen, Telefon (0 71 21) 9 17-24 15 oder -24 16, E-Mail: fortbildung@baek-sw.de
Impressum
Hinweis:
Die Änderung der Zustelladresse für das ÄBW ist bitte ausschließlich an die zuständige Bezirksärztekammer zu melden.
Weitere Informationen: www.ärzteblatt-bw.de
Kompetenzzentrum Weiterbildung Baden-Württemberg (KWBW)

Im Neuenheimer Feld 130.3 69120 Heidelberg Telefon (0 62 21) 56-71 75 kwbw.AMED@med.uni-heidelberg.de weiterbildung-allgemeinmedizin.de
KWBW Verbundweiterbildung plus Wir stehen für eine bessere Weiterbildung in der Allgemeinmedizin!
Einstieg jederzeit möglich –auch für Quereinsteiger!
Wir begleiten Sie während der gesamten Weiterbildung. Die KWBW Verbundweiterbildung plus bietet ein strukturiertes Seminar- und MentoringProgramm in persönlicher Atmosphäre. Regionale Vernetzung steht bei uns im Mittelpunkt! Für Weiterbildende werden Trainthe-Trainer-Seminare angeboten.
Kursinhalte:
In industrieunabhängigen Seminaren erhalten Sie das Handwerkzeug für die hausärztliche Versorgung:
LEBEN RETTEN ÜBER DAS EIGENE LEBEN HINAUS
UNTERSTÜTZEN SIE ÄRZTE OHNE GRENZEN MIT IHREM
TESTAMENT. Mehr Informationen finden Sie in unserer Broschüre „Ein Vermächtnis für das Leben“: www.aerzte-ohne-grenzen.de/testamentsspende
Ansprechpartnerinnen:
Sinah Scheffler und Katharina Nägler
Telefon: 030 700 130-145
Mail: testament@berlin.msf.org
Symptombezogene Beratungsanlässe wie Brennen beim Wasserlassen oder Ohrenschmerzen, praktische Übungen wie Urinkatheter legen oder Untersuchungstechniken des Bewegungsapparates und auch Umgang mit chronischen Krankheiten wie Diabetes oder Depression werden ebenso strukturiert vermittelt wie beispielsweise Abrechnung, Praxisorganisation oder Wundmanagement.
In Train-the-Trainer-Seminaren unterstützen wir Sie bei der Umsetzung der Weiterbildung in Ihrer Praxis.
Alle Termine 2023 und einfache Anmeldung unter: www.kwbw.de
Herausgeber:
Landesärztekammer Baden-Württemberg und Kassenärztliche Vereinigung Baden-Württemberg
Herausgebergremium:
Dr. med. Wolfgang Miller (Vorsitzender), Dr. med. Karsten Braun (stellv. Vorsitzender), Dr. med. Sophia Blankenhorn, Dr. med. Jürgen de Laporte, Markus Haist, Dr. med. Paula Hezler-Rusch, Prof. Dr. med. Christof Hofele, Dr. med. Doris Reinhardt, Dr. med. Anne Gräfin Vitzthum Verantwortlicher Chefredakteur:
Dr. med. Oliver Erens (OE)
Anschrift Redaktion:
Jahnstraße 38 A, 70597 Stuttgart
Postfach 70 03 61, 70573 Stuttgart
Telefon +49 (0) 711 / 7 69 89-45 aebw@aebw.de
Verlag und Auftragsmanagement:
Alfons W. Gentner Verlag GmbH & Co. KG
Forststraße 131, 70193 Stuttgart
Postfach 10 17 42, 70015 Stuttgart
Anzeigenleitung:
Axel Hollenbach
Telefon +49 (0) 711 / 6 36 72-8 27
Telefax +49 (0) 711 / 6 36 72-7 60 hollenbach@gentner.de
Auftrags-Management:
Melanie Schweigler (Leitung)
Telefon +49 (0) 711 / 6 367 2-8 62 schweigler@gentner.de
Rudolf Beck
Telefon +49 (0) 711 / 6 36 72-8 61
Telefax +49 (0) 711 / 6 36 72-7 60 beck@gentner.de
Z. Zt. ist Anzeigenpreisliste Nr. 66 vom 1. 1. 2023 gültig. Layout und Gestaltung: GreenTomato GmbH, Stuttgart
Druck:
Vogel Druck und Medienservice GmbH, Höchberg
Internet: www.ärzteblatt-bw.de
Bezugspreise:
Inland: jährlich 112,90 € zzgl. Versand kosten 21,00 € (inkl. der jeweils gül tigen MwSt.).
EU-Länder- Empfänger mit UST-ID-Nr. und Ausland: jährlich 112,90 € zzgl. Versandkosten 36,00 € EU-Länder ohne UST-ID-Nr.: jährlich 112,90 € zzgl. Versandkosten 36,00 € zzgl. MwSt. (Export- oder Importland).

Einzelheft: 15,00 € zzgl. Versandkosten.
Bei Neubestellungen gelten die zum Zeitpunkt des Bestelleingangs gültigen Bezugspreise. Durch den Kammerbeitrag ist der Bezugspreis für Mitglieder der Landesärztekammer Baden-Württemberg abgegolten.
Bezugsbedingungen:
Bestellungen sind jederzeit beim Leserservice oder bei Buchhandlungen im In- und Ausland möglich. Abonnements verlängern sich um ein Jahr, wenn sie nicht schriftlich mit einer Frist von drei Monaten zum Ende des Bezugsjahres beim Leserservice gekündigt werden. Die Abonnementpreise werden im Voraus in Rechnung gestellt oder bei Teilnahme am Lastschriftverfahren bei den Kreditinstituten abgebucht. Redaktionsschluss für redaktionelle Beiträge ist jeweils der 15. des vorangehenden Monats. Mit Namen und Signum des Verfassers gezeichnete Artikel entsprechen nicht unbedingt der Meinung der Schriftleitung. Für unverlangt eingesandte Manuskripte übernehmen Schriftleitung und Verlag keine Haftung. Bei Einsendungen an die Schriftleitung wird das Einverständnis zur vollen oder auszugsweisen Veröffentlichung vorausgesetzt. Die Redaktion behält sich Kürzungen von Leserbriefen vor. Die systematische Ordnung der Zeitschrift sowie alle in ihr enthaltenen einzelnen Beiträge und Abbildungen sind urheberrechtlich geschützt. Mit der Annahme eines Beitrages zur Veröffentlichung erwirbt der Verlag vom Autor umfassende Nutzungsrechte in inhaltlich unbeschränkter und ausschließlicher Form, insbesondere Rechte zur weiteren Vervielfältigung und Verbreitung zu gewerblichen Zwecken mithilfe mechanischer, digitaler oder anderer Verfahren. Bis auf Widerruf (socialmedia@gentner.de) gilt dies auch für die Verwendung von Bildern, Graphiken sowie audiovisueller Werke in den Social MediaKanälen Facebook, Twitter, Google+ und YouTube. Kein Teil dieser Zeitschrift darf außerhalb der engen Grenzen urheberrechtlicher Ausnahmebestimmungen ohne schriftliche Einwilligung des Verlages in irgendeiner Form – durch Fotokopie, Mikrofilm oder andere Verfahren – reproduziert oder in eine von Maschinen, insbesondere von Datenverarbeitungsanlagen verwendbare Sprache übertragen werden. Die Wiedergabe von Gebrauchsnamen, Handelsnamen, Warenbezeichnungen u. dgl. in dieser Zeitschrift berechtigt nicht zu der Annahme, dass solche Namen ohne Weiteres von jedermann benutzt werden dürfen; oft handelt es sich um gesetzlich geschützte eingetragene Warenzeichen, auch wenn sie nicht als solche gekennzeichnet sind. Im Ärzteblatt Baden-Württemberg werden für die Bezeichnungen der einzelnen Gruppen nicht durchgehend beide Formen – männlich und weiblich – verwendet. Sämtliche Personenbezeichnungen gelten im Sinne der Gleichbehandlung für alle Geschlechter. Die verkürzte Sprachform hat nur redaktionelle Gründe und beinhaltet keine Wertung. Erscheinungsweise: 12 Ausgaben pro Jahr jeweils zur Monatsmitte
ISSN 0720-3489
490 ÄBW 07 | 2023 Bekanntmachungen
NEPAL © VISUM / Panos Pictures / Brian Sokol
Für Stellen- und Rubrikanzeigen
Aktuell & jederzeit
▪ Mit ärzte-markt.de alle Ärzte in Süddeutschland erreichen.
▪ Stellenanzeigen erscheinen online und können in den Printausgaben der Ärzteblätter:
- Ärzteblatt Baden-Württemberg
- Bayerisches Ärzteblatt verlängert werden.
▪ Selbstverständlich können Rubrikanzeigen für die Printausgaben über das Portal aufgegeben werden.

Buchungsoptionen
Ihre Stellenanzeige erscheint online und wird als Index Kurzversion in der nächstmöglichen Printausgabe des Ärzteblattes Baden-Württemberg und des Bayerischen Ärzteblattes verö entlicht
- Ganzseitige Stellenanzeige online
- Indexanzeige erreicht 142.100 Leser
- Erreicht aktiv und passiv suchende Ärzte
Ansprechpartner:


Rudolf Beck
beck@aerzte-markt.de 0711 63672 -861

www.ärzte-markt.de wird betrieben von Verlagsgemeinschaft Atlas Gentner GbR Hauptsitz: Forststraße 131, 70193 Stuttgart
Ihre Stellenanzeige erscheint in den ausgewählten Printprodukten und wird 30 Tage online verö entlicht

- Ihre gebuchte Printausgabe erscheint zusätzlich einszu-eins online, wie o ine

- Auswahl zwischen Kombiverö entlichung und Einzelbelegung Ärzteblatt BadenWürttemberg und Bayerisches Ärzteblatt
Ihre Rubrikanzeige (Stellengesuch, Praxisverkäufe/ -abgaben/ -vermietungen etc.) erscheint ausschließlich in den Printausgaben
Auswahlmöglichkeit:
- Ärzteblatt
Baden-Württemberg
- Bayerisches Ärzteblatt
- Kombibuchung

491 ÄBW 07 | 2023
Niederlassung München, Bajuwarenring 19, 82041 Oberhaching Telefon: +49 711 63672-861, Fax: +49 711 63672-747 Email: support@aerzte-markt.de
1. Online First (Stellenanzeigen)
2. Print First (Stellenanzeigen)
3. Print only (Rubrikanzeigen)
Das medizinische Stellenportal für Süddeutschland
So einfach geht’s:
1. QR-Code scannen oder direkt www.ärzte-markt.de öffnen

2. JOB-ID in der Suchmaske eingeben
3. Umgehend alle weiteren Informationen zu der Indexanzeige erhalten
4. Bewerbung abschicken und Traumjob starten
Aktuelle Stellenangebote
5010 Ärztin/Arzt (m/w/d) mit Schwerpunkt Öffentliche Gesundheit
Ärztin/Arzt (m/w/d) mit Schwerpunkt Öffentliche Gesundheit für die Landessanitätsdirektion Salzburg ...
81679 Facharzt für Psychiatrie und Psychotherapie (m/w/d) Die HNO Klinik Dr. Gaertner ist eine im Krankenhausplan ... #ZCUN
81737 Oberärztin / Oberarzt Psychosomatische Medizin und Psychotherapie (w|m|d)
82319 HNO-Oberärzt:innen – Fachärzt:innen – Assistent:innen in Weiterbildung
84453 FA für Orthopädie und Unfallchirurgie (m/w/d)
85276 FA Innere Medizin (m/w/d) Schwerpunkt Gastroenterologie und Schwerpunkt Hämatologie/ Onkologie
85521 Facharzt für Radiologie (m/w/d)
für 40 Std./Woche in Vollzeit, Teilzeitbeschäftigung ist möglich, auch in ... #BNQW
Wir suchen HNO-ärztliche Verstärkung (w/m/d) für unsere Standorte in der ... #CQYJ
Moderne, chirurgische Praxisklinik in Mühldorf mit den Fachrichtungen Orthopädie, Unfall-, ...
FA Innere Medizin (m/w/d) Schwerpunkt Gastroenterologie und Schwerpunkt Hämatologie/ Onkologie ...
Facharzt für Radiologie (m/w/d) mit Erfahrung in Schnittbilddiagnostik und Freude ...
86152 Oberärztin/-arzt der Wirbelsäulenchirurgie (m/w/d) Sie sind Facharzt für Neurochirurgie oder Orthopädie und Unfallchirurgie ... #VGRP
86152 Oberärztin/-arzt der Gefäßchirugie (m/w/d)
86152 Oberärztin/-arzt der Phlebologie und Venenchirurgie (m/w/d)
86152 Oberärztin/-arzt Kardiologie (m/w/d)
86159 FA Psychiatrie & Psychotherapie oder FA Kinder-/Jugendpsychiatrie (m/w/d)

86551 Fachärztin / Facharzt (m/w/d) in Teilzeit mit vorhandener Zusatzbezeichnung Palliativmedizin
89134 FA f. Orthopädie o. FA für physikalische Therapie/ Rehawesen (m/w/d) in Teilzeit/Vollzeit
89335 OBERARZT (m/w/d) für die neurologische Frührehabilitation mit Weaning-Einheit
89335 OBERARZT ANÄSTHESIE (m/w/d)
Sie sind Facharzt für Gefäßchirurgie und haben Erfahrung in der ... #HPAS
Sie sind Facharzt für Allgemeine Chirurgie oder Gefäßchirurgie und tragen ...
Sie sind Facharzt für Innere Medizin und Kardiologie? Sie verfügen ... #FJTB
Für die ärztliche Leitung der Reha-Abteilung für suchtkranke Jugendliche bei ... #VZNR
Für unser Palliativteam Wittelsbacher Land (SAPV) suchen wir zum nächstmöglichen ... #AWBV
Zur Teamerweiterung meiner orthopädischen Praxis FA f. Orthopädie o. ... #PSVQ
Herzlich willkommen als OBERARZT (m/w/d) für ... #QFHC
Herzlich willkommen als OBERARZT ANÄSTHESIE (m/w/d) #GFZW
Weitere aktuelle Stellenangebote aus dem süddeutschen Raum finden Sie unter ärzte-markt.de
Suchen und inserieren unter ärzte-markt.de
492 ÄBW 07 | 2023
ärzte-markt.de |
Scan me Bild: GettyImages PLZ Titel (m/w/d) Beschreibung ID
#UGKN
#HSND
#SUNF
#FGQT
#ULCQ
90513 Weiterbildungsassistenten & Fachärzte (w/m/d) in Voll- oder Teilzeit
91341 FA/FÄ Innere/Allgemeinmedizin in Teilzeit/Vollzeit
92637
Fachärztin/-arzt für Radiologie m/w/d –Assistenzärztin/-arzt für Radiologie m/w/d –Fachärztin/-arzt für Nuklearmedizin m/w/d
94032 Arzt/Ärztin (m,w,d) TZ od. VZ amb. Palliativversorgung
97440
Fachärztin / Facharzt (m/w/d) für Psychiatrie und Psychotherapie
97440 Fachärztin / Facharzt (m/w/d) für Psychiatrie und Psychotherapie
97440 Ärztinnen und Ärzte (m/w/d) in Weiterbildung zur Fachärztin / zum Facharzt für Psychiatrie und Psychotherapie
Weiterbildungsassistenten & Fachärzte (m/w/d) gesucht. Wir, die Praxis Krafft und ...

FA/FÄ Innere/Allgemeinmedizin in Teilzeit/Vollzeit für moderne Hausarztpraxis in Röttbach bei ... #BZAN
Wir suchen zum nächstmöglichen Zeitpunkt in Voll- oder Teilzeit. – ... #QUHG
SAPV-Team Stadt- u. Lkrs. Passau sucht eine(n) Arzt/Ärztin (m,w,d) ...
Für unsere Psychiatrische Institutsambulanz am Standort Werneck such wir zum ...
Für unsere Psychiatrische Institutsambulanz (PIA) am Standort Schweinfurt suchen wir ...
Für verschieden Fachbereiche suchen wir ab sofort Ärztinnen und Ärzte ...
#ZVXU
#GWUT
#LPWA
#CEML
Weitere aktuelle Stellenangebote aus dem süddeutschen Raum finden Sie unter ärzte-markt.de
Suchen und inserieren unter ärzte-markt.de
KRIEGEN SETZEN WIR HOFFNUNG ENTGEGEN
Mit Ihrer Spende rettet ÄRZTE OHNE GRENZEN
Leben: Mit 52 Euro können wir zum Beispiel 40 Menschen auf der Flucht drei Monate lang mit den wichtigsten Medikamenten versorgen.
Private Spender*innen ermöglichen unsere weltweite Hilfe –jede Spende macht uns stark
Spendenkonto:
Bank für Sozialwirtschaft
IBAN: DE72 3702 0500 0009 7097 00
BIC: BFSWDE33XXX
www.aerzte-ohne-grenzen.de/spenden
493 ÄBW 07 | 2023
PLZ Titel (m/w/d) Beschreibung ID
#AVSF
ärzte-markt.de
| Das medizinische Stellenportal für Süddeutschland
REPUBLIK MOLDAU: Raisa Pavlova flieht vor den Kämpfen in der Ukraine, unsere Mitarbeiterin Svetlana Bujac bietet ihr Hilfe an. © Peter Bräunig
WIR suchen Assistenzärzte, die im LEBEN noch einiges vorhaben und in der GESUNDHEIT den nächsten Karriereschritt machen wollen.
A RBEITSMEDIZINER oder ARZT IN WEITERBILDUNG (M/W/D)
UNBEFRISTET in VOLL- oder TEILZEIT, BUNDESWEIT ( u.a. FRIEDRICHSHAFEN | AALEN | TAUBERBISCHOFSHEIM | ULM/GEISLINGEN | KIRCHHEIM | LÖRRACH | HEILBRONN | MANNHEIM | ALBSTADT | WAIBLINGEN | RADOLFZELL | KARLSRUHE | REUTLINGEN)
Starten Sie mit uns durch in eine gesunde Zukunft!
Wir sind Vordenker, Marktführer und deutschlandweit an unseren 152 Standorten mit über 3.800 Fachkräften in der Arbeitsmedizin, Arbeitssicherheit und im Gesundheitsmanagement im Einsatz. Wir unterstützen und beraten unsere Kunden bei der Gestaltung gesunder und sicherer Arbeitsplätze.
Unser Antrieb: Wir fördern und leben Gesundheit – auf allen Ebenen.
WIR BIETEN MEHR
Sehr gute Work-Life-Balance ohne Wochenend-, Nacht- und Feiertagsdienste
Erlangung des Facharzttitels für Arbeitsmedizin durch unsere finanzierte Weiterbildung inklusive eigenem Weiterbildungscurriculum
Strukturierte Einarbeitung zu allen Themen des Arbeits- und Gesundheitsschutzes
Vielfältige und erfüllende Aufgaben sowie ausgezeichnete Entwicklungsmöglichkeiten
Attraktiver Tarifvertrag, jährliche Erfolgsprämie, betriebliche Altersvorsorge, Gesundheitsangebote, Jobrad u. v. m.
LEBEN UND ARBEITEN
Ausschließlich präventive Tätigkeiten, u. a. Durchführung von Vorsorgen und Untersuchungen bei Mitarbeitenden unterschiedlichster Unternehmen
Diagnose und Prävention von arbeitsbedingten Erkrankungen
Umfassender Einblick in das komplette Spektrum der Arbeitsmedizin durch Kundenunternehmen verschiedener Branchen und Wirtschaftszweige
Flexible Arbeitswelt mit Tätigkeiten im Gesundheitszentrum, im Außendienst und der Möglichkeit, anteilig mobil zu arbeiten (standortabhängig)
IHRE EXPERTISE IM BEREICH GESUNDHEIT

Mindestens 24 Monate absolvierte Weiterbildungszeit in anderen Gebieten der unmittelbaren Patientenversorgung, um nun bei uns den Facharzttitel in der Arbeitsmedizin erlangen zu können
Sie sind alternativ bereits Facharzt (m/w/d) für Arbeitsmedizin oder Arzt (m/w/d) mit Zusatzbezeichnung Betriebsmedizin und steigen direkt als Experte (m/w/d) bei uns ein
Freude an der Arbeit im Team und am kollegialen Austausch, auch mit unseren anderen Fachbereichen
Führerschein und idealerweise eigener Pkw
INTERESSIERT?
Dann freuen wir uns auf Ihre vollständigen Bewerbungsunterlagen unter Angabe Ihrer Gehaltsvorstellungen und des frühestmöglichen Eintrittstermins über unser Bewerberportal.
FA/FÄ Allgemeinmedizin oder Innere Medizin zur Anstellung in VZ/TZ gesucht (ab sofort)

Modern eingerichtete und ausgestattete Hausarztpraxis in Stuttgart-Feuerbach (Grazer Str. 22, 70469 Stuttgart)
Abnahme administrativer Aufgaben durch eigene Software, praxisübergreifender Austausch, kollegiale Atmosphäre, attraktive Rahmenbedingungen.
E-Mail: habib.fussi@avimedical.com / Tel.: 015209068823 www.avimedical.com/aerzte
B·A·D GmbH –Personalentwicklung und Recruiting, Organisations- und Kulturberatung
Herr Düsing, Tel.: 0228 - 40072-184
Folgen Sie uns auf:
JETZT BEWERBEN!
https://www.bad-gmbh.de/karriere/ stellenangebote/
Einfach QR Code scannen und direkt zu den Anzeigen gelangen.

Sicher arbeiten. Gesund leben.
Kinder-Jugendärztin/-arzt (w/m/d) gesucht in TZ/VZ ab September 23 nach Esslingen a. N. Sinnhafte Arbeit, flexible Zeiten, Gehalt wie Tarif, kompetentes Team, moderne Räume, sichere EDV, umfangreiche Medizintechnik. backoffice@kinderarzt-dr-vonbutler.de
HNO FA (m/w/d) in Pforzheim zur Anstellung in Praxis in VZ/TZ gesucht. hno-pf@gmx.de
Baden-Württemberg

494 ÄBW 07 | 2023 STELLENANGEBOTE Ein Unternehmen der LBBW-Gruppe Bestens beraten. Unsere Beratung für Heilberufe. Branchenvergleich Praxiswertermittlung Liquiditätsplanung Standortanalyse Heilberufe-Seminare Vermögensmanagement Infos unter Telefon 0711 124-45019 www.bw-bank.de/heilberufe F0220002_10_03_AZ_BW_Heilberufe_183x40.pdf - Jul_17_2020 05_17_16
Är zteblatt
Ärztliche Leitung (m/w/d)
Einsatzort
Günzburg
Arbeitszeit
Vollzeit/Teilzeit
Nicht irgendein Job.
Eintrittsdatum nach Vereinbarung
Ein selbstbestimmtes Leben ermöglichen beim Spezialisten für Heimdialyse.
Ihre Aufgaben bei uns
• Im Team unseres KfH-Nierenzentrums betreuen Sie unsere Patienten während der erforderlichen ambulanten Dialysebehandlung und auch in unserer nephrologischen Sprechstunde.
• In Kooperation mit niedergelassenen Kollegen, Universitätskliniken, Krankenhäusern und Transplantationszentren leisten Sie einen wichtigen Beitrag zur nephrologischen Gesamtversorgung.
• Mit Ihrem medizinischen Wissen und Können verbessern Sie die Lebensqualität der uns anvertrauten Patienten.
• Sie behandeln Menschen mit chronischen internistischen Erkrankungen.
• Sie behandeln unsere Patienten in der Prädialyse, Transplantationsvorbereitung und -nachsorge sowie Lebendspender.
Darum passen Sie zu uns
• Sie sind Facharzt (m/w/d) für Innere Medizin mit der Zusatzbezeichnung Nephrologie.
• Sie arbeiten gerne teamorientiert und interdisziplinär.
• Sie besitzen idealerweise bereits eine Ultraschallgenehmigung.
• Sie nehmen sich Zeit für Ihre Patienten.
• Sie sind flexibel und engagiert.
• Sie reizt das breite und vollständige nephrologische Aufgabenspektrum.
• Sie sind hochmotiviert und möchten sich in ein dynamisches Team einbringen.
• Sie suchen die Herausforderung des professionellen und interdisziplinären Austausches.
• Sie verfügen über eine hohe menschlich-soziale Kompetenz und gute Kommunikationsfähigkeit.
Unser Angebot für Sie
• Freuen Sie sich auf eine attraktive Vergütung mit leistungsorientierten variablen Vergütungsanteilen.
• Profitieren Sie von einem zusätzlichen Zuschuss zu Ihrer privaten Altersversorgung.
• Entwickeln Sie sich durch medizinische und fachübergreifende Fortbildungen beruflich weiter.
• Unterstützung in allen beruflichen und privaten Lebenslagen durch eine kostenlose externe Mitarbeiterberatung.
• Bewerbungen von Menschen mit Behinderung sind uns besonders willkommen.
Was Sie sonst noch wissen sollten
• Das Nierenzentrum in Günzburg behandelt rund 120 Dialysepatienten mit den unterschiedlichsten Dialyseverfahren.
• Durch die enge Zusammenarbeit mit den Kreiskliniken Günzburg-Krumbach ist sowohl eine ambulante als auch eine stationäre Behandlung der nierenkranken Patienten gewährleistet.
• Neben der großen nephrologischen Sprechstunde gibt es auch eine umfassende Transplantationssprechstunde. Hier besteht eine langjährige Zusammenarbeit mit den Transplantationszentren in Augsburg und München-Großhadern.
• Die Stadt Günzburg liegt landschaftlich reizvoll direkt an der schwäbischen Donau und verfügt über eine verkehrsgünstige Autobahnanbindung nach München und Stuttgart.
KfH Kuratorium für Dialyse und Nierentransplantation
Herr Sebastian Weidner
Kaumännische Leitung
Telefon 0174 6374175
Weitere Informationen und Online-Bewerbung: jobs.kfh.de
Bewerbungen auch gerne via E-Mail an: sebastian.weidner@kfh.de
Wir suchen zur Erweiterung unseres Dozententeams an der Physiotherapieschule Ortenau gGmbH in Willstätt-Eckartsweier:

1 Facharzt (m/w/div) für Pädiatrie evtl. auch Weiterbildungsassistenten/innen bzw. Ärzte/innen im Ruhestand auf Honorarbasis (Stundenumfang nach Absprache) zur Lehrtätigkeit im Bereich der Pädiatrie. Der/die Bewerber/in sollte über gute Deutschkenntnisse in Wort und Schrift verfügen. Unterrichtserfahrung ist erwünscht, aber nicht zwingend erforderlich.
Sie geben Ihr Wissen und Ihre Erfahrung gerne an junge motivierte Physiotherapieschüler weiter? Dann freuen wir uns auf Sie. Wir bieten Ihnen einen modernen Arbeitsplatz mit allen erforderlichen Einrichtungen für den Unterricht. Sie arbeiten in einem hoch qualifizierten Team aus Professoren, Ärzten, Psychologen, Juristen und Physiotherapeuten.
Falls Sie mehr über uns erfahren wollen besuchen Sie uns auf unserer Homepage www.pso-physiotherapie.eu oder besser setzen Sie sich gleich mit uns in Verbindung. In einem persönlichen Gespräch können wir Ihnen weitere Informationen geben.
Bewerbungen an: Physiotherapieschule Ortenau gGmbH
Frank Pahle M. Sc. (Stellv. Schulleiter)
Birkenstr. 5, 77731 Willstätt-Eckartsweier
Tel.: 07854/9829412, Fax: 07854/599
Email: frank.pahle@pso-physiotherapie.eu

Arzt als Gutachter (w/m/d) im Bereich Verkehrsmedizin in Voll- oder Teilzeit
Aufgaben
• Begutachtung von verkehrsauffälligen Kraftfahrern
• Erstellen von medizinisch-psychologische Gutachten gemäß der Fahrerlaubnisverordnung (FeV) und den Vorgaben aus dem Qualitätsmanagement
• Erstellen von ärztlichen Gutachten gemäß den Vorgaben aus dem Qualitätsmanagement
• Durchführung von Abstinenzkontrollprogrammen
• Weitere fahreignungsdiagnostische Tätigkeiten
• Unterstützung der Gebietsleitung
Qualifikationen
• Abgeschlossenes Studium der Fachrichtung Medizin sowie mindestens zwei Jahre Berufserfahrung im klinischen Bereich
• Freude an verantwortungsbewusster und selbständiger Arbeit
• Belastbarkeit und Mobilität sowie zeitliche Flexibilität
• Bereitschaft zur späteren Übernahme von Fach- und/oder Führungsfunktionen
• Positive Ausstrahlung, Teamfähigkeit und Kundenorientierung sowie Einsatzbereitschaft für unsere Kunden
• Routinierter Umgang mit MS-Office Anwendungen

• Interesse an der Weiterentwicklung unseres Arbeitsgebietes
TÜV SÜD Life Service GmbH Ihre Ansprechpartnerin:
Friedrichstraße 9 a Frau Andrea Häußler
70174 Stuttgart (andrea.haeussler@tuvsud.com)
495 ÄBW 07 | 2023 STELLENANGEBOTE
e. V.
Kleinanzeigen im Ärzteblatt Baden-Württemberg
Stellenangebote für Fachärzte (m/w/d) im amb. Bereich in modernen Praxen / MVZ´s in folgenden Regionen:
Allgemeinmedizin/Innere Medizin (hausärztlich):
Freiburg: TZ/VZ, opt. Einstieg in BAG, ab sofort (A790010BW)
Heilbronn: TZ/VZ, Einzelpraxis, baldmöglichst (A740010BW)
Heidelberg: TZ/VZ, MVZ, mehrere Standorte ab 09.23 (A690010BW)
Karlsruhe: TZ/VZ, opt. Einstieg in BAG, ab Herbst (A760010BW)
Mannheim: TZ/VZ, Einzelpraxis, ab sofort (A680010BW)
Pforzheim: TZ, EP, kurzfristig, später steigende Std.zahl (A750010BW)
Reutlingen: VZ, opt. Einstieg in EP, mehrere Sitze vorh. (A721010BW)
Stuttgart: TZ/VZ, opt. Einstieg in BAG (A700010BW)
Frauenheilkunde:
Freiburg: TZ/VZ, Einzelpraxis, kurzfristig möglich (A790011BW)
Heidelberg: TZ, BAG, zum 1.1.24 (A690011BW)
Pforzheim: TZ/VZ, EP, gerne mit Praxiserfahrung (A9X0080JS)
Reutlingen: TZ/VZ, Einzelpraxis, ab sofort (A721011BW)
Ulm: TZ/VZ, MVZ, mehrere Standorte (A890011BW)
Innere Medizin (fachärztlich):
Freiburg: Gastroenterologie, TZ, opt. Einstieg (A790014BW)
Stuttgart: Diabetologie, TZ/VZ, MVZ, versch. Standorte (A700015BW)
Ulm: Pneumologie, TZ/VZ, BAG mit Schlaflabor (A890013BW)
Orthopädie, Orthopädie/Unfallchirurgie, Chirurgie:
Heilbronn: TZ/VZ, MVZ, kons./operativ, ab sofort (A740012BW)
Heidelberg: TZ/VZ, MVZ mehrere Standorte, operativ (A690012BW)
Karlsruhe: VZ, opt. Einstieg, EP, gern Schulterspez. (A760012BW)
Stuttgart: TZ/VZ, MVZ, rein kons., Schmerztherapeut (A700012BW)
Tübingen: TZ/VZ, MVZ, mehrere Standorte, kons. und operativ, ab sofort, ggfls. Leitungsposition besetzbar
Für Bewerber ist die Vermittlung kostenfrei!
Weitere Angebote finden Sie im Arztstellenmarkt: s.s.p. Die Ärztevermittler.
Tel. (0911) 8012849 I aerztevermittler@ssp-online.de I www.ssp-aerztevermittler.de

Zur Teamerweiterung meiner orthopädischen Praxis FA f. Orthopädie o. FA für physikalische Therapie/Rehawesen (m/w/d) in Teilzeit / Vollzeit im Alb-Donau-Kreis (Nähe Ulm) gesucht
Zuschriften erbeten unter ÄBW 20072 an den Gentner Verlag, PF 10 17 42, 70015 Stuttgart oder per E-Mail an chiffre@aebw.de
Facharzt/Fachärztin für Psychiatrie/Neurologie
für 8 – 40 Wochenstunden in Gemeinschaftspraxis mit 6 Ärzten gesucht. Dres. Schlüter/Beckmann, 74613 Öhringen, 07941 9849356
Wir setzen auf Teamarbeit, flache Hierarchien und treffen Entscheidungen auf Augenhöhe. Eine ausgewogene Work-Life-Balance und die
Dozent gesucht
Arzt /Ärztin wird gesucht für medizinischen Unterricht (Donnerstagabend) in einer Heilpraktikerschule in Stuttgart auf Honorarbasis. Tel. 0172 7233936
Psychiatr.-Psychother. (m/w/d), Teil- od. Vollzeit, ggf. 1 J. Weiterbildung, schöne Unistadt BW, spätere PraxisÜbernahme mögl.
Zuschriften erbeten unter ÄBW 20021 an den Gentner Verlag, PF 10 17 42, 70015 Stuttgart oder per E-Mail an chiffre@aebw.de
STELLENGESUCHE
Innere Medizin/Kardiologie
Kardiologin (m/w/d) zur Mitarbeit in Tübinger Schwerpunktpaxis gesucht. Zeitpunkt und Stellenumfang frei verhandelbar
E-Mail: marion.estler@t-online.de

Honorararzt:innen für Notfalldienste Raum Stuttgart gesucht. Attraktive Vergütung, freie Dienstauswahl, keine Bürokratie. Bitte melden Sie sich unter dienste.nfd@gmail.com oder Tel 01525-3077714
FA Allgemeinmedizin
im Ruhestand mit 30-jähriger Erfahrung in eigner Praxis sucht TZ-Mitarbeit in Hausarztpraxis im Raum Rastatt /Karlsruhe. Zuschriften erbeten unter ÄBW 19873 an den Gentner Verlag, PF 10 17 42, 70015 Stuttgart oder per mail an chiffre @ aebw.de
VERTRETUNGEN
HNO-Praxis in Wiesloch sucht einen Kollegen /eine Kollegin zur regelmäßigen Praxisvertretung sowohl an Einzeltagen in der Woche als auch zur Urlaubsvertretung. Das Arbeitsklima ist außerordentlich freundlich und wir freuen uns auf Sie. Sollten Sie eine längere Anreise haben, steht eine Übernachtungsmöglichkeit (Pension) zur Verfügung.
Bitte senden Sie Ihre Bewerbung unter ÄBW 19043 an den Gentner Verlag, PF 10 17 42, 70015 Stuttgart oder per mail an chiffre@aebw.de
DIENSTLEISTUNGEN
Vereinbarkeit von Familie und Beruf sind bei uns selbstverständlich.
Um die Abrechnung kümmern sich unsere Expert*innen.
Fachärzt*in (m/w/d) für Allgemeinmedizin oder Innere Medizin (hausärztlich) in Voll-/ Teilzeit
Hausarztpraxis Plochingen
in 73207 Plochingen
07153.6085980 info@hausarzt-plochingen.de
Interessiert? www.hausarzt-plochingen.de
496 ÄBW 07 | 2023 STELLENANGEBOTE
Bitte beachten Sie, dass im Gegensatz zu anderen Diensten im ÄBW Chiffreanzeigen möglich sind, die Ihre Anonymität gewährleisten! ÄBW-markt, der etablierte und effektive Stellenmarkt!
PRAXISABGABE
Bestens beraten. Profitieren Sie vom kostenlosen Service »Praxisabgabe«.
Praxisabgabe-Seminar Praxiswertermittlung
Standortanalyse Praxisbörse
Branchenvergleich Finanz- und Erbfolgeplanung
Infos unter Telefon 0711 124-45019 www.bw-bank.de/heilberufe
Gut eingeführte hausärztliche Praxis in 89551 Königsbronn mit Potential sehr günstig abzugeben.
EKG, Sono, Echo, Ergo, Spiro, Labor. Angebot zur Einarbeitung / übergangsweisen Mitarbeit zur Entlastung. Dringender Versorgungsbedarf, Unterstützung durch Gemeinde zugesagt. Mail: praxis-2023@gmx.de
A l l g e m e i n m e d i z i n a m F o r g g e n s e e / R e g i o n F ü s s e n Kein Sanierungsstau! Papierlos, TOP-Personal! Sono, Ergo, 24 h RR, 24h-EKG, LuFu. OP-Raum. EG, günstige Miete. Ertrag >10TSD/Monat/Netto. Ab 25 flexibel frei. Auch WB, Übergangskooperation, Fusion möglich. Arztsitz@email.de
Psychiatrischer Praxissitz abzugeben
Sehr gut frequentierter Praxissitz für Psychiatrie u. Psychotherapie im LK Heilbronn altersbedingt zum 01.07. 2024 abzugeben.
Zuschriften erbeten unter ÄBW 0132 an den Gentner Verlag, PF 10 17 42, 70015 Stuttgart oder per E-Mail an chiffre@aebw.de
Etablierte Hausarztpraxis mit breitem Behandlungsspektrum (im Raum HD-Wiesloch) sucht Nachfolger:in. Veysi Ezgin, 0178/7323423; veysi.ezgin@mlp.de
Nachfolge FA Innere Medizin/Allgemeinmedizin (m/w/d)
In unserer sehr gut gehenden hausärztl. Gemeinschaftspraxis in Mannheim Rheinau-Süd wird einer der beiden Praxissitze zum 01.04.24 frei. Wir suchen eine(n) Nachfolger(in) zur Übernahme. Der Zeitpunkt kann variabel angepasst werden. Kontakt zu Dr. Kaiser: jr_kaiser@web.de
Praxis Psychiatr.-Psychother.
Schöne Unistadt BW. Hier stimmt alles: gute motivierte MFAs, Atmosphäre, Patienten-Stamm, Zulauf, Lage, Räume, geeignet f. Prax.-Gem. od. MVZ. Zunächst Anstellung, Voll- od. Teilzeit, evtl. Weiterbildung (1 J.).
Zuschriften erbeten unter ÄBW 20020 an den Gentner Verlag, PF 10 17 42, 70015 Stuttgart oder per E-Mail an chiffre@aebw.de
PRAXISRÄUME
H a u s a r z t i n K o n s t a n z sucht Nachfolger (m/w/d) ab 1/24, NHV , Homöop., Akup., 50% Pädiatrie E-Mail: hcfoerster@web.de
Bitte beachten Sie: Anzeigenschluss = Druckunterlagenschluss
Alteingesessene HNO Praxis im Speckgürtel von Stuttgart, Zentrumslage, sucht Nachfolger:in. Barbara Brenner, 0176 23364375
Hausarzt/-ärztin in der Schweiz
Praxisnachfolge gesucht für Hausarztpraxis in Schaffhausen mit elektronischer KG, direkter Medikamentenabgabe, treuem Patientenstamm. Zentrale Lage, Parkplätze vor dem Haus, ÖV in Gehdistanz. Pensum (aktuell 60 %) und Räumlichkeiten erweiterbar. Interessante Notfalldienstregelung. Günstige Übernahmekosten, ab April 24 oder nach Vereinbarung. Bilder unter docSH. Administrative Unterstützung durch Hausarztverein. Mehrere deutsche Kollegen bereits ansässig.
Kontakt: Dr. med. Petra Kappeler, Durachweg 22, CH-8207 Schaffhausen, Tel. +41 625 14 95, E-Mail: petra.kappeler@hin.ch od. petraka@hotmail.ch
Kardiologische Praxis abzugeben
Großraum Stuttgart / Abgabe zu Mitte 2024 / Referenz 388388
Dr. Meindl & Collegen AG, Marc Schiffer marc.schiffer@muc-gruppe.de, Tel. 0911/234209-18
Pneumologie – Praxisübernahme-Möglichkeit
Raum Heilbronn/Schwäbisch Hall / gut etablierte Praxis / Übernahme 2024 gewünscht / Referenz 380889
Dr. Meindl & Collegen AG, Marc Schiffer marc.schiffer@muc-gruppe.de, Tel. 0911/234209-18
Hausärztliche Praxis in Esslingen abzugeben. Sehr geräumig, daher auch für 2 Ärzte /Ärztinnen oder als Standort für MVZ geeignet; Fläche 144 m²; Aufzug vorhanden. Telefon: 0711- 317004
Suche im Mandantenauftrag: Praxiseinstiege/Übernahmen
Urologie und HNO


Gebiet Südbaden/Mittelbaden.
Ludger Huber, 0761/70328-36 ludger.huber@mlp.de
Praxis
im Großraum Stuttgart zu vermieten Schöne Praxisräume (134 m²) in zentraler Lage einer großen Kreisstadt in der Nähe Stuttgarts zu vermieten. Aufzug vorhanden. Frei ab Mai 2024. Informationen: 0162-7685894
PRAXISSUCHE
Bestens beraten. Profitieren Sie vom kostenlosen Service »Praxisgründung«.
Existenzgründungs-Seminar Standortanalyse Niederlassungsberatung Praxiswertermittlung Branchendaten Liquiditätsplanung
Infos unter Telefon 0711 124-45019 www.bw-bank.de/heilberufe F0220002_10_02_AZ_BW_Heilberufe_91x40_AEBW.pdf
Suche im Mandantenauftrag: Praxiseinstiege/Übernahmen
Kardiologie und Augenheilkunde. Gebiet Südbaden/Mittelbaden.
Armin Ritter, 0761/70772-55, armin.ritter@mlp.de
Ein Unternehmen der LBBW-Gruppe
GEMEINSCHAFTSPRAXIS
ENDLICH VERTRAGSARZT!
Ihr Beratungsbonus zum Einstieg
Orientierung – Vor der Zulassung Niederlassung oder Anstellung Finanzielle Auswirkungen des Projektes Der Weg zur Zulassung als Vertragsarzt Seminare zur Praxisgründung und Praxisführung Informationsbroschüren „Beratungsservice für Ärzte“ Praxisbörse
Nach der Zulassung und vor der Praxisaufnahme Erstberatung Abrechnung/Honorar Sprechstundenbedarf und Erstbeschaffung Wirtschaftliche Verordnung
IT in der Praxis Praxismanagement
Zeitnah nach der Praxisaufnahme Abrechnungsergebnisse Verordnungsstatistik Finanzielle Entwicklung
Nach Etablierung der Praxis
Patientenzufriedenheit Wirtschaftlicher Praxisbetrieb Entwicklung der Praxis
Kooperation/Strukturveränderung Finanzielle Auswirkung Kooperationsformen Praxisausrichtung Praxisbewertung
P r a x i s n a c h f o l g e r N e u r o l o g i e ( m / w / d ) g e s u c h t Gemeinschaftspraxisanteil an großer und gutgehender neuro-psychiatrischer Praxis mit engagiertem Team in Stuttgart abzugeben.
Zuschriften erbeten unter ÄBW 0130 an den Gentner Verlag, PF 10 17 42, 70015 Stuttgart oder per E-Mail an chiffre@aebw.de
SONSTIGES
Tattoo Entfernung
ND YAG Laser N e u 09861/9386250 info@topsued.de
PRAXISABGABE
Attraktive Gynäkologische BAG sucht Nachfolger/in im LK Calw.

Praxisservice
E-Mail: Praxisservice@kvbawue.de Tel.: 0711 / 7875 3300 www.kvbawue.de / www.mak-bw.de
Tel.: Tobias Krämer 0151/15192509
497 ÄBW 07 | 2023
- Jul_17_2020 05_19_45
Ein Unternehmen der LBBW-Gruppe
F0220002_10_01_AZ_BW_Heilberufe_91x40_AEBW.pdf - Jul_17_2020 05_16_00
PARTNER DES ARZTES

FÜR PRAXISEINRICHTUNG, PRAXISMANAGEMENT UND MARKETING in Baden-Württemberg



Är zteblatt
Baden-Württemberg Anzeige



www.ärzteblatt-bw.de


Herausgegeben von Kurt Landau
Gesundes

Arbeiten in der Gebäudetechnik




1. Au age, 2023, 257 Seiten, Gebunden oder E-Book, € 49,–























Bestellung unter:





Jetzt bestellen!

Fotos: Getty Images/stock.adobe.com
www.gentnershop.de/buchshop
Fax: (07 11) 6 36 72 - 7 60
E-Mail:
Tel.: (07 11) 6 36 72 - 8 27
Fax: (07 11) 6 36 72 - 7 60
E-Mail:
hollenbach@gentner.de Auftragsmanagement


Rudolf Beck
Tel.: (07 11) 6 36 72 - 8 61


Fax: (07 11) 6 36 72 - 7 60

E-Mail: beck@gentner.de

mayer gmbh amalienstraße 4 75056 sulzfeld 07269 - 91999-0 info@mayer-im.de www.mayer-im.de | praxen | apotheken | medizinische zentren |praxisplanung |praxiseinrichtung |projektsteuerung räume realisieren lassen.
FÜR PRAXISEINRICHTUNG, PRAXISMANAGEMENT UND MARKETING in Baden-Württemberg Anzeigenschluss für Heft 8 / 2023 ist der 26. Juli 2023 wolf.g. praxis + objekteinrichtungen Planung Beratung Fertigung Planung Hauptstr. 15 73563 Mögglingen296 97 78 296 98 28 07174 07174 Tel. Fax www.wolf-g.com info@wolf-g.com Fertigung Vordere Angerstr. 10 86720 Nördlingen/Löpsingen // Kostenfreie Architektenplanung // Höchste Designqualität // Individuelle Möbelentwürfe // Hauseigene Leasing-Finanzierung OLYMP GmbH & Co. KG 0711 21310 service @olymp.de www.olymp.de Hier könnte Ihre Anzeige stehen ! Rufen Sie an!
PARTNER DES ARZTES
Tel.: (07 11) 6 36 72 - 8 27
hollenbach@gentner.de Anzeigenleitung Axel Hollenbach
Stabilität für Ihre Geldanlage: die LBBW Balance Fonds.
Unsere LBBW Balance Fonds setzen auf Nachhaltigkeit – investieren Sie in eine Anlage, die Klimaschutz, soziale Aspekte und eine gute Unternehmensführung berücksichtigt.


Ob defensive oder offensive Anlageausrichtung: Wir beraten Sie gerne. Jetzt informieren und Termin vereinbaren unter www.bw-bank.de/balance
Allein verbindliche Grundlage für den Erwerb der dargestellten Investmentvermögen sind die jeweils aktuellen Basisinformationsblätter und Verkaufsprospekte in Verbindung mit den neuesten Halbjahres- und/oder Jahresberichten. Diese Unterlagen können kostenlos in deutscher Sprache bei der Baden-Württembergischen Bank, Kleiner Schlossplatz 11, 70173 Stuttgart, in schriftlicher Form angefordert werden sowie unter https://www.bw-bank.de/balance in elektronischer Form abgerufen werden. Eine Zusammenfassung der Anlegerrechte und Informationen zu Instrumenten der kollektiven Rechtsdurchsetzung sind ebenfalls in deutscher Sprache kostenlos bei der Baden-Württembergischen Bank wie oben angegeben sowie unter https://www.bw-bank.de/anlegerrechte erhältlich. Die Verwaltungsgesellschaft des Investmentvermögens kann jederzeit beschließen, den Vertrieb zu widerrufen. Um weitere Informationen, insbesondere zur Struktur und zu den mit einer Investition in das Investmentvermögen verbundenen Risiken zu erhalten, sollten potenzielle Anleger diese Unterlagen lesen.
Ein Unternehmen der LBBW-Gruppe
Werbung

Unverbindliche Visualisierung. Darstellung kann Sonderwünsche enthalten.
Unverbindliche Visualisierung. Darstellung kann Sonderwünsche enthalten.




























































































